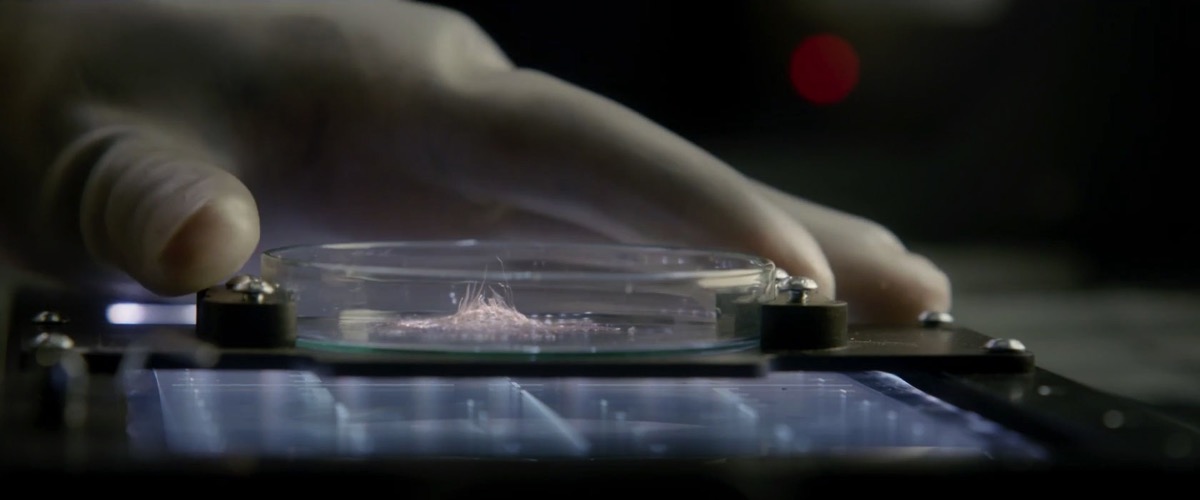
imagen

Un viaje intergaláctico gracias a los datos de GAIA DR3. Ojalá hubiera GPS y wifi en el espacio.

Una criatura cibernética logra la autonomía, pero en lugar de dominar el mundo prefiere esconderse y ver tele, porque socializar es un coñazo.

Un youtuber se ha empeñado en construir una versión real del equipo de maniobras tridimensionales del anime. Y sorprendentemente funciona… a veces.

Había en total 48 candidaturas de 20 nacionalidades distintas.

Más que de los peligros de saltar en el tiempo, la película nos avisa de que una red neuronal chiflada podría hacernos esclavos de no se sabe qué.

Ir de la Comarca a Mordor no es un paseo por el campo.

Historiales clínicos diseccionados al milímetro, por si los términos y acrónimos de hospital son lo tuyo.

La nostalgia manda: 40 canales convierten YouTube en una tele con horarios, zapeo y la gloriosa imposibilidad de elegirlo todo.

Ha sido remasterizado a partir de los negativos originales guardados en los archivos de la ITV.

El nuevo generador de vídeos logra un realismo obsceno con prompts simples.

¡Hoy es el día! El día de la marmota, 2 de febrero. Uno de los más curiosos, fluzeantes y divertidos, inmortalizado en la entrañable película de Bill Murray, Groundhog Day. Su título en España fue Atrapado en el tiempo (1993, Harold...

Cuatro tecnobros se encierran con sus móviles en Utah a todo lujo, para ver arder el mundo y luego intentar arreglarlo con IA y un poco de ego.

Arrancó con 30 segundos del transbordador espacial, 5 videoclips, más rótulos, y anuncios.

Una colección de fotos panorámicas de las naves de Star Trek. Poca resolución, pero inmersión garantizada.

Una serie satírica sobre el mundo startup, donde hay más humo que en una feria de baratijas.

Un corto sobre CAPTCHAs y existencialismo.

Si sobrevivir a una bomba atómica es tu plan de futuro, esta película te dará lecciones prácticas sobre el caos y la paranoia.

Fue un éxito arrollador tanto entre el público como entre la profesión, que le otorgó varios galardones.

Entre la verdad y el cine: Selma se lleva el Oscar a la honestidad; Alan Turing se revuelca en su tumba.

El sueño de la TV sin calidad: cientos de canales mediocres en un solo mosaico.

Son algo más de 9.000 piezas para un conjunto que probablemente es el más caro de la historia de la empresa.

La serie fue muy popular en su momento, aunque no ha resistido muy bien el paso del tiempo.

El «top geek» que envejeció como el vino: tráilers de culto, algunos remasterizados y todo.

Daisy Bell, cantada por un IBM 7094 en 1961, marcó el inicio de la era de las voces artificiales. Su eco sigue resonando.

Westworld y la IA: de la ciencia ficción a la realidad. Las máquinas podrían alcanzar la autoconsciencia, pero aún son simples entindades robóticas.

Todavía no hay fecha de salida al mercado ni precio pero está confirmado que la marca danesa sacará un conjunto dedicado a la popular serie.

La ciencia ficción de Star Trek ha inspirado gadgets: móviles, tabletas y asistentes de voz; el transportador, por desgracia, no tanto.

El purismo cinéfilo se enfrenta a 12 versiones de Seven. Del 35 mm al 4K, el dilema es qué versión ver para sentir la original.

Un teclado de 899 dólares de la serie Severance. En Kickstarter lo intentan, pero la cosa pinta complicada.

Viaje al pasado: las fuentes de WarGames disponibles en formatos .FON, .TTF y .OTF, gracias a una meticulosa labor de arqueología informática

La forma en la que está contada la historia hace difícil –o más bien imposible– saber qué está pasando en realidad con sólo los episodios disponibles.

La campaña antipiratería de 2004, irónicamente, usó una tipografía pirata. Increíble pero cierto: sermonear sobre un «crimen» con otro «crimen».

Se trata de una nueva aventura de la Rocinante y su tripulación situada entre el final de la serie de Amazon y el principio de la séptima novela.

Una crítica mordaz a las redes sociales que reflejan el abismo generacional entre adultos despistados y adolescentes atrapados por likes y emojis.

La crítica está siendo bastante dura con ella, todo hay que decirlo.

Pelotas de goma a 210 km/h, 24 coches dañados y un niño feliz con 500 pelotas. El anuncio de Sony que hizo historia en San Francisco.

Una nueva obra de nuestra especialista en el tema, Olga Osorio.

El refinamiento de datos encarna el tedio diario en una actividad enigmática, combinando monotonía con el inusual gusto por acertar.

Más de 180 modelos de sillas y sillones usados en Star Trek, desde diseños de Philippe Starck a IKEA, catalogados con precisión casi vulcana.

Junto con ellas están disponibles el resto de las películas soviéticas del director.

Un viaje visual por las interfaces más creativas de películas, videojuegos y anime, organizadas y explicadas al detalle.

Jonas es un creador de efectos visuales para cine y series de televisión que está un poco indignado por el hecho de que la industria audiovisual «venda» que muchas películas están «hechas sin CGI» cuando en realidad hay CGIs a diestro...

Satoshi Nakamoto, la persona (o personas) que inventó Bitcoin y lo dejó libre para que cualquiera pudiera usarlo hizo luego la jugada perfecta. Simplemente, desapareció.

¿Por qué los estudiantes recuerdan mejor lo que ven en televisión que lo que aprenden en clase? Esto es tan curioso como la genealogía que van de Aegon el Conquistador a Daenerys Targaryen en Juego de tronos, a la de los...

Si hay un juego que ha marcado una generación en las últimas décadas sin duda ha sido Minecraft. Un juego de culto donde el objetivo es (o era) pasárselo bien, con piezas para construir como las de Lego, en mundos explorables...

EC Henry se ha dedicado a modelar algunas naves de Star Wars para examinar y comparar su coeficiente de resistencia, un valor asociado con la aerodinámica de las naves que da una idea de lo capaz, veloz y maniobrable que puede...

Who Killed the World? (¿Quién destruyó el mundo?) es un trabajo interactivo de Alvin Chang en forma de artículo con muchísimos datos clasificados y visualizados de forma elegante. Básicamente trata sobre cómo han visto las amenazas y la destrucción del mundo...

La Criterion Collection es una de las más prestigiosas recopilaciones de largometrajes tanto clásicos como modernos, centrada sobre todo en que tengan la máxima calidad técnica que permita su reproducción de forma fiel y a la máxima resolución (ya sea en...

El buen profesor Neil deGrasse Tyson también se ha apuntado a la noble costumbre de hacer listas y deja en su videoblog de StarTalk Plus la racionalización sobre cuáles son sus películas de ciencia-ficción favoritas. La enumeración no tiene ni orden...

Con destino a la Luna (Irving Pichel, 1950), conocida como precursora de Alien: el octavo pasajero Tanto si te gustan las obras cinematográficas maestras de toda la vida como si eres más del cine de serie B cutre seguro que te...

Ovejas Eléctricas en La 2 de TVE. También estará disponible a la carta en RTVE Play para poder verlo en horarios compatibles con la vida humana.

Imagino que a estas alturas ya más o menos todo el mundo sabe de qué va El problema de los tres cuerpos. Pero por si acaso, sin spoilers… Ye Wenjie, una astrofísica china víctima de la Revolución Cultural que termina trabajando...

Bienvenido al mundo real, Neo.– Morfeo Thomas Anderson ha estado llevando una doble vida. Durante el día es programador en una empresa. Pero por la noche es Neo, un hacker de élite en continua búsqueda de algo. A través de Morfeo...

Puede que tuviera las expectativas demasiado altas por la increíble Hermanos de sangre. Y que los trece años que han pasado desde que empecé a oír hablar de ella hayan contribuido a ello. Pero por fin he terminado de ver Los...

Las ya no sé si tan buenas gentes de Zococity me han dejado un amplificador/DAC y streamer de escritorio FiiO R7 para probar y me han creado una necesidad que no sabía que tenía. Para entendernos, es un dispositivo que hace...

Kole Stojanoski es un fan de la ciencia ficción y sus interfaces, hasta el punto de que llegó a crear esta completa interfaz LCARS para Android que emula la de los ordenadores de las sagas Star Trek modernas, a partir de...

Un producto multimedia tiene que proporcionar un dólar de entretenimiento por hora o te destrozarán los comentarios transmitidos de boca en boca.– Daniel U., programadorMicrosiervos (Douglas Coupland, 1995) Taylor Town hizo algunos cálculos en su blog sobre el precio del entretenimiento...

En el archivo de internet puede encontrarse el Kit de prensa original de Sneakers, la película de hackers de 1992 que marcó época, y una de nuestras favoritas. El disquete original con el que se generó la versión para el archivo...

Después de unas cuantas semanas diciendo que «launching soon» por fin está en línea NASA+, la plataforma de contenidos en streaming de la NASA. Está disponible de forma gratuita a través de las apps de la agencia para Android e iOS, para...

Si el buscador no me engaña la primera vez que mencionamos Masters of the Air (Los amos del aire en español) fue el 20 de enero de 2013. En aquel momento comentábamos que HBO había adquirido los derechos del libro en...

Nos enteramos de la triste noticia de que ha muerto Carlos Pumares (1943-2023), uno de los críticos de cine más conocidos y queridos por el público. Muchos lo descubrimos en las madrugadas de la los inicios de la mítica Antena 3...

Erik Wernquist ha publicado esta minipeliculita titulada Una revolución por minuto creada con imágenes 3D y música de Cristian Sandquist imaginando cómo sería una límpida estación espacial al estilo de un hotel «retro» para visitantes y viajeros espaciales. La estación espacial...

Me ha gustado esta pieza de The Overview Effect dedicada a la ubicación de los mundos de Star Trek y otra ciencia-ficción en el espacio, que aunque tiene un aspecto galáctico por su comienzo está más bien concentrada en las cercanías...

Tal día como hoy en 1999 una explosión en un depósito de residuos radiactivos en el lado oculto de la Luna la sacaba de su órbita lanzándola en portentoso viaje a través del tiempo, el espacio, y otras dimensiones. Y con...

La factoría de Star Trek ha estrenado Skin a Cat, el primero de una serie de cortometrajes animados «muy cortos», que en cierto modo son un homenaje a Star Trek: la serie animada (1973-1975). Tienen el estilo de los dibujos animados...

Me explicaron hace tiempo este truco que me ha salvado más de una vez, especialmente de pasar noches sin dormir. Sirve para evitar engancharse a una serie de TV de esas que te dejan colgado de un episodio a otro, obligándote...

Antes de empezar: hace muchos años que tengo la suerte de poder considerar amiga a Olga Osorio, la directora de la película. Pero puedo prometer y prometo que ¡Salta! me ha gustado mucho con independencia de eso. O a pesar de...

Vi que en The Guardian hablaban de El imperio de los chimpancés (Chimp Empire, 2023, Netflix) como si fuera «Succession, pero con simios» y lo describían como «una historia de traición, conflicto y luchas de poder». Así que como solo eran...

A quienes les guste el ambiente Bladerunneriano o simplemente el look de las ciudades futuristas un tanto oscuras, con música ambiental relajante y tranquila, el canal Science Fiction Ambience es su destino ideal. Son vídeos de 8 horas con este tipo...

Me topé vía algoritmo con este vídeo de YouTube que resulta ser un cuatro en uno, a cual más interesante, y que se deben corresponder con los extras del DVD de Juegos de Guerra (1983), la famosa película hackeril por excelencia,...

El físico de armas nucleares Greg Spriggs analiza en este vídeo para Insider el realismo de las explosiones nucleares en el cine. Las únicas películas que se salvan de casi una decena son dos de Christopher Nolan: Oppenheimer y Batman: el...

Si te has cansado ya del catálogo de los Netflix y Prime Video de turno he aquí mi recomendación para descubrir lo que yo denomino películas malas buenísimas, algo a medio camino entre el cine de serie B y el de...

Nat Kelly dirige, actúa y participa en la producción y montaje de esta película titulada Moon Dog en este cortometraje muy corto pero intenso, en el que un perro es enviado a la luna y luego suceden muchas más cosas. Toda...

Se ha estrenado ya la sexta temporada de Black Mirror en Streamberry. Es una de nuestras series favoritas por lo distópico y tecnológico, que añadide de este modo cinco nuevos episodios a su historial, sumando ya 27 en total. (En esta...

«Desde aquí se hackeó Protovision», dice @6502B, que ha recreado con cuidadoso y delicado detalle la habitación de David en Juegos de guerra (1983), mítica película para todos los hackers ochenteros donde las haya. Esta maqueta a escala 1:12 parece hecha...

¡Mírame, tonto! - Las mentiras impunes de la tele. Por Mariola Cubells. Robin Book (28 de octubre de 2003). 240 páginas. Cuando llegaron las televisiones privadas a España dos cosas me llamaron la atención: los bloques de publicidad eternos y la telebasura....

Welcome to Life es una simpática minipeliculita de Tom Scott inspirada por Everyone in Silico, de Jim Munroe y Postsingular, de Rudy Rucker, acerca de cómo podría ser nuestra existencia virtual más allá de la muerte si las cosas toman un...

Reagan Ray tiene en su blog esta página dedicada a la rotulación en los logotipos de películas de ciencia-ficción, con decenas de ellos todos anteriores al año 2000. La lista no está completa pero los logotipos están limpios y muy cuidados,...

MeWho Rob se dedica a recrear con infinito detalle las interfaces futuristas del universo de Star Trek, en particular las que emplean el sistema operativo LCARS que gobierna todas las naves terrestres de la Flota Estelar. Su última creación es Titan.DS,...

Kirby Ferguson ha publicado por fin la versión definitiva de Everything is a Remix (2023) como versión completa y actualizada de su trabajo documental entre 2010–2012 sobre el concepto de la remezcla. Es un documenta de una hora que combina lo...

El 8 de marzo de 2014 el vuelo MH370 de Malaysia Airlines entre Kuala Lumpur y Beijing desapareció sin dejar rastro. Sólo año y pico más tarde unos restos aparecidos en Madagascar y unos meses después en Mozambique parecen confirmar que...

U2 acaba de publicar Songs Of Surrender, un disco en el que revisitan 40 canciones de la historia de la banda con nuevos arreglos musicales e incluso, en algunos casos, con retoques en las letras. Bono & The Edge: A Sort...

Esta maravilla es Super Star Trek 1978 + 25th Anniversary y es un crossover entre la versión del Star Trek 1978 de estrategia que provenía de 1971 y que se jugaba en modo texto pero con los gráficos y sonidos del...

Bajo el título de Blade Runner: White Dragon Cut hay una página web que recoge una serie de notas y vídeos con una versión alternativa de las primeras escenas de Blade Runner, aunque en realidad es más cómodo verlos por fechas...

[Ojo, en esta anotación hay un posible pequeño spoiler sobre The Expanse] Entre Las cenizas de Babilonia y El alzamiento de Persépolis, respectivamente la sexta y séptima novelas de The Expanse, transcurren 28 años. Esas tres décadas nunca habían sido contadas hasta...

Se acerca el final de año y llega el momento de las recopilaciones. Así que hemos desempolvado algunos datos de la página de estadísticas para ver qué fue lo más popular del año pasado en Microsiervos. Estas son las cinco anotaciones más...

La buena gente de MetaBall Studios ha preparado para terminar el año una versión mejorada de uno de sus clásicos: una comparativa de naves espaciales comparadas en 3D. Hay naves principalmente de películas, series y también videojuegos, con alguna surgida de...

Johnny Darrell ha dedicado un buen tiempo a trabajar con Midjourney, una de las IA de moda para generar imágenes fotorrealistas en todo tipo de estilos y ha conseguido una combinación brutal: un cruce entre los diseños, personajes y escenarios de...

Me he encontrado a través de los insondables RTs de Twitter con CaixaForum+, una plataforma de vídeo que no tengo ni idea de cuándo se ha lanzado pero que tiene pintaza: contiene cerca de mil documentales sobre cultura, ciencia y artes,...

¿Te imaginas ver Star Wars y que todos los láseres fueran reales y te pasaran por encima de la cabeza? Pues en esos consiste este experimento, que a falta de un nombre mejor han llamado mapeado láser o visionado aumentado /...

Me crucé revisando catálogos con Filmed in Supermarionation (Stephen La Rivière, 2014), un documental que tiene unos cuantos años –anterior al Netflix que ahora conocemos– sobre las series y películas británicas de Gerry y Sylvia Anderson donde los personajes eran marionetas...

Hoy se cumplen 25 años del estreno de Starship Troopers, la película de Paul Verhoeven basada en la novela homónima de Robert Heinlein. En su momento no fue precisamente un éxito porque en un primer vistazo no deja de ser una...

Hace poco estuve viendo Science Fiction: Voyage to the Edge of Imagination, una magnífica y muy interesante exposición sobre ciencia ficción que el Museo de Ciencias de Londres inauguró a principios de este mes. Si te pilla por allí –y te...

En una enciclopedia temática a la antigua usanza, muy al estilo web «de los años 90», llamada Ex Astris Scientia un usuario llamado Will se entretuvo en preparar un artículo que recopila todos los tipos de ordenador de Star Trek, la...

Flight/Risk, en español Peligro en el vuelo (disponible en Prime Video), es el tercer documental sobre el fiasco del Boeing 737 MAX que he visto. El mejor de los tres sigue pareciéndome que es, con diferencia, Boeing's Fatal Flaw. Pero Flight/Risk,...

Tenía muchas ganas de ver el resultado de la serie de Netflix que adapta The Sandman. Y aunque he de reconocer que hace demasiado tiempo desde la última vez que leí los cómics, así que a lo mejor me he perdido...

Cuando empieza Las luminosas (Apple TV+) conocemos a Kirby Mazrachi, que trabaja en el archivo del Chicago Sun-Times. Seis años atrás, Kirby fue atacada y dejada por muerta por alguien que nunca fue detenido. Desde entonces, aparte del trauma evidente del...

Este precioso cortometraje animado de Simon Biggsse se titula Widdershins (2018). Es una palabreja que es la versión escocesa de Withershins, que viene a ser nuestro equivalente a A contracorriente o «en dirección opuesta a lo que normalmente se espera». Y...

Esta curiosa película llamada Rythmetic es un trabajo de Norman McLaren y Evelyn Lambart, dos pioneros del cine de animación moderno que eligieron la aritmética y la magia de los números para transmitir algo de ritmo, humor y, por qué no,...

Siempre que puedo veo películas o series en versión original. Pero es cierto que hay veces en que, aunque me defiendo bastante bien con el inglés, necesito los subtítulos para entender algunos diálogos. Aunque a veces también me pasa con películas y...

Mark Scout trabaja para la megacorporación tecnológica Lumon Industries. En concreto lo hace en el departamento de Refinamiento de macrodatos (MDR). Es un departamento que está situado en una planta especial de las instalaciones de la empresa. En concreto aquella en...

Con gran tristeza ha llegado la noticia del fallecimiento de Nichelle Nichols (1932-2022), la actriz que encarnó a la Teniente Uhura en Star Trek: la serie original. Según ha contado su hijo en una nota, Nicholls falleció de causas naturales a...

Este curioso cortometraje titulado Infinite Escher es una especie de exhibición de poderío de Sony sobre la animación por ordenador y los gráficos 3-D de allá hacia 1990. Aunque ahora resulte un tanto infantil e ingenua, es lo que había, y...

Este año se cumplen 40 años del estreno de Tron, una de las películas favoritas de esta casa. Es cierto que no fue un gran éxito comercial en su momento, entre otras cosas porque ese año se peleaba con títulos como...

No sé por donde vi pasar esta secuencia-recordatorio de la estupendísima Battlestar: Galáctica (2004-2009), una de las mejores series de ciencia-ficción de todos los tiempos. En el episodio en cuestión el comandante de la nave insignia de la flota, interpretado por...

Elegir qué ver por la noche es para muchas personas algo complicado, una proeza sin igual, una gesta digna de Aquiles o un logro mayor que la conquista del Everest. 500 servicios de streaming y nada que ver, sería el título...

Al principio de Outer Range (Prime Video), Royal Abbot tiene una vida más o menos sencilla intentando mantener el rancho familiar a flote. Aunque meses atrás Rebecca, la esposa de Rhett, uno de sus hijos, y madre de Amy, su nieta,...

Ha fallecido José Luis Balbín (1940-2022), quien para toda una generación fue un periodista de referencia por haber popularizado en televisión el formato del «debate entre expertos» con La Clave. Este mítico programa se emitía las noches de los sábados en...

Moisés nos escribió para hablarnos de un proyecto que me recordó la época de los gloriosos años 80 de la informática, en la que si querías un videojuego para los pequeños ordenadores de la época, tenías que programártelo tú mismo. Y...

En uno de los episodios de la entretenida serie La mujer del viajero en el tiempo (homónima de la película de 2009 y por extensión de la novela original de Audrey Niffenegger de 2003), el protagonista pasa unos cuantos chivatazos de...

Estuve viendo en el siempre interesante Absolute History una curiosa dramatización histórica documental titulada Saving The Titanic (Salvar el Titanic, 2012) de Maurice Sweeney. Es una película de 90 minutos sobre el archiconocido hundimiento del RMS Titanic allá por 1912, pero...

Como gran aficionado a Star Trek: la nueva generación me ha encantado la visita guiada que en Halfscreen han preparado sobre un modelo 3D muy detallado de la mítica nave y sus 42 cubiertas. Es la mejor forma de entender su...

Al principio de Top Gun: Maverick descubrimos que casi cuatro décadas después de Top Gun, Pete «Maverick» Mitchell sigue siendo capitán de la Armada de los Estados Unidos. Se las ha apañado para no subir de grado y poder seguir volando...

Si te gusta la tipografía y también el cine, es tu día de suerte. Y una vez que leas sobre esto, ya no podrás olvidarlo cada vez que veas una película. El caso es que Mark Simonson publicó hace dos décadas...

Lo habrás visto ya en todas partes, pero por si acaso: hace unas horas saltaba la noticia de la muerte de Evángelos Odysséas Papathanassíou, mucho más conocido como Vangelis. Falleció el 17 de mayo de 2022 a los 79 años de edad....

Josh Roshell se dedica al envidiable diseño de tipografías; comerciales, divertidas y también para películas. Uno de los últimos encargos que ha recibido es el proyecto de modernizar la apariencia de la tipografía para Avatar 2. ¿Por qué cambiar esa tipografía...

Las buenas gentes de Free League Publishing lanzaron hace un par de días una campaña de financiación colectiva para un juego de rol basado en Blade Runner. En tan sólo tres minutos consiguieron su objetivo y ahora, con la financiación ya...

Si de pequeños alucinabas con los gigantescos brutos mecánicos del Doctor Infierno y jugabas a hacer volar a mano el Jet Scrander para recoger a Mazinger Z y acabar con sus mortíferos enemigos a base de rayos láser y «fuego de...

Apple ha aprovechado que hoy es el día de Star Wars* para estrenar su minidocumental acerca de cómo se crean los sonidos de las películas más populares de todos los tiempos en Skywalker Sound, explicando en boca de quienes trabajan allí...

p Me avergüenza no haber descubierto antes el trabajo de Karel Zeman, quizá porque su obra no pasó por Hollywood o porque estaba dirigida al público infantil. Este clip resume uno de los documentales sobre su trabajo y da una buena idea...

Como modelista aficionado en mis años mozos me ha encantado el trabajo que se ha metido un grupo de alumnas y alumnos de un curso de modelismo en animación de la National Film and Television School (NFTS, Escuela Nacional de Cine...

Framed es un juego de adivinar películas a partir de fotogramas al que se ha añadido la «mecánica Wordle» de que hay un solo reto diario y de que los resultados se pueden compartir con solo copiar-y-pegar en las redes sociales....

Bosikova Kiunnei es una yacuta siberiana (más exactamente: sajá) que comparte en YouTube unos preciosos minidocumentales sobre las gentes de Yakutstk, un poco como vimos hace unos meses que hacía Ruji Çenet, solo que él iba más bien plan turístico. Su...

Contenidos de la caja – LEGO LEGO acaba de anunciar la salida de una nueva versión del DeLorean DMC-12 de Regreso al futuro que es la más mejor de la historia hasta el momento; que si no nos fallan las cuentas es...

Bellatrix es un experimento visual y sonoro de Sebastien Guerive, un artista que ha plasmado en música e imágenes lo que le sucede al agua cuando se congela. Tal y como explica, en la cristalización la saturación química se vuelve inestable...

Esperaba con ganas que Netflix estrenara Caída en picado: el caso contra Boeing para ver cómo trataba el documental el fiasco el caso del Boeing 737MAX. Pero he de decir que me ha defraudado, que en mi opinión se queda a...

Netflix Codes desentraña los secretos de cómo clasifica Netflix las películas y series produciendo unas listas y categorías mucho más precisas y fáciles de entender que los que se pueden ver a simple vista al entrar en el servicio de streaming....

La arcadeología, así en genérico, podría definirse como (…) Investigar qué hubo en algún local de recreativas hace 30 o 40 años, desempolvar cabinas de arcades, repararlas, documentarlas completamente (…) algo que haces porque si no lo haces tú no lo...

Al ver este vídeo de primeras queda claro que las cosas no son como parecen. Es el delicado trabajo de carpintería para fabricar un cajón para botellas de leche grabado mediante la técnica de stop-motion. El resultado es bastante delicioso a...

Tal y como cuentan en The Hollywood Reporter, Futurama revivirá en Hulu en 2023 [en España en Disney+], sacándola así de una hibernación de una década, puesto que los últimos episodios de la séptima temporada se emitieron allá por 2013. De...

Douglas Trumbull – vía Amy Trumbull Hace unas horas Amy Trumbull, la hija de Douglas Trumbull, daba la noticia de su fallecimiento. Trumbull fue un genio de los efectos especiales –se dice a menudo que una de las personas que los inventó–...

Finding X («Buscando a X») es un cortometraje matemático sobre la búsqueda del sentido de la vida y el entendimiento del universo de una pequeña variable en el mundo de las matemáticas. El guión, la narración y los personajes son obra...

Con motivo de las celebraciones de Año Nuevo chino y aprovechando para hacer publicidad de forma un poco diferente, Apple encargó el rodaje de El regreso, un cortometraje del director chino Zhang Meng que transcurre a lo largo de algo más...

En este vídeo John DiMarco se ha marcado una buena recopilación de cómo han evolucionado los efectos visuales del salto a velocidad de curvatura (warp speed) del Enterprise y otras naves del universo Star Trek, comenzando por la primera y espectacular...

Impresión artística de SEE-1 acoplado a la Estación Espacial Internacional a través de un módulo de la estacion espacial de Axiom. Es la pelota de golf XXXXXL – Space Entertainment Enterprise No recuerdo desde cuándo se habla de la película que Tom...

Reseña spoiler free más allá de lo que ya habrás visto en el tráiler. Veinte años después de su estreno Lana Wachowski, junto con Aleksandar Hemon y David Mitchell, se ha atrevido a revisitar el universo de Matrix con el que...

Un interestante panel de control de la Rocinante Cooper, ready.[…]Ripley, ready. Que las personas que escribían la serie The Expanse disfrutaban de su trabajo estaba claro por la calidad de la adaptación. Y por los numerosos huevos de pascua que han ido...

Dicen que las desgracias nunca vienen solas. Hace unas semanas quienes llevamos años disfrutando del universo de The Expanse creado por James A. Corey vimos como era publicada la que será la última novela ambientada en ese universo, Leviathan Falls. Y...

De 10 Lesser-Known Sci-Fi Movies That Are Worth Your Time, una lista, como el título indica, de diez películas de ciencia ficción poco conocidas pero que merecen la pena. He usado, cuando lo hay, el título que le da la IMDB...

Reseña sin spoilers, aunque sí con uno de Spider-Man: Far from Home Tuve la suerte de entrar en el cine a ver Spider-Man: No Way Home sin haberme tragado ningún spoiler, así que la pude disfrutar como se merece; me ha...

En el año 2022 la Tierra está superpoblada y totalmente contaminada; los recursos naturales se han agotado y la alimentación de la población corre a cargo de Soylent Industries, una empresa que fabrica un «alimento» compuesto por plancton de los océanos....

Enviar un correo electrónico es todo un ritual que las personas minuciosas quieren completar acertando en cada detalle. Samantha Jayne de Quarter Life Poetry lo demuestra en esta peliculita que forma parte de un conjunto más amplio sobre la «crisis del...

No mires arriba (Adam McKay, 2021) es la última película de argumento «¡Que viene el asteroide!» que se acaba de estrenar en Netflix, de esas que nos encantan por aquí por lo apocalíptico. Pero a diferencia de otras es quizá la...

Who wouldn't want to hang out on the Roci with Shohreh Aghdashloo? #TheExpanse pic.twitter.com/fdLM1bMd1N— The Expanse (@ExpanseOnPrime) December 21, 2021 Shohreh Aghdashloo, la actriz que interpreta de manera tan soberbia a la Secretaria General de las Naciones Unidas Chrisjen Avasrala en la...

Esta pequeña película japonesa de Junta Yamaguchi es toda una muestra del ingenio y ambor el trabajo por «amor al arte» de algunos amantes del cine. Una película que sabe a poco (71 minutos) rodada con bajísimo presupuesto, un guión tremendamente...

La premisa de Invasion (disponible en Apple TV+) es que un día cualquiera comienzan a pasar cosas raras. Críos qu eoyen voces en sus cabezas. Cortes en las comunicaciones y en el suministro eléctrico. Explosiones que resultan ser meteoritos. Una unidad...

Por cosas del algoritmo me he cruzado con este vídeo de UFO (1970-1971), una serie británica creada por Gerry y Sylvia Anderson que me ha evocado recuedos de mi niñez: fue una de las primeras ciencia-ficción que vi, junto con la...

Esta curiosa «experiencia» que ha preparado la gente de Unreal es toda una demostración de la capacidad de Unreal Engine 5 para PlayStation 5 y Xbox X/S. La verdad es que abre los ojos como platos, porque no queda claro qué...

Leviathan Falls por James S. A. Corey. Orbit (2 de diciembre de 2021). 528 páginas. Inglés. He devorado y terminado con pena y a la vez con alegría Leviathan Falls, la novena y última novela de The Expanse. La última en el...

En un futuro remoto, tan remoto que la memoria Tierra no es más que una leyenda, la humanidad se ha expandido por la Vía Láctea en un Imperio Galáctico que abarca millones de mundos. En ese contexto el matemático Hari Seldon...

Hace algunos meses estuve viendo John DeLorean: Un magnate de leyenda (2021), un mini-documental biográfico sobre el creador de la DeLorean Motor Company (DMC), la empresa que lleva su apellido. La DMC hace décadas que no existe, pero es todavía conocida...

Si hubiera que hacer un Top 10 de inventos de la humanidad, la imprenta estaría sin duda en un alto lugar de la lista, junto con la rueda, la electricidad y algunos más. En estos 60 minutos de documental Stephen Fry...

En un futuro no demasiado lejano la vida en la Tierra está prácticamente extinta. La causa, una descomunal fulguración solar que ha acabado con la capa de ozono, con lo que no se puede estar al Sol sin abrasarse con la...

Esta curiosa miniserie alemana de cuatro episodios es de lo más geek que se puede encontrar ahora mismo en Netflix, y hay que reconocer que está entretenida y con buena producción [doblada al español –excepto el tráiler– incluyendo un curioso mix...

No es lo que haces cuando estás en el espacio sino con quién lo haces.– Chris Cassidy Entre las estrellas (Among the Stars), disponible en Disney+, cuenta la historia de la última misión del astronauta de la NASA Chris Cassidy, quien...

Cuando un alien feroz acecha en los corredores de una nave espacial, la experiencia dice que más vale salir por patas y quemar los todos los puentes en el camino, incluyendo la autodestrucción de la nave si fuera posible. Que nunca...

En la mañana del 17 de octubre de 2021 la actriz Yulia Peresild y el director Klim Shipenko volvieron a tierra a bordo de la cápsula tripulada Soyuz MS-18 después de haber pasado 12 días rodando escenas para la película El...

Пропустили сегодняшний пуск? Мы подготовили для вас повтор этого исторического события!Missed today's launch? We have a replay of this historic event for you! pic.twitter.com/XiVqjG0FVl— РОСКОСМОС (@roscosmos) October 5, 2021 La actriz Yulia Peresild y el director Klim Shipenko llegaban a la Estación...

Blue Origin acaba de hacer públicos los nombres de quienes irán a bordo de su cápsula RSS First Step en su proximo lanzamiento tripulado. Serán Audrey Powers, vicepresidenta de operaciones de vuelo de la empresa; Chris Boshuizen, antiguo ingeniero de la NASA...

En el interesantísimo canal Pics And Portraits recopilan toda suerte de material audiovisual viejo del llamado retrofuturismo, uno de los más fascinantes fenómenos que nos permite ver cómo se imaginaba el futuro desde los ojos del pasado, hace décadas y décadas....

Vi pasar por @TheSpaceshipper unas imágenes de algo que parecía una versión en cómic de 2001: una odisea del espacio (1968), la mítica película de ciencia-ficción de Stanley Kubrick inspirada por el libro de Arthur C. Clarke. Tras soltar un lógico...

Me encontré con las mejores 1000 películas con un diagrama de cuerdas que es parte de una demostración de visualización con una herramienta llamada Data Crayon. Los datos provienen como es habitual de la Internet Movie Database. El formato de visualización...

Decenas de miles de años en nuestro futuro la humanidad se ha extendido por el universo conocido gracias a la especia, una sustancia que permite a los Navegantes de la Cofradía Espacial plegar el espacio y mover naves de un lugar...

Acaba de ponerse en preventa Space: 1999 Moonbase Alpha Technical Operations Manual, una versión actualizada a después de los eventos de Breakaway del manual de operaciones de la Base Lunar Alfa de Espacio: 1999. Aquella serie mítica de los 70 que...

Esta misión abrirá una nueva dimensión en cuanto a quién participa en una misión espacial. Y en ese sentido esta es una de las misiones más importantes jamás voladas.– Jeffrey Kluger,Redactor jefe para el espacio de Time. Si todo va según...

He estado viendo Lupin (Netflix), la serie de televisión francesa inspirada en Arsenio Lupin. Y aunque no he leído ningún libro de los que narran las aventuras del conocido ladrón de guante blanco me ha parecido que no hay ninguna duda...

John Knoll creó junto a su hermano el famoso Adobe Photoshop pero no contento con eso años después pasó a trabajar en Industrial Light & Magic junto con George Lucas en la segunda trilogía de Star Wars y en las Ediciones...

Tenía guardado por ahí para ver este enlace a Me and Bobby Fischer (Fridrik Gudmundsson, 2010), un extraño y curioso documental sobre los últimos días del Campeón Mundial de ajedrez Bobby Fischer y su insólito declive. Está disponible completo en YouTube....

Nestflix es una pequeña gran maravilla hecha con mucho amor al arte. Su catálogo son «series y películas anidadas», es decir, series y películas que pueden verse dentro de otras series y películas y que son (al 99%) inexistentes porque nunca...

Estaba viendo unas cosas sobre la escalera de Penrose cuando me crucé, cómo no, con la escena de las escaleras infinitas de Origen (Inception, 2010). Tras mirarla detenidamente es fácil entender el cómo se hizo, sobre todo teniendo en cuenta que...

Estaba esperando a tener unos días relajados para poder disfrutar de Invincible [Prime Video], una serie animada de superhéroes mucho más profunda de lo que parece, cuyo tráiler ya tenía pintaza, y la verdad es que la he disfrutado porque me...

Tom McWeeney es un artista que tiene en Behance diversas series de personajes de películas recreados al estilo «serie animada». Son auténticas maravillas que van desde Blade Runner a Terminator, Conan o Kill Bill. Y hay quien se pregunta si de...

Este minidocumental de Jeremy Benning descubre parte de la «magia» que hay detrás de las películas y series de televisión. Muestra el día a día del trabajo de los aristas de los «estudios de efectos», el denominado Foley, en inglés. En...

A mediados del siglo XX, coincidiendo con el codazo atómico volador con el que «Tusslin' Tom» Gurney derrotaba al calamar espacial de Rigel X–9, nacieron 43 niñas y niños en todo el mundo de forma simultánea. Aunque ninguna de sus madres estaba...

Ben Ouaniche, director de arte visual, nos muestra en su canal Macro Room una secuencia de efectos de manipulación del tiempo muy resultones y elegantes, a la par que bien trabajados. Aunque no se desvela el truqui parece una combinación de...

Marcin Wichary preparó esta curiosa charla para un evento de charlas ultra-rápidas Ignite, acerca de las películas y vídeos en bucle. Se trata de una curiosa técnica que nos ha dejado grandes trabajos a lo largo de la historia de las...

La gente de Flipboku está terminando en Kickstarter la financiación colectiva de The Pioneers - A Cinemagic Flip Book Collection. Es una especie de tributo a los pioneros del séptimo arte, una decena de flipbooks con seis secuencia cada uno (según...

Salad Mug es el primer episodio de Dynamo Dream, una futurista creación largamente esperada: tres años ha requerido su creación. Estos 20 minutos son básicamente el trabajo de un solo artista: Ian Hubert, quien además se empeñó en realizar todo el...

Julie tiene un diseño en Rebrickable para construir una Rocinante –la nave que coprotagoniza The Expanse– en la versión de las temporadas 4 y 5. Cuesta 40 dólares canadienses, que al cambio actual son 27 euros. Pero luego vienen las piezas,...

Este cortometraje titulado The End es una gigantesca, estilosa y cuidada recopilación de imágenes de cine en formato cinemagraph, que vienen ser algo así como «GIF animados supervitaminados», tratados con esmero para limpiarlos de todo lo superfluo y concentrar la acción...

Taehoon Park ha estrenado en una web especialmente diseñada para la ocasión 0110, un cortometraje de binario título y muy, muy corto, tanto que prácticamente podríamos llamarle micrometraje: apenas dos minutos y medio de duración. Pero son 150 segundos muy intensos,...

Después de muchos meses de rumores Rusia, a través de su agencia espacial Roscosmos, ha confirmado los nombres de la actriz y el director que rodarán la película Вызов (El desafío) a bordo de la Estación Espacial Internacional (EEI); también ha...

Los fetichistas de los objetos raros y el atrezzo cinematográfico apreciarán que alguien haya dedicado una página al vaso de Blade Runner en el que Deckard, el protagonista, se bebe un Johnny Walker como mandan los cánones detectivescos. Según cuenta la...

En Ready Player Me se pueden crear fácilmente avatares tridimensionales para VRChat, un mundo virtual al estilo Ready Player One, donde jugar y hacer el ganso. Si te gustó la película, pues ya sabes. No lo he probado muy a fondo...

Al principio de NOS4A2 (disponible en Prime Video) conocemos a Victoria «Vic» McQueen, quien está en el último curso de instituto cuando descubre que tiene poderes sobrenaturales. En concreto es capaz de viajar montada en su moto a través de un...

Bajo el curioso título de Can I Binge? tenemos aquí una web que te calcula cuánto tiempo necesitas para devorar cual bestia parda todos los episodios de una serie de televisión. Simplemente hay que escribir el título de la serie e...

Pues ya se ha terminado la segunda temporada de Para toda la humanidad (For All Mankind), disponible en Apple TV+. Y ya me ha le visto enterita, claro. La acción transcurre casi diez años después del final de la primera. El...

Por fin he visto Philip K. Dick's Electric Dreams, disponible en Amazon Prime. Es una serie de diez capítulos independientes que, como su propio nombre indica, adaptan –con más o menos licencias creativas– otros tantos relatos de Philip K. Dick. Así...

En Musement han creado un vistoso mapa con 34 lugares ficticios que se pueden visitar en España, utilizando el formato «plano del metro». Si suena un poco raro ir de Rocadragón a Naboo o de Brokilón a Monteperdido saltando de universo...

The Americans (disponible en Prime Video) empieza en enero de 1982 justo cuando Ronald Reagan acaba de tomar posesión como cuadragésimo presidente de los Estados Unidos. Elizabeth y Philip Jennings son dueños de su propia agencia de viajes, viven en una...

En este vídeo de hace unos cuantos años, Penny Juday, más conocida como «la archivera de Star Trek» enseña orgullosa la gigantesca colección de maquetas, planos, piezas de decorado y otros artilugios de la saga Star Trek. Sabemos que Penny falleció...

Una de las múltiples consecuencias de la pandemia de covid 19 ha sido que el estreno de Top Gun: Maverick se ha visto aplazado hasta el verano de este año. Pero @OnBeatMan ha aprovechado la espera para recrear el tráiler en...

Lo más divertido de las películas de la saga Star Wars suelen ser las batallas de naves espaciales. Tanto es así que hay remezclas resumidas de las películas en las que se han extraído todas las tomas con naves espaciales en...

Tráiler versión 2020 vs. Tráiler versión 1979, 35mm vs. Tráiler versión 1979, VHS/Laserdisc/DVD La versión modernizada del tráiler original de la primera película de Star Trek –del que existen varias versiones– está creado por William Renken; las escenas seleccionadas están reordenadas...

Ya está disponible en Apple TV+ la segunda temporada de For All Mankind, una de nuestras series favoritas de los últimos tiempos. No recomendamos ver este vídeo si no has visto ya la primera temporada. Como decíamos en su momento, es...

Barrenderos espaciales (Netflix) tiene lugar en el año 2092. La Tierra está hecha unos zorros y resulta ya casi imposible vivir en ella. La megacorporación UTS, sin embargo, ha establecido un hábitat orbital en el que aquellas personas que pasan sus...

Sé que llego con un par de eones de retraso pero por fin he visto El primer hombre. Me ha parecido mala y no me ha gustado. No tengo nada contra que me gusten películas malas, pero no ha sido el...

Una representación de R.U.R. Se cumplen estos días cien años de la primera representación de la obra teatral R.U.R. (Rossumovi univerzální roboti), Robots Universales Rossum. Publicada en 1920 en ella se usa por primera vez la palabra robot para referirse a unos...

El historial de reproducciones de los diversos servicios de vídeo que hay por Internet se considera muy conveniente por varias razones: Para revisar qué has visto y cuándo; es útil para quien le guste llevar un diario o revisar películas o...

NeXt (2020) es una serie de diez episodios con un tema de actualidad: una inteligencia artificial (IA) que toma conciencia y quiere conquistar el mundo. El bisho surge, cómo no, de los laboratorios de Silicon Valley de la mente de un...

Por fin he visto la serie Elegidos para la gloria perpetrada por Disney + y National Geographic, que cubre el periodo desde la selección de los Mercury 7 hasta unas semanas después del vuelo suborbital de Alan Shepard. Vaya desperdicio. Es...

Penrose es una preciosa historia animada con algunos objetos imposibles como escenario de la acción, en particular la Escalera de Penrose que data de 1958. Una versión muy popular es la que se ve en Ascendiendo y descendiendo (1960) de M.C....

{Sin spoilers más allá del tráiler, que de por sí ya destripa demasiado para mi gusto.} Me ha sorprendido gratamente cruzarme con Criada por lobos, una serie creada por Aaron Guzikowski y la producción y respaldo del mismísimo Ridley Scott (quien...

Pues por fin me he puesto al día con The Mandalorian (Disney +). Una serie que recupera en las dos temporadas que han salido hasta ahora buena parte del espíritu divertido y algo gamberro de la trilogía original de La guerra...

La foto con las cenizas de Scotty que se quedó en la EEI – Richard Garriott Richard Garriott, que en octubre de 2008 estuvo a bordo de la Estación Espacial Internacional (EEI) como astronauta privado (AKA turista espacial) acaba de revelar que...

A principios de 2049 un desastre no explicado –aunque se intuye que puede haber sido causado por nosotros mismos– va a terminar con la población de la Tierra en semanas. El personal del Observatorio Barbeau en el Ártico está siendo evacuado...

A principios de 1942 el comandante Ernest Krause, un veterano de la Armada de los Estados Unidos, recibe su primer mando. Como capitán del destructor USS Keeling, que usa Greyhound como indicativo de radio, es el máximo responsable de la protección...

The Liberator: One World War II Soldier's 500-Day Odyssey From the Beaches of Sicily to the Gates of Dachau. Por Alex Kershaw. Cornerstone Digital 2012. 466 páginas. El 10 de julio de 1943 el 157º Regimiento de Infantería de la 45ª División...

Un mecha, meka (del japonés メカ, meka, abreviación de メカニック, mecánico) es un vehículo de gran tamaño controlado por uno o más pilotos, que posee partes móviles tales como brazos o piernas, y varía en su uso dependiendo de la obra...

Por fin he visto la serie de Amazon El hombre en el castillo, libremente basada en la novela homónima de Philip K. Dick, y disponible en Amazon Prime. Y me ha gustado mucho. Aunque ahora he de repasar la novela, que...

Acaba de morir David Prowse, el actor británico que prestó su cuerpo a Darth Vader en la trilogía original de La guerra de las galaxias. Su cuerpo porque por algún motivo nunca aclarado entre ellos George Lucas decidió usar la voz...

Si te gusta Blade Runner o te gusta Vangelis estás de suerte: alguien de la interminable lista de fans con el nick Greendragon861 decidió crear una especie de remasterización de la banda sonora de modo que tuviera la misma longitud de...

Considerada una de las maravillas del cine de animación de todos los tiempos, lo que la mayor parte de la gente recuerda de Akira (1988) de Katsuhiro Otomo, es la famosa secuencia de las motos de los pandilleros en las calles...

Gambito de dama es una preciosa y relajante miniserie que narra la historia de Beth, una niña prodigio del ajedrez, que en los años 60 sale del orfanato en el que ha aprendido a jugar a escondidas de la mano de...

Este archivo inmenso, detallado y precioso sobre películas de cine y series de televisión que conocemos como IMDb, la sempiterna Internet Movie Database, nació tal y día como hoy hace 30 años. Su creador Col Needham arrancó el proyecto en el...

Álvaro de Metaball Studios ha actualizado su vídeo en el que muestra los tamaños de distintas naves de ciencia ficción a la misma escala para que podamos comparar. Es una actualización de uno que publicó a finales de 2015. Inlcuye naves...

Otra vida, disponible en Netflix, es otra de esas series que mejor olvidar. O que ver por las risas pero sabiendo a lo que vas. Ojo que esta reseña contiene algunos espoileres. La premisa es que en un futuro no muy...

...ya sean el incendio del Apollo, la pérdida del Challenger, la pérdida del Columbia, o durante los cien años de vuelo que llevamos, las lecciones que hemos aprendido los que volamos ahora están escritas con la sangre de otras personas. -...

He terminado de ver Away en Netflix tanto porque no me gusta dejar series ni libros sin terminar como por la fascinación de saber si la cosa mejoraba en algún momento. TL;DR: vaya truño. En versión más fina: no debo ser...

Este vídeo de Scientific American recopila fragmentos de los mejores vídeos del concurso Nikon Small World in Motion 2020. Son trabajos presentados por científicos y fotógrafos que combinan con arte el mundo de lo sumamente pequeño con la estética fotográfica en...

Bienvenido al año 2084. Una ciudad otrora orgullosa se ha convertido a un estercolero de crímenes, pecado y miseria. Una fuerza policial corrupta y un vasto submundo criminal protagonizan cada día una lucha salvaje por la supervivencia. Sin embargo, alguien intentará...

Bill & Ted Face The Music (2020) es la tercera película de la –digamos– saga de culto que comenzó con Las alucinantes aventuras de Bill y Ted (1989), que fue uno de los primeros papeles en largometrajes de Keanu Reeves, justo...

Gente de diversas épocas aparece misteriosamente en Oslo y trata de adaptarse al mundo actual en una serie intrigante y entretenida.

Tesla (2020), escrita y dirigida por Michael Almereyda, es la típica película que cualquier fan de Tesla querrá ver… y luego olvidar. En la IMDB está ya con una nota de 5,1 sobre 10, y ya sabemos que hoy en día...

He terminado de ver Away (Andrew Hinderaker, 2020), una interesante y recomendable serie de diez episodios que como deja entrever el tráiler trata sobre los peligros y sentimientos del primer viaje tripulado a Marte en futuro bastante cercano. La temática desde...

La franquicia Star Trek no para, y al estreno de la reciente Star Trek: Discovery y de los cortometrajes oficiales Short Treks hay que sumar ahora Star Trek: Lower Decks: diez episodios de animación que comenzaron a emitirse este verano en...

Tales from the Multiverse, de Møller, Tange y Smith (Estudio Thumblehead), es un cortometraje de animación muy divertido que combina cuestiones teológicas con el mundano mundo del diseño y la programación, pasando por los orígenes de la humanidad, la época de...

Ya me ha tocado recomendar a las amistades varias veces JustWatch, un servicio muy sencillo y útil que básicamente sirve para saber en qué plataforma online puedes ver cualquier serie o película. Y es que en esta era en la que...

High Score es una miniserie sobre la historia de los videojuegos en seis capítulos de unos 40 minutos cada uno. Naturalmente, al revisar lo que ha sucedido desde hace básicamente el medio siglo hay muchas lagunas. Podríamos decir que la serie...

Super Generic, de Di Lu, tiene el encanto de ser un poco autorreferente. Es una minihistoria sobre un personaje de animación que intenta cambiar su propio aspecto, todo ello contado desde una tercera perspectiva y en versión clip corto. El personaje...

De manera un poco sorpresiva pero totalmente agradable la CBS ha anunciado seis cortometrajes trekkers bajo el título genérico y autodescriptivo de Short Treks. Tienen una duración de entre 10 y 15 minutos y combinan personajes de diversas series, pero especialmente...

Estuve ayer repasando Predestination (2014), dirigida por los Hermanos Spierig, que es una de esas películas que no puedes interpretar correctamente con todos sus detalles hasta que la ves al menos por segunda vez. Está basada en Todos ustedes, zombies (1959)...

Quién se aburre estando sin poder salir de casa es porque quiere. La artista Lydia Cambron lo demuestra con fino sentido del humor al haber convertido su cuarentena y aislamiento durante la Covid-19 en el ambiente ideal para recrear el icónico...

Un humano modificado procedente de un planeta artificial arriesga su vida para volver al lugar donde se originó la humanidad. ¿Elegirá el amor o a su propia civilización? De Ji, de Ben Griffin, me ha gustado especialmente la ambientación y el...

Closer Than We Think (2017) es un documental de Brett Ryan Bonowicz acerca de la vida y el arte del ilustrador Arthur Radebaugh. Sus diseños de los años 60 acerca de cómo imaginaba que se integrafían las nuevas tecnologías en la...

Javier de La Nube de Coleto nos pasó un enlace a un completísimo análisis que ha llevado a cabo acerca de Cómo cambian las notas en la IMDb a lo largo del tiempo, extrayendo datos de la propia IMDb y de...

En esta pieza experimental de Longneck Films se combinan con gran habilidad clips antiguos de los lanzamientos de las misiones Apolo de la NASA con imágenes aviejunadas con un alto atractivo visual. Demostrando así algo que ya sabemos: que cualquier cosa...

Ian Hubert es un artista visual que ha publicado cómo se ha realizado la composición y efectos visuales del téaser de Dynamo Dream, y es totalmente impactante. Lo más increíble es que si a veces nos llama la atención el gran...

Nigel es un anciano que vive recluído, perseguido por su pasado y por el recuerdo de la familia que una vez tuvo… Hasta que un día llega un visitante inesperado y perturba su solitaria rutina. This Time Away es un cortometraje...

Alien 3. El guion no filmado. Por William Gibson, Johnnie Christmas y Tamra Bonvillain. Norma Editorial 2020. 17,58€. 136 páginas. Esta es la adaptación al cómic de un guión que en su momento escribió William Gibson para la tercera película de la...

La Fuerza Espacial de los Estados Unidos existe de forma independiente desde hace unos meses. Pero los creadores de The Office se han adelantado y rodado una primera temporada del «cómo sería» un nuevo ejército espacial de exploración no tan pacífica,...

En Upload cuando la gente va a morir puede elegir entre subirse digitalmente a un servicio de alojamiento eterno en realidad virtual o palmarla. Tras la primera impresión resulta que la cosa no está tan mal: el entorno es un hotel...

{Reseña sin spoilers} Megacorporaciones tecnológicas. Desarrolladores. Computación cuántica. Física. Algoritmos. Qubits. Programación. Libre albedrío. Determinismo. Secretos. Azar. Misterios. Conspiraciones. Incógnitas… Devs (Alex Garland, 2020) ha sido para mí una de las sorpresas de la temporada. Es una serie de ocho capítulos...

Flash, te quiero, pero sólo tenemos catorce horas para salvar la Tierra.– Dale Arden Gran alegría y alborozo me ha producido ver que StudiocanalUK ha anunciado la restauración de Flash Gordon en 4K, en lo que parece va a ser una...

Este vídeo muestra el proceso de reconstrucción de una película antiquísima (1888) utilizando todas las «armas» digitales disponibles hoy en día de la famosa película La escena del jardín de Roundhay: 20 fotogramas, capturados a unos 12 fotogramas por segundo para...

Los Filmumentaries de Jaime Benning son ediciones especiales de grandes películas de esas que nos gustan por aquí (básicamente: el duo Lucas + Spielberg) pero con comentarios acerca de todo tipo de historias relativas a su creación a modo de documental....

Pit Stop es un cortometraje de Raship Trikna realizado como trabajo de fin de curso en la Escuela Sheridan (Canadá). Es una historia muy corta sobre problemas cotidianos (ejem) de los astronautas que exploran lejanos planetas: cosas como naves que se...

Actualización (diciembre de 2022) – Hace tiempo que esta app ya no está disponible, pero se puede acceder a más o menos las mismas películas en PublicDomainMovies.info, del mismo autor. Estaba el otro día repasando algunas películas clásicas de Buster Keaton...

Llevaba tiempo queriendo ver La guerra de las corrientes (Alfonso Gomez-Rejon, 2017) que estuvo en el cajón de la productora un par de años hasta que llegó a las salas de cine. El título y el tráiler eran bastante prometedores y...

Estos adorables bichejos son los Momonsters, unos adorables personajillos de una serie infantil de animación 3D que se emite actualmente en Clan RTVE. Como tengo la suerte de conocer a parte del equipo de Big Bang Box que los ha creado...

El 11 de febrero de 1985 el control de la misión perdió inesperadamente el contacto con la estación espacial Saliut 7, que en esos momentos no estaba habitada. Ante la imposibilidad de retomar el contacto con ella las autoridades soviéticas decidieron...

En la primera escena de The Good Place Eleanor Shellstrop abre los ojos sentada en un sofá y lo primero que ve son unas grandes letras que le dan la bienvenida y que le dicen que todo está bien. Casi inmediatamente...

Tenía muchas ganas de ver Tales From the Loop, Historias del bucle, la serie basada en el universo imaginado por Simon Stålenhag en sus dos primeros libros. Pero lo cierto es que aunque me he visto los ocho episodios de la...

Esta curiosidad no la vi en su día, pero parece que alguien se entretuvo en crear una versión inmersiva (360°) del arranque de La guerra de las galaxias: una nueva esperanza, en versión 3D. Diría casi «versión Lego» pero parece que...

Tras haber estado moviendo el Top 10 de películas geek de la edición de 2005 –sí, los microsiervos llevamos muchos años dando la brasa– y por aclamación popular hemos decidido que es momento de actualizar la lista aprovechando estos días de...

Durante la presentación de Netflix en Argentina Reed Hastings, director ejecutivo de la compañía, ha confirmado que van a hacer una serie de El eternautaa. Si todo va según lo previsto se estrenará a finales de 2021 o principios de 2022....

Que el Enterprise 1701-D, la nave insignia de clase Galaxia de la Flota Estelar a es inmensa es algo que es sabido. Y no sólo por las imágenes que en algunos episodios y películas de Star Trek: La nueva generación dejan...

En esta casa somos muy «fanses» de los mundos de Simon Stalenhag. Así que nos alegra saber que la serie de Amazon Prime basada en Tales from the Loop ya tiene fecha de estreno, el 3 de abril de 2020. Tales...

Arthur Cauty tiene este precioso documental acerca de 20th Century Flicks, al que llaman «el último videoclub del mundo». Naturalmente, es probable que queden otros supervivientes, pero el carisma imbuído esta pequeña tienda es especial. Está en Bristol (Inglaterra) y lleva...

En ese pozo de entretenimiento y procrastinación infinito que es YouTube me crucé con este documental sobre la producción de las maquetas de Espacio 1999. Son sólo unos minutillos, pero permiten hacerse una idea de cómo se creaban las imágenes con...

El protagonista de Travelooper (Jennifer Sheridan, 2019) es un apocado joven que se enfrenta a sus propios miedos. Sin embargo, a veces suceden cosas que hacen que uno vea más cosas que le pueden hacer salir del «atasco» mental. Y todo...

Álvaro García de Metaball Studios ha subido a YouTube otra de sus increíbles animaciones en las que compara el tamaño de cosas, en este caso la altura de edificios emblemáticos de las películas, series y videojuegos más populares. Como se suele...

Supongo que a estas alturas ya no es un spoiler hablar de 1917. Pero como a continuación van algunos detalles de lo que sucede en el largometraje (sin desvelar nada relevante, eso sí), por si caso aviso. Y antes de que...

Me crucé por casualidad –más bien debería decir por algoritmos– con este viejo vídeo de Boing Boing TV en el que hay una breve pero estupenda entrevista a Syd Mead, el recientemente fallecido diseñador de los mundos de Blade Runner, Alien...

Cuando a 2019 apenas le quedaban unas horas fallecía en su casa de Pasadena, California, Syd Mead. Quizás el nombre no os diga mucho pero de su imaginación salió el aspecto visual del universo de Blade Runner y algunas de las...

Apenas terminada la Segunda Guerra Mundial el Ministerio del Aire del Reino Unido emitió una solicitud para el diseño de un bombardero estratégico con capacidad de llevar bombas nucleares que le permitiera enfrentarse a la realidad de un mundo en el...

Alexei Leonov en la Luna – Tall Ship Productions / Sony Pictures Television / Apple TV+ Mientras la NASA ultima los detalles para el lanzamiento del Apolo 11, la Unión Soviética gana por apenas unos días la carrera espacial al conseguir que...

Terminé de ver la segunda temporada de Marte, la serie de National Geographic (también en Netflix) que combina ficción del futuro cercano con entrevistas reales con grandes personajes del mundo de la ciencia. Al igual que la primera es una interesante...

Este cortometraje visual de Eric Whitacre se titula Deep Field: The Impossible Magnitude of our Universe y está inspirado por la famosa imagen de campo ultra profundo del telescopio espacial Hubble. El montaje tiene mucho de ciencia y también de arte,...

Esta batalla de bolas de nieve cinemática titulada «Snowbrawl» está grabada con un iPhone 11 Pro; es una pieza publicitaria de esas que da a conocer Apple de vez en cuando bajo el lema Grabado con un iPhone, que permite hacerse...

{Anotación libre de spoilers; los vídeos no tanto, así que si todavía no has pasado de los tres o cuatro primeros episodios de la serie… Mejor espera un poco.} Watchmen (2019) es una serie de Damon Lindelof con el mismo título...

Julius Horsthuis ha utilizado el maravilloso Mandelbulb 3D para crear otras de sus películas. Es un recorrido por fractales en el que se combinan matemáticas con un poco de arquitectura y los extraños y coloridos seres que habitan en el interior...

Bueno, pues ya estamos....

Este vídeo-flipbook se dio a conocer celebrando el #AlienDay en el canal Alien Anthology, con motivo del 40º aniversario de la mítica película de Ridley Scott, que como bien sabemos todos los fans fue este año. Se trata de un muy...

Michael Stevens, más conocido por Vsauce, preparó hace tiempo una serie documental para YouTube Premium acerca de la mente y el comportamiento humano desde el punto de vista científico. Y tal y como ha anunciado ahora va a ser completamente gratis...

Ser una celebridad tiene sus cosas, como aparecer en cameos en las películas y series de moda… Aunque no tengo muy claro si pagando o sin pagar, la verdad. En este caso Elon Musk, creador de Tesla y SpaceX –entre otras,...

Bajo el título MetropolisRemix se puede encontrar en YouTube esta «modernización» del largometraje clásico de Frit Lang de 1927 coloreado y doblado con voces de actores y actrices, pues el original era mudo y en blanco y negro. Es ciertamente un...

Undone (2019) es una miniserie de Raphael Bob-Waksberg y Kate Purdy, calificada como thriller psicológico que se ve en un plis-plás (8 episodios de 25 minutos), tiene una gran historia y toca un montón de temas interesantes: las consciencia, la existencia...

Mario es el enfermero jefe de una residencia de ancianos. Todo el mundo en su trabajo lo aprecia y respeta. También tiene una pareja con la que esperan su primer hijo. Pero un nuevo ingreso pone patas arriba todo su mundo...

Esta visualización de los colores de Blade Runner de Rick Proza muestra cómo son los colores promedio de las escenas de ambas películas; la original arriba y la secuela debajo. El tiempo transcurre de izquierda a derecha. Las fuentes son las...

Este año debido a eso de las vacaciones se nos pasó felicitar a todos los administradores de sistemas el último viernes de julio, como marca la tradición del Sysadmin Day. Pero para compensarlo he encontrado este divertido tráiler del Día de...

Tiene dificultades con las normas, señor Anderson. Usted se cree muy especial… Y que por algún motivo las reglas no están hechas para usted. Obviamente, se equivoca (…)– el jefe de Thomas Anderson Variety se ha apuntado un golazo con la...

Fernando Livschitz ha publicado esta peliculita acerca de un parque de atracciones un tanto diferente y caótico, en el que las cosas funcionan un poco de aquella manera. Son efectos especiales ingeniosamente resueltos y muy armónicos, llevados a cabo con gran...

The Boys (2019) es una impactante serie de superhéroes del lado oscuro un tanto fuera de lo común, con una producción más que decente, una cinematografía cuidada y un guión sobresaliente. Son ocho episodios de una hora que se disfrutan a...

Hay que reconocer que para el pedazo de truño de película que era la cinta de Stallone Demolition Man (Marco Brambilla, 1993) nos legó dos chascarrillos importantes para la cultura nerd de la ciencia-ficción de baratillo: las multas instantáneas por violación...

Nuevas apariciones estelares de las Venancia Lengüeta de la Internet moderna, las compañías más cotillas que «todo lo escuchan»: dispositivos, apps… Microsoft Contractors Hear Skype and Cortana Recordings(Tom’s Hardware) Apple contractors ‘regularly hear confidential details’ on Siri recordings(The Guardian) Google Admits Humans...

Las primeras películas de cine que todavía se conservan, que se remontan a finales del siglo XIX y principios del XX, eran pequeñas piezas de unos pocos minutos, rodadas con gran esfuerzo e increíbles limitaciones técnicas. Estamos acostumbrados a verlas a...

Unos 4.000 años antes de Cristo se lía parda en el paraíso cuando Adán y Eva comen la fruta prohibida. Enfadadísimo con ellos Dios los expulsa. Junto con ellos llegan a la Tierra Azirafel, el ángel guardián de la puerta del...

Me ha sorprendido muy gratamente Years and Years (HBO), una mini serie de seis episodios con todos los ingredientes de «futuro cercano pero inquietante» de Black Mirror pero combinado con una historia con muchos personajes, política y situaciones que viviremos –de...

Yo he visto cosas que vosotros no creeríais. Naves de ataque en llamas más allá del hombro de Orión. He visto rayos-C brillar en la oscuridad cerca de la Puerta de Tannhäuser. Todos esos momentos se perderán en el tiempo, como...

Empezando con Le Voyage dans la Lune (1902) muchas han sido las veces que el cine de Hollywood ha llevado a los seres humanos a visitar nuestro satélite natural, como repasa este vídeo de la Royal Ocean Film Society. Cubre desde...

Apollo 11 de Todd Miller es una de esas películas que cumplen más que de sobra con las expectativas creadas por el trailer. Cuenta la historia del Apolo 11 desde que el Saturno V es llevado a la plataforma de lanzamiento...

Hitchcock odiaba trabajar con niños («y con animales y con Charles Laughton», añadió) porque eran bastante impredecibles y difíciles de controlar para lograr el resultado deseado para sus películas. Sin embargo las niñas de Space Girls (dirigidas por Carys Watford) lo...

Robot & The Robots (de Ricard Badia) procede del estudio Animade y los protagonistas son unos instrumentos musicales que «se tocan a sí mismos», según sus creadores. Quizá porque fuimos niños de Barrio Sésamo y jóvenes de la primera época de...

Thomas Flight ha montado este interesante vídeo que compara unos siete minutos de escenas de la serie Chernobyl de HBO con las escenas reales¹ de Chernobyl de 1986, que acabaron viendo la luz tiempo después. El montaje da una idea de...

Normalmente dejamos caer por nuestro canal de Twitter los enlaces a los tráilers de los próximos estrenos de cine de nuestros temas favoritos, entre ellos la ciencia ficción, los documentales científicos y similares. Cada vez son más y llegan antes, así...

Esto tiene una pinta estupenda: The War of the Worlds: The Immersive Experience. Es un espectáculo medio teatral, medio parque de atracciones, medio virtual en el que se combinan un montón de escenarios y técnicas con La guerra de los mundos...

– Bien razonado, bien razonado.– Desde luego. Está claro que una cosa lleva a la otra.– Ye Olde Black Mirror El siempre hilarante elenco de actores y los sagaces guionistas de CollegeHumor nos deleitan en esta ocasión con una versión medieval...

Chernobyl (Craig Mazin, 2019) con Stellan Skarsgård, Emily Watson, Jared Harris. La esperada recreación del desastre de Chernobyl, sus circunstancias y consecuencias, con producción de la HBO y un magnífico elenco nos ha dejado esta auténtica maravilla de miniserie de cinco...

Los pocos minutos de este vídeo son envidia pura: es un recorrido por la Millenium Falcon: Smugglers Run, la atracción del Halcón Milenario «tamaño real» que hay en el nuevo parque temático Galaxy’s Edge, sin duda su atracción estrella. La estructura...

Este vídeo de Insider es de los que ponen los dientes largos. Está dedicado a todos los juguetitos, disfraces, muñecos y chismes que se pueden comprar en las tiendas del Galaxy’s Edge, el nuevo parque temático de Disney en California. El...

Interesante este tráiler de For all Mankind, una serie de once episodios producida por Apple TV+ y que se emitiría en otoño. (Ojo: no confundir con el documental de 1989 del mismo título). El principal gancho: tiene tras de sí la...

Este kit de Lego llamado simplemente El otro lado tiene una pinta estupenda: no solo lleva los minifigs de algunos de nuestros personajes favoritos de las últimas series de ficción; además es un escenario espectacular y no doble sino cuádruple. No...

The Planets es una nueva serie documental de la BBC Earth narrada por el físico Brian Cox, a quien ya conocemos y admiramos por sus excelentes trabajos divulgativos como Wonders of the Solar System (2010) Wonders of the Universe (2011) y...

Estuve viendo estos días la segunda temporada de The Orville, esa curioso hijo bastardo de Star Trek, una versión «diferente» creada por Seth MacFarlane, con buenas intenciones y regulares resultados. Y aunque la primera temporada me pareció fallida –pero permitía pasar...

The Augmentation of Douglas Engelbart (2019) es una documental de Daniel Silveira acerca de uno de los pioneros de la informática, visionario e inventor del ratón entre otras cosas. Fue una de las personas que realizó la primera demostración de una...

La evolución de las animación de imágenes generadas por ordenador (más conocidas simplemente como CGI) abarca ya tantas décadas como los ordenadores mismos. Se han usado en el mundo del entretenimiento para películas, series de televisión, documentales, videojuegos, anuncios y con...

Es imposible no ver el paralelismo entre el nuevo teaser tráiler de Star Wars: Rise of the Skywalker y la mítica escena de la avioneta fumigadora de Con la muerte en los talones (North by Northwest, 1959) del gran Alfred Hitchcock....

Este pequeño cortometraje de animación 3D dirigido por Andy Goralczyk titulado Spring es tanto una pequeña historia de «fantasía poética» como una demostración de poderío. Está creado con Blender 2.8, la última versión del popular software de 3-D. Parte de la...

En el canal de Sam y Niko han realizado varios montajes realmente espectaculares con las naves de Star Wars a su tamaño «oficial» según los documentos técnicos y películas sobre ciudades, autopistas y edificios. Lo cierto es que en las películas...

Según he leído en junio se estrenará Framing John DeLorean, una película-documental «dramatizado» de Don Argott y Sheena M. Joyce sobre el fundador de la mítica compañía automovilística cuya creación más reconocible y popular es sin duda el DeLorean DMC-12, más...

Por fin tuve ocasión de ver Unsane (Perturbada, 2018), una película medio de misterio medio de terror cuya característica más llamativa es que está grabada completamente con un iPhone 7 Plus. Y no es cosa de un aficionado: el director es...

Me ha encantado este segmento de los Cazadores de Mitos en Science Channel donde intentan comprobar si –como en las películas– sería posible montar una barricada inexpugnable detrás de una puerta con lo que haya a mano, básicamente muebles diversos y...

Air Hollywood es el nombre de un curioso estudio de cine especializado en aviones. Aunque sus instalaciones más famosas están en Los Ángeles también tiene otras en Atlanta y Victorville (California). En el vídeo de Insider se pueden ver muchas de...

– Dígale al comandante que hemos de aterrizar lo antes posible; hay que llevar a esa mujer a un hospital. – ¿A un hospital? ¿Qué es, doctor? – Un gran edificio lleno de enfermos, y a veces no hay camas.– ¡Aterriza...

Tras el título del documental Float (Phil Kibbe, 2019) parece haber una historia realmente apasionante acerca de la obsesión y la búsqueda de la perfección de los aficionados a los aviones planeadores con motor a gomas. Se trata de una variante...

Se abre el telón y aparecen un matemático, siete colaboradores y una cómica. ¿Cómo se llama el programa? ¡@orbitalaika_tve! Los lunes a las 22h, no te pierdas la 5º temporada del show científico en @la2_tve. ¡Estreno el 18 de marzo!➡️https://t.co/EWVX6nflEe pic.twitter.com/61h0Ss222n— Órbita...

Richard Vezina creó esta remezcla a modo de homenaje a Stanley Kubrick y su obra allá por 2003 y lo dio a conocer en 2011. Ahora con motivo de la conmemoración del 20º aniversario del fallecimiento del cineasta ha creado una...

Bastante impresionante: Los animatrónicos A1000 son la nueva versión de los A100 que Disney empezó a utilizar en la década de los 80. Se trata de un «método estándar» para la fabricación de figuras robóticas humanoides, que incluyen funciones eléctricas de...

Una cortometraje simpático para un viernes cualquiera: Un niño de 12 años y sus amigos viajan en en el tiempo de forma «secreta» con la esperanza de desentrañar el misterio que rodea a la muerte de una de sus madres… Con...

En Cinematic Names la programadora Mary Zam muestra una estupenda visualización interactiva con un curioso análisis estadístico sobre los nombres de la gente en las películas. En total ha utilizado 400.000 nombres aparecidos en películas y series de televisión de Hollywood...

Nunca sonrío si puedo evitarlo. Mostrar los dientes es señal de sumisión entre los primates. Así que cuando alguien me sonríe, todo lo que veo es a un chimpancé suplicando por su vida.– Dwight Schrute(The Office, 2005) La oficina de «The...

Harun Mehmedinovic y Gavin Heffernan tienen esta curiosa peliculita rodada sorprendentemente con permiso en un paraje único. Forma parte de la serie de fotografías y películas del Proyecto Skyglow acerca de los cielos nocturnos y los efectos de la contaminación lumínica...

Iteration 1 es un curioso y entretenido cortometraje de Jesse Jupini. Es como un cruce entre Cube, El Día de la Marmota y juegos como Cursor*10 o Chronotron. Trata de una chica que despierta en un extraño lugar en el que...

Epoch es un curioso trabajo de Kevin McGloughlin que combina imágenes de Google Earth cuidadosamente seleccionadas con algunos sonidos rarunos de la NASA. El resultado es (…) una representación visual de nuestra conexión con la Tierra y su vulnerable gloria. Nuestro...

¡Alimenta tu espíritu! Hoy en día hasta los clásicos se pasan a formatos de nueva factura tecnológica como el vídeo inmersivo en 360°. En este caso se trata de teatro: Hamlet, una de las obras cumbres de Shakespeare, presentada por la...

Este cortometraje que homenajea Regreso al futuro» se estrenó en 2015, que como es bien sabido es el año al que viajan los protagonistas de la película en Regreso al futuro II: 30 años después de la fecha del «presente» de...

Este año, en el que se cumplen 50 años de nuestra llegada a la Luna, va a haber un montón de material nuevo para conmemorar ese momento histórico. Pero sin duda uno de los más espectaculares va a ser el documental...

Una cena, cuatro comensales y una hipótesis: ¿viajaríais en el tiempo para matar a Hitler cuando tan solo era un bebé?– Todo por Galactus Nos pasaron un enlace a este simpático y bien realizado cortometraje de Mendufest Productions dirigido por José...

Echo de menos algún detalle más acerca de su construcción –aunque es posible que se estén guardando eso para otro vídeo– pero como alguien que hizo maquetas en sus años mozos me parece una pasada el trabajo que hizo Kayte Sabicer...

Es una política muy peligrosa. Alguien tiene que pararla. Una tarde el sargento de la policía David Budd evita un atentado en un tren con destino a Londres. Como recompensa a su acción su jefa lo nombra responsable de la protección...

Universe (1960) es un documental de Roman Kroitor y Colin que rodaron siendo parte de la segunda unidad de la National Film Board de Canadá. Ahora ha sido restaurado y está disponible en YouTube a buena calidad, con estupendo sonido y...

Merger es una película de Keiichi Matsuda, al que conocíamos por su [hiper]realidad aumentada, con una historia interesante, una técnica 360° que resulta siempre curiosa y unas interfaces virtuales espectaculares, que –quién sabe– quizá lleguemos a ver en los próximos años:...

Bruce W. Berry Jr ha creado este magnífico y relajante vídeo de vistas de la Tierra desde la Estación Espacial Internacional utilizando diversas técnicas interesantes para mejorar las imágenes. Lo ha combinado con música de Hans Zimmer (Journey to the Line)...

¡Estoy flipando, tío!– apropiado título para el minidocumental El repaso que hace Film Qualia de los efectos especiales por ordenador en las escenas psicodélicas del cine –especialmente tras la llegada de las imágenes por ordenador– es bastante completo, aunque se limita...

En este vídeo de BuzzFeed la experta en inteligencia artificial Kristin Lennox explica algunas de las cuestiones más relevantes acerca de si el cine nos la está mostrando correcta o incorrectamente el estado de la IA que nos rodea o es...

En esta featurette Netflix muestra a algunos de los creadores de Bandersnatch, el episodio interactivo con el que sorprendieron estas navidades como parte del universo Black Mirror. Aparecen algunos de los jefazos y también de los que más curro sin duda...

Anunciada casi por sorpresa hace unos días, Bandersnatch se presentó como «un evento Netflix» y luego como «película interactiva» bajo el paraguas de la distópica y excelente serie Black Mirror. Así que con una ambientación ochentera, un programador de videojuegos como...

Juan David Gómez ha creado SoundtrackMap, una herramienta de visualización que combina música, cine y series de televisión. El resumen es un enorme grafo donde se pueden ver las relaciones, hacer zoom y buscar por artista/película/serie. Básicamente relaciona los datos y...

TL;DR: los smartphones apenas aparecen en muy breves secuencias en las diez películas más taquilleras del año, aunque son dispositivos omnipresentes y absorbentes de nuestro tiempo en el MundoReal™. Este estupendo análisis de Nerdwriter titulado ¿Por qué hay tan pocos teléfonos...

Lizz Hobbs es la creadora de esta mini-película sobre el viaje de un biplano sobre los océanos y las montañas, a lo largo de muchos días y noches. La técnica es muy peculiar porque está montado cuidadosamente fotograma a fotograma con...

Hasta ahora habíamos visto documentales dedicados a empresas de Silicon Valley, software –pero generalmente videojuegos– (Nibbler, Donkey Kong, Tetris) o sistemas operativos (Linux). Ahora Radley Olsen ha ido un paso más allá con Off the Tracks, un documental de entrevistas sobre...

El mayor problema que Samy Kamkar (hacker y especialista en seguridad) ve a las películas de hackers es que suelen emplear interfaces visuales muy llamativas pero poco realistas (¡es cine! dirán muchos, no sin razón). En casi todas hay gráficos en...

Este cortometraje de Casey Cavanaugh titulado Peripheal busca el mérito de la originalidad: la película transcurre completamente a través del visor de una cámara Hasselblad 500c/m, de modo que es una especie de «película dentro de la película». Además tiene un...

Se nos ha ido Stan Lee, el genio que nos hizo soñar con superhéroes, que decía no saber mucho de ciencia y que dijo que aunque Spiderman y Hulk adquirieran sus poderes de arañas radioactivas y rayos gamma él no tenía...

Una de las escenas más desasosegantes de la historia del cine, al menos para mí, es aquella en la que David Bowman decide desactivar a HAL 9000, el ordenador que controla los sistemas de la Discovery, la nave en la que...

Scrambled, de Bastiaan Schravendeel y el equipo de Podel Animation es un simpático cortometraje de animación donde el protagonismo recae en un cubo de Rubik abandonado en una estación de metro, que consigue captar la atención de una joven que está...

No es precisamente barata (~10.000 eurazos) pero desde luego esa maqueta de la Discovery XD-1, la emblemática nave espacial en la que viajan los astronautas de 2001: una odisea del espacio tiene una pinta estupenda. La detallada y colosal réplica está...

Este cortometraje de Ghost+Cow Films es una especie de episodio de Black Mirror acelerado, que en diez minutos pasa de las situaciones cómicas del futuro que se nos viene encima a otras no tan agradables sino más terroríficas. Los protagonistas son...

Hasta la nave más famosa de aquella galaxia muy, muy lejana debió vivir ese día mágico en el que le entregaron las llaves a su primer propietario junto con al manual del propietario… ¡Mmmm, qué apetecible! Pues bien, ahora el manual...

Saga Norén, homicidios de Malmö. Una noche aparece lo que parece ser el cadáver de una mujer en medio del puente de Öresund, el puente que une Dinamarca y Suecia. Como en principio es identificado como el cadáver de una política...

Dirigido y escrito por Florian Brauch, Matthieu Pujol, Kim Tailhades, Yohan Thireau, Romain Thirion, con música de Vincent Govindin, Hybrids es un impresionante corto que busca concienciarnos acerca de toda la basura de todo tipo que estamos tirando al mar día...

{Ligerísimos spoilers, si acaso hechos históricos pueden considerarse «spoilers»} Al igual que a directores como Chistopher Nolan (Inception, Batman) o Mark Rosenberg (Approaching the Unknow) a Damien Chazelle, creador de First Man le gusta usar el mínimo de efectos especiales generados...

Aparentemente hay unas nuevas figuritas de acción que ya se puede reservar– y que representan a dos de nuestros astronautas favoritos de la ciencia ficción: Dave Bowman y Frak Poole, dos de los protagonistas de 2001: una odisea del espacio (Stanlek...

Este bonito vídeo de Great Big Story muestra cómo trabaja Ross MacDonald, que es un artesano del cine y la televisión. Su envidiable trabajo de ensueño consiste en la creación de los textos, dibujos e ilustraciones que se ven en las...

One Small Step es un precioso, entrañable y lacrimógeno cortometraje de animación de Andrew Chesworth y Bobby Pontillas (Taiko Studios), que cuenta la historia de Luna, una niña que sueña con ser astronauta. Está tan bien producida y con una animación...

Esta pieza de H1 Films comenzó como unas sencillas pruebas de procesamiento de imágenes digitales sin más, pero acabó en forma de simpático cortometraje a lo Black Mirror en el que los productos de los anuncios y los muñecos y personajes...

Jorge de Términos y Condiciones nos escribió para contarnos que acaban de lanzarse a una aventura llamada Derecho Ficción que básicamente consiste en una serie de diez capítulos de unos diez minutos cada uno en lo que se explican cuestiones legales...

Esta es la segunda versión de Cosmic Eye (2011/2018), un viaje cósmico en el MundoReal™ desde la cotidianeidad de una escena que parte de una sonrisa en el Googleplex de Silicon Valley a lo más grande e inimaginable… Y vuelta hasta...

Los arranques de los primeros minutos de algunas películas son auténticas perlas del cine que, siendo sinceros, valen tanto o más que muchas películas completas. También llamados intros u openings, dejan con la boca abierta, presentan al espectador el contexto del film...

Algunos trabajos por amor al arte son verdaderas joyas, además de preciosos homenajes. Este por ejemplo es un tráiler de Star Wars: una nueva esperanza en versión anime (animotion), obra de Dmitry Grozov «Ahriman». Menudos ojazos los de Leia… y Obi...

Esta película remasterizada por Guy Jones muestra el París de la Belle Époque de finales del siglo XIX. Dos segmentos son especialmente llamativos: el del final que muestra la recién inaugurada Torre Eiffel y uno anterior que muestra una cinta transportadora...

Jack Ryan, creado por Tom Clancy como protagonista de La caza del Octubre rojo, ha sido protagonista de varios libros, películas, e incluso juegos de ordenador. Y ahora ya tiene serie de televisión. O algo parecido por aquello de que ha...

No sé cómo se nos pudo pasar en su día Nikola Tesla y el Fin del Mundo (2015), una webserie de cinco episodios (de unos 5 minutos) que consiguió llegar a Amazon en algunos países (por desgracia no a España) y...

Desde el departamento de predicciones del futuro desde el lejano pasado nos llega Rendezvous in Space (Cita en el espacio, 1964), un curioso cortometraje documental sobre la exploración espacial producido para la Feria Mundial de Nueva York de 1964. Es especialmente...

El famoso historiador y divulgador de la ciencia y la tecnología James Burke protagonizó en 1978 este plano en su aclamada miniserie Conexiones para la BBC, concretamente en el episodio 8 (Eat, Drink and Be Merry). Hay quien lo ha denominado...

Con el breve título de 41 tenemos esta curiosa película indie australiana de bajo presupuesto con los viajes en el tiempo como tema principal. En mi caso ha sido una de esas que te encuentras por casualidad: es de 2012 y...

Farrokh Bulsara, que años después sería mundialmente conocido como Freddie Mercury, el cantante de Queen, nació tal día como hoy en 1946. Pero antes de ser Freddie Mercury el de Queen trabajó de maletero en el aeropuerto de Heatrowh. Con motivo...

Rumbo a lo desconocido (Approaching the unknown) es una película ambientada en un futuro no muy lejano en la que el capitán William Stanaforth viaja rumbo a Marte a bordo de la Zephyr. Le sigue tres semanas después la capitán Emily...

No sé si será la primera vez, pero desde luego que es muy notable la aparición de una publicación científica sobre el software utilizado para una película de ciencia ficción. Se titula Gravitational Lensing by Spinning Black Holes in Astrophysics, and...

A finales de diciembre de 1962 los únicos seres humanos que quedan con vida sobre la Tierra son aquellos que viven en las zonas más al sur de África, Australia y Sudamérica. Esto es debido a la contaminación radiactiva producida por...

Steve Young dirige este sencillo cortometraje titulado Pointless Time Travel en el que la máquina del tiempo es una caja de madera con un botón. Simple y directo. ¿Qué pasará al usarla? Pues resulta que es una de las pocas historias...

En Laughing Squid encontraron este vídeo de James Rolfe de Cinemassacre que permite solidarizarse con la a veces agobiante, interminable e insufrible tarea de seleccionar «algo para ver» en Netflix. Algo que a todo el mundo le ha pasado y que...

El número secreto es un cortometraje de Colin Levy que creó hace ya algunos años un equipo de estudiantes de Arte y Diseño del Savannah College – y al que dedicaron dos años completos de trabajo. El planteamiento es interesante: un...

Dust ha recuperado en su canal el cortometraje Last of You, de Dan Sachar, que tiene ya unos añitos pero no había visto pasar en su momento y ha sido una grata sorpresa. Se trata de una historia distópica sobre el...

El «alienés» es un lenguaje alienígena que aparece en muchos episodios de Futurama a modo de chiste recurrente. Matt Groenig y el equipo de guionistas y dibujantes lo utilizaron en decenas de episodios de la futurista serie de humor para incluir...

Este proyecto de financiación colectiva en Kickstarter del que nos avisó Amy como parte del equipo que lo ha creado y del que ya habíamos oído hablar son Réplicas de HAL 9000 de 2001: una odisea del espacio en forma de...

Se me hace complicado creer que no viéramos pasar este cortometraje en su día, pero es que no se puede estar en todo… O quizá es que nunca estuvimos allí. Room 88 es una simpática peliculita de Mike Booth rodado con...

La agencia Neomam y Angie's List firman siete GIF animados de películas ochenteras con el aspecto de los gráficos en 8 bits de la época "para inspirar al público con un estética retro y elementos de la cultura pop." En Angie's...
Por Nacho Palou -
31 JUL 2018

En el canal CGBros un equipo de creadores de la Universidad de Bournemouth University (Inglaterra) autodenominado The Spaghettify Team ha estrenado este cortometraje animado sobre un jovenzuelo que vive en su particular «cueva desordenada» y cuya intención de comerse un plato...

En esta casa nos encanta el mundo imaginado por Simon Stålenhag en Tales from the Loop y Things from the Flood, un mundo que recoge los recuerdos del autor de su infancia y adolescencia en una Suecia rural en la que,...

A los guionistas de Stranger Things claramente les encanta jugar con nuestras mentes y acaban de publicar este vídeo a modo de teaser trailer de la tercera temporada de la serie. Es sobre la inauguración del centro comercial Starcourt en Hawkins...

Desde el Tribeca Film Festival llega el prometedor tráiler de General Magic, un documental sobre una de las más extrañas y a la vez desconocidas startups de Silicon Valley, sin la que no existirían muchas de las cosas que hoy damos...

Las misiones espaciales del futuro no siempre serán sencillas y exentas de problemas. En este caso a los dos protagonistas de la historia la investigación de un cometa se complica y la misión queda comprometida. Poco a poco se descubre que...

Si todavía no has visto Jurassic World: Fallen Kingdom tal vez no quieras arriesgarte a ver la parodia de un spoiler; de otro modo esta versión animada de Toon Sandwich, con subtítulos en español, es bastante hilarante y "corrige" acertadamente algunas...
Por Nacho Palou -
10 JUL 2018

Arthropoda Iconicus Volume I: Insects From A Far Away Galaxy es el título del libro que saldrá a finales del verano de 2018 con algo más de 60 ilustraciones de insectos ficticios que Richard Wilkinson ha creado inspirándose en personajes y...

Gamma es un cortometraje de Dylan Harrington (seleccionado por el canal de ciencia ficciónDust) sobre dos hermanos que tras el fallecimiento de su padre deciden vender la granja familiar. Pero en esa granja hay algo raro. Un «algo» que aparece enterrado...

¡Cosas que pasan cuando se mezclan madres y transpondedores cuánticos en laboratorios de investigación! Las buenas intenciones convertidas en desastre espaciotemporal de proporciones universales. Tan tópico como hilarante. Es un cortometraje de Xavier Pijuan de Laboina Produccions; hay más vídeos en...

Por fin he podido ponerme con la adaptación a la televisión que ha hecho HBO de El cuento de la criada, la novela de Margaret Atwood de la que ya escribí en su momento. La premisa es la misma: los Estados...

Hyperlight es un cortometraje de Nguyen-Anh Nguyen. Impecablemente realizado a nivel de fotografía, efectos especiales y actores cuenta la historia de dos astronautas de élite que despiertan tras un accidente en su nave para descubrir que algo raro sucede. A partir...

El 12 de octubre de 2018 está previsto el estreno de El primer hombre, una película sobre la misión Apolo 11, que nos llevó por primera vez a la Luna, centrada en Neil Armstrong y el periodo comprendido entre los años...

En este vídeo de Wired el analista profesional de la policía científica Matthew Steiner repasa qué hay de realidad y qué de ficción en algunas icónicas escenas «estilo C.S.I.» de películas y series de todas las épocas. El veredicto es por...

Están bien esos aparatitos que nos miden las pulsaciones, las calorías y los alimentos que comemos, ¿eh? Pues si se les añadiera algo de inteligencia artificial y un poquito de domótica (además de un collar un tanto «peculiar») la cosa podría...

Este Regreso a la Luna en VR/360° de Nexus Studios es una pequeña gran superproducción entre Google – que ha aportado recursos de varios de sus departamentos, incluyendo el de los doodles diarios, Spotlight y «Arte y cultura», y la Cinémathèque...

Take my love, take my landTake me where I cannot standI don’t care, I’m still freeYou can't take the sky from me…– banda sonora de Firefly (2002) ZŌIC Studios ha preparado este sentido vídeo-homenaje a Firefly (Joss Whedon, 2003), una de...

A mediados del siglo XXI la humanidad dispone de la tecnología necesaria para viajar a las estrellas. Y como la Tierra está cada vez más perjudicada emprende la colonización de un planeta en órbita alrededor de Alfa Centauri (ya, ya). La...

Ahora que podemos respirar aliviados porque Amazon ha anunciado que The Expanse tendrá al menos una cuarta temporada puede ser un buen momento para echarle un ojo a este vídeo. An Overview of the The Expanse cuenta, usando imágenes de la...

Scott Park ha creado Eighty², un póster-homenaje al cine de la década de los 80, con decenas de personajes reinterpretados con su personal estilo. Casi se puede utilizar como juego, a ver cuántos adivinas. En su web se pueden ver a...

Stu Maschwitz ha creado este cortometraje titulado Tank, con reminiscencias de los videojuegos clásicos vectoriales como Battlezone (Atari, 1980), los Snowspeeders T-47 de El imperio contraataca (1980) o algunas de las naves y tanques de Tron (1982). El look antiguo incluye...

Este vídeo aéreo de Phil Holland titulado Above NYC es un lujo en lo que a calidad se refiere: está filmado a 12K de resolución. ¿Cómo se alcanza esa calidad? Lo hicieron montando tres cámaras RED Weapon Monstro VV de 8...

Acaba de morir el escritor y periodista estadounidense Tom Wolfe, autor de Lo que hay que tener, subtitulado Elegidos para la gloria, un magnífico libro que relata los primeros tiempos del programa espacial tripulado estadounidense, justo hasta el final del programa...

¿Para qué nos sirve conocer nuestro lugar en el universo? Puede que la respuesta sea para todo.– Neil deGrasse Tyson Neil deGrasse Tyson y Ann Druyan vuelven en una nueva temporada de Cosmos, anunciada para 2019, titulada Mundos posibles, en la...

Neo-Tokio: descomunales e infinitos rascacielos. Perspectivas interminables. Ingravidez sobrenatural. Música majestuosa… Con Awaken Akira Ash Thorp y Zaoeyo han querido homenajear a Akira (1988), el clásico de Katsuhiro Ôtomo que por cierto este año celebra su 30º aniversario. El vídeo –que...

En el siglo XXIII la humanidad se ha expandido por el sistema solar. Pero para variar está dividida en distintas facciones. La Tierra, gobernada por las Naciones Unidas, y la República de Marte son los dos grandes superpoderes, aunque dependen para...

¿Por qué la gente codicia esos estúpidos trozos de papel verde que guarda en sus carteras? Porque somos ovejas. Y las ovejas nos hemos puesto de acuerdo en que esos trozos de papel tienen valor.– Gilfoyle En la web de la...

¿Que si hacen falta mujeres en el espacio? Bueno, es lo mismo que «¿hacen falta hombres en el espacio?» Si vamos a enviar a un ser humano al espacio, deberíamos enviar al más cualificado. Y en ciertas áreas, las mujeres tienen...

En este episodio del podcast Los Crononautas #S02E22 aproveché para celebrar con Martín Expósito el 50º aniversario del estreno de 2001: Una odisea del espacio (una de mis películas favoritas) charlando acerca de todo lo que había de ciencia y tecnología...

Dice Pedro Duque, el primer y por ahora único astronauta español, que este vídeo, el primero grabado en 360º dentro de la Estación Espacial Internacional es «como estar allí otra vez». Grabado fundamentalmente por Paolo Nespoli con una cámara Vuze en...

Los Planos Star Trek de Gilso (Gerar Gillian) en su web-homenaje Cygnus-X1 recopilan decenas y decenas de planos y dibujos de naves, estaciones y áreas técnicas del universo Star Trek, obra del autor. Auténtica artesanía. Pero eso no es nada comparado...

El 11 de abril de 2018 se produjo una tormenta solar de clase X9. Fue la más intensa jamás registrada. Dos días después, el 13 de abril, la radiación alcanzó la atmósfera terrestre inutilizando los satélites y gran parte de los sistemas...

Los vídeos de Script to Screen son ingeniosos montajes que combinan escenas míticas del cine con los diálogos y guiones originales. Están sincronizados de modo que las palabras salen de las bocas de los protagonistas tal cual aparece el texto; el...

En este documento gráfico un poco retro se puede ver el trabajo del mismísimo Jim Henson y su equipo durante el rodaje de una de las más emblemáticas escenas de Dentro del laberinto (1986). También se pueden examinar algunas páginas del...

Hoy, 2 de abril de 2018, se cumplen 50 años de la premier de 2001: una odisea del espacio en el Cine Uptown de Washington, aunque para cuando se estrenó en cinco ciudades de los Estados Unidos el día 10, Kubrick...

{Sin spoilers más allá de lo visto en los tráilers, excepto si sigues los enlaces con los cuales te adentrarás en otros artículos.} Ready Player One (2018) de Steven Spielberg. Con Tye Sheridan, Olivia Cooke y Ben Mendelsohn. (Web oficial). Basada...

Samsung ha instalado la primera pantalla de cine led, llamada Samsung Cinema LED, en los cine Arena Sihlcity, en Zúrich. Se trata de la primera sala de cine comercial de Europa que utiliza una pantalla de grandes dimensiones (10,2 x 5,4...
Por Nacho Palou -
22 MAR 2018

Grabación de películas de bajo prespuesto – a partir de 01:11:00 Para el episodio de Los Crononautas #S02E19 –que por cierto es el último antes del parón de Semana Santa– estuvimos hablando de esa otra forma de hacer cine: grabando con un...

Interesante gráfica: según las estadísticas de Netflix que publica Recode no toda la vida del internauta está en el ordenador ni en el teléfono móvil. Y es que aunque aunque mucha gente se suscribe a la plataforma de alquiler de películas...

Este vídeo de Fame Focus revela algunos efectos visuales utilizados en la película de El vuelo (Flight, 2012), protagonizada por Denzel Washington. La versión CGI (producida por ordenador) del MD-80 que vuela invertido corrió a cargo de Atomic Fiction, y también...
Por Nacho Palou -
7 MAR 2018

No he visto la película Dunkerque de Cristopher Nolan aunque como buen aerotrastornado sí he visto algunas escenas en las que salen unos Spitfire Mk. 1, uno de los cuales tiene que aterrizar en la playa tras ser alcanzado por un...

La quinta temporada de Silicon Valley será estrenada a finales de este mes de marzo, por lo que su tráiler lleva ya un par de semanas en los tubos. Pero no ha sido sino hasta hace un par de días cuando...

La película Juegos de guerra (WarGames, 1983), la #2 en el Películas geek de Microsiervos, de algún modo que todavía está por ver inspira la serie interactiva #WarGames, que se estrena el próximo 14 de marzo. La primera temporada de #WarGames...
Por Nacho Palou -
5 MAR 2018

Esta iniciativa de Musement es un mashup entre Google Maps y más de 1.900 ubicaciones de películas desde los años 50 hasta nuestra época. Se puede ver en su web, bajo el título Las localizaciones de las películas más taquilleras. Basta...

Tangerine (2015), de Sean Baker Los interesados en cómo algunos cineastas están utilizando equipos de bajo presupuesto para crear «películas de verdad» encontrarán interesante este artículo de IndieWire: How To Be Unstoppable: Sean Baker and the Digital Filmmaking Revolution. Es toda una...

Viajar en el tiempo es fácil.Sólo tienes que… esperar. The Time Agent es una historia de viajes en el tiempo sencillamente original, metódica y preciosa. Está dirigida por el surcoreano Jude Chun. Es cierto que el formato no le favorece: un...

Siguiendo el storyboard original de J.J. Abrams para El despertar de la fuerza, Tim Gray ha recreado esta animación que interpreta cómo debería haber sido la primera escena, la que aparece justo después del texto en escalera. Visto ahora resulta complicado...
Por Nacho Palou -
8 FEB 2018

Este vídeo de Álvaro Gracia Montoya compara algunos de los monstruos del cine más conocidos: desde Mike Wazowski (de Monsters, Inc., 2001) hasta el exogorth o babosa espacial de la-no-cueva en la que se esconde el Halcón Milenario en Star Wars...
Por Nacho Palou -
1 FEB 2018

Un simpático y muy bien realizado cortometraje de Ben Rock que llegó hasta el canal de ficción Dust, en el que una pareja tiene una cita – aunque hay un pequeño detalle: alguien ha viajado desde el futuro gracias a una...

Los robots tienen un papel cada vez más importante en nuestras vidas. Tanto que a la gente del ROS Film Festival le ha parecido lo más normal del mundo crear un festival de cortos en el que los robots son el...

He aquí una herramienta de previsualización para renderizar y grabar con una cámara en movimiento imágenes con croma en tiempo real. Aunque todo parezca muy fluido y natural, se diría incluso que «fácil», lo cierto es que se necesita un montón...

Hace un par de días tuve la oportunidad de entrar en Esto me suena para hablar con el Ciudadano García del asunto de la basura espacial y todo lo que vamos dejando ciscado por ahí. Fue un poco a salto de...

Grace Rowe nos cuenta en The Sweetening la historia de una mujer un tanto deprimida que tiene acceso a la fase de pruebas de un software de realidad aumentada/virtual y donde le suceden algunas cosas inesperadas. Digno de ser prácticamente un...

Chris y Jack han producido esta parodia de la mítica no, mitiquísima escena de La cosa (1982), en la que los protagonistas reunidos en un momento de máxima tensión tienen que comprobar su sangre uno por uno para descubrir cuál de...

En el verano de 1982 Teo le dice a su hermano Óscar que ha encontrado un agujero de gusano. Óscar no se lo cree… pero quizás todo sea cuestión de tiempo. Einstein-Rosen es un corto dirigido por mi amiga Olga Osorio...

La gente considera que los episodios que encabezan la tabla son los más negativosde Black Mirror (temporadas 1 a 3). Los de la cola son los que despiertan menos negatividad Analizando palabras y términos publicados en las redes sociales se puede obtener...

La cuarta temporada de Black Mirror (Netflix) ha permitido empezar el año con alegría – si acaso enfrentarse a un amplio despliegue de futuros distópicos y chungos aparentemente muy, muy cercanos puede considerarse «alegría». Se nota ya cierta estupenda madurez en...

In the Gap es un corto de ciencia ficción y abierto a la interpretación escrito y dirigido por el sueco Albin Glasell y en el que “una mujer atrapada en una sala de servidores se enfrenta a su pasado.” Relacionado, Anomaly,...
Por Nacho Palou -
29 DIC 2017

Emma, de Daniel Limmer, es el corto ganador de la edición de 2017 del 15 Second Horror Film Challenge, un concurso internacional sin ánimo de lucro en el que se puede participar con un corto de terror que tenga esa duración,...
Por Nacho Palou -
28 DIC 2017

Este vídeo de Rodeo FX desvela algunos de los efectos visuales aplicados a la película Blade Runner 2049. Sobra decir que si no has visto la película existe cierto riesgo de spoiler, aunque el propósito del vídeo es promocionar el trabajo...
Por Nacho Palou -
26 DIC 2017

Con entusiasmo y efectos generados por ordenador un grupo de entusiastas ha recreado el duelo de espadas entre Obi-Wan y Darth Vader en Una nueva esperanza. La escena modificada apenas dura unos segundos, pero contrasta con la escena original y es...
Por Nacho Palou -
26 DIC 2017

“La espada láser de tu padre. Un arma noble para tiempos más civilizados. Tu padre quería que la tuvieras cuando fueras mayor. Con ella mató a decenas de niños.” Blake Harper en Fatherly, 8 Horrifying Realities About ‘Star Wars’ You Should Never...
Por Nacho Palou -
21 DIC 2017

Este vídeo es un proyecto personal hecho por dos hermanos entusiastas de Star Wars, Benjamin e Isaac Botkin. Isaac planificó y creó todo el aspecto visual con Lightwave 3D, mientras que Benjamin compuso la música original “con el objetivo de desarrollar...
Por Nacho Palou -
19 DIC 2017

“Un corto con un título largo.” Electronic Labyrinth: THX 1138 4EB fue el primer corto de ciencia ficción escrito y dirigido por George Lucas, en 1967. Entonces Lucas tenía 23 años y era alumnno de la escuela de cine de la...
Por Nacho Palou -
12 DIC 2017

La verdad: me esperaba algo más histriónico de The Orville. Es una criatura surgida de la imaginación de Seth MacFarlane – el conocido creador de Padre de familia y Padre Made in USA (además de la versión moderna de Cosmos, esa...

Al parecer Netflix tiene una lista de “cámaras aprobadas” a las que hay que idealmente hay ceñirse para filmar sus producciones, documentales, programas, series y películas que luego firma como Netflix originals. Salvo que aspires a que Netflix emita tu producción...
Por Nacho Palou -
11 DIC 2017

Este trabajo de Tim Sessler tiene unas espectaculares imágenes de Nueva York con ángulos que parecen imposibles. Además del mérito artístico lo interesante es que está completamente grabado con la cámara de un iPhone 8 utilizando la app FilmicPro. Otro de...

Yo soy Groot. El personaje de Guardianes de la galaxia, volumen 2 convertido en maceta para colocar plantas “de verdad”, o lápices: Baby Groot Figure Flowerpot — que no he encontrado en Amazon España, cachis. Bonus: El origen de Baby Groot en...
Por Nacho Palou -
5 DIC 2017

Cuando las sirenas suenan en la distancia una familia corre hacia el refugio... y ya nada volverá a ser igual. Este corto de un minuto (presentado al One Minute Short Film Challenge de Film Riot) de Gaspar Palacio y guión de Robert...
Por Nacho Palou -
4 DIC 2017

Me han encantado los carteles versión spaghetti western que ha hecho Timothy Anderson de las películas de la trilogía original de La guerra de las galaxias. Guerre Stellari, L'Impero Colpisce Ancora e Il Ritorno Dello Jedi están disponibles en un par...

Parallax es un curioso ejercicio de efectos visuales en el que los integrandes del New Balance Numeric Team se enfrentan a escenarios imposibles con sus skateboards. Nada es del todo real –o casi– y en la postproducción del vídeo se utilizan...

Hic sunt spoilers (aunque pequeños y creo que nada que no hayas visto en los tráileres). Ha pasado casi un año desde la aparición del demogorgon. En Hawkins el sheriff Hopper intenta mantener la tranquilidad mientras en el laboratorio Sam Owens...

Gran montaje este de la gente de la IMDb (Internet Movie Database) en el que se pueden ver comparados muchos planos de la segunda temporada de Stranger Things con los de películas antiguas. Si por «antiguas» aceptamos los clásicos de los...

Robby el robot, el auténtico, el original, ha sido subastado y vendido por 5.735.000 dólares – un precio que según dicen es el segundo más caro para un objeto de coleccionista de cine (sólo superado por el «vestido de la escena...

Nebulae, una meditación cósmica de Teun van der Zalm se presenta con una narración de Carl Sagan acerca de las nebulosas: Una nebulosa es una nube que oculta uno de los lugares secretos de la naturaleza. Es una guardería estelar, un...

Si sigues las aventuras de Once y sus amigos por Hawkins y del revés y tienes la edad suficiente como para acordarte de Balki Bartokomous y el «pimo Lary», los protagonistas de Primos lejanos –en inglés Perfect Strangers– este mashup, recientemente...

Utilizando una combinación de las Hololens de Microsoft y un pequeño sensor biométrico de estrés Robert Burke ha recreado una versión «jugable» de uno de los más viciosos videojuegos jamás inventados en nuestra galaxia, el que aparece en el episodio The...

Este estupendo cortometraje sobre un futuro tan cercano como distópico no es demasiado gore –al menos para lo que se suele ver por ahí– pero resulta en sobremanera inquietante cuando menos. Hay que verlo tal cual. . . . Stuart Russel,...

Star Trek: Discovery (2017, en Netflix) es la sexta serie de la saga creada por Gene Roddenberry que llega a las pantallas – si no contamos la serie de animación. Ahora mismo está en el parón de inverno, con 9 episodios...

De los siete DeLorean que se usaron en el rodaje de la trilogía de Regreso al Futuro sólo quedaron tres: uno que está en los Estudios Universal de Florida, otro en California y este que compró Bill Shea, un coleccionista que...

Mindhunter, de David Fincher (en Netflix) está resultando ser una de las mejores series de la temporada. Lo más interesante es que es una serie que por su ambientación y guión apenas necesitaría efectos visuales. Situada a finales de los años...

Cinemaps: an Atlas of 35 Great Movies es un libro en formato digital o papel (a cual más apetecible) de Andrew DeGraff, en cuya web pueden verse más de una decena de los trabajos que allí se puede encontrar: los mapas...

Hace mucho tiempo en una galaxia muy, muy lejana… Patrick Johnson, profesor adjunto en la universidad de Georgetown, discurre qué significa, física conocida en mano, “hace mucho tiempo” en la franquicia de Star Wars, La teoría más aceptada sobre la edad del...
Por Nacho Palou -
8 NOV 2017

Como hijo de la generación trastornada por Mazinger Z no puedo resistir la tentación de dejar por aquí el último tráiler de Mazinger Z Infinity, que se estrenará a mediados de enero de 2018 con motivo del 45º aniversario de la...

Julius Horsthuis define Fraktaal como Un cortometraje de ciencia ficción fantástico sin una historia. Lo cierto es que las imágenes generadas por ordenador, básicamente fórmulas fractales supervitaminadas, afinadas y coloreadas, tienen un aspecto increíblemente realista y sobrecogedor. De hecho, como explica...

Resulta un poco irónico que este libro titule sobre el alma de Blade Runner, pero como lo compensa con la parte artística se le puede permitir la licencia. Su título completo es The Art and Soul of Blade Runner 2049 y...

En Minute Physics han dedicado un vídeo a clasificar y desgranar los diferentes tipos de viajes en el tiempo que se suelen dar en la ficción, no tanto desde el punto de vista técnico de la física o las máquinas que...

Alejando Clavijo, miembro de Astromech (club de constructores de modelos de R2), ha fabricado esta réplica del droide R4-P17 con ayuda de su padre, utilizando principalmente aluminio y madera. Según nos cuenta Alejandro, “la semana pasada Lucasfilm aprobó formalmente el modelo...
Por Nacho Palou -
25 OCT 2017

Los amantes de Blade Runner disfrutarán de esta pieza de Soundworks Collection [libre de spoilers] dedicada al sonido de Blade Runner 2049: un elemento de la película con un proceso de creación complejo, técnicamente delicado y muy artístico explicado en varias...

En este delicioso episodio de Sixty Symbols la astrofísica Becky Smethurst utiliza el alfabeto de luces de la pared de Stranger Things para elucubrar una teoría física alocada acerca de si podría ser posible transmitir mensajes entre dos universos mediante un...

Olga Osorio es la directora y guionista de este cortometraje titulado reStart sobre un peculiar viaje en el tiempo que encierra a la protagonista (Marta Laralde) en un perverso bucle temporal. Todos sus intentos para salir de la pesadilla parecen infructuosos,...

Puntuada con un mísero 6,2 en la Internet Movie Database, cuando se estrenó Hackers, de Iain Softley, hace ya más de dos décadas (1995) todo el mundo andaba un poco flipadillo con lo de la «nueva era de Internet» y sobre...

En esta casa somos muy «fanses» del trabajo de Carolina Jiménez en películas que van desde Planet 51, su primer trabajo para cine, a GG y La liga de la justicia, películas en las que está trabajando actualmente, pasando por otras...

Hoy en día llamamos gadget a cualquier aparato electrónico, generalmente a aquel que muestra unas propiedades «inusuales o fuera de lo común», pero van desde un medidor de pasos a un soporte para el teléfono móvil en el coche o la...

Tears in Rain es un homenaje a Blade Runner con imágenes del Tokio de hoy en día «actualizadas a 2019» con todo tipo de retoques digitales, efectos y animaciones, así como alguna escena rodada ad hoc. No es nada oficial sino...

Esta película en stop-motion de Páraic Mc Gloughlin es un experimento visual en el que se recorren diversos lugares buscando algún elemento común: una persona, un vehículo, una farola… Artísticamente él lo interpreta como (…) Un viaje que explica algunas ideas...

The History of Television es una estupenda web que mediante imágenes y vídeos –con sus correspondientes breves descripciones– narra la historia de la televisión. Esto hace referencia tanto al concepto tecnológico de la TV como a su industria y contexto cultural....

Un giroscopio, un robot, un Slinky… Todo lo que aparece en este corto de animación son juguetes viejunos, de la «vieja escuela» o vintage que te dirían en un mercadillo. Una estupenda utilización de la nostalgia como recurso para enseñar un...

MovieMania es una vasta colección con cerca de 13.000 fondos de pantalla para teléfonos móviles con el cine y las series de televisión como motivo principal. Muchos son pósteres de películas, pero todos ellos sin letras. En cierta medida me recuerdan...

En 1977 el novelista Philip K. Dick (1928-1982) explicó en sus propias palabras cómo una revelación le mostró que podríamos estar viviendo en una realidad simulada, algo que quedó plasmado en muchas de sus obras en las que el mundo no...

Los ataques terroristas del 11 de septiembre de 2001 hicieron que muchas cosas cambiaron en el mundo, pero en Estados Unidos el efecto fue tan devastador que perdura hoy en día. Tanto fue así que durante meses –e incluso años– libros,...

Un precioso cortometraje de animación al más puro estilo videojuego escrito, animado y dirigido por Anthony Falleroni. Las herramientas para contar esta pequeña gran historia más simples, imposible: Photoshop + After Effects + Premiere. Tan adorable como entrañable, con una banda...
Después de muchos años descatalogado vuelve el Halcón Milenario de Lego versión ultimate collector series. Se trata de un pedazo de bicho de 7.500 piezas que una vez montado mide 21 centímetros de alto, 85 de largo, y 56 de ancho....

Al parecer estos próximos días del 1 al 3 de septiembre hay algo como una especie de «fin de semana de La Fuerza», como parte de la parafernalia que Disney está preparando para los fans en torno a Star Wars: los...

En esta casa esperamos Blade Runner 2049 con una mezcla de ansiaviva y miedo. Pro mientras llega su estreno podemos irnos contentando con los tres cortos que Warner Bros. irá estrenando de aquí a entonces y que sirven como nexo de...

Un pasajero de un tren que habla de una estación que no sale en los mapas pero que desaparece en cuanto lo acosas preguntándole por ella. Un robot programado para venderse a sí mismo pase lo que pase. Un explorador espacial...

Neil Armstrong y «Buzz» Aldrin, los nombres de los tripulantes del Apolo 11 que dieron los primeros pasos de la humanidad en otro astro, son razonablemente conocidos. Pero los de misiones posteriores, o incluso el del piloto del módulo de comando...

Entre los muchos detalles futuristas que hoy en día se han convertido en retro en esa maravilla del séptimo arte llamada 2001: una odisea del espacio hay un pequeño detalle que hará las delicias de los amantes de los gadgets en...

Tristram Geary escribió y dirige este trepidante cortometraje de acción sobre un mundo en el que los viajes en el tiempo se han hecho realidad pero son un tanto diferentes a lo que estamos acostumbrados. Y es que aquí no se...

Este cortometraje de Grant Harveyes titulado Tears in the Rain (Lágrimas en la lluvia) es todo un homenaje a Blade Runner, una suerte de precuela con tan solo un par de personajes, una cuidada ambientación, una estupenda banda sonora y unos...

La explicación está en esta escena de 90 segundos que no fue incluida en Terminator: 3, pero que ha circulado por ahí como los extras del DVD. Si lo piensas tiene tu lógica. De hecho me parece bastante brillante aunque quizá...
Chavdar Yordanov creó esta peliculita de animación en blanco y negro titulada simplemente Schrodinger’s Cat que dura apenas tres minutos y destila bastante humor negro. Es otra vuelta de tuerca a la famosa historia del gato más famoso de la física....

El 27 de octubre de 2017 veremos cómo Will Byers y sus amigos, familiares y vecinos de Hawkins vuelven de nuevo a enfrentarse a lo desconocido en la segunda temporada de Stranger Things, una de nuestras series favoritas de 2016. Quizás...

Prevista para otoño y limitada a 6000 unidades, esta edición de Terminator 2 remasterizada en 4K (UHD) en soporte Blu-ray vendrá acompañada de un antebrazo de T-800 a escala natural y firmado por James Cameron. Eso sí, el precio de la...
Por Nacho Palou -
20 JUL 2017

Dark Legacy, de Anthony Pietromonaco, es una de esas producciones no oficiales de Star Wars capaces de dejarte boquiabierto. En esta minipelícula de poco más de diez minutos Kia se enfrenta a su maestro Sith (el primero que veo, creo, que...
Por Nacho Palou -
19 JUL 2017

Me ha encantado Based on a True True Story?, una visualización de cómo de ciertas son algunas películas basadas en hechos reales. Aparte de un porcentaje global se puede explorar la película escena a escena ya sea haciendo clic en la...

Un día me desperté y lo vi todo en perspectiva… Fernando Livschitz de Black Sheep Films dirige esta pequeña pieza con mucha imaginación, tremendos CGI cuidadosamente creados y, cómo no, musiquilla pegadiza. Si te suena el estilo es porque alguna vez...

En la web MickStorm.com hay un algoritmo que genera pósteres de películas al azar. Si le das al botón Generar otro póster un rato verás que es un random más viejo que la tana. Según parece combina fotos con diversos textos,...

Las sencillas pero inquebrantables reglas del juego persecutorio entre Coyote y Correcaminos, la serie de animación creada por Chuck Jones en 1949. Se trata de una versión ligeramente extendida de la que sacamos por aquí ya hace diez años. Correcaminos nunca...
Por Nacho Palou -
4 JUL 2017

El vídeo Pixar Movie Evolution de Burger Fiction recopila escenas de películas de Pixar (y también de algunos cortos de la productora), desde fragmentos de Toy Story, y cortos anteriores como The Adventure of André y Wally B. (1984) hasta las...
Por Nacho Palou -
27 JUN 2017

Al igual que con tantas otras series de televisión los títulos de crédito de Silicon Valley (HBO, 2014) son uno de los aspectos más cuidados con el que arranca cada episodio. En este caso a lo largo de sus cuatro temporadas...

De If You Want to Get into Hard Sci Fi - Watch These 8 Movies, ocho películas para iniciarse en la ciencia ficción dura: Moon. Gattaca. 2001: Una odisea del espacio. Un amigo para Frank. Marte (El marciano). Ex machina. La...

Demostrando una vez más que no hacen falta espectaculares efectos especiales ni grandes presupuestos, este cortometraje de Ashley Cooper es básicamente un ejercicio de actuación entre los dos protagonistas, especialmente Eric Johnson («el viajero») sobre una historia de viajes en el...

El progreso depende del hombre irracional. Amazon Prime Video (el servicio de vídeo bajo demanda de Amazon para clientes de Amazon Premium) estrena estos días la serie Le Mans, dedicada a “la cuna espiritual de las carreras de coches”. La serie...
Por Nacho Palou -
13 JUN 2017

Hace poco el ilustrador brasileño Butcher Billy descubrió Black Mirror. La serie le causó tal impresión que se vio todos los episodios disponibles prácticamente seguidos. Y mientras los veía comenzó a hacer bocetos de estas portadas versión pulp de los capítulos....

Durante décadas Watchmen, la novela gráfica y obra maestra de Alan Moore y Dave Gibbons, se consideró sencillamente inadaptable al cine. Una historia tan larga y compleja, llena de personajes importantes, múltiples escenarios y una combinación de todo tipo de «ficciones»...

Thomas Lemandarin tiene montada en LCARSStudio47 una tiendecilla con láminas gigantescas de muchas de las naves de Star Trek, en la interfaz digital del LCARS, el sistema operativo de las series modernas. A pesar de los 69 euros por lámina (tamaño...

Sobra decir que si no vas al día con la serie Juego de Tronos este vídeo de HansoArt contiene spoilers: representa con dibujos y animaciones hechas a mano (grabadas en una única secuencia) las muertes de algunos de los personajes más...
Por Nacho Palou -
1 JUN 2017

El 12 de febrero de 1985 una serie de errores por parte de los controladores de la misión hicieron que la estación espacial Salyut 7 quedara inutilizada en órbita, aunque afortunadamente en aquel momento no estaba ocupada. La misión de Vladimir...

En Cosmos, Carl Sagan imaginaba la existencia de una Enciclopedia Galáctica, un vasto repositorio del conocimiento de muchos mundos. En Parallax, Adam Westbrook se imagina cómo sería la entrada sobre la Tierra en esa enciclopedia intentando ponerse en la piel –si...

Quienes disfrutan de las películas de David Ficher lo suelen hacer tanto por las historias como por los grandes detalles que en cierran. Y se trata de películas que no son necesariamente «de efectos especiales»… (exceptuando Alien 3 y poco más)...

The Most Beautiful Space Shots in Movie History es una recopilación de escenas de películas relacionadas con el espacio (entre otras, 2001: A Space Odyssey, Interestellar, Wall-E, Alien, Una nueva esperanza, Moonraker, Event Horizon, Encuentros en la tercera fase, Superman Returns,...
Por Nacho Palou -
26 MAY 2017

Esta imagen de 1954 compartida en Twitter por Andrew Wiseman revela al montaje físico con hilos, madera y la iluminación adecuada que resultaba en el famoso logo de Eurovisión que durante años aparecía acompañado del Te Deum de Marco Antonio Charpentier...
Por Nacho Palou -
22 MAY 2017

La Fox estrena en breve The Orville, una parodia bastante a degüello de Star Trek en la que incluso muchos de los personajes parecen extraídos, retorcidos humorísticamente y vueltos a poner en una especie de Enterprise tripulado por un equipo completamente...

Genius (2017) es una serie-documental de National Geographic acerca de la vida y obra de Albert Einstein, uno de los mayores genios científicos del siglo XX y de todos los tiempos – y si no el más grande al menos el...

Ayer se hizo público el trailer final oficial de Blade Runner 2049, que se estrenará el 6 de octubre de este año en todo el mundo. Esta circunstancia lleva una década angustiando al personal, especialmente a tanta y tanta gente que...

He aquí una de esas versiones raritas de los episodios clásicos de La guerra de las galaxias, en este caso sólo el metraje que incluye naves espaciales. En Una nueva esperanza son poco más de 8 minutos. Pero la cosa mejoró:...

Sobre Ghost in the Shell: El alma de la máquina se ha escrito mucho y aunque haya defraudado a bastante gente, crítica especializada y haya cosechado un pobre 6 y pico en la IMDB hay algo inequívoco en lo que casi...

The Bucket es una simpática peliculita tiene un comienzo con música épica y está protagonizada por los animales de un paraje desértico del sudoeste de Texas. Lo ha grabado la gente de The Field Lab y fue relativamente sencillo: simplemente meter...

A finales de julio y principios de agosto se celebrará en Los Ángeles el 44ª festival SIGGRAPH, un evento de unos cinco días en el que se combina la exhibición de nuevas técnicas en animación, interactivos, demos y gráficos con la...

El la web del museo esta maqueta de la nave nodriza de Encuentros en la tercera fase en la que pueden apreciarse algunos detalles peculiares que son muy difíciles de ver en la película, incluso en las versiones restauradas de más...

En Forbes han preguntado a unas 4500 personas si prefieren Star Wars o Star Trek, y este es el resultado resumido. Se puede ver el gráfico completo en el artículo original. En general el público (o el grupo de encuestados) prefieren...
Por Nacho Palou -
4 MAY 2017

Science Fiction Interfaces es un Tumblr dedicado única y exclusivamente a imágenes de calidad de todas las interfaces de la ciencia ficción a las que su autor ha tenido acceso. Naves espaciales, ordenadores, Estrellas de la Muerte… De todo y muy...

Tom Scott explica en este vídeo por qué todos los planetas de las series y películas de ciencia ficción parecen exactamente los mismos. Y si eres aficionado al género alguna vez habrás notado ese curioso parecido. Quizá la forma en la...

El último experimento en VR de Google se llama Tabel y es lo que podrían ser las películas de realidad virtual del futuro – o al menos de algún estilo peculiar. No es que sea la primera vez que se hace...

El 18 de marzo de 1965 Alekséi Leónov se convertía en el primer ser humano en dar un paseo espacial al salir de la esclusa inflable de la cápsula Vosjod 2 a las 8:34:51 UTC, aunque casi no lo cuenta. First...

Callejón sin salida [+12] es el título de un cortometraje del cineasta neoyorquino Paul Trillo que aceptó un reto casi imposible: grabar todo el cortometraje en un solo plano y con la única ayuda de un dron. Se trata de una...

Una imaginativa y simpática peliculita experimental medio de animación medio de imagen real, con cierto transfondo artístico-matemático y algo de metaniveles e incluso del espíritu de M.C. Escher se podría decir. Es una obra del holandés Johan Rijpma, quien tiene una...

Sólo sé una verdad… Es hora de que los Jedi se acaben. Venga, a salivar de aquí al 15 de diciembre de 2017 con este teaser tráiler y todo lo que nos irán soltando hasta entonces sobre Star Wars: Los últimos...

A Movie Poster A Day es un proyecto de Pete Majarich, quien se pasó todo 2016 publicando pósteres rediseñados de películas. No son 366 películas aunque sí 366 pósteres porque de alguna ha hecho más de una versión re-revisada del póster,...

Eran Amir es un artista que nos tiene acostumbrados a vídeos en los que manipula el tiempo y las imágenes. En esta ocasión ha creado algo que denomina cámara lenta rápida, un pequeño «espectáculo visual» en el que nada es como...

Desde 2007 el The Geena Davis Institute on Gender in Media recopila datos e información acerca de los patrones de género que se dan en la industria del entretenimiento como películas y otras producciones para cine y televisión. El objetivo de...
Por Nacho Palou -
9 ABR 2017

Acción, filosofía y estética en un remake que homenajea al clásico anime pero deja debates profundos en segundo plano.

Este delicioso vídeo de Zackery Ramos-Taylor compara algunas escenas de Rogue One con escenas de las tres películas originales de Star Wars, los episodios 4, 5 y 6. Viendo el vídeo cuesta creer que entre una y otras películas hayan transcurrido...
Por Nacho Palou -
29 MAR 2017

Caleb es un cortometraje de Amanda Mesaikos y Susanne Aichele que bien podría ser un episodio de la próxima temporada de Black Mirror – al menos deja esa misma sensación. Y además la producción y FX son más que dignos. Se...

Strange Beasts es un corto de Magali Barbé que utiliza un formato medio de publicidad-de-producto medio de entrevista-documental acerca de un videojuego de realidad virtual en el que se interactúa con unas simpáticas bestias animadas. Lo más divertido es que gracias...

Film Map es un mapa de películas, un callejero imaginario de la ciudad de Los Ángeles, donde se reúnen más de 900 títulos que reemplazan a los nombres reales. Todos los detalles del plano están sumamente cuidados, desde la tipografía hasta...

Este modelo 3D del Halcón Milenario que han preparado en Archilogic para Archdaily puede verse el interior de la nave más rápida de la galaxia desde cualquier ángulo: basta usar el ratón para desplazarse o bien elegir las posiciones preprogramdas (1,...

No se reproduce al revés ni está «grabado al revés» ni se le ha dado «la vuelta» al editarlo. Y además está grabado en una sola toma. Es sumamente ingenioso y tiene gran mérito por todo ello. Es una pequeña gran...

La colección de fotografías Fury Road Vehicles del fotógrafo australiano John Platt (también en Instagram) retrata algunos de los 150 vehículos utilizados en la película Mad Max: Fury Road antes de la filmación. O lo que es lo mismo, antes de...
Por Nacho Palou -
7 MAR 2017

Hace un montón de años conocí a un veterano estadounidense de la Segunda Guerra Mundial. Me contó que la guerra es una cosa horrible, que nunca deberíamos idealizar una guerra… pero que también me contó que estaba orgulloso de su participación...

Walk Away es un videoclip de David Ariew, una especie de viaje de un cosmonauta dentro y fuera de su nave, una especie de extraña combinación entre 2001 y Space Oddity. La música está muy bien y algunos de los escenarios...

Otro genial vídeo de Carolina J. Giménez, AKA @OKInfografía, en esta ocasión con la colaboración de Javier Santaolalla, en el que nos habla del uso del color en el cine, que dista mucho, al menos en una buena película de ser...

La amenaza de Andrómeda fue probablemente lo mejor que se hizo en el cine de ciencia ficción en 1971. Esta película dirigida por Robert Wise estaba basada en una novela de Michael Crichton de 1969 y ahora la han revisado en...

Figuras ocultas (Theodore Melfi, 2016) con Taraji P. Henson, Octavia Spencer, Janelle Monáe, Kevin Costner, Kirsten Dunst y Jim Parsons. (Trailer) Esta es la historia de tres mujeres: Katherine G. Johnson, Mary Jackson y Dorothy Vaughan que trabajaron en la NASA...

Si el mejor adjetivo para definir algunos robots y androides que hemos visto pasar por aquí es inquietante, qué decir describir a estos animales animatrónicos que los ingenieros y artistas de Nature construyen para infiltrarlos en los entornos naturales de los...

Creo que no seré el único que esté convencido de que todavía les falta algo. Pero teniendo en cuenta el estado actual de la cuestión, y sobre todo a raíz de los comentarios de las «caras familiares» que retornaron en Star...

Este vídeo de Industrial Light and Magic muestra cómo se realizaron los efectos visuales de la destrucción de Jedha en Rogue One y la batalla de las playas de Scarif. Relacionado: Algunos efectos visuales de Star Wars: El despertar de la...

Esta es la historia animada del Camarada Cominternov y el Ejercito Rojo que vuelan por el espacio hasta Marte para eliminar a todos los capitalistas del planeta –irónicamente– rojo. Se ve que la propaganda soviética no tenía fronteras, ni siquiera en...

Esta pieza de animación de Raphael Vangelis titulada Analogue Loaders dice ser un homenaje a las barras de progreso, en todos sus formatos, pero reimaginados como objetos analógicos en vez de digitales. Es una buena forma de recordar todo ese tiempo...

Probablemente es para que compres más merchandising… Pero en cualquier caso es interesante el estudio que Retcon ha hecho sobre la evolución de los uniformes de las diferentes series y temporadas de Star Trek. En esta evolución hay razones tecnológicas, como...

Según los expertos publicitarios de los Clio Awards que saben mucho de estas cosas, este anuncio de Einstein inspirándose con música de Lady Gaga al violín fue el mejor de la larga lista de los que desfilaron por el mayor escaparate...

En esta casa somos muy aficionados a los vídeos que nos cuentan cosas acerca de los efectos visuales de las películas, y sin duda ¿Cómo funciona el Pipeline de VFX? se va a convertir en uno de nuestros favoritos. En poco...

En una galaxia paralela, muy paralela... Este simpático y algo wtf corto animado de Juhász Márk es una adaptación libre, muy libre, de Una nueva esperanza en versión sin violencia, excepto “si te pones a fumar en una zona de no...
Por Nacho Palou -
27 ENE 2017

Este vídeo recopila algunas escenas de películas que no recurren a los efectos digitales sino a efectos especiales físicos incluso a pesar de que, muy probablemente, habría sido «más fácil» hacerlos por ordenador. Un ejemplo es la escena de la película...
Por Nacho Palou -
26 ENE 2017

La música de The Derevolutions sirve como acompañamiento a esta película de parkour titulada 2D RUN - MMP 3 (Mixed Motion Project) grabada desde un dron procurando que la cámara siga al personaje completamente desde la vertical, como si de un...

La gente aplaudiendo en el cine para celebrar la oportuna llegada de la caballería encarnada por Han Solo abordo del Halcón milenario. El público también reacciona con entusiasmo a la destrucción de la Estrella de la muerte, y aplaude al final...
Por Nacho Palou -
19 ENE 2017

Blade Runner 9732 es un proyecto de Quentin Lengele: una recreación del apartamento de Rick Deckard, el Blade Runner perseguidor de androides. En la simulación se utiliza el motor 3D de Unity 5.4 que es el mismo que hace funcionar muchos...

Nuestra ex-agente favorita de la CIA vuelve a la pantalla en la sexta temporada de Homeland, que en esta ocasión se desarrolla en los Estados Unidos. En unos Estados Unidos casi de ciencia ficción porque los preside una mujer, algo que...

Los efectos visuales en el cine son tan viejos como los mismísimos hermanos Lumiére; de hecho en aquella época (finales del siglo XIX) el mismísimo pionero Georges Melies desarrolló muchas de las ideas técnicas que se han utilizado durante décadas y...

Epoch es una de esas minipelículas que se ven mejor en pantalla gigante, alta resolución, sin luz de ambiente y con el sonido surround ajustado de forma generosa. Es obra de Ash Thorp y recuerda a algunas secuencias de 2001: una...

Una recopilación de secuencias de las diez películas que optan este años a los Premios Óscar en la categoría de efectos visuales: La llegada, Mi amigo el gigante, Captain America: Civil War, Deepwater Horizon, Doctor Strange, Animales fantásticos y dónde encontrarlos,...
Por Nacho Palou -
12 ENE 2017

Este reel de Oblique muestra algunos de los efectos especiales, gráficos generados por ordenador, simulaciones y composiciones 2D realizados para La llegada, una de las mejores películas de ciencia ficción del año pasado. Esto incluye tanto las naves espaciales de los...

¿Por qué un nombre con connotaciones negativas para un vídeo tan… Agradable? En cualquier caso ahí están los pequeños robots de Michael Marczewski realizando tareas aparentemente repetitivas al ritmo de la música, aunque a medida que pasa el tiempo la cosa...

La película Rogue One (2016) se sitúa cronológicamente justo antes del episodio IV de Star Wars que se filmó entre 1975 y 1976. Hay 40 años entre ambas películas, pero la narrativa de Rogue One hacía necesario recuperar a personajes de...
Por Nacho Palou -
10 ENE 2017

Cinema in Slow Motion de Jim Casey es una recopilación de decenas de escenas a cámara lenta de películas de todos los colores, desde los monos de 2001 hasta las piruetas de Deadpool. Solo está de más incluir Superman Returns, escena...
Por Nacho Palou -
9 ENE 2017

IRIS es un cortometraje de Hasraf «Haz» Dulull en el que las máquinas que nos rodean, a las que les hemos dotado de características quizá demasiado complejas y avanzadas para lo que merecen, comienzan a comportarse de una forma un tanto...

A pesar de ser una auténtica preciosidad y una de las naves más espectaculares y a la vez temibles del universo Star Trek, este Ave de presa Klingon (clase K’Vort) no se puede comprar en tiendas: es un modelo construido en...

He aquí una colección minimalista de Star Trek: incluye personajes, el Enterprise y algún paisaje. También algunos bocetos e ideas donde pueden quedar plasmados para siempre, como camisetas y tazas. (Vía Taxi.)...

Pues no hay mucho más que decir que lo que cuenta el título: Lord Aussem se ha tomado la molestia de crear una versión del Episodio IV de Star Wars pero con la peculiaridad de que cada vez que se dispara...

Lisa Yaszek, presidenta de la Science Fiction Research Association es una historiadora de uno de los géneros que más nos entretienen por aquí: la ciencia ficción. Pero ciencia ficción hay mucha y muy variada, así que en este vídeo dedica un...

Chris Maddison dedicó un mes completo para construir esta versión Lego de un Viper Mark II, el caza monoplaza de la Flota Colonial en la serie de televisión Galáctica: estrella de combate. Mide unos 82 cm de longitud y pesa unos...

Conseguí el papel acostándome con algún rarito... espero que fuera George [Lucas]. Pero después tomé demasiadas drogas y ya no me acuerdo.– Carrie FisherThe Princess Diares, Vanity Fair. El vídeo corresponde a la audición que hizo Carrie Fisher en 1975 para...
Por Nacho Palou -
28 DIC 2016

Time, de Liam Conner, es uno de los cortometrajes del canal Dust, dedicado a la ciencia ficción. Narra un día cualquiera de un niño y sus amigos mientras meditan sobre viajes en el tiempo – si te gusta el temas sabrás...

Me googleé a pelo. No lo recomiendo.– Carrie Fisher La actriz Carrie Fisher, que será recordada siempre como la princesa Leia Organa, falleció el 27 de diciembre de 2016 a los 60 años tras no superar un infarto sufrido el 23...

En la cuenta en Vimeo de Glass Distortion hay vídeos interesantes relacionados con el cine, como estas tres comparativas que hacen entre los storyboards orginales de una película y la filmación resultante y tal y como se vió en los cines....
Por Nacho Palou -
27 DIC 2016

¿Cómo nos relacionaremos con los robots? ¿Llegarán a ser autoconscientes y emanciparse de los humanos? ¿Qué significa ser humano en un futuro altamente tecnológico? Estas –entre otras– son las preguntas que pretenden plantearnos –que no necesariamente resolver– desde el Robotic Online...

La agencia de diseño Blind fue la encargada de crear los gráficos y las interfaces visuales de las máquinas y de los ordenadores que aparecen en la película Rogue One. El mismo estudio también se encargó de los gráficos que aparecían...
Por Nacho Palou -
26 DIC 2016

{Reseña 100% libre de spoilers a menos que lleves 40 años viviendo en una galaxia muy muy lejana.} A estas alturas todos sabemos que al final de Una nueva esperanza la Alianza Rebelde consigue destruir la Estrella de la muerte gracias...

Este cortometraje animado de Maxime Causeret es una curiosa exploración tanto visual como acústica con diversos temas de la química y la biología de fondo: desorden y caos frente a orden, formas inertes frente a células vivas, seres animados, rivalidad frente...

{Anotación patrocinada por el Reloj de la Muerte de Industrias Farnsworth.} Este episodio de 20 minutos [subtítulos en inglés] del que ya habíamos podido ver algún adelanto es el resultado del trabajo de un grupo de aficionados que lo han hecho...

Los Jedi se han extinguido, la República ha caído y en su avance el Imperio galáctico ha llevado el miedo hasta los confines de la galaxia.Perseguidos, los miembros de la República se han visto empujados a la clandestinidad. Sólo los miembros...
Por Nacho Palou -
23 DIC 2016

Barb’s Revenge es un simpático y breve corto (~ 1 min) producido con la técnica del stop-motion que mezcla la serie Stranger Things y las películas Cazafantasmas y Regreso al futuro. Vía Blog de cine. Relacion, Stranger things tendrá segunda temporada...
Por Nacho Palou -
23 DIC 2016

– Hace tiempo trabajaba en lo mismo que tú… Y era bueno.+ Las cosas eran más simples entonces Harrison Ford vuelve a interpretar a Rick Deckard en Blade Runner 2049, la secuela de la que probablemente es la película favorita de...

En Forbes, A Look At The Real Star Wars Universe, Desde la nieve y el hielo del planeta Hoth en El imperio contraataca al exuberante bosque de la luna de Endor en El retorno de Jedi, las localizaciones para Star Wars...
Por Nacho Palou -
19 DIC 2016

Los fans de Star Wars encontrarán divertida Star Wars Intro Creator: una página que genera la secuencia de tres planos del prólogo con textos personalizados (el opening crawl, en inglés). Se puede simplemente disfrutar o grabar como película para hacer un...

Un corto hecho por entusiastas de Star Wars que tiene como protagonista a Han Solo, el contrabandista favorito de la galaxia. Además de la cuidada producción y unos efectos especiales bastante logrados, Jamie Costa, en el papel de Han Solo, es...
Por Nacho Palou -
16 DIC 2016

El británico James Bruton hace robots. Muchos robots. También hace disfraces articulados y robotizados (como este disfraz del Iron Man Hulkbuster o este otro disfraz de xenomorfo) y a la vez desarrolla otros proyectos de ingeniería y de mecánica que explica...
Por Nacho Palou -
14 DIC 2016

Esta Llamada cuántica (Quantum is Calling) es un cortometraje-secuela de Anyone Can Quantum, otra pieza de Paul Rudd (más conocido como Ant-Man). El reparto es de auténtico lujo: está protagonizada por Zoe Saldana (Star Trek) y el mismísimo Doctor Stephen Hawking...

Dave Addey, que en su espléndida web Typeset in the Future ya nos deleitó con un excelente análisis acerca de Blade Runner. Hace unos meses preparó este vídeo que es una recreación de la máquina Esper que el protagonista utiliza para...

De los cracks de College Humor, en los que poderosa la Fuerza es, un vídeo que enfrenta al capitán Picard y a Darth Vader acerca de si es más nerd Star Wars o Star Trek. – ¿Quieres hablar de pseudociencias? Midiclorianos....

Bora Barroso editó este vídeo recopilatorio/homenaje a las grandes películas de ciencia-ficción sobre los finales del mundo tal y como lo conocemos. Formas apocalípticas en las que autores y cianeastas de las últimas épocas han imaginado cómo sería un mundo del...

Está haciendo las rondas el vídeo titulado Why Do Marvel's Movies Look Kind of Ugly? en el que Patrick (H) Willems argumenta que todas las películas del universo cinematográfico Marvel rodadas en digital –todas después de Iron Man 1 y 2,...

Ricardo de Creativa nos envió estos Pósteres alternativos minimalistas de series de TV, entre los que están los grandes éxitos de las últimas temporadas: The Walking Dead, Breaking Bad, Juego de Tronos… Casi podrías jugar a identificarlas si tapas rápidamente los...

Disney ha producido unos envoltorios para películas en discos Blu-ray y DVD que básicamente son del mismo tamaño que los antiguos LaserDisc de 12 pulgadas (30 cm, el mismo que los vinilos LP de 33 rpm). Los enseña Techmoan en uno...

El ingeniero que ayudó a electrificar el siglo XX y a inspirar lo inalámbrico, con cierta fama de «loco», no muy lejos de la genialidad.

Novae, una visión estética y científica de una supernova, Durante la explosión de una estrella, tal vez causada por un colapso gravitacional, su luminosidad pueden aumentar hasta en 20 magnitudes. Esto sucede durante las últimas fases de la evolución estelar de...
Por Nacho Palou -
22 NOV 2016

Tenemos el honor de anunciar que 1982, el fan film cortometraje-videoclip protagonizado por Mayor Tom, dirigido y realizado por Fran Gas y con el mítico Miguel Ríos como invitado de honor ya está disponible en su canal de YouTube – y...

Prityazhenie (Atracción) es una película de ciencia ficción rusa que se estranará en enero del año que viene, en la madre patria. De momento hay un par de tráilers (este otro es del verano pasado) con bastante buena pinta. Pero está...
Por Nacho Palou -
21 NOV 2016

Nunca sucede nada los domingos, o sí: On Sunday es un fenomenal corto de David Lea, quien prácticamente produjo la totalidad de la filmación por sí mismo, la cual protagoniza su padre....
Por Nacho Palou -
20 NOV 2016

{No hay spoilers aquí.} La llegada (Denis Villeneuve, 2016) con Amy Adams, Jeremy Renner y Forest Whitaker. Estamos ante una película inevitable de ver para todo aquel que difrute con la ciencia ficción, pues como se puede adivinar por el título,...

En la lista de YouTube Las aventuras no‑canónicas de Rick y Morty la gente de Adult Swim ha publicado una serie de micrometrajes de unos pocos segundos en los que muñecos de plastilina encarnando a Rick y Morty reviven aventuras de...

Adam Savage (Los cazadores de mitos) enseña en este vídeo de Tested una pequeña parte de la increíble, envidiable y fantástica colección de artilugios de cine (props, en la jerga) que atesora en su «cueva» el director Peter Jackson. Cosas de...

El 15 de enero de 2009 el capitán Chesley «Sully» Sullenberger, su copiloto Jeff Skiles, y las tres TCP que formaba la tripulación del vuelo 1549 de US Airways entraron en la historia de la aviación. Al poco de despegar del...

Los cómics franceses de Valérian y Laureline tuvieron gran influencia en Star Wars en cuanto a estética, personajes y eventos. Tal y como ya adelantamos el hace un año, en 2017 se estrenará la primera película Valerian and the city of...
Por Nacho Palou -
11 NOV 2016

New Atlas ha publicado una serie de tres artículos sobre los hackers en las películas de Hollywood de los años 80, 90 y 2000 que bien merece repasar: Hollywood and Hacking: The 1980s Hollywood and Hacking: The 1990s Hollywood and Hacking:...

En 2033 una misión internacional lanza a seis astronautas con destino a Marte. Pero durante el aterrizaje un fallo en el módulo de descenso hace que aterricen a más de 100 kilómetros de su punto de destino en el que los...

Man vs. Snake (2015) (El Hombre contra la Serpiente) es la historia de los récords de competición de Nibbler. Es un documental al más puro estilo de King of Kong (2008) o Ectasy of Order (2012) con los que incluso comparte...

Ko Hoshino es una joven padawan que bajo la tutela del maestro Jaan–Xu sufre de la consabida ansiaviva que lleva a muchos padawanes a cometer errores más o menos serios a pesar de los consejos de sus maestros… Y con eso...

Doctor Strange (Marvel Studios 2016). El doctor Stephen Strange es un brillantísimo neurocirujano, aunque todo lo que tiene de bueno como profesional lo tiene de malo como persona. Arrogante, engreído, egoísta… Lo tiene todo para resultar odioso. Pero toda su lamentable...

En un futuro cercano –en el trailer dice que en la actualidad, aunque eso es casi la parte más de ficción de la película– una sonda que trae una muestra desde Marte es capturada con el brazo robot de la Estación...

Esta película es tanto una laboriosa curiosidad técnica como una inquietante visión del panorama en la frontera entre Estados Unidos y México. Con más de 200.000 fotos por satélite Josh Begley montó un recorrido de uno a otro extremo de esta...

Netflix ha puesto a disposición de los fans de Black Mirror los soniditos del móvil del primer episodio de la tercera temporada, Caída en picado: Black Mirror Nosedive Ringtones (/Film)Sugerencia: elegir el archivo e ir directamente a Get Ringtone y Download...

Bastiaan Koch, diseñador y modelador 3D en Industrial Light and Magic, escribe, produce, dirige y filma el corto Follow The Camera (2015), que en realidad es una prueba de concepto de un largometraje que de momento es un borrador. La historia...
Por Nacho Palou -
26 OCT 2016

Hay belleza en el horror, la naturaleza seductiva de algo terrorífico, y en ningún lado está más presente que en el diseño de Alien de H.R. Giger. Un vistazo al trabajo del diseñador Hans Ruedi Giger, más conocido como H. R....
Por Nacho Palou -
26 OCT 2016

The Escape (con subtítulos en español) es una producción de BMW Films, de los BMW de toda la vida. La marca de coches estrenó su primera minipelícula hace ahora quince años, en 2001, con The Hire. Desde The Hire el actor...
Por Nacho Palou -
24 OCT 2016

Endure es un corto de Gautier Cloquet y Pablo Morales que bien podría ser un spoiler del fin del mundo: narra en tres minutos el último intento de la humanidad por frenar el calentamiento global allá en el año 2150 desde...
Por Nacho Palou -
21 OCT 2016

One Woman Army hace bueno su título en forma de cortometraje de acción con actores reales y toques épicos de videojuego. Lo más curioso: está grabado en buena parte con drones: casi todo el presupuesto (unos 2.500 dólares australianos) se lo...

Borgen (Danmarks Radio 2010-2013) Graves errores de los líderes del Partido Liberal y del Partido Laborista pocos días antes de las elecciones generales en Dinamarca llevan a Birgitte Nyborg, líder del Partido Moderado, a la posición de ver factible formar gobierno...

¡Es un spoiler! Las rebeliones se fundamentan en la esperanza pero la esperanza de la gente de GameSpot es haber acertado con el orden de las escenas: este supercorte reúne todas las escenas conocidas a través de los tráiler de Rogue...
Por Nacho Palou -
17 OCT 2016

Por un lado, la BMW Motorrad Vision Next 100, un modelo conceptual de la marca alemana que bien podría pasar por una de las motos de luz que Flynn, Tron y sus amigos usaban en la primera película. Por otro lado, unos...

Liberty Games preparó para su blog una infografía explicando 12 razones para permitir a los empleados jugar en el trabajo. Lo cual unido a los fines de semanas de tres días comienza a parecerse un poco más al paraíso – o...

El vídeo de Bart van Dijk utiliza la técnica de stop-motion en versión supersuave, cual Scottex, para documentar con movimiento el montaje de la Estrella de la muerte de Lego —el set 75159 de 4016 piezas. El resultado es una animación...
Por Nacho Palou -
11 OCT 2016

El Centro de Conservación Audiovisual Nacional de EE.UU. forma parte de la Biblioteca del Congreso; físicamente está en un antiguo búnker en Culpepper, Virginia. Originalmente servía como refugio militar para el Presidente en caso de ataque nuclear y también como almacén...

Un anticipo de Planet Earth II, la serie de documentales sobre naturaleza narrada por David Attenborough que se ha filmado en más de 320 territorios de 64 países diferentes a lo largo de los últimos cuatro años, desde que se iniciase...
Por Nacho Palou -
11 OCT 2016

El público está como loco con el tráiler de la última entrega de Star Wars: The Old Republic, de la expansión Knights of the Eternal Throne, que hasta ahora no había tenido ocasión de ver. Y lo cierto es que aunque...
Por Nacho Palou -
10 OCT 2016

Tan importante como las leyes de la física, la relatividad y la mecánica hay un concepto subyacente la física, la computación e incluso la filosofía: la causalidad. Las causas van antes que los efectos. Y punto.

El 21 de octubre de 2016 Netflix estrenará la tercera temporada de Black Mirror. Constará de seis capítulos, aunque ya se sabe que habrá, salvo que las cosas se tuerzan mucho, una cuarta temporada de otros seis ya que en realidad...

Westworld (HBO), que acaba de comenzar su emisión, es una de las series más esperadas de la temporada. Básicamente versa sobre todo lo que sucede en un futurista «parque de atracciones» en el que los muñecos animatrónicos han evolucionado hasta ser...

Si hay una serie para la que sea realmente adecuada una versión en 8 bits esta es Stranger things, cuya acción transcurre en los Estados Unidos de los años 80 en pleno boom de la Atari 2600 y juegos como Dragones...

Netflix estrenó ARQ, el primer largometraje de Tony Elliott que los aficionados a los viajes en el tiempo han de ver por completitud pero que dejando aparte la cuestión cronoviajera tampoco aporta gran cosa. ARQ es básicamente El día de la...

Star Wars: Liberation es un corto «casero» que en apenas diez minutos relata un episodio que bien podría situarse justo antes del episodio IV: Una nueva esperanza, el mismo espacio que ocupará Rogue One. Se trata de un magnífico trabajo de...
Por Nacho Palou -
22 SEP 2016
El ojo de la mente fue un plan B de George Lucas para continuar la saga de Star Wars en modo bajo presupuesto en el caso de que la primera película, Una nueva esperanza, fracasara en taquilla. La historia había sido...
Por Nacho Palou -
20 SEP 2016

Soy perfectamente consciente de que no son más que una artimaña del lobby juguetero para aumentar nuestra ansiaviva de comprar merchandising de Rogue One, pero llevo un rato partiéndome de risa y buscando referencias a otras películas en los cortos de...

Súbitamente aparece una nave sobre París y comienza a engullir todo a su paso. El corto es el trabajo de fin de curso de un grupo de estudiantes y está simpático. Y por una vez la ciudad caída en desgracia no...
Por Nacho Palou -
15 SEP 2016

Calificada como «la más precisa escena de hacker jamás rodada» este momento de la octava temporada Castle (episodio 8) podría pasar a los anales de la informática más bien como la mayor serie de WTFs encadenados de la historia del hacking....

Infinitude es una meditación sobre la evolución cósmica de la energía y la materia con el paso del tiempo. El trabajo de Scott Portingale es visualmente muy atractivo, especialmente si puedes verlo tranquilamente a oscuras en una gran pantalla 2K o...

Actualización (17 de febrero de 2026) – ¡Oooh! El vídeo lo borraron. Tal día como hoy, un 8 de septiembre pero de 1966 se emitía en la televisión estadounidense el episodio piloto de una nueva serie de «aventuras espaciales». Se llamaba Star...

El astrodroide R2-D2 bien podría considerarse el héroe del universo de Star Wars: «ha salvado a los otros “héroes”, ha transportado información vital y ha aportado el humor necesario en una galaxia muy muy lejana en la cual las cosas no...
Por Nacho Palou -
7 SEP 2016

George Lucas fundó ILM (Industrial Light & Magic) para que llevase a cabo los sofisticados efectos especiales que exigía la trilogía original de Star Wars. En ILM también se encargaron, como no podría ser de otro modo, de los efectos especiales...
Por Nacho Palou -
7 SEP 2016

The Enchanted Drawing de James Stuart Blackton, estrenada el 16 de noviembre de 1900, es considerada como la primera película que incluyó una secuencia grabada siguiendo la técnica del stop-motion o «animación fotograma a fotograma». Es precisamente esa la película que...
Por Nacho Palou -
5 SEP 2016

Este experimento es un muy digno tráiler creado para la película de ciencia-ficción y terror Morgan, que se estrena este mes. La historia es acerca de una «solucionadora de problemas» contratada como consultora por una empresa altamente secreta debe decidir si...

Madmax. El niño resucitado. El huerto de calabazas. El palacio. La tormenta. El renacuajo. La cabaña secreta. El cerebro. El hermano desaparecido. ¿Serán estos quizás los títulos de los capítulos de la segunda temporada de Stranger Things? Pues podría ser. Pero...

Esta colección se llama Star Trek Forever y la va a emitir el próximo 2 de septiembre el servicio postal de los Estados Unidos con motivo de la conmemoración del 50º aniversario de la serie de ciencia-ficción más famosa de todos los tiempos.

Un cortometraje que muestra, quién sabe si satíricamente o como fiel relato de la vida cotidiana, cómo de rápidas y vertiginosas son algunas relaciones sociales de quienes están adaptados a las tecnologías de hoy en día.

Thomas Jerome Newton es la identidad que adopta un extraterrestre que llega de Anthea, un planeta que sufre una terrible sequía, con el objetivo de llevar agua a su planeta. Pero en cuanto Newton comienza a conocer las costumbres terrestres las...

Rich Williamson preparó Kenobi: A Star Wars Story Teaser, un montaje con títulos de Star Wars y el metraje de diversas películas sobre el que podía ser el relato del origen de Obi-Wan Kenobi, el maestro Jedi. Un título al que...

En su relato corto La historia de tu vida Ted Chiang cuenta la historia de la doctora Louise Banks, una lingüista que ha de desentrañar el idioma de unos extraterrestres que visitan la tierra. El relato va desvelando como cambian sus...

El vídeo de Vox Media, How Stranger Things got its retro title sequence, está dedicado a los créditos de inicio de la serie Stranger Things diseñados por Imaginary Forces: cómo se hizo el título (proceso que incluye papel de acetato y...
Por Nacho Palou -
17 AGO 2016

Entre otras cosas Mary Jackson, Katherine Johnson y Dorothy Vaughan ayudaron a la NASA a no quedarse definitivamente atrás en la carrera espacial al ayudar a calcular la trayectoria de la cápsula Friendship 7 en la que John Glenn se convirtió...

TK-436: A Stormtrooper Story es un corto hecho por entusiastas de Star Wars. La historia profundiza en la vida de un soldado imperial, «examina el trauma de combatir en una guerra civil galáctica», resumen en io9. En opinión de los directores...
Por Nacho Palou -
15 AGO 2016
Tal vez el pajarillo de la cabina no sea muy buena señal… Alex Kavutskiy y seis de sus amigos (relacionados de algún modo con el mundo de la comedia) repasaron Aterriza como puedas (Airplane! 1980) tomando cuidadosas notas sobre todos y cada...

Aunque los avances en electrónica permiten hoy en día construir R2-D2 a control remoto en las seis primeras películas de la saga de Star Wars este simpático robotijo estuvo interpretado por el actor británico Kenny Baker, quien acaba de morir a...

Igual que sucedió en la trilogía original, y según la IMDB, James Earl Jones volverá a prestar su voz a Darth Vader en la versión original de Rogue One. (Y, como sucedió también en la trilogía original, quién está metido en...
Por Nacho Palou -
12 AGO 2016

El mundo se desbarata. Las banderas del Imperio ondean por toda la galaxia. Tras un avance y un mini cómo se hizo este es el primer tráiler de Rogue One: Una historia de Star Wars, película que llegará a los cines...
Por Nacho Palou -
12 AGO 2016

A final de año se podrá ver Arrival, una película de Denis Villeneuve (Enemy, Blade Runner 2) en la que una experta lingüista (Amy Adams) se enfrenta a la labor de determinar si unas naves alienígenas que han llegado a la...

Godzilla en 1954 – Toho Company Ltd En la película original de 1954 Godzilla medía 50 metros de altura, un tamaño escogido para que fuera más alto que cualquiera de los edificios de Tokyo en aquel entonces. Pero con el paso del...

Tom Ward, diseñador gráfico e ilustrador, repasa algunos personajes del cine y de la televisión de los ochenta y los reinterpreta con simpatía y estilo para traerlos a la era de los selfies y los hoverboards. Es inevitable echar de menos...
Por Nacho Palou -
4 AGO 2016

Matt McEntegart admite que no sabe dibujar y que no tenía experiencia previa como diseñador. En cambio, explica en Creating a Supercar from Scratch, modeló las formas exteriores de su supercoche Vaydor directamente en espuma. La talla sirve como molde para...
Por Nacho Palou -
2 AGO 2016

De la nota de prensa de la Mars Mission corporation y de la International Mars Science Foundation, embargada hasta 2033: Londres, 9 de mayo de 2033 La nave espacial Dedalus despegó a las 9:47 UTC de la plataforma 39A del Centro...

Con subtítulos en inglés. Dan Perri es diseñador de títulos de crédito. Enamorado de las tipografías desde los doce años, comenzó diseñado carteles para supermercados («bolsa de patatas a 0,99») y después cartas para restaurantes; hasta que consiguió llegar gasta el...
Por Nacho Palou -
1 AGO 2016

En el pequeño pueblo de Hawkins, Georgia, la vida es de lo más tranquila mientras 1983 llega a su fin; es el típico pueblo estadounidense en el que las emociones más fuertes se corresponden con los partidos del equipo del instituto....

Si se combinan en una enorme base de datos todos los guiones de la serie y películas de Star Trek y se clasifican los personajes y los diálogos que mantienen unos con otros el resultado es esta bonita visualización interactiva: Star...

Cinesift utiliza datos principalmente de The Movie Database y las valoraciones de público y críticos especializados del Tomatómetro de Rotten Tomatoes, la legendaria IMDB, Letterboxd y Metacritic para mostrar en un sencillo buscador la valoración combinada de todas las películas de...

Este largo pero interesante vídeo es una mesa redonda con varios ingenieros y técnicos de cine que cuentan en primera persona los últimos secretos sobre el funcionamiento de BB-8, en entrañable robot de El despertar de la Fuerza. Y es que...

Recién presentado en la Star Wars Celebration Europe 2016 y a medio camino entre un teaser trailer y un making of Rogue One: A Star Wars Story – Celebration Reel cumple perfectamente su objetivo de mantenernos salivando mientras esperamos el estreno...

El 29 de junio de 1985 el piloto Randy Mamola montó en su Honda de 500 cc la primera cámara a bordo de una moto de MotoGP capaz de retransmitir la carrera en vivo y en directo y desde un punto...
Por Nacho Palou -
16 JUL 2016

Gary Hustwit, cineasta autor del documental Helvética, entre otras producciones, está preparando el documental Rams, «el primero dedicado al legendario diseñador Dieter Rams» debido al carácter reservado del Dieter. Hustwit obtuvo en Kickstarter la financiación para producir Rams que se publicará...
Por Nacho Palou -
14 JUL 2016

En esta película de técnica stop-motion creada por un fan con infinita paciencia (Jürgen Kaiser) se narra la historia de diversas razas de la federación luchando contra una forma de vida alienígena que destruye toda vida orgánica que encuentra.

La historia del famoso accidente de aviación de Chesley Sullenberger «Sully», nuestro piloto con los cojones de acero favorito.

Esta máscara derretida de Darth Vader, es una réplica exacta de la máscara que venera Kylo Ren en Star Wars: El despertar de la fuerza. De hecho, el vídeo de Disney muestra el proceso de fabricación. Desde el escaneado 3D con...
Por Nacho Palou -
29 JUN 2016

Un genial artículo de Dave Addey sobre la tipografía y diseño de Blade Runner. Es tan detallista y delicado que incluso si conoces a fondo la obra maestra de Ridley Scott seguramente habrá detalles de los que nunca habías oído hablar y que te sorprenderán.

Un hombre se despierta misteriosamente dentro de su teléfono móvil un buen día, lo cual le obliga a ver el móvil y la tecnología que nos rodea en la vida cotidiana de otra forma…

Dicen que este montaje contiene las mejores imágenes del New York City Drone Film Festival, uno de los eventos para los amantes de la cinematografía y los drones. Todas las escenas están grabadas con drones.

Uno de los clásicos de la divulgación científica divertida más apreciados por nuestros lectores ha reaparecido así de repente en YouTube. (…) El excéntrico profesor Beakman responde a preguntas populares e inusuales de su público haciendo demostraciones prácticas con sus ayudantes...

Con motivo del 30 aniversario de la película Aliens, el regreso —segunda entrega después de Alien, el octavo pasajero— aquí van casi cinco horas en un par de documentales sobre cómo se hizo Aliens, en 1986. Hay que tener en cuenta...
Por Nacho Palou -
9 JUN 2016

Este extraño cortometraje experimental se titula Sunspring. Es una idea de Oscar Sharp (cineasta) y Ross Goodwin (tecnólogo) que partió del reto de crear una «máquina capaz de escribir guiones». Con ideas basadas en las redes neuronales crearon Jetson, un software...

Lumbergh Tiburón Adam nos ha escrito para hablarnos de Movies & T.V., una colección de ilustraciones pixeladas, estilo 8 bits, de 26 personajes (tomado en un sentido amplio de la palabra) de películas y televisión. Si te gusta alguno de ellos puedes...

En el retrofuturo, Tiger Corp. desarrolla su ambicioso proyecto para mejorar el mundo. Por supuesto, algo sale mal. Unos decorados construidos en un polígono industrial de Bilbao y varios años de postproducción en un sótano madrileño, así como una historia que...
Approaching the Unknown, de Mark Rosenberg, es una película de ciencia ficción de corte independiente y bajo presupuesto. «Bajo presupuesto» al menos en comparación con las últimas películas del mismo tipo: Gravity, Interstellar o The Martian contaron las tres con 100...
Por Nacho Palou -
6 JUN 2016

[¡Advertencia! Ya nunca volverás a ver una taza de café en televisión del mismo modo.] En Slate han dedicado un vídeo a analizar una de las anomalías más tontas peculiares que se pueden ver en las películas y series de televisión:...
Lo And Behold: Reveries of the Connected World es un documental de Werner Herzog sobre Internet y lo que supone vivir en un mundo conectado que se estrena el 19 de agosto de 2016. Según cuentan en Wired, donde ya han...

Un simpático cortometraje grabado con la vieja técnica del stop-motion (¡requiere mucha paciencia!) sobre la rutina mañanera de un ingeniero loco y un poco vago que dota a su casa de avances mecánicos y robóticos para realizar las aburridas mismas cosas...
Tras el despegue de una lanzadera que lleva a la tripulación que está destinada a colonizar Marte se descubre que una de las astronautas está embarazada. Poco después del aterrizaje la mujer muere por complicaciones durante el parto de quien será...
Por Nacho Palou -
31 MAY 2016
No sé cómo se me pudo pasar Black Mirror: White Christmas que fue el especial navideño de 2014 de Black Mirror, esa miniserie sobre el futuro cercano que a todo el mundo ha impactado por su creatividad, buena producción y excelentes...
Con un estilo «inspirado en las infografías» el ilustrador suizo Martin Panchaud ha creado en Adobe Illustrator Swanh (Star Wars A New Hope), una adaptación en una única imagen del Episodio IV de Star Wars: Una nueva esperanza. La película completa...
Por Nacho Palou -
24 MAY 2016
El astrofísico Borja Tosar y el periodista científico Xavi Fonseca vuelven a la carga con su Espoiler científico, en este caso centrando su atención en el universo de Star Wars para hablar de cosas como los planetas que aparecen en la saga,...
En Timeless un grupo «medio secreto» compuesto por una historiadora, un científico, un militar y un piloto viajan a diversas épocas con un descacharrado prototipo de máquina del tiempo persiguiendo a un malvado que se ha adueñado del «último modelo» en...
Guns replaced with Selfie Sticks es un tumblr de reciente creación que se dedica a recopilar pósteres y fotogramas de conocidas películas en los que se reemplazan rifles y similares por paloselfies. Los resultados son hilarantes cuando menos. (PetaPixel vía zr)....

A ver si va a resultar que el futuro era esto: Hyper-Reality presenta una nueva visión provocativa y kaleidoscópica del futuro, donde se combinan las realidades físicas y virtual y la ciudad está saturada de todo tipo de mensajes, medios informativos...

Dispuesto a escapar de cualquier situación de peligro con un lápiz, un clip y el envoltorio de una chocolatina –o algo más rústico todavía– MacGyver es un héroe de acción capaz de deshacer cualquier entuerto. Lo que viene siendo un hacker...
Dan Lewis en The Stapler, La versión roja de la grapadora Swingline tiene una puntuación de 4,7 estrellas (de cinco) en Amazon donde además es el producto más vendido del departamento «Grapadoras de oficina». Se ha convertido en un objeto de...
Por Nacho Palou -
17 MAY 2016
Si intentas joder el pasado, el pasado te joderá a ti.– regla del viaje en el tiempoen 11.22.63 11.22.63: en formato anglosajón, el 22 de noviembre de 1963. Fecha significativa, el día que asesinaron a John F. Kennedy. Uno de los...
Este pequeño vídeo de 40 segundos contiene unas 20 escenas de 2 segundos cada una que describen formas extrañas, horribles y espectaculares de morir en el espacio. Un plato demuestra lo difícil que será el día a día cuando abandonemos el...
Álvaro Gracia de MetaBallStudios ha reunido en este espectacular vídeo todas las naves del universo Star Trek, de modo que puedan compararse visualmente con facilidad. Esto incluye desde las pequeñas lanzaderas (unos 9 m de largo) hasta la gigantesca nave V’yer...
El texto en movimiento al inicio de cada película de Star Wars está siendo objeto de uno de los debates más nerds de los últimos tiempos: legiones de seguidores se encuentran alterados y ofendidos debido a un pequeño cambio en la...
Por Nacho Palou -
11 MAY 2016
«Una historia de terror isométrica»: así es como han subtitulado esta pequeña pieza de vídeo en la que se utilizan imágenes 3D en perspectiva para homenajear a algunos de los clásicos del cine de terror. Uno curioso y divertido entretenimiento artísticamente...
Este vídeo es parte de la tesis de Kurt Rauffer, que estudia en la Escuela de Artes Visuales de Nueva York, y que sin duda se lo ha currado como un homenaje a las películas de James Bond y a El...
Una colaboración entre How It Should Have Ended y Screen Junkies que tiene como objetivo crear una escena extra para muchas películas después de los títulos de crédito. Empiezan con Interstellar. ¿Alguien se acuerda de cual era el objetivo principal de...
Hace mucho tiempo, en un guión muy, muy, lejano... Mark Hamill revelaba en The Sun cómo iba a ser inicialmente la escena inicial de El despertar de la fuerza, En la escena de apertura inicial lo primero que aparece flotando en...
Por Nacho Palou -
8 MAY 2016
El vídeo Rogue One: A Star Wars Story in Lego! de BrotherhoodWorkshop recrea fotograma por fotograma el tráiler de Star Wars Rogue One usando Lego y la técnica stop-motion, en la que que para cada fotograma se mueven las figuras un...
Por Nacho Palou -
8 MAY 2016
Una deliciosa frikada por parte de All Nippon Airways para el Día de Star Wars: el tema de Star Wars compuesto a partir de sonidos que produce la operativa diaria de la aerolínea. BB8 en el Boeing 777 - ANA Claro...
Film Color Analysis es un proyecto de Dillon Baker que hace visible la gama cromática o los colores que predominan en algunas películas analizadas con su programa de procesado, El programa de procesado basado en Java convierte cada fotograma de una...
Por Nacho Palou -
3 MAY 2016
En el mundo del pinball, el Modo Wizard es una especie de Huevo de Pascua o Nivel Oculto al que se puede llegar tras superar ciertos retos. Es además el título de este documental que narra la vida de Robert Emilio...
En este vídeo de Filmmaker IQ John Hess explica todo lo que hay detrás de los CGI o imágenes generadas por ordenador principalmente en el cine. Como sabiamente dice en el fondo todo son matemáticas aplicadas a las coordenadas de los...
Esta película protagonizada por Dev Patel es una biopic escrita y dirigida por Matthew Brown acerca de Srinivasa Ramanujan (1887-1920), una de las figuras más misteriosas y enigmáticas de las matemáticas. Muy al estilo de Una mente maravillosa, muestra cómo el...
Bendito Machine es una miniserie animada que durante diez años ha producido cinco episodios sobre una especie alienígena bastante tontorrona y su peculiar relación de amor-odio con la tecnología. Durante este tiempo ha hecho las rondas por unos 500 festivales de...
He aquí un curioso vídeo medio-documental medio-lujoso con un toque muy artístico acerca de Wasteland Weekend, un encuentro entre aficionados al los futuros distópicos al estilo Mad Max: La experiencia es un festival post-apocalíptico de cuatro días en el desierto de...
La mayoría de las películas se graban hoy en día con cámaras digitales, aunque todavía algunas películas se filman con película convencional o combinando ambas tecnologías, con secuencias filmadas con película y con secuencias grabadas en digital. El despertar de la...
Por Nacho Palou -
27 ABR 2016
Este vídeo sobre el uso de los iconos y signos del interior de la USCSS Nostromo 180286 es un interesante análisis de cómo los diseñadores trabajaron en darles verdadero significado a cada uno de los rótulos que aparecen en puertas, compartimentos...
Perdona, no he entendido muy bien lo que has dicho.– Siri 9000 ¡Que San Kubrick nos perdone! Pero esta «versión Siri» de 2001: una odisea del espacio (1968) explica mucho mejor la cara de monumental cabreo contenido que pone Bowman cuando...
Star Wars Special: C-3PO #1 es un cómic dedicado a C-3PO, en el que se cuenta la historia detrás del brazo de color rojo que exhibe el droide en Star Wars: El despertar de la fuerza. En la película el detalle...
Por Nacho Palou -
25 ABR 2016
Balance, de Brandon Bray y Tim Sessler es un montaje medio p0rn sobre rascacielos, medio juego visual con perspectivas imposibles, engaños a la percepción, zooms extraños y giros imposibles. Las imágenes están rodadas en Manhattan, Brooklyn y algunas otras zonas de...
La película Help, o más bien el corto (dura unos cinco minutos) está grabada con técnicas cinematográficas en 360° con calidad de cine. Está dirigida por Justin Lin (Star Trek Beyond). Se trata de la primera historia disponible —de momento gratuitamente—...
Por Nacho Palou -
21 ABR 2016
John Wikstrom dirige este cortometraje acerca de una historia con la que se encontró en un comentario en YouTube. Lo firmaba alguien llamado 00WarTherapy00: La historia que cuenta es la de un joven que recordaba en su niñez haber jugado con...
¿Puede la exposición a una estrella como nuestro Sol darle superpoderes a un alienígena nacido a la luz de otra estrella? ¿Cómo reaccionaríamos si ahora mismo llegaran unos extraterrestres a vernos? ¿Se puede hacer retroceder el tiempo haciendo girar la Tierra del...
Drake Doremus dirige esta película producida entre otros por el mismísimo Ridley Scott y que tiene pintaza. Por desgracia no se sabe cuándo llegará a nuestras pantallas – y quizá ni siquiera llegue. Por el avance que han dejado ver parece...
Con un invitado muy especial e icónico de la época Mayor Tom ha dado a conocer el segundo trailer de 1982, un Regreso al Futuro a la española. Al crowdfunding le falta el último empujoncito para llegar a los 3.000€ y...
Tan grandiosa como la historia de Interestelar (Cristopher Nolan, 2014) es su banda sonora. Aquí se puede disfrazar de First Step, uno de los temas, versionado para órgano de iglesia. Precioso y relajante a la vez. El artista es David Robertshaw....
El 12 de febrero de 1985 una serie de errores por parte de los controladores de la misión hicieron, casi literalmente, saltar el sistema eléctrico de la estación espacial soviética Salyut–7 por los aires, aunque afortunadamente en aquel momento no había...
Sam Klemke es el autor de este curioso documental híbrido que, como decía Variety, «convierte décadas de la vida de un hombre en una especie de mensaje existencial en una botella.» Es como esos proyectos personales del tipo Un segundo al...
Según cuentan en io9, en Godzilla Strikes Back In the First Trailer For Japan's New Godzilla Movie este verano se estrenará en Japón una nueva película de Godzilla, de Hideki Anno y Shinji Higuchi, reencarnado en un lagarto que recupera el...
Por Nacho Palou -
15 ABR 2016
O como dirían en inglés, trailer del spin-off. Y con estos 99 segundos a salivar hasta diciembre amiguitos....
Ascensión (2014) es una mini-serie de Adrian Cruz y Philip Levens que emitió Syfy que me encontré el otro día por casualidad en Netflix. No tenía mal aspecto: una nota aceptable (7,2 en la IMDB) para una historia de astronautas y...

Michael Tucker preparó la estabilización de las imágenes de algunas de las escenas de 2001: Una odisea del espacio para entender mejor «cómo se rodaron». ¿Cómo consiguió Kubrick este efecto en 1968, sin ordenadores, retoques y todas esas cosas que hay...
1982 es una idea para un cortometraje de ciencia ficción sobre un tipo que viaja al pasado en un coche Delorean DMC-12 gracias a un dispositivo llamado «condensador de fluzo» y… ¡Ey! ¿Dónde he visto eso antes? Vale: en realidad estamos...
Un futuro ¿utópico? ¿distópico? Robots y automatismos. Desempleo tecnológico. La breve historia de Alice, que tiene el último empleo reconocible como tal en el planeta Tierra. Que han utilizado en The Guardian como apoyo a este buen artículo: Automation may mean...
¿Publicidad engañosa? Esta es la lista de WacthMojo de las 10 películas cuyos trailers eran espectacularmente mejores que las películas propiamente dichas: Wild Wild West. Battle: Los Angeles Prometheus, que a mí tampoco me gustó nadita. Star Wars: Episodio I -...
El corto “Rise” de David Karlak es la producción resultante de la financiación colectiva que Karlak consiguió con la campaña iniciada hace un par de años en Kickstarter. Y es brillante. Rise es una película sobre el levantamiento de los robots,...
Por Nacho Palou -
30 MAR 2016
Un joven con poderes especiales se enfrenta a unas fuerzas de la ley fuertemente militarizadas debido a que la mayor parte de la gente con poderes especiales de este mundo tan diferente en vez de convertirse en «millonarios» viven en la...
Spoilers por un tubo y blah blah… Pero si aún no has visto Star Wars: El despertar de la fuerza te los mereces. Star Wars Force Awakens ALL Easter Eggs & References es un vídeo que analiza, casi escena por escena,...
¿Te acuerdas del desastre de la Deepwater Horizon? era una «plataforma semisumergible» que perdió el prefijo semi- para acabar sumergida del todo en el fondo marino del golfo de México después de explotar y liberar de forma descontrolada miles de toneladas...
(Si todavía no has visto la peli ten en cuenta que... bla bla bla... supongo que vives en Dagobah... spoilers... bla bla bla... saluda a la babosa del plantano y todo eso.) De Star Wars: El despertar de la fuerza empieza a...
Por Nacho Palou -
23 MAR 2016
¡Esa persona es rara de narices!– Gale Según algunos expertos, «los robots con aspecto de humanos son la clave para la comunicación entre personas y ordenadores». Sin duda robots humanoides de la ficción como Ava en Ex machina (2015) pueden despertar...
Por Nacho Palou -
22 MAR 2016
Rick y Morty (Justin Roinland y Dan Harmon, 2013). En España se emite en TNT. Rick Sánchez es el clásico científico loco superdotado que a la vez es un abuelillo alcoholizado: inventa geniales gadgets de todo punto prodigiosos, pero no puede...
Calle Cloverfield 10 (Dan Trachtenberg, 2016) tiene el gran atractivo de unir a quienes interpretaron a Walter Sobchak y Ramona Flowers (John Goodman y Mary Elizabeth Winstead) en un búnker cuando algo terrorífico, apocalíptico y misterioso sucede en el exterior. Poco...
El vídeo Behind the Scenes of Darth Maul: Apprentice muestra la producción de Darth Maul: Apprentice el corto dedicado al intimidante Sith del sable de doble hoja realizado por un grupo de estudiantes alemanes entusiastas de Star Wars, quienes dedicaron en...
Por Nacho Palou -
18 MAR 2016
Delivery from Earth es un pequeño corto de ciencia ficción que trata del nacimiento del primer humano en Marte cuando su madre, miembro de una expedición a nuestro vecino, da a luz allí, una historia que por ahora es ciencia ficción,...
En este cortometraje un niño que sueña con aventuras espaciales se hace amigo de un anciano que dice ser un antiguo astronauta. Entre los dos construyen un «cohete» con una vieja aspiradora –un poco a lo rocketeer– para a continuación vivir...
Madres reemplazadas por androides. Mieduqui. Y es que esa mirada vidriosa y perdida no puede presagiar nada bueno. Es un trabajo de Ariel Martin, que ha ganado varios premios con esta historia protagonizada por Matilda Brown....
Los Cazadores de mitos gustaban de rechazar tu realidad y sustituirla por la suya, pero no pudo ser con la realidad sobre su final: el último episodio de la serie se emitió ayer, tras 282 episodios repartidos a lo largo de...
Por Nacho Palou -
8 MAR 2016

Buscando unos subtítulos para revisar las viejunísimas versiones de las películas y series de Flash Gordon (que se retrotraen hasta 1936) me encontré con el canal de los Seriales de Genteovejuna en YouTube, donde están éstas y otras joyitas de la...
Shawn Bu, un entusiasta de Star Wars que estudia cinematografía en Alemania, firma este increíble cortometraje dedicado a la figura de Darth Maul. «Siempre creí que Darth Maul debería haber tenido un protagonismo mayor —cuenta Shawn— y ese es el motivo...
Por Nacho Palou -
7 MAR 2016
Como cualquier otra lista esta puede ser discutida, pero también sirve como punto de partida para descubrir nuevas series que ver. Into the badlands: ambientada en un futuro distópico donde las armas de fuego han sido prohibidas por los señores feudales...
Melissa McCarthy, Leslie Jones, Kate McKinnon y Kristen Wiig protagonizan la nueva versión de la mítica película Los Cazafantasmas / Ghostbusters, en esta ocasión dirigida por Paul Feig. Feig no es Ivan Reitman —el director de la película original de 1984—...
Por Nacho Palou -
3 MAR 2016
Primera encarnación del Halcón Milenario Michael Heilemann es un verdadero friki de Star Wars; sólo eso explica que haya pasado años leyendo libros, webs, foros y similares y repasando todo tipo de imágenes para escribir A Complete History of the Millennium Falcon....
En Force Push A Car los chicos de Film Riot explican con cierto detalle qué efectos especiales utilizan y cómo los aplican para completar un simpático microcorto de algo menos de dos minutos de duración. En total apenas suman cinco segundos...
Por Nacho Palou -
1 MAR 2016

El otro día tras ver Deadpool (altamente recomendable por cierto) estuvimos comentando sobre el aterrizaje en tres puntos que se parodia como no podría ser menos en una película de cachondeo salvaje sobre personajes con superpoderes. Se trata de una «maniobra»...
Esta noche saldremos de dudas acerca de qué película se llevará el Óscar de 2015 a los mejores efectos visuales. Las nominadas son Ex Machina, Mad Max: furia en la carretera, Marte, El renacido y Star Wars: el despertar de la...
Boldly Gone es la historia de dos hermanos distanciados que se reúnen para lanzar las cenizas de su padre al espacio. Esta pequeña historia de poco más de diez minutos tiene como curiosidad atípica la presencia de actores que han participado...
Estos cascos traductores a la «lengua droide» sirven como disfraz pero además llevan micrófono y auriculares. De este modo que todo lo que se habla se «traduce» a sonidos ambiente similares a los del idioma droide de los R2-D2s y BB-8s...

¿Qué sucedería si todas las diatribas en contra de los sistemas de cifrado y seguridad hubieran tenido su origen en una película de ficción? ¿Si se hubieran gastado millones y millones en defender a un país de amenazas imaginarias? ¿Si al presidente...

Tremendamente ingenioso el trabajo de Tyler Hopkins, un fan de Regreso al Futuro que ha preparado un «falso avance» de lo que sería la precuela del clásico de Zemeckis utilizando fragmentos de otras películas – y el hecho de que Christopher...
Poco más hace falta decir que lo que dice el título salvo que pongas el vídeo en HD, pantalla completa, y con altavoces, aunque si quieres saber algo más es Horacio Llorens volando en paramotor en Trømso. (Vía Paco Taracido)....
El “mini doc” Maximum Fury es un «cómo se hizo» la película Mad Max: Furia en la carretera — el episodio más reciente añadido a la saga de Mad Max que llega 25 años después... porque llevó casi 25 años completarlo....
Por Nacho Palou -
16 FEB 2016
Jackie es una monitora de gimnasio que, enfrentada al paso del tiempo y a la pérdida de la juventud, no sabe muy bien qué hacer con su vida, que no le satisface especialmente, además de que está perdiendo el contacto con...
Un grupo de seis especialistas deben trabajar en equipo para entregar un «paquete» mientras huyen de un depredador desconocido que acecha en las calles de Gotham. ¿Es un monstruo, un alienígena o un psicópata suelto? Este cortometraje de Letia Clouston es...
Ayer tuve ocasión de ver el documental I Am Your Father de Marcos Cabotá y Toni Bestard y me pareció maravilloso: es técnicamente impecable, con una magnífica fotografía, a la vez que es emotivo y necesario. Darth Vader es considerado el...
Por Nacho Palou -
11 FEB 2016
Un fan de Bola de dragón convirtió su hoverboard en Nube Kintō y se paseó de esta guisa por las calles de Taipei. Genial disfraz que dejó asombrados a todos los viandantes. (Vía Kitai + Mezvan.)...
Además del final que debería haber sido según How It Should Have Ended el vídeo How Star Wars The Force Awakens Should Have Ended (con subtítulos en español) contiene correcciones en el desarrollo de algunas escenas — algunas de ellas acertadas...
Por Nacho Palou -
10 FEB 2016
La Caja de Pandora de Daniel Hernández Torrado presenta una historia basada en los videojuegos y el aislamiento provocado por las nuevas tecnologías. [Es una] crítica a una sociedad atrapada en las redes digitales. Una combinación de cine de acción y...
Por Nacho Palou -
5 FEB 2016
De las profundidades de Internet llega esta especie de Google de «Los Simpsons» llamado Frinkiac. En total almacena más de tres millones de fotogramas de todas las temporadas de los populares personajes, adecuadamente asociadas con palabras descriptivas, de modo que se...
En Gear Patrol, Why Space Is Making a Comeback, sobre el resurgir de la fascinación por el espacio en los últimos años que se expresa en el cine, con un montón de películas sobre este tema estrenadas en los últimos años...
Por Nacho Palou -
2 FEB 2016
Piezas de la maqueta original del USS Enterprise 1701 completamente desmontado Según cuenta The Register, está restaurando la maqueta original del Enterprise 1701, una de las más icónicas naves de la ciencia ficción, con motivo del 50º aniversario del estreno de Star...
Autonomous de Aleksei Shulga y Mihhail Kohtov, un corto animado de ciencia ficción que se desarrolla en un escenario de ruinas y de armas autónomas....
Por Nacho Palou -
31 ENE 2016
14A Studio publicó su versión en 60 segundos de la última entrega de la saga de Star Wars, con su habitual toque de humor y personajes entrañables que hablan con las ratitas de los dibujos animados. De entre su galería de...
{Ojo: spoilers visuales si todavía no has disfrutado de la película. ¡Corre, insensato!} Cual capas de una cebolla este vídeo del estudio MPC desgrana los principales efectos visuales de Marte (2015), una de nuestras películas favoritas del año pasado. Como es...
Una visión alternativa del encuentro del villano de El despertar de la Fuerza con Han Solo. Y no escribo más para no spoilear. Ojo también con los vídeos relacionados. (Canino vía Pepe Cervera, pero no leas el enlace de Canino a...
… porque también podría no llegar a fabricarse de nuevo nunca. El caso es que de vez en cuando aparece esta «noticia» que deja salivando a los fans de Regreso al Futuro: que van a fabricar de nuevo el mítico, legendario...
Mucho ha llovido desde que reseñamos por aquí Expediente X (X-Files, 1993) que es según los lectores de este blog una de sus cinco series geek favoritas de todos los tiempos. Con el retorno que tuvo lugar ayer en formato miniserie...
Gran recomendación desde ¡Es la guerra!: La batalla del agua pesada (2015) – Se trata de la miniserie noruega de sólo seis episodios, que narra la Operación Gunnerside, cuyo objetivo era sabotear el proyecto atómico de la Alemania nazi (…) Aunque...
Gran toma de la película El topo (2011): cuentan en PetaPixel que esta escena la rodó Hoyte van Hoytema usando un teleobjetivo de 2000 mm de modo que la profundidad de la imagen –una pista de casi dos kilómetros– quedara perfectamente...
La civilización galáctica depende de tecnologías milenarias. La comunicación y el transporte a velocidades subluz son el pan de cada día, e incluso los objetos más corrientes rezuman energía informática. Las diferentes facciones tienen mano de obra barata e impersonal: droides...
Esta es la lista las películas que para Neil deGrasse Tyson incluyen los mejores extraterrestres, traducida y adaptada de Best Hollywood aliens, una buena disculpa para repasarlas, salvo, quizás, en el caso de Independence Day: 2001: Una odisea del espacio, donde...
{Dedica unos minutos a esto que merece la pena. Prometido} Joe Sill narra en esa mini-superproducción de Whitelist.tv, en poco más de seis minutos, una pequeña gran historia del universo Star Wars: buenos actores y unos espectaculares efectos especiales, por no...
Grabas unas cuantas tomas en París, eliminas los edificios y recuperas las fachadas convirtiéndolas en una especie de decorados irreales. Esa es la idea detrás de Apariencias, una curiosa pieza de Claire & Max. (Vía Neatorama.)...
Diría que la película 10 Cloverfield Lane ha aparecido así como por sorpresa, o al menos no me suena nada haber oído hablar antes de ella. Y me extraña, porque al parecer guarda relación con Cloverfield (2008) [Monstruoso, en España], que...
Por Nacho Palou -
15 ENE 2016
(Sobra decir que si aún no has visto la película igual te interesa no ver este vídeo por si te destripa alguna escena o trama. Claro que si todavía no has visto la película es porque probablemente te da bastante igual.)...
Por Nacho Palou -
15 ENE 2016
El despiadado Imperio Galáctico persigue a muerte a un piloto de la Alianza Rebelde, abandonado a su suerte en las nieves de Hoth, el planeta helado. Cuenta su director que durante el rodaje de Escoria rebelde se ha procurado rendir homenaje...
Construido por el equipo de Bright Bricks hace unas semanas, con ocasión del estreno de la película en el Reino Unido, el vídeo muestra el proceso de construcción que resulta en una versión de BB-8 a tamaño real y que —aunque...
Por Nacho Palou -
14 ENE 2016
Traveler, de Simon Brown (un artista multidisciplinar el mundo de los VFX y el cine) es un buen ejemplo de excelente trabajo de diseño y efectos visuales, con reminiscencias del landspeeder y las vainas de carreras de Star Wars. La historia...
Archdirectors de Federico Babina, Leonidas Mamais y Elisabet Raspall, personifica edificios inspirados en la estética, escenografía y ambiente o música característicos de directores de cine como Hitchcock o Kubrick entre otros arquitectos del cine. Vía The Creators Project....
Por Nacho Palou -
12 ENE 2016
Los holoramas de Jeff Desom son una auténtica obra de arte, una combinación de maquetas creadas con infinito detalle y escenas de películas de cine que se proyectan en una caja tridimensional mediante un truco óptico de espejos. El resultado, como...
Siete años después de sus últimas aventuras juntos, Fox Mulder y Dana Scully vuelven a juntarse para salvar el mundo en una nueva temporada de Expediente X de 6 episodios que se estrena el 26 de enero de 2016 en la...
Si la primera regla de los viajes en el tiempo es «Debes matar a Hitler» la segunda es para algunos «Debes impedir que maten a JFK». Y con esta última idea llega 22.11.1963, una producción de J.J. Abrams y Stephen King...
Sonya Belusova, de PlayerPiano, toca al piano una selección de temas de Star Wars, pero hay que verlo, casi más que oírlo. Es su homenaje al estreno de El despertar de la fuerza. (Ángel Domínguez vía un RT de Minibego)....
Yo… He visto cosas que vosotros no creeríais… Naves de ataque en llamas más allá de Orión, he visto rayos C brillar en la oscuridad cerca de la puerta Tannhäuser…Todos esos momentos se perderán en el tiempo como lágrimas en la...
Igual que Stan Lee en la mayoría de las películas de superhéroes de Marvel basadas en personajes creados por él, Alfred Hitchcock hace cameos en 37 –puede que en 38– de sus películas, apareciendo en alguna de ellas dos veces. Estos...
Vaya por delante que me encantaron tanto la novela como la película, pero me he partido de risa con este tráiler honesto de The Martian: Es prácticamente como cualquier otra película que Matt Damon ha hecho, pero con un poco más...
De los seis metros de un caza TIE de Star Wars a los , este vídeo da un repaso a toda una serie de naves de novelas, películas, series y juegos de ciencia ficción, con la única salvedad de la Estación...
Saturday Night Live (SNL) es un conocido «late show» televisivo que desde mediados de los 70 ha marcado muchos grandes momentos del humor en forma de sketches, monólogos y entrevistas. De sus mejores momentos han salido cientos de personajes y decenas de...
La vida es corta: no veas mierdas– BAGmovies El lema de BAGmovies deja claro su misión: recomendar las mejores series de televisión y películas dado que el tiempo del que disponemos en nuestras limitadas vidas es demasiado breve. Lo dicen con...
Los vídeos educativos de John Hess en Filmmaker IQ son una auténtica maravilla; por aquí los hemos mostrado más de una vez y lo cierto es que cualquiera podría pasarse horas y horas revisándolos para aprender sobre la cinematografía en todos...
El corto The Looking Planet de Eric Law Anderson ha logrado durante este año medio centenar de premios y reconocimientos en numeros festivales. Su autor lo resume como un cuento traducido de la radiación cósmica de fondo. Relata cómo durante la...
Por Nacho Palou -
26 DIC 2015
El desafío (Robert Zemeckis, 2015) [trailer]. Tuvimos la oportunidad de asistir a uno de los pases de preestreno de El desafío, la última película de Zemeckis que narra la historia del funambulista francés Philippe Petit, un curioso artista obsesionado con caminar...
Si tienes cerca a un friki de Star Wars que con el reciente estreno de El despertar de la fuerza ha sentido un resurgir en su frikismo, puedes probar a sorprenderlo con alguno (o todos) de estos libros sobre la saga,...
No tenía aún diez años cuando se estrenó la película ahora conocida como Star Wars: Episodio IV - Una nueva esperanza, y era aún un adolescente cuando se estrenó Star Wars: Episodio VI - El retorno del jedi, así que las...
{Reseña sin spoilers para no destriparle la peli a nadie que no haya visto los trailers.} Han pasado 32 años desde el estreno de El retorno del Jedi, así que ese es el tiempo que muchos llevábamos esperando para vivir la...
Aunque cuando oímos hablar del monzón pensamos inmediatamente en la India en realidad se da en más partes del mundo, como por ejemplo en los Estados Unidos. Mike Olbinski pasó 48 día cazando tormentas en Arizona durante el monzón durante los...
Leia: ¡Qué gracia encontraros por aquí!Laureline: ¡Oh, nosotros venimos por aquí desde hace tiempo!En 1983, después de que el ilustrador Jean-Claude Mézières hubiera visto las películas de Star Wars publicó esta viñeta en la revista francesa Pilote. En una cantina parecida...
Por Nacho Palou -
17 DIC 2015
Esto más que un mero entretenimiento es todo un señor cortometraje: los muñecos de palo de los videomemes descubriendo Minecraft (en 2D, eso sí) y protagonizando aventuras sobre el escritorio de Windows. Escenas cada vez más surrealistas y curiosas en las...
Desde el departamento de nuestros amigos los gérmenes llega esta simpática y deliciosa peliculita animada sobre un germen codicioso y lo que sucede en el pequeño e invisible de mundo estas criaturitas «tímidas y amigables, que se ayudan unas a otras»...
Al ver el avance de Star Trek: Beyond me encontré con este vídeo en The Verge acerca de la réplica del comunicador de Star Trek (clásico) fabricado por la mismísima gente de ThinkGeek. El chisme funciona como un auricular manos libres...
Con esta van trece: Seis películas con los personajes de Star Trek (clásica), cuatro de La nueva generación y dos del reinicio, con personajes clásicos pero actores modernos, siendo esta nueva la decimotercera. Star Trek Beyond, que es el nombre de...
Esto va a durar menos en línea que las resoluciones de año nuevo en nuestras mentes, pero tiene su coña: las seis películas de Star Wars en HD, reproduciéndose a la vez, por si andas pillado de tiempo para repasarlas antes...
Todavía tengo pesadillas con aquello de colarle un virus a los extraterrestres by the face o con la lamentable traducción aquella de «los humos de la victoria»… Pero lo mismo caigo y voy a ver Independence Day: Resurgence cuando la estrenen...
Ya se puede ver en Internet The Expanse, una opereta espacial de SyFy que se estrena estos días en televisión. Narra la historia de una conspiración y un detective que trabaja en el futuro, dentro de 200 años, cuando los humanos...
No soy ya muy de publicar vídeos de gente haciendo el cabra con sus GoPro en deportes de acción adrenalínica patrocinada por Red Bull porque ya saturan un poco, la verdad – tuvieron su momento de «novedad», pero ya pasó. Pero...
Antes de que acabe el 2015, año en que Marty McFly y Doc llegan al futuro desde 1985, Borja Tosar y Xavi Fonseca se encargarán de dar un repaso a cómo creíamos que sería el futuro y a como ha resultado ser...
El minicortometraje de hoy es un trabajo de Federico Heller / 3dar. Se trata de un cortometraje sobre el famoso valle inquietante (o «valle inexplicable») y ese difuso momento entre que la realidad y la ficción se cruzan y no resultan...
Tenía pendiente ver Atari: Game Over (2014) y… ¡Vaya joyita! Es un documental de algo más de una hora sobre el auge y caída de Atari, una de las más reconocidas marcas del mundo de los videojuegos de la historia:desde la...
En una era post-nuclear en la que poseer libros es un crimen y la comunidad intelectual está perseguida, un grupo de científicos intentan en vano salvar el mundo. Enmienda 10/60 es un cortometraje griego de Akis Polizos realmente curioso y muy...
En Star Wars no hay galaxias. En cambio todos los acontecimientos discurren en una galaxia muy, muy lejana. Pero en una, eh....
Por Nacho Palou -
7 DIC 2015
El corto The Shaman, de Marco Kalantari, que se ha hecho recientemente con el premio del Festival de cine de Tribeca de New York, dura poco más de quince minutos y tiene subtítulos en español (entre otros idiomas) y no decepciona...
Por Nacho Palou -
7 DIC 2015
La construcción de la Estrella de la muerte fue para el Imperio galáctico algo equivalente económicamente a lo que el proyecto Manhattan —el desarrollo de la bomba atómica— fue para EE UU, proporcionalmente. Esto es, una inversión económica bastante grande. Ingente....
Por Nacho Palou -
4 DIC 2015
Aunque se parecen mucho a las imágenes astronómicas que produce el Hubble, por ejemplo, en realidad lo que se ve en este delicioso vídeo son gotas de tinta luminiscente dejadas caer en un recipiente con agua iluminado con luz negra. Están...
Películas que son básicamente la misma historia contada de otra manera —esto es, el mismo argumento en distinta productora y estrenadas el mismo año— conocido como el fenómeno de las películas mellizas separadas al nacer: Armageddon vs Deep Impact (1998), Asalto...
Por Nacho Palou -
3 DIC 2015
El debate eternamente recurrente, George Lucas Offers New Explanation of Why Han Didn't Shoot First, Aquellos que vieron la primera versión de La guerra de las galaxias se irán a la tumba convencidos de que en la escena de la cantina Han...
Por Nacho Palou -
2 DIC 2015
Del planeador de los ewoks hasta la segunda Estrella de la muerte, pasando por tauntauns y banthas, todos los medios de transporte que salen en La guerra de las galaxias, El Imperio contraataca y El retorno del jedi, a la misma...
Star Wars Spoiler Blocker es una extensión para el navegador web Chrome que bloquea una página o contenido web si detecta que contiene algún spoiler de Star Wars: El despertar de la Fuerza. Basta con instalar la extensión en el navegador...
Por Nacho Palou -
30 NOV 2015
Este vídeo-homenaje titulado simplemente Apollo es además de bonito un perfecto ejemplo del efecto paralaje, una técnica para simular «profundidad 3D» a partir de imágenes planas 2D convencionales, en lo que se conoce popularmente como Efecto 2,5D. La técnica consiste básicamente...
Alternative Movie Posters II es la segunda parte de una recopilación de trabajos de artistas poniendo su toque especial a las películas clásicas y de culto, con pósteres alternativos a cual más espectacular e ingenioso. Y es que muchas veces las...
{Sin spoilers} Jessica Jones es una serie de Marvel para Netflix que ha llegado en el formato «ahí están los 13 episodios en tarifa plana», de modo que puedes vértela en dos o tres días si te engancha. Tiene detrás una...
¿Cómo sería el mundo si los aliados hubieran perdido la segunda guerra mundial? Esa es la premisa de la que parte la novela El hombre en el castillo, de Philip K. Dick, cuya acción discurre en 1962 en unos Estados Unidos...
Llega el turno de Interstellar en Spoiler científico, el ciclo de conferencias sobre ciencia en el cine organizado por los Museos Científicos Coruñeses, en los que trabajo. El martes 24 de noviembre, en Domus, a las 19:30, el astrofísico Borja Tosar y...
Muy buena pinta para los tiempos que corren tiene RocketJump, una producción de Hulu con la gente de RocketJump Studios que cuenta cómo rodar, con relativo bajo presupuesto –porque luego seguro que se pone en un «pico»– cortometrajes y escenas para...
Jamás vimos su cara en ninguna de las películas –ni siquiera en El retorno del jedi por un desencuentro con George Lucas que ya dura décadas– así que Marcos Cabotá y Toni Bestard pensaron que era de justicia hacer un documental...
Este cortometraje es una muy buena historia de ciencia-ficción a pesar del bajo presupuesto con que se ve que está producido. Deja entrever cómo es un mundo en el que la gente vive con unos «pequeños ayudantes» para llevar su vida...
Melody Sheep ha creado este precioso homenaje musical con Spock como protagonista. Interpretado por Leonard Nimoy (1931-2015) es sin duda uno de los personajes más reconocibles del mundo de la ciencia-ficción en general y del universo Star Trek en particular. Aunque...
«Ahora te toca a ti patear clones» En Wired, You Won’t Live to See the Final Star Wars Movie, Las nuevas películas de Star Wars no son sólo secuelas. No es así como funciona ya el negocio. Olvídate de las sucesiones finitas;...
Por Nacho Palou -
18 NOV 2015
«Zero» cuenta la historia de un padre y su hijo, emocional y físicamente separados el día que la Tierra pierde la gravedad de forma intermitente. El niño, perdido, deambula por la ciudad obsesionado con dar respuesta al reciente fallecimiento de su...
Por Nacho Palou -
13 NOV 2015
Movie Posters es un delicioso vídeo en el que invertir los algo menos de dos minutos que dura. Son los pósteres animados de 16 conocidas películas, ambientados con música de Ludovico Einaudi. ¿Cuantas de ellas has visto? (Vía @Molinos1282, que en...
¿Ese destructor estelar que se ve al principio del trailer de El despertar de la fuerza? Es el Inflictor, uno de los restos de la batalla de Jakku, un enfrentamiento entre el Imperio y la Nueva República que tuvo lugar un...
Nos recomendaron hace tiempo la divertidísima serie de animación y humor negro Rick y Morty (2013), sobre las aventuras de un científico loco y su nieto, cuya especial son los viajes interdimensionales. Aquí un episodio en el que llegan a un...
Esto es tan oficial como que la web de StarTrek.com ya lo ha dado: Star Trek volverá en 2017 a las pantallas. Será una producción para la plataforma de contenidos de la CBS, que es donde están actualmente disponibles los episodios...
Del 1 al 5 de noviembre puede verse en YouTube en exclusiva CodeGirl, un documental sobre un grupo de chicas de secundaria que participa en un concurso de programación para mejorar la comunidad en la que viven mediante el uso de...
Una solución de baja tecnología al problema de encontrar tu media naranja que abordaba 97%, otro corto que publicamos hace unos días. Signs es el ganador del Schweppes Online Short Film Festival de 2007, y ganó un León de Cannes en...
Face the Force (Encara la Fuerza) lleva algunos días en carteles de todo Madrid; nos tenía un poco despistados porque parecía una exposición normal y corriente; más todavía porque su web FaceTheForce.com redirigía a la web normal y corriente de Star...
Ayer asistí a la primera de las charlas del ciclo Spoiler Científico que han organizado los Museos Científicos Coruñeses, donde trabajo en el MundoReal™. La «víctima» de esta primera charla fue Marte (The Martian), que Borja Tosar y Xavi Fonseca se...
Los Museos Científicos Coruñeses, en los que trabajo en el MundoReal™, estrenan mañana un nuevo ciclo de conferencias titulado Spoiler científico en el que hablaremos de la ciencia en el cine. La primera película en ser destripada será Marte (The Martian), el...
The Brain Hack plantea lo que podría pasar después de que dos estudiantes descubran que las visiones de dios no son más que un fallo de nuestro cerebro y de que inventen una forma de provocarlas a voluntad. ¿Se acabarían las...
97% es un cortometraje romántico de la era moderna: el protagonista recibe un aviso de un app que le indica que su «media naranja» con un 97% de «compatibilidad» está muy cerca, dentro de un vagón de metro. ¿Podrá encontrarla antes...
Our Fractal Brains / Fractalocious 2 son fractales poéticos en los cuales se combina el uso del color, la poesía, la tipografía y la composición visual. Es un trabajo de Julius Horsthuis, con música de Patrick O’Hearn. El trabajo incluye todo...
La gente de Science Vs. Cinema ha cogido el tráiler de El despertar de la fuerza, los teasers, y el vídeo de la Comic–Com y ha montado este interesante mash–up. Eso sí, no sé lo que durará en los tubos, así...
Circle (2015) de Aaron Hann y Mario Miscione. Se trata de una peliculita de terror indie de bajo presupuesto que no es un peliculón pero al menos da que pensar un poco. Es diferente a lo habitual si obvias que se...
Esta semana asistimos a la puesta de largo de Netflix en España, un servicio que en EE UU puso de moda a finales de los 90 la denominada «tarifa plana de videoclub» originalmente con DVD físicos y posteriormente a través de...
Va a haber que pedirle a los reyes Ciencia ficción: Crónica visual del género más apasionante de la galaxia, un libro que en 272 páginas promete ser el libro de referencia más completo del género en todas sus facetas: literatura, cine,...

Esto ha sido parte parte de mi proyecto personal de este verano: la elaboración de una lista de cortometrajes sobre viajes en el tiempo que permitiera disfrutarlos en Internet de forma cómoda. Está disponible en dos formatos: YouTube y Vimeo (todavía...
La mayor parte no han cambiado mucho: la casa de los McFly, el colegio, la pista de baile… Incluso el parking del centro comercial donde tienen lugar los primeros viajes al futuro y al pasado parecen prácticamente los mismos. La soleada...
Como toda película, Regreso al futuro toma elementos de otras películas como inspiración y a su vez ha inspirado miles de referencias en otros largometrajes, cortos, series y en la cultura popular. Tal vez el mejor ejemplo sea la relativamente desconocida...

He aquí una recopilación de mis curiosidades favoritas acerca de Regreso al futuro, procedentes de diversas fuentes; especialmente de los documentales «cómo se rodó» y de la IMDB. 1. Las dos Jennifer. Claudia Wells, la actriz que encarna a la novia de...
Este bellísimo homenaje a las películas sobre viajes en el tiempo es un montaje obra de Javier (del blog Manual del viajero en el tiempo). Es toda una joya que repasa el aspecto de las máquinas del tiempo, sus creadores y...
En todos estos años a Regreso al futuro hemos dedicado un sinfín de anotaciones a diversos aspectos de la película aquí en Microsiervos, así que a modo de recodatorio-homenaje ahí va una selección de las más relevantes, organizadas por temas: Regreso...
Regreso al futuro (1985) de Robert Zemeckis. Con Michael J. Fox (Marty), Christopher Lloyd (Dr. Emmett «Doc» Brown), Lea Thompson (Lorraine), Crispin Glover (George McFly) y Thomas F. Wilson (Biff Tannen). Aprovechando que hoy se celebra el 30º aniversario del regreso...
Marty McFly: ¿Dónde estamos? ¿Cuándo estamos? Doc Brown: Estamos descendiendo hacia Hill Valley, California, a las 4:29 de la tarde del miércoles 21 de octubre de 2015. Marty McFly: ¿2015? Quieres decir que… ¿estamos en el futuro? Pues sí. El futuro...
– Hay historias sobre lo que pasó.– Todas… Ciertas. √ Pantalla completa. √ Altavoces. √ Salivar. Y ahora a esperar al 18 de diciembre por el estreno de El despertar de la fuerza, aunque ya deberías poder reservar las entradas en...
Marte (The Martian) de Ridley Scott (2015) con Matt Damon, Jessica Chastain, Kristen Wiig, Jeff Daniels, Michael Peña, Sean Bean y Kate Mara. Basada en la novela El marciano de Andy Weir. {Sin spoilers, que ya habrá tiempo} Teniendo en cuenta...
A Etienne Auge le apasiona la ciencia ficción. De hecho ha fundado, junto con la Universidad Erasmus el Centro Para Historias del Futuro (CHIFT, Center for Histories of the Future ), en el que estudian y debaten la ciencia ficción y...
En el futuro los humanos hemos conseguido finalmente cargarnos la naturaleza. Hace 17 años que no hay árboles y 49 que no hay animales. Lo que queda de la humanidad vive en una ciudad colmena llamada Sumer, en un entorno férreamente...
El vídeo del viernes es en esta ocasión un cortometraje de esos rarunos, que juega mucho con el lenguaje visual y la sorpresa para dejar al espectador con la boca abierta –y una sonrisa– gracias al efecto de «entrada y salida»...
En esta ingeniosa publipromo la gente de Dissolve viene a demostrar que hay tantos clips de vídeo de stock que casi, casi podrías montar una película con ellos (vale, es un poco exagerado, pero para un cortometraje o un anuncio bien...
NASA/JPL/University of Arizona En HiRISE and “The Martian” se recopilan imágenes obtenidas por la sonda Mars Reconnaissance Orbiter de la NASA que muestran con detalle, en alta resolución, las zonas del MarteReal™ que aparecen en la película —y antes las novela, los...
Por Nacho Palou -
7 OCT 2015
Ahora que llega The Martian a la gran pantalla la gente de Burger Fiction ha aprovechado para recopilar un montón de escenas de películas con Marte como escenario: desde las primeras cutre-cintas de serie B con donde los efectos visuales consistían...
Preciosas ilustraciones estilo steampunk de Bjorn Hurri, con los personajes de Star Wars como protagonistas. Se pueden comprar directamente en su tienda como láminas de distintos tamaños por unos 30 dólares....
Con presupuestos de más de 100 millones de dólares cada una si se dedicara lo que ha costado producir Insterestelar (165 millones de dólares) + Gravity (100 millones) + The Martian (otros 100 millones) se podrían enviar cinco misiones orbitales reales...
Un fan de Regreso al futuro se ha dedicado a recopilar escenas extra, anuncios publicitarios y homenajes de otros aficionados al tema para darles forma y crear el «trailer homenaje» de lo que sería un hipotético Regreso el futuro 4. Una...
Presentado por Javier Sardá, hoy comienza ADN Max, un nuevo programa semanal dedicado a la ciencia en que tambien tendrán cabida humor, tecnología, magia, y entretenimiento. Para ello Sardá contará con colaboradores como Pablo Jáuregui, el redactor jefe de ciencia en...
Dicen que Tomorrowland es una castaña, pero si la ves con el espíritu relajado, la mente en modo juvenil y ganas simplemente de pasar un rato entretenido me parece que pasa del aprobado. Tiene acción, efectos especiales y una historia con...
Me da que este vídeo durará más bien poco en Vimeo por problemas de copyright y esas cosas, pero mola todo: Pink Floyd - Time feat. Carl & Ellie es un mashup de la historia de Carl y Ellie, los entrañables...
«Colosal» es poco. Un precioso vídeo de Andrew Walker sobre un lugar único en total decadencia: una central nuclear abandonada que nunca llegó a terminar de construirse (situada en Sastop, en el estado de Washington al noroeste de Estados Unidos). Como...
Burnt Grass (Hierba quemada), seleccionado oficialmente en el Festival de Cortometrajes de Sploid, es una curiosa historia sobre lo que le sucede a una pareja cuando descubren que algo «extraño» sucede en el jardín de su casa. No se puede revelar...
A partir del 20 de octubre Netflix estará disponible en España directamente a través de Internet — en móviles y tabletas, ordenadores, smart TV, Apple TV, Google Chromecast, videoconsolas y similares. Según la nota de prensa Netflix estará disponible «en prácticamente cualquier...
Por Nacho Palou -
30 SEP 2015
El desconocido (Dani de la Torre, 2015) Luis Tosar, Paula del Río, Marco Sanz, Goya Toledo, Javier Gutiérrez, Elvira Mínguez. Un viernes de fin de mes parece empezar como cualquier otro día para Carlos cuando se lleva a sus hijos al...

En mensajes para el futuro se mencionaba You, Me and the Apocalypse, una miniserie británica de Sky 1 con un planteamiento muy sencillo: contar la historia de los últimos 34 días de un grupo de personas cuando llega a la Tierra...
Ojo con los spoilers, que lo mismo descubres antes de tiempo que algún personaje de la extremadamente popular Juego de tronos sigue vivo... Pero la calidad de los efectos especiales empleados para dar vida a los dragones de la serie es...
Aunque su estreno estaba inicialmente previsto para el pasado domingo, en el mismo hueco que la primera temporada, al final los responsables de programación de La 2 han optado por colocar la segunda temporada de Órbita Laika los miércoles a las...

En HackerTarget se entretuvieron en revisar todas las escenas de Mr. Robot –nuestra nueva serie de hackers favorita– para ver qué herramientas y técnicas utilizan los hackers protagonistas en sus andanzas entre el bien y el mal a ambos lados de...
Toma una cámara, corre y que no te encontremos es básicamente el argumento del programa de televisión tipo reality que estrenará la cadena británica Channel 4 hacia navidades, Hunted. En la serie 14 voluntarios tienen que mantenerse desaparecidos durante 28 días...
Por Nacho Palou -
14 SEP 2015
BBBgtoby se entretuvo en recopilar en Letterboxd una enorme lista de todas las películas que se mencionan en Ready Player One, la novela de Ernest Cline sobre videojuegos, realidad virtual y cultura pop de los 80 que reseñé por aquí hace...
En la quinta temporada de Homeland Carrie Mathison ha dejado la CIA y está haciendo de jefe de seguridad de un multimillonario alemán en Berlín… ¿Qué podía ir mal? La respuesta, a partir del próximo 4 de octubre....
La gente de Finite Films rodó hace tiempo este cortometraje titulado Stealing Time («Robo de tiempo»), donde con ciertas limitaciones lograron condensar una simpática y enrevesada historia de viajes temporales. Stealing Time trata sobre la paradójica dificultad de cambiar el presente...
El Halcón Milenario de Air Hogs teledirigido es disimuladamente un quadricóptero con cuatro motores y efectos de luz y de sonido. De momento está a la venta en Amazon de EE UU por algo más de cien dólares — y me...
Por Nacho Palou -
7 SEP 2015
Adam Savage de Los cazadores de mitos se entretuvo en calcular la velocidad de las partículas disparadas por los rifles báster, que resulta ser de 208 km/h exactamente. Una velocidad muy apropiada para que los Jedi puedan evitarlos pero también muy...
Cuando se supo que el droide BB-8 que aparecerá en la próxima película de La Guerra de las Galaxias no era un personaje generado por odenador sino que era de verdad a muchos se les dispararon las alarmas: si existía como...
Por Nacho Palou -
4 SEP 2015
En la tienda de Lego de Amazon ya están disponibles los primeros modelos de Lego correspondientes a la película de Star Wars, El despertar de la Fuerza. En el caso del Halcón Milenario vuelve al catálogo de Lego. El mítico caza...
Por Nacho Palou -
4 SEP 2015
La película The 5th Wave (La quinta ola) se estrenará el próximo mes de enero en EE UU. Está basada en la novela del mismo título de Rick Yancey. La película, como el libro, trata de una adolescente que sobrevive a...
Por Nacho Palou -
2 SEP 2015
Al margen de esa posible película de Star Wars que tendría al cazarrecompensas Boba Fett como protagonista —y de la que no se sabe en qué momento de la saga transcurriría—, Eric Demeusy ha producido su propio tráiler de una hipotética...
Por Nacho Palou -
2 SEP 2015
Ver Back to the Future Trilogy in 1.21 Minutes no es lo mismo que ver las tres películas, pero si ya las has visto sirve perfectamente como recordatorio de qué sucede en cada una de ellas — y de paso muestra...
Por Nacho Palou -
1 SEP 2015
Sí, el mismísimo Neil deGrasse Tyson de Cosmos: una odisea del espacio-tiempo presenta en esta Our Greatest Adventure la misión Ares 3, la misma que Mark Watney cuenta desde su punto de vista en El marciano....
Code Rush (David Winton, 2000) es un documental sobre los ingenieros de Netscape a finales de los 90, cuando en plena Guerra de los Navegadores una de las empresas puntocom más emblemática, Netscape, decidió crear la Fundación Mozilla para que gestionara...
Ya tenemos tráiler oficial de The martian, la película conocida en España como Marte: operación rescate que narra la historia de un astronauta abandonado en Marte que tiene que buscarse la vida para sobrevivir hasta que alguien pueda venir a buscarlo....
El departamento de científicos locos está de enhorabuena: ¡Vuelve el boss! Aunque ya existen más de 170 películas con referencias al monstruo de Frankenstein, con unas 50 en las que se menciona a su macabro creador y tal vez cinco o...
Mad Max: fury roadGravity En Going green II: green screen shots before (and after) visual effects se pueden ver unas cuantas escenas de películas en las que se usaron efectos visuales digitales usando cromas para componer el resultado final. Igual que en...
Find #1 Movie Day You Were Born & Watch Trailer hace exactamente lo que dice: contarte qué película estaba en el número 1 –en los Estados Unidos– en el día de tu nacimiento, o en la fecha que le digas, lo...
El vídeo del viernes es un pequeño cortometraje sobre viajes en el tiempo: I’m You, Dickhead (2015, Lucas Testro). Narra las aventuras y desventuras de un tipo que decide hacer un viaje en el tiempo a su infancia, algo que en...
Este vídeo de cometas de Cy Kuckenbaker está grabado en el Tijuana Slough de San Diego (California) durante el mes de junio. Se utilizó una cámara BMCC full-frame con una lente de 80mm y se grabó en RAW a 2,5K. La...
Todos hemos visto películas de las que hemos salido protestando por lo malos que eran los efectos especiales creados por ordenador, si es que no hemos empezado a protestar antes de salir del cine. Pero este vídeo defiende la idea de...
Si tienes la suerte de pasar este verano por Londres tal vez te interese encontrar un hueco para ver la versión de Secret Cinema de Star Wars: El imperio contraataca. Se puede disfrutar hasta finales de septiembre. Es de la misma...

Si estás aburrido estas tardes de verano después de ver las noticias te habrás cruzado con Ciencia para aficionados, título políticamente correcto de Science of Stupid, un producción de National Geographic que tiene buenas dosis de ciencia seria, recreativa y –siempre,...
En Digg, The History Of Aliens In Film, Desde su aparición en la película Viaje a la Luna de Georges Méliès en 1902, nuestra idea sobre la vida fuera de la Tierra ha ido evolucionando para reflejar nuestras esperanzas y nuestros...
Por Nacho Palou -
3 AGO 2015
Los vídeos All Changes Made to Star Wars de Marcelo Zuniga (A New Hope I, A New Hope II; The Empire Strikes Back, Return of the Jedi) comparan las escenas que han sufrido cambios y ediciones especialmente en las películas de...
Por Nacho Palou -
29 JUL 2015
A finales del siglo XXI la humanidad ha descubierto la forma de viajar más rápido que la luz y hay una nueva tierra que colonizar. Pero no todo el mundo puede permitirse dar el salto, así que florece un negocio ilegal...
Las persecuciones de coches son un ingrediente casi imprescindible en cualquier película de acción desde que los coches son coches y desde que el cine es cine. Aunque se considera que fue la película Bullitt la que «revolucionó los estándares de...
Por Nacho Palou -
28 JUL 2015
–¿Estás lista para esto, Scully?–No creo que podamos escoger. Ya falta menos para que vuelvan Mulder y Scully y sus Expedientes X… En enero de 2016 en la Fox. (Vía @lagamez)....
Ver Pixels (2015, Chris Columbus) es toda una experiencia: es como un viaje temporal a los 80, un poco al estilo del Jacuzzi en el tiempo pero poniendo el foco en el mundo de los videojuegos. El argumento es simple y...
Por fin el tráiler honesto de Interstellar subtitulado en español y, ojo, lleno de spoilers. Y sí, a mí no me gustó mucho Interstellar a pesar de las esperanzas depositadas en ella. Tengo que dejar de ver tráilers. O algo. (_IvanBlues_...

QuoDB es un sencillo y estupendamente diseñado buscador de frases y citas de películas de todas las épocas. Simplemente escribes la frase y recibes las respuestas: película, año e incluso la carátula, que sirve como guía visual. Por desgracia solo funciona...
{Nota: contiene ligeros spoilers que quizá prefieras evitar; pero probablemente no son nada que no mostraría el trailer.} De entre todas las películas sobre máquinas en el tiempo que existen -y hay más de 1500 catalogadas- Project Almanac (2015) de Dean...
¿Ha perdido Hollywood el rumbo? se preguntaban hace tiempo en Short of the Week. Los amantes del cine reconocerán que en cierto modo la situación es un poco penosa. La imagen, que muestra las películas originales frente a las adaptaciones y...
Esta semanita sigue cargada de trailers y adelantos sobre películas tan lejanas como 2016: este es el caso de Superman vs. Batman: Dawn of Justice (traducido como El origen de la justicia por Warner). El megatrailer tiene de todo, Wonder Woman...
Un pequeño regalito del que han podido disfrutar los asistentes a la Comic-Con de San Diego de 2015. Y a seguir esperando al 18 de diciembre al estreno de El Despertar de la Fuerza. Cada vez con más ganas. A ver...
Me había mentalizado para recibir una patada en el estómago y tragarme una patata integral al ir a ver Terminator Génesis pero nada más alejado de la realidad: una película tan difícil de plantear como de resolver y resulta que va,...
Es una creación de Otto Dieffenbach de Flyguy Promotions (ojo, vídeo con reproducción automática en este enlace), fabricado para la Comic Con de San Diego de 2015. Hay otro pequeño vídeo en Star Wars Episode VII Flying R2-D2 Coming to Comic-Con....
Para los que aún sigáis las andanzas de Carrie Mathison y compañía, aquí va el teaser trailer de la quinta temporada de Homeland. En sus torrents en el otoño de 2015. O lo mismo hasta en Netflix. Ojo, contiene un pequeño...

Devon Avery dirige este cortometraje en el que como en la famosa escena del bar de Atrapado en el tiempo (o más recientemente, Al filo del mañana) alguien trata de conquistar a alguien, aprovechándose de reintentos e reintentos, tantos que se...
Hoy en día casi todos son digitales, pero… Hubo un tiempo que en que los proyectores de películas eran mecánicos. Gracias a un sinfín de mecanismos a cual más ingenioso conseguían crear la ilusión del movimiento manteniendo el tiempo preciso cada...
La gente de Dolby nos consiguió muy amablemente unas entradas pera ver San Andrés, la última de catástrofes dirigida por Brad Peyton y con Dwayne Johnson «La roca» como protagonista. La falla de San Andrés en California se sacude violentamente, forma...
Si mis cálculos son correctos, cuando esta belleza llegue a 140 kilómetros por hora vas a ver algo acojonante.– «Doc» Emmett Brown, enviando el DeLorean al futuro(Regreso al Futuro, 1985) Regreso al Futuro se estrenó el 3 de julio de 1985...
Ulysse (2013) es un cortometraje de Hugo Bodoukian, sobre un futuro un tanto sucio y oscuro en el que todo es masivamente gigantesco y desproporcionado, y en el que la música (de Sébastien Églème y Simon Tribault, con Marion Tassou) tiene...
Ahondando en la respuesta a ¿por qué los efectos especiales de las películas de hoy en día son menos creíbles que en los 90? este vídeo de la gente de NewMediaRockstars aporta algunas comparaciones entre escenas del antes y el después...
Este pequeño vídeo de StoryBrain explica una teoría según la los efectos especiales más creíbles del cine se consiguieron en los años 90. Y se pregunta: Pero si hoy en día existen ordenadores más potentes y nuevas tecnologías… ¿Por qué basta...
Mr. Robot (de Sam Esmail ) es de momento el episodio piloto una altamente prometedora serie que es tan geek, tan geek que le gustaría hasta al sysadmin de tu empresa. Después de leer buenas críticas en Twitter me entretuve en...
En septiembre vuelve Heroes Reborn, continuación natural de Heroes, una de las series que allá por 2006 tuvo uno de los más prometedores episodios pilotos tan solo para resultar decepcionante a medida que pasaban los episodios y las temporadas (llegó a...
En VashiVisuals, The Editing of Mad Max: Fury Road, La tendencia más popular para editar escenas de acción en los últimos diez años ha sido el denominado Chaos Cinema. Filmaciones a golpes y aparentemente al azar que abruman al espectador con...
Por Nacho Palou -
23 JUN 2015
Estuve viendo Ecstasy of Order: The Tetris Masters (2012) un documental sobre uno de los campeonatos mundiales de Tetris (2010) donde se hace un perfil de los tipos de jugadores, se recupera la figura de algunos nombres legendarios de los 80...

The Rise and Rise of Bitcoin de Nicholas Mross es documental de 2014 (la fecha aquí es crítica) sobre el fenómeno Bitcoin. El director cuenta su propia experiencia como minero de bitcoins desde 2011, a la vez que cuenta cómo un...
Si te aburres este fin de semana tal vez quieras probar a ver Derelict que es una combinación de dos horas y media de Alien: el octavo pasajero y su precuela Prometheus. Dado que Prometheus es cronológicamente anterior a Alien lo...
The Last One de Daniel Titz y Dorian Lebherz, En el año 2058, después de años de investigación, los humanos finalmente han logrado alcanzar el objetivo para el que han estado trabajando durante mucho tiempo. Han conseguido robots con la misma...
Por Nacho Palou -
12 JUN 2015
¡Valar Morghulis! {Y aviso de spoilers de paso.} El universo de ficción de la exitosa saga de Juego de tronos / Canción de hielo y fuego tiene su propia consistencia; en este vídeo no se exploran precisamente las semajanzas con nuestra...
Halt and Catch Fire, conocida por el nemónico HCF, fue en origen una instrucción ficticia en código máquina que se decía estaba siendo desarrollada por IBM para su uso en sus computadoras System/360 (…) se refiere a una instrucción en código...
The Hiker de Moth Media es un corto —muy corto, menos de tres minutos— que trata sobre un tipo que se va a dar un paseo por el campo para airearse. El corto participa en My Rode Reel donde se pueden...
Por Nacho Palou -
9 JUN 2015
Pues nada, que en el paso del libro al cine la 20th Century FOX España ha masacrado un poco el título y El marciano se ha convertido en Marte: operación rescate… Pero aún así tiene toda la pinta de que habrá...
En el vídeo Ares 3: Farewell el astronauta Mark Watney (Matt Damon) presenta a la tripulación del Ares 3 antes del lanzamiento — los compañeros que una vez en Marte y tras un percance darán por muerto a Watney y vuelven...
Por Nacho Palou -
8 JUN 2015
En un gran repaso a algunos de los clásicos de las películas de ciencia-ficción, la gente de Hope & Fears ha recopilado unos cuantos diseños interesantes: The ultimate guide to analog control panels in sci-fi movies. No están todos pero hay...
Pues después de años de rumores ya es oficial: De una entevista de Ángel Jiménez y Javier López con con Reed Hastings, creador y presidente de Netflix: El precio rondará los 8 euros al mes No estarán, al menos la principio, series...
En Wikipedia, Jaws (soundtrack), Compuesta por John Williams, la banda sonora de Tiburón (1975) ganó una premio de la Academia. La American Film Institute la puntúa como la sexta mejor banda sonora. El tema principal, Shark, que alterna simplemente dos notas...
Por Nacho Palou -
2 JUN 2015
Alan Warburton creó esta película utilizando una de las mejores y más conocidas piezas de Johann Sebastian Bach, El clave bien temperado, una obra en dos volúmenes que se compone de 48 preludios y 48 fugas que exploran con fines didácticos...
Hoy, 25 de mayo, se celebra el Día de la toalla, un día dedicado a rememorar y celebrar la vida y el trabajo de Douglas Adams, el autor de la Guía del autoestopista galáctico, enamorado de los ordenadores, y friki como...
¡Cuidado que vicia! Film Hunt es una estupenda base de datos que ha extraído la información de las «puntuaciones del público» de la IMDb en diversas categorías: ciencia-ficción, crimen comedia... Es básicamente un resumen de lo mejor del o mejor del...
Es lógico que tras 26 temporadas Los Simpson den señales de cansancio y agotamiento. Por no hablar de las infinitas repeticiones con las que cual día de la marmota nos deleita Antena 3 año tras año. Buena muestra de ello es...
Hay gente pa tó que desarrolla los artículos más inverosímiles, como esta increíble pieza de Critical Shit dedicada a la clasificación de las naves espaciales de la ciencia ficción. Más en concreto se refiere a las naves espaciales clasificadas según su...

En otoño llegará a los cines The Walk: a true story, una nueva visión de las hazañas del funambulista francés Philippe Petit a mediados de los años 70: Allá por 1974, Philippe Petit cruzó por un cable los 60 metros que...
El vídeo muestra el funcionamiento de la tecnología Exacto (Extreme Accuracy Tasked Ordnance) de Darpa, que utiliza un sistema de reconocimiento de imagen y proyectiles del calibre 50 capaces de cambiar su trayectoria durante el vuelo, una vez que han sido...
Por Nacho Palou -
15 MAY 2015
Es una de las películas más enigmáticas que haya visto nunca.– Steven Spielberg Según cuentan este cortometraje de Roger Christian –director artístico de La guerra de las galaxias– se proyectó en las salas británicas justo antes del comienzo de El imperio...
No es un pájaro. No es un avión. No es un hombre. Es… ¡Supergirl! Bueno, ha llegado el trailer-preview de Supergirl, una serie que se estrenará este otoño y que tiene como protagonista a la prima de Superman, aunque en versión...

Me pareció muy simpática esta pieza de National Geographic sobre las instalaciones de Iron Mountain, Inc. en una mina abandonada de Pensilvania. Un sitio que bien podría pasar por ser la guarida de algún grupo de malosos de 007, por el...
«Cuando descubres que todo el mundo te odia.» Después de revelar algunos personajes nuevos de Star Wars, Vanity Fair ha relatado algún detalle más, con cuentagotas, sobre el rodaje de Star Wars: The Force Awakens. Uno de los detalles revelados en Vanity...
Por Nacho Palou -
11 MAY 2015
Que sí, que ya tengo una edad, así que tremendo momento revival gracias a este vídeo. Creo que me he visto todas las películas que salen en él, a saber: Risky Business. Ferris Bueller’s Day Off. Sixteen Candles. El Club de...
Manolo nos envió un enlace al Pretenciosómetro (pretentious-o-meter.co.uk), un sitio web que ofrece un resumen rápido de la valoración de las películas según los críticos y según el público: (…) Básicamente lo que hace es comparar la nota que los críticos...
La fotógrafa Annie Leibovitz viajó a los estudios Pinewood en Londres, donde se están rodando el Episodio VII de La Guerra de las Galaxias: el Despertar de la Fuerza, revelando o confirmando por el camino algunos personajes nuevos junto con algún...
Por Nacho Palou -
5 MAY 2015
El 18 de marzo de 1965 Alekséi Leónov se convertía en el primer astronauta en dar un paseo espacial al salir de la esclusa inflable de la cápsula Vosjod 2 a las 8:34:51 UTC. El tiempo de los primeros trata de...
Beyond The Brick se estrenará el 31 de julio en los cines de EE UU. No es una película de Lego ni hecha con Lego sino sobre Lego. En Rotten Tomatoes, Desde el nacimiento de la marca en 1958, Lego ha...
Por Nacho Palou -
4 MAY 2015
The Visit, de Michael Madsen, se estrenó en el festival de Sundance; trata sobre cómo podría ser el primer contacto de la humanidad con una civilización alienígena que llega a la Tierra. Lo más interesante es que parece un poco diferente...
No trace, de Alex Forbes y Fancy Jam Pictures, es un cortometraje de ciencia-ficción sobre una asistente virtual llamada Jessica que se extralimita un poco en cuanto «toma el control del hogar». Y es que dejar nuestras vidas en manos de...
Siempre quise visitar la Antártida, pero no es cosa fácil. Por suerte películas como la de Kalle Ljung nos acercan un poco el misterioso continente cada vez con más calidad y capacidad de inmersión, aunque sea tras una pantalla plana de...
Ryan Connolly de Film Riot nos trae este simpático cortometraje humorístico de ciencia-ficción, en la línea de las clásicas escenas de ovnis al estilo de Encuentros en la tercera fase, Expediente X o Mars Attack. ¡Ah! Ya no hay películas como...
La nave Ares 3 llega a Marte donde hay una fortísima tormenta y la tripulación se ve obligada a regresar a la nave y abandonar el planeta. El personaje interpretado por [Matt] Damon recibe un golpe y se le da por...
Por Nacho Palou -
25 ABR 2015
Tomorrowland, de Brad Bird, está al caer (para mayo). Si los primeros trailers eran atractivos, este último resulta muy revelador. Es todo un festival de efectos especiales y escenarios futuristas al que ya le han encontrado reminiscencias de prácticamente todas las...
Markus nos escribió para explicarnos cómo creó esta mini película creada con papel, rotuladores y material de papelería –100 dibujos concretamente– utilizando como inspiración el mítico videojuego Ghosts’n Goblins de Capcom, que este año cumple su 30º aniversario. El trabajo está...
En The Doghouse Diaries, Emotion in Star Wars Films, “La amenaza fantasma” +“El ataque de los clones” +“La venganza de los Sith”vs.El trailer de “El despertar de la Fuerza”...
Por Nacho Palou -
19 ABR 2015
Nos vamos a hartar de aquí a fin de año a ver adelantos y detalles de la séptima entrega de Star Wars algunas están siendo geniales. He aquí al droide BB-8, uno de los supuestos modelos sucesores del pequeño R2-D2 al...
Aerotrastornados del mundo, preparaos... El 787-900 de ANA con una librea imitando a R2-D2 sí que se va a convertir en una de esas piezas que todos querremos tener en nuestras colecciones de fotos de aviones. Todos los detalles de esta...
Ay… Que hasta me están entrando ganas de ver El despertar de la fuerza. ¿Se me pasarán de aquí al 18 de diciembre? (@eurekablog vía RT de @maqqem)....
Ellen Stofan, científica jefe de la NASA, en Phys.org, We'll find alien life in 10 to 20 years, Creo que vamos a encontrar fuertes evidencias de que existe vida más allá de la Tierra durante la próxima década y pruebas definitivas...
Por Nacho Palou -
9 ABR 2015
Con la paciencia de un carpintero, el buen gusto de un diseñador y los conocimientos de un hacker de la electrónica Ochre Jelly construyó este disfraz de TARS uno de los metálicos robots de Interstellar. Las pantallas son auténticas y tan...
Para ser fan fiction, en Star Trek: Renegades aparecen hasta los actores de las series originales: el Comandante Tuvok (ST: Voyager) y el Admirante Chekov (ST: TOS); además de eso dicen que aparecerá por ahí también Corin Nemec (Parker Lewis) e...
Aunque no son versiones en VHS de verdad, sino que StanVHS creó estas carátulas de cintas VHS para películas y series actuales —y aspecto totalmente ochentero— con motivo de la pasada celebración del 1 de abril, el equivalente en otros países...
Por Nacho Palou -
6 ABR 2015
Lo suyo es, por supuesto, ver este vídeo en resolución 4K. Según sus autores, la productora Brain Farm, se trata de la primera grabación hecha con una Phantom Flex4K desde un dron. Se trata de una cámara de cine 'de verdad'...
Por Nacho Palou -
6 ABR 2015
Bloque a bloque, el vídeo Lego Back To The Future de Macro Lego Universe recrea la escena en la que Doc utiliza la energía del rayo que cae en la torre del reloj para enviar a Marty a su época, al...
Por Nacho Palou -
6 ABR 2015
El Palacio de Vistalegre de Madrid ha sido lugar elegido para la celebración el próximo 13 de junio (de 2015, dato importante en este evento) de Regreso al futuro en concierto, un espectáculo consistente en la proyección de la película junto...
The Reinvention of Normal (en YouTube, con subtítulos automáticos) es un breve documental de Liam Saint-Pierre acerca del diseñador, artista e inventor Dominic Wilcox que probablemente te sacará alguna sonrisa con sus extrañas e ingeniosas transformaciones de objetos comunes en objetos...
Por Nacho Palou -
3 ABR 2015
Artoo in Love es un simpático cortometraje de Evan Atherton donde el protagonista en R2-D2, probablemente el más entrañable de los personajes de La guerra de las galaxias. El escenario es San Francisco; más concretamente el parque del Golden Gate y...
Ya tienen financiación, incluso para el primero de sus objetivos extra, que son subtítulos en español, francés, portugués, italiano, alemán, e inglés. Pero si quieres aún puedes apuntarte como cofinanciador de Back in Time, un documental en el que los protagonistas,...
TIE Fighter es un corto de animación dibujado con el estilo del anime japonés de los años 80. El corto plantea la clásica batalla de naves de Star Wars enfocada desde el lado del Imperio, con los pilotos de los cazas...
Por Nacho Palou -
27 MAR 2015
Dicen de Sundays que prácticamente es «el cortometraje de moda» y gente que sabe mucho de cine que lo describe vehementemente como «la definición de puta pasada». Lo cierto es que es un despliegue de efectos visuales, cuidada fotografía y delicado...
Fotos y más fotos de las miniaturas de Blade Runner; 142 en total. Sencillamente impresionante. Porque téngase en cuenta que la época de Blade Runner (1982) los ordenadores eran rudimentarios y no podían utilizarse para crear los efectos especiales que emplean...
Tanta pasión por los videojuegos retro va a tener por fin su compensación: Pixels, que se estrenará el próximo verano, tiene una pinta estupenda y nos traerá a la tierra a unos alienígenas confundidos y convertidos en forma de Pac-Man, «moscas»...
A partir del 18 de marzo de 2015 podemos disfrutar del «montaje final y definitivo» en versión original de Ridley Scott de Blade Runner en 35 salas de cine de España. Blade Runner es una de nuestras películas favoritas de todos...
En Reddit, esta imagen compara los temas con los que algunas cadenas (de pago en España) tratan de asociarse y lo que realmente emiten, al menos en cantidades considerables. La cadena “Animal Planet” no me suena, pero cualquiera que haya visto...
Por Nacho Palou -
17 MAR 2015
Combinando un pequeño cuadricóptero teledirigido y una versión a escala de juguete de una moto jet comercializado por Hasbro en los años 80, Adam Woodworth construyó esta versión teledirigida de una ‘moto speeder’ imperial. El modelo dispone de una cámara frontal...
Por Nacho Palou -
15 MAR 2015

Y otros ‘dobles-cortos’ —cortos por cortometrajes y cortos también en la longitud de sus títulos— para echar el rato: Anomaly Entangled Génesis Silo Closer Ambition Project Skyborn The Gift...
Por Nacho Palou -
13 MAR 2015
Queeeeeé casualidad que los terremotos siempre ocurren en la zona de Hollywood, siempre hay olas gigantes que engullen el Golden Gate (¿cuántas películas ya?) y que los protagonistas pueden correr y saltar como si tuvieran superpoderes en las más pintorescas situaciones...
Nightcrawler (2014) de Dan Gilroy. Con Jake Gyllenhaal, Rene Russo y Bill Paxton. Con unos actores más que dignos y una historia entre lo cotidiana y lo diferente, Nightcrawler resulta altamente entretenida: cuenta la historia de un joven que trata de...
Bueno, en realidad no, porque en el Banco de Canadá están pidiendo a la gente que no se dedique a tunear los billetes de 5 dólares en los que sale el séptimo primer ministro de la historia de Canadá, Sir Wilfrid Laurier...

Mazinger Z,puede controlar la pazcon su energía mortal…– bizarra letra de la canción de Mazinger Z, versión española Un tuit de Acevedo me recordó hoy que un 4 de marzo como hoy, pero de 1978, se emitió el primer episodio de...

Mañana se estrena esta nueva serie de la Fox de la franquicia CSI (Crime Scene Investigation), en este caso situada en la darknet y la web profunda. Seamos claro: o la amaremos o la odiaremos, porque tiene el típico problema de...
El bienestar de la mayoría supera al bienestar de la minoría, o de uno solo.– SpockStar Trek II: La ira de Khan Con 83 años ha fallecido Leonard Nimoy, el actor que interpretó durante décadas a Spock, el oficial de orejas...

Este corto documental de James Benning se montó tras una entrevista con los artistas que dieron vida a Jabba el Hutt, el viscoso y repelente antagonista de Han Solo que apareció por primera vez en El retorno del Jedi de la...
Así que es buena ocasión para revisitar la película y también para indagar qué es un informe TPS, vía 20 Things You Might Not Know About 'Office Space'. En el MundoReal™ un informe TPS se refiere a Testing Procedure Specification, un...
Por Nacho Palou -
19 FEB 2015
Poderoso el frikismo es en General-Driver, el autor de The lunch time of construction trooper, todo un friki-homenaje al clásico de Charles C. Ebbets, Lunch atop a Skyscraper: Claro que trabajar en la Estrella de la Muerte no estaba exento de...
Por Nacho Palou -
9 FEB 2015
No deberían exisitir fronteras para el esfuerzo humano. Por muy dura que nos parezca la vida mientras hay vida hay esperanza. La teoría del todo (James Marsh, 2015). Eddie Redmayne, Felicity Jones. En 1963 Stephen Hawking, en aquel entonces un estudiante...

¿Por qué el cine se fotografía a 24 imágenes por segundo? ¿No es cierto que las películas antiguas utilizaban únicamente 16 o 18? ¿Y por qué en en televisión se usan 50 o 60? Todas estas preguntas tienen su respuesta técnica...
Alien es una de las pocas películas que me han hecho pasar miedito en el cine. Hoy, 5 de febrero de 2015, y para celebrar el 35.º aniversario del Óscar que le dieron a los mejores efectos especiales, Cinesa proyecta el...
Carlos Sisí tiene un impresionante álbum fotográfico de sus creaciones en Lego y Hasbro con Star Wars y otras películas de ciencia-ficción. El resultado son una espectacular serie de imágenes con fondos caseros en diversos ambientes altamente realistas y que pueden...
StoryCharts es un ejercicio visual mediante el cual se describe una película troceando convenientemente en sus arcos argumentales y diferentes momentos claves. De esta forma se pueden ver las «historias dentro de las historias» y sus altibajos. Cada momento además tiene...
En, The 6 Most Messed Up Things In 'Star Wars' No One Talks About, Cuando Obi-Wan lleva a cabo su plan de ser asesinado por Darth Vader para convertirse en un fantasma-consejero lo único que deja tras de sí son su...
Por Nacho Palou -
28 ENE 2015

Ya sea con sables, dagas o espadas láser, los duelos de espadachines son una de las grandes diversiones del séptimo arte. Y da igual que los duelos tengan lugar en en escenarios medievales como los de La princesa prometida, en la...
Hay un concurso en marcha para el diseño de un laberinto gigante de unos 900 metros cuadrados en el hotel Stanley, el «Overlook» de la película El resplandor (1980) de Stanley Kubrick, basada en un libro de terror de Stephen King...
Dino Ignacio ha hecho una remezcla con comentarios acerca del Episodio IV de La guerra de las galaxias concentrándose en todos los elementos de interfaz en los que los protagonistas interactúan con máquinas, puertas, pantallas, palancas, interruptures y botones. El resultado...
Tras el terremoto de Los Ángeles de 1994, que dejó buena parte de la ciudad a oscuras, la policía recibió numerosas llamadas de ciudadanos preocupados por una curiosa nube plateada que veían en el cielo. Se trataba de la Vía Láctea,...
Educación 3.0 acaba de publicar esta lista de 15 películas basadas en las matemáticas con la idea de que ver películas en las que los conceptos matemáticos son de alguna manera los protagonistas puede ayudar a desarrollar un interés y la...
La Gran Guerra Marciana (Canal Historia, 2014). En el verano de 1913 un misterioso objeto en apariencia procedente de Marte se estrella en lo más profundo de la Selva de Bohemia. El Kaiser envía a sus tropas a investigar, y estas...
A Guide to Classic Cars on the Big Screen cuenta algún dato curioso sobre algunos de los coches clásicos más conocidos del cine, caso de los Mini de Italian Job (1969), el Volkswagen Escarabajo de Herbie (1969), el Ford Falcon de...
Por Nacho Palou -
19 ENE 2015
SE BUSCA: Alguien para retroceder en el tiempo conmigo. Esto no es una broma. Apartado de correo 322, Oakview, California 93022. Se paga al regresar. Traer armas propias. Seguridad no garantizada. Solo he hecho esto una vez antes. No vi en...
Swiss Star Wars son pósteres de La Guerra de las Galaxias con la tipografía Helvética diseñados por Fernando de Carabassa, vía Design Taxi....
Por Nacho Palou -
16 ENE 2015
I like to fly, un vídeo con tomas sueltas realizadas a lo largo de 2014 por Stuart Gibson, un fotógrafo al que le encanta surfear pero que últimamente anda enamorado de lo que se puede hacer con un dron, al que...
Si tienes un par de horas libres puedes aprovechar para echarle un ojo a la versión de 2001: una odisea en el espacio que acaba de publicar Steven Soderbergh. Son 110 minutos, uno 50 menos que la versión de Kubrick. Soderbergh...
En 10 Science Fiction Doomsdays That Could Theoretically Happen, un repaso a un decena de desastres naturales y artificiales capaces de terminar con la civilización que, aunque suceden en películas, son más o menos posibles: Debido a hiperhuracanes capaces de despeinar...
Por Nacho Palou -
14 ENE 2015
A pesar de que Mikel me tiene prohibido ver trailers para no llegar a conclusiones autoespoileadoras de las películas me atreveré a decir que Chappie parece Cortocircuito pasada por el filtro de Neill Blomkamp, el director de Distrito 9. Citando a...
Cosas originales que puedes hacer con píxeles. Bonito e ingenioso....
The imitation game (Descifrando Enigma) (Morten Tyldum, 2014). Benedict Cumberbatch, Keira Knightley. El trabajo de Alan Turing en Bletchley Park, en especial entre 1939 y 1941, mientras desarrollaba lo bomba criptográfica que permitió descifrar los mensajes codificados con las máquinas Enigma...
Anomaly de Salomon Ligthelm y Dan DiFelice es una película independiente que obtuvo la financiación necesaria para su rodaje y producción en la primavera de 2013, a través de una campaña en Kickstarter y que ahora se puede ver gratis, online....
Por Nacho Palou -
1 ENE 2015

Desde el departamento de yo-quiero-estar-ahí llega esta historia sobre Secret Cinema: un grupo que organiza experiencias relacionadas con el cine y la forma de ver las películas. Básicamente se trata de aprovechar las temáticas de grandes películas o temas de moda,...
De Predestination (2014) -de los hermanos Spierig- dicen que es la madre de las películas de viajes en el tiempo. El protagonista es Ethan Hawke y Sarah Snook tiene un gran papel. Y hasta aquí puedo contar para no spoilear. Tan...
Cinema space tribute es una pieza de Max Shishkin que reúne clips de un montón de películas de ciencia ficción como homenaje al espacio en el cine. La banda sonora es Mountains, de Hans Zimmer, de la banda sonora de Interstellar;...
Arriba: versión remasterizada y en 19:9, donde «los vampiros toman el sol»Abajo: versión original «oscura y tenebrosa», en 4:3 Fox’s sad attempt at revamping Buffy is ruining the slayer (en The Verge) cuenta con todo detalle uno de los mayores desastres de...

Esta delicioso documental titulado Linotype: The Film (2012) cuenta la historia de la linotipia, un invento que revolucionó a finales del siglo XIX la forma de preparar los textos para las imprentas. Estos monstruosos victorianos, imposibles y descomunales artilugios mecánicos, eran...
Ando estos días enganchado a The Knick (de Steven Soderburgh), una serie de diez episodios producida por Cinemax y protagonizada por Clive Owen que se podría resumir de muchas formas, pero por abreviar: Un Dr. House en el Nueva York de...
Ryan Emond nos ha dejado en Vimeo esta preciosa obra de pr0n para rascacielostrastornados en la que enseña la ciudad canadiense de Toronto con infinidad de imágenes desde las alturas, tomas aéreas y time-lapses a todas horas del día. Es todo...
Mañana. Estoy de vuelta.– Terminator: Génesis (2015) Ni puertas giratorias ni ná: Un trabajo digno para un político cuando acaba su carrera: actor de películas de acción. (¡Y con 67 tacos!) Podremos verla el próximo verano....
La película podrá considerarse mejor o peor, pero solo por esta escena merece la pena. En X-Men: Días del futuro pasado el peculiar Quicksilver realiza un numerito propio de un mutante nacido con el don de la supervelocidad en una huída...
No se puede decir que hayan tardado mucho los memes del trailer del Episodio VII: el despertar de la fuerza. Ahí dejo mis dos favoritos hasta el momento: las instrucciones-tipo-IKEA del impactante estoque láser de Doealy Design y la versión alternativa...
Reconozcamos que este curioso remix de 2001 del videoremixer Eclectic Method (Jonny Wilson) tiene su aquel. En sus propias palabras: He necesitado que llegara el año 2014 para hacer un remix de 2001, pero con su relanzamiento en los cines británicos...
Her (Spike Jonze, 2013). Joaquin Phoenix, Scarlett Johansson. En un futuro no muy lejano Theo se gana la vida escribiendo cartas para la gente, cartas emocionantes y llenas de sentimiento. Pero su vida personal es un desastre tras haberse separado de...
Supongo que caeré como un pardillo igual que hice con las películas de la nueva trilogía, pero esa especie de Naranjito bobótico… Casi que huele demasiado a Disney. Siento venir una conmoción en la fuerza con El Despertar de la Fuerza....

Una historia corta sobre la soledad, la aventura y el autosacrificio. Lo que comenzó con una pequeña idea sobre una pieza de animación minamalista acabó siendo algo más complicado – y pero sin duda bello: SOLUS, una historia donde el protagonista...
La suponíamos completamente innecesaria dado la mala que era la tercera parte, y dios sabe que hay una alta probabilidad de que efectivamente lo sea… Pero oye, el trailer oficial tiene su aquel. La cuarta entrega de Parque Jurásico, que se...

Ni más que ni menos que Jim Parsons, más conocido como Sheldon Cooper, nuestro científico incomprendido favorito que durante años ha estado ocupado el mismo hueco del sillón de su apartamento en The Big Bang Theory. Lo va a tener difícil...
Esta featurette de Interestelar (Christopher Nolan, 2014) explica algunos de los detalles científicos sobre los que se trabajó durante la creación del guión y los efectos visuales de la película de ciencia-ficción del momento. Pero pese a todo lo que veáis...
Interstellar (Cristoher Nolan 2014). Matthew McConaughey, Anne Hathaway, Jessica Chastain. Las cosas en la Tierra están muy chungas porque cada vez es más complicado producir alimentos para los miles de millones de personas que la habitan; la agricultura es una actividad...
Vía Digg....
Por Nacho Palou -
3 NOV 2014
La isla mínima (Alberto Rodriguez, 2014). Raúl Arévalo, Javier Gutiérrez En los primeros años de la transición española dos policías llegan a un pueblo en las marismas del Guadalquivir a investigar la desaparición de dos hermanas adolescentes. Pero en un ambiente...
Este trailer muestra un pequeño avance de Ex Machina, una película de Alex Garland sobre robots, test de Turing y los retos de la inteligencia artificial – una de las mayores amenazas a las que nos enfrentaremos en las próximas décadas....
Viaje Alucinante (1966), de Richard Fleischer / X-Ray Delta One Estaba revisando las relaciones con el séptimo arte de Isaac Asimov, el popular divulgador científico y autor de ciencia ficción, cuando me encontré con un par de curiosidades interesantes. El caso es...
Esa maravilla de Terry Gilliam llamada 12 monos entró en nuestro Top 10 de mejores películas geek de todos los tiempos¹ –que por cierto ya va siendo hora de renovar, porque falta casi toda la última década– y ahora SyFy va...
Matthew Raetzel es el creador de Star Trek: Horizon, un largometraje de esos creados por fans, ambientado la época del Enterprise. La verdad es que tiene una pinta estupenda, con romulanos, batallas y unos efectos especiales y decorados envidiables. El presupuesto...
Sólo en la trilogía original de Star Wars mueren unos 5 millones de soldados imperiales; más de 2 mil millones de seres en total según estimaciones de la Wookieepedia, el wiki de Star Wars. Y todas esas muertes aparecen y se...
Por Nacho Palou -
29 OCT 2014
Pues poco más hay que decir, 140 fotos de modelos de naves y vehículos utilizados para la trilogía original de La Guerra de las Galaxias (1977-1983), para procrastinar un rato viendo como se hacen efectos especiales de la vieja escuela. (Vía...
Bag Man, una historia de apenas quince minutos que te deja con más preguntas que respuestas y que de de nuevo pone de manifiesto aquello que decía el tío Ben de que un gran poder conlleva una gran responsabilidad. (Jack Moreno...

Como anticipo de la nueva versión remasterizada digitalmente de 2001: Una odisea del espacio –ante lo que muchos salivamos– el British Film Institute ha creado un nuevo trailer con las mejores escenas del largometraje de Kubrick. Ni que decir tiene que...
Nada tan inocente como un niño que le pide a su padre que mire debajo de la cama después de arroparlo y antes de irse de su habitación… O no. Sin sangre, sin ruidos a volumen brutal, Tuck me in transmite...
Al igual que hicieron con La guerra de las galaxias: uncut, los fans han completado ya las más de dos horas de remake de El impero contraataca, repartiéndose el trabajo escena a escena y montando el largometraje completo con su banda...
Aunque en este corto titulado Envoy se reconocen muchas escenas y momentos ya vividos en numerosas películas de ficción, desde El Gigante de Hierro a Señales; e incluso el alienígena de turno tiene aspecto, y suena, como un "Predator", también hay...
Por Nacho Palou -
1 OCT 2014
Una pequeña historia sobre un experimento de entrelazamiento cuántico que sale… mal. Hay quien la compara con Primer, esa pequeña joya indie sobre experimentos en el tiempo gracias a un invento «de garaje» y bajo presupuesto. Mejor verlo pronto porque dicen...
The Physics of Space Battles cuestiona la posibilidad de que puedan tener lugar en el EspacioReal™ las batallas a las que nos tiene acostumbrados la ciencia ficción en general y la Guerra de las Galaxias en particular. ¿Por qué viajo con...
Por Nacho Palou -
24 SEP 2014
Atresmedia acaba de lanzar CreaCultura, un «movimiento para defender y dar valor a la Propiedad Intelectual», aunque si ves este vídeo, es más de lo mismo, con la vieja cantinela de que si las descargas no autorizadas destruyen puestos de trabajo....

Si nunca has jugado al rol, ya estás tardando. Para inspirarte, qué mejor que Héroes de Papel y Lápiz un documental de aficionados realizado para celebrar el 40º aniversario de Dungeons & Dragons (Dragones y Mazmorras). El trabajo es muy personal...
Al igual que el año pasado y el anterior, el 16 de noviembre se celebrará el Timelapse Showfest 2014, una proyección en superpantalla gigante de esos vídeos que tantos nos gustan: los time-lapses. Buen momento para disfrutar de grandes trabajos, muchos...
Desde el departamento de cómo plantear un vídeo de vacaciones para que al verlo no sea un aburrimiento integral nos lleva este divertido y marchoso montaje de Miguel Campos, que recomiendo ver en HD por la calidad y volumen a tope,...
Aviation: The Invisible Highway es una película todavía en producción sobre la historia de cómo la aviación ha cambiado el mundo: Filmada en 18 países de los 7 continentes, esta película muestra nuestro precio por los aspectos más extraordinarios e inspiradores...
Una forma impactante de ver una de las ciudades más bonitas de Europa: sin gente en sus calles. La técnica consiste en grabar el time-lapse y luego minuciosamente eliminar todo rastro de actividad humana y movimientos: personas, luces de los semáforos,...
En el universo de Espacio 1999 el 13 de septiembre de 1999 la explosión de un depósito de residuos nucleares en el lado oculto de la Luna arranca a esta de su órbita y la lanza a toda velocidad por el...
Para ir desfogando al final de la semana, Nuestra Tierra - Our Earth, un vídeo montado por Fede Castro con fotos tomadas por los tripulantes de la Estación Espacial Internacional aprovechando que estás están disponibles para su uso en la Earth...
Nick Acosta se preguntó cómo se verían las viejas escenas de Star Trek, que ya tienen casi 50 años, en formato panorámico así que dedicó algo de tiempo en convertirlo en un proyecto personal para comprobarlo. El resultado son las fotografías...
No siempre los time-lapses espectaculares que se ven por Internet están rodados en lugares lejanos, inaccesibles y exóticos; aquí tenemos el magnífico trabajo de Miguel Ángel Langa en el Parque Natural del Alto Tajo, donde ha pasado más de seis meses...
Una historia entrañable y futurista en un anuncio publicitario de esos a los que los del mundillo prefieren llamar «películas». La música es de Morning Phase, de Beck....
Prelude to Axanar hará las delicias de los fans de Star Trek y las batallitas espaciales: es un cortometraje que recrea una historia anterior a las del Capitán Kirk y Spock en la serie original, llena de batallas espaciales y con...
Las Vidas Posibles de Mr. Nobody (Jaco Van Dormael, 2009). Jared Leto, Sarah Polley, Diane Kruger. A principios de febrero de 2092 el mundo sigue atento los últimos días de vida de Nemo Nobody, el último ser humano que morirá de...
TVFLOORPLANSandMORE es una colección de los planos de las viviendas de series de televisión, obra de Iñaki Aliste Lizarralde, que abarca películas y series desde Las Chicas de Oro o Friends hasta Los Simpson, Seinfeld, Carrie Bradhsaw de Sexo en Nueva...
Por Nacho Palou -
5 SEP 2014
Abiogenesis es un corto de ciencia ficción creado por Richard Mans en el que un curioso dispositivo mecánico aterriza en un planeta desolado y usa el planeta para sufrir una completa transformación, transformación que también afecta al resto de la galaxia....
El vídeo de arriba es el tráiler de la reedición de El Imperio Contraataca hecha por fans, inspirada en el estilo narrativo y en la música utilizadas en las películas de Quentin Tarantino, en especial Kill Bill. Los seis capítulos suman...
Por Nacho Palou -
3 SEP 2014
Desde que los ordenadores dominan esta parcela del cine estamos ya de vuelta con el tema de los efectos especiales y es extremadamente difícil que nos logren sorprender con nada. Por eso el mérito que tenía Karel Zeman, que jugando con...
Guardianes de la Galaxia (James Gunn, 2014). Chris Pratt, Zoe Saldana. Mala, mala, incluso siendo Marvel. Se supone que es de humor pero ni la historia vale nada ni los chistes son gran cosa. Una pena porque los trailers prometían diversión....
{Ligerísimos spoilers} Merece la pena por la calidad del montaje y el vídeo HD echar un vistazo a los efectos visuales de la última temporada de Juego de Tronos, una de las series de moda. Esta es una de las cintas...
#RESPETO. Quién iba a pensar que una serie protagonizada por un profesor de química que acaba usando Heisenberg como alias triunfaría del modo que lo ha hecho: pues ahí está Breaking Bad con premios (categoría «drama») a la mejor serie, mejor...
Este cortometraje de Jason Gwynn narra de forma emotiva el final de las proyecciones analógicas ante la imparable llegada del cine digital. Y es que en un momento en el que las distribuidoras han decidido que ya no enviarían más rollos...
El vídeo de este viernes es Silo, un cortometraje de David Soll, que cuenta una peculiar historia sobre uno de los encargados de un silo de misiles nucleares, en un ambiente de soledad rodeado de botones y tecnología de lo más...

Después del verano llegará a las pantallas Autómata, una película de Gabe Ibáñez con Antonio Banderas, Birgitte Hjort Sørensen y Melanie Griffith. Según se puede ver en el trailer trata sobre un futuro distópico pero próximo en el que los androides...
Antiguamente la peor escena de la película era aquella en la que el protagonista encontraba una carta y se ponía a leerla (a cámara); hoy en día es inevitable mostrar cómo envían y leen mensajes en el móvil. ¿Qué soluciones han...
Con toques de Una mente maravillosa + historia romántica en noviembre llegará «La teoría del Todo», una película biográfica sobre Stephen Hawking, el físico, cosmólogo y divulgador científico. Aunque no sea una superproducción de Hollywood, a sus 72 años parece un...
Merece la pena relajarse un rato con este documental de John Hess de Filmmaker IQ titulado La historia del sonido en el cine, donde hace un somero y altamente interesante repaso a la tecnología del sonido que la industria cinematográfica ha...
Nos avisaron de que a partir de mañana 12 de agosto comienza La vida en números en National Geographic, una serie divulgativa para entender la estadística de una forma más visual y cotidiana. El conductor del programa en Jake Porway y...
A pesar de ser de la marca de coches de juguete Hot Wheels, este Darth Vader Car es un vehículo de verdad, a escala real y que funciona. Está construido sobre la base de un Chevrolet Corvette y tiene un motor...
Por Nacho Palou -
29 JUL 2014
Según parece la saga Mad Max no terminó Más allá de la cúpula del trueno; desde hace décadas existía el proyecto de rodar una cuarta parte de uno de nuestros futuros distópicos favoritos: un mundo sin combustible, con ciudades arrasadas y...

Benedict Cumberbatch = Alan Turing. Añádanse máquinas Enigma + ambientación en Bletchley Park y la temática relacionada de la II Guerra Mundial y tenemos una película que ya nos ha conquistado antes de que se estrene. El título del largometraje es...
Preciosas estas creaciones de Ryan Putnam que en su colección de diseños ha añadido versiones icónicas de la vestimenta de algunos protagonistas de películas míticas - entre ellas Marty McFly en la saga Regreso al Futuro, los Cazafantasmas, Rudolph y esperamos...
En el fluzeante Time Travel Lover, de Bo Mirosseni podemos ver uno de los posibles efectos de la invención de los viajes en el tiempo, especialmente cuando se empieza a ir de las manos a los protagonistas de la historia. La...

Dicen los que saben que la nueva película de Nacho Vigalondo (Los cronocrímenes, Extraterrestre) encantará a los geeks, habiéndola calificado de «un guión tan apasionante como el de Juegos de Guerra o Sneakers». Los protagonistas son Elijah Wood y una renovada...
Así, a simple vista, Dracula Untold = Juego de Tronos + Batman + las batallas de El Señor de los Anillos. Veremos....
Hardware Wars: The Mother of All Star Wars Fan Films (and the Most Profitable Short Film Ever Made), En 1977 al cineasta Ernie Fosselius le dio por hacer una parodia de una película que se acaba de estrenar. Fue una decisión...
Por Nacho Palou -
27 JUN 2014
Vía Geeks are Sexy....
Por Nacho Palou -
26 JUN 2014
Los seguidores de Star Trek quizá recordarán uno de las más emblemáticas naves de la serie, la lanzadera Galileo, un pequeño transbordador que llevaba a Kirk, Spock y compañía desde el Enterprise hasta la superficie de los planetas en sus aventuras....
Un documental que cuenta con todo detalle el proceso de creación de la saga Star Wars de George Lucas
El último episodio de la fantástica cuarta temporada de Juego de Tronos ha batido todos los récords de descargas en Internet: 254.114 personas compartiendo el mismo torrent simultáneamente: unas 190.000 al completo y 63.000 descargando. A las 12 horas de su emisión...
Gracias a los efectos especiales la Dra. Ryan Stone pasa de estar en su cocina vaciando el lavaplatos a flotar en el espacio. Before & After VFX Shots From Popular Movies & TV Show es una recopilación de escenas e imágenes de...
Por Nacho Palou -
16 JUN 2014
Este vídeo que forma parte de Everything is a Remix muestra cómo The Matrix (1999) = Total Recall + Fist of Legend + Tai Chi Master + The Killer + Iron Monkey + Once Upon a Time in China + Akira....
De ‘2001’ and beyond: Neil deGrasse Tyson names his top 10 sci-fi films: Ultimátum a la Tierra. 2001: Una odisea del espacio. El planeta de los simios. Terminator. Único superviviente. Contact. Deep Impact. The Matrix. La isla. Watchmen. Y confiesa que nunca...
Pues eso, poco más hay que decir: Descargable del Halcón milenario para maqueta 3D. Eso sí, nunca me he dedicado a la rama de los recortables, así que no tengo mucha idea de si es medio fácil o si hay que...
Ojo, montones de spoilers de Gravity por si aún no la has visto. Alguien debería subtitular esto en español –la opción automática de YouTube no lo pilla muy bien– porque es para partirse la caja. Everything Wrong With Gravity - With...
Cortometraje: un auditor de cuentas revisa los vídeos de los mercenarios de una misión
El teletexto, ese simpático «fósil tecnológico» se niega a desaparecer en España
Documental sobre el auge y caída de la mítica empresa de tecnología, de cuyos laboratorios surgieron el transistor, el teléfono, el UNIX o el láser.
Vía The Verge....
Por Nacho Palou -
20 MAY 2014
En el futuro cercano los gobiernos y economías del mundo se han colapsado, la comida escasea, no existe la NASA y se culpa de todo ello al siglo XX. Pero entonces se abre un misterioso «agujero de gusano» en el espaciotiempo...
Lights out es el corto ganador de la categoría Mejor Cortometraje de FANT 2014, el Festival de Cine Fantástico de Bilbao de 2014. Mejor si no lo ves a solas. (Vía El Correo)....
He aquí el trailer de la próxima serie sobre Flash, el «corredor escarlata», el hombre más rápido del mundo, curiosamente uno de los personajes más entrañables –y relevantes– del universo de DC Comics. Está en crossover con Arrow, la otra serie...
Sí, después de lo que nos hicieron con Lost hay que tomárselo con un pelín de precaución, pero aquí queda el trailer de The leftovers, la nueva serie de Damon Lindeloff. Es la adaptación de una novela de Tom Perrotta que...
Un regalo –aunque regalo es un decir porque habrá que pagarlo– de Lucasfilms a los fans de La guerra de las galaxias, los storyboards originales de Una nueva esperanza, El imperio contraataca y El retorno del jedi en un libro con...
Cosmos: una odisea del espacio-tiempo (2014) es un remake del mítico documental de Carl Sagan de los años 80 que acercó el amor y la pasión por la ciencia a gentes de todas las edades. Esta nueva versión el mismo objetivo....
Si tienes unas 3500 horas libres –las vacaciones de semana santa pueden ser un buen momento para empezar– British Pathé, que es un poco el equivalente al NO-DO español, acaba de terminar de subir 85.000 vídeos a su canal de Youtube....
Las colonias del espacio exterior, llenas de aventuras y oportunidades, y el «más humanos que los humanos», lema de la Tyrell Corporation, ahora en forma de informales pero elegantes camisetas del universo Blade Runner en la Neatoshop....
Ocho apellidos vascos (Emilio Martínez Lázaro, 2013; guión de Borja Cobeaga y Diego San José). Chico andaluz –sevillano a más señas– conoce a chica vasca. Chicho se enamora hasta las trancas de la chica y se va a buscarla a su...
En junio de 2008 Promusicae, Sony BMG Music Entertainment S.A, Universal Music Spain S.A., y Warner Music Spain S.A. denunciaron a Pablo Soto reclamándole 13 millones de euros al entender que había desarrollado sus aplicaciones para intercambio de archivos mediante redes P2P...
Basada en el libro 1001 Movies You Must See Before You Die de Stephen Jay Schneider este vídeo, que a su autor le llevó más de un año montar, recoge escenas de esas 1001 películas que hay que ver antes de...
El documental es algo viejuno, probablemente es de hace unos diez años, pero hasta ahora no había tenido ocasión de verlo. En The Birth of the Lightsaber George Lucas habla sobre el origen de la espada láser que aparece en las...
Por Nacho Palou -
2 ABR 2014
Se estrenará próximamente y esto es solo el trailer: una pequeña píldora de 60 segundos para dar buena cuenta de las posibilidades de recrear protagonistas no-humanos. Será un largometraje y su título es Construct. Aspira no solo a mostrar cuán realistas...
Parece que fue ayer cuando terminamos de ver una historia alucinante de hackers, peleas con superpoderes, bullet-time y pseudofilosofía de todos los colores, tan solo para quedarnos pegados al asiento tras dos horas de impactos visuales en nuestras neuronas. Y es...
Apenas uno días después de que un juez denegara la petición de cierre de Goear.com por parte de la Comisión Sinde-Wert por considerarlo una medida desproporcionada se ha sabido que la Secretaría de Estado de Cultura recurrirá el auto judicial en cuestión,...
Tiny Worlds es una muestra de las técnicas de trabajo de animación por ordenador de Nuno Cortez que que muestra cómo es capaz de darle «otra vida» a juguetes y objetos cotidianos callejeros en menos de un minuto, combinando imágenes reales...

Lonani es el segundo episodio de Star Trek Continues, un proyecto del que ya hablamos por aquí cuando se lanzó el primer capítulo (Pilgrim of Eternity). Este proyecto hecho por fans sigue funcionando estupendamente: tiene el look de la serie clásica...
Lo cuenta con todos los detalles que puede David Bravo en Denegada judicialmente la primera orden del Ministerio de Cultura de cierre de una página web. Pero el resumen es que la Comisión Sinde-Wert pidió el cierre de Goear porque se habían...
En Hispaviación han hecho una recopilación de películas para aerotrastornados en El cine de aviación: un vistazo a nuestras películas favoritas que seguro que todos hemos visto: Elegidos para la gloria, sobre aquellos primeros astronautas del programa Mercury. Aeropuerto, una de aquellas...
Graph TV es una herramienta que recopila los datos que lo usuarios de la Internet Movie Database introducen en forma de votaciones y los convierte en gráficas para cada una de las temporadas de las series de televisión más populares. Cada...
Project Skyborn - short film de Marko Slavnic en Vimeo. Aunque el desenlace es similar al de un par de películas de los últimos años, merece la pena ver el corto Project Skyborn de Marko Slavnic, con una buena estética y...
Por Nacho Palou -
21 MAR 2014
... a veces tiene sus sorpresas. Aunque la historia que haya detrás puede llegar a ser más enrevesada de lo que parece....

Hay tantos vídeos de deportes espectaculares que –la verdad– ya aburren un poco. Pero cuando vi pasar los primeros segundos de Cómo bajar el Mont Blanc en speed riding, de Didier Lafond, queme quedé clavado. Hay quien dice que es el...
Dice Daniel Beaulieum, el creador de este proyecto de la escuela de cine de Vancouver titulado Malaise, que se inspiró en clásicos como Barbarella y Solaris aunque la historia también rezuma a Alien por todas partes. La animación 3D es de...
Félix Joleanes et al. son un grupo de fans de Matrix que han creado prácticamente de la nada Trickster, un cortometraje con el estilo visual y alguno de los artefactos de The Matrix, el clásico del género de la ciencia-ficción y...
Tras su estreno en los Estados Unidos Cosmos: a spacetime odyssey llega esta noche a España con la emisión simultánea del primer capítulo a las 23:00 en los canales National Geographic Channel, FOX, FOX Crime, Nat Geo Wild y Viajar. El...
Nuestras madres, nuestros padres, dirigida por Philipp Kadelbach. UFA 2013. Los hermanos Friedhelm y Wilhelm Winter se reúnen con sus amigos Charlotte, Greta y Viktor justo antes de partir hacia el este para incorporarse a la ofensiva alemana para conquistar la...
Luis Alfonso Gámez prepara su enésimo suicidio homeopático con Sedatif PC, y como siempre, sobrevive. Algo falla en esto. Me recordó mucho al capítulo correspondiente de Escépticos, algo que de hecho estaba avisado. Así que me parece muy recomendable el programa El...
Europa Report (Sebastián Cordero, 2013). Por fin he tenido tiempo de ver esta película en formato cuasi documental sobre la primera misión tripulada a Europa, la luna de Júpiter, en busca de señales de vida, misión financiada por una empresa privada,...
HUVr ha conseguido reunir a viejas glorias, famosetes variados y recuerdos imborrables en una pequeña historia que hace bueno aquello que decía Fox Mulder en Expediente X: Quiero creer...
La batalla de Stalingrado fue la mayor de la segunda guerra mundial, quizás la mayor de la historia, aunque el puesto de la más relevante probablemente le corresponda a la de Kursk. Stalingrad es una película de Fyodor Bondarchuk sobre esta...

Que todos esos ceros y unos vayan directamente a tu mierdecilla de teléfono inteligente y que cualquier gilipollas que se caga en los pantalones sea capaz de suscribirse en 12 segundos no es «magia», es sudor y talento. ¡Esto promete! Mike...
Ahora que Operación Palace parece haber descubierto a mucha gente la existencia de los mockumentaries o falsos documentales, un par de listas para ver de qué va todo eso. Una, en español, Grandes Documentales que Engañaron al Mundo, la otra, en inglés,...
Fer, quien en su momento hizo los planos para construir un Águila de Espacio: 1999 en papel, nos ha escrito para pasarnos un enlace que explica cómo fabricar una con palitos de helado, depresores linguales, y similares. Es un instructable que...
Ojo, contiene muchos spoilers, pero el trailer honesto de Gravity es una risa, en especial la parte que incluye sonidos de una máquina de pinball. (Vía @Elzo_). Los problemas de un espaciotrastornado con Gravity vs Lo bien que te lo puedes...
Todo depende, por supuesto, de lo que consideres otro idioma, sobre todo si llevas años acostumbrado a oír a los personajes de una serie doblados. En What The Simpsons Sound Like In Other Countries se puede ver –o mejor dicho oír–...
¿Reconoces a estos nerds galácticos? En Star Wars 80's High School hay una serie de ilustraciones de los personajes de La guerra de las galaxias ambientados y vestidos como si estuvieran en un instituto de los Estados Unidos de los años 80....
Gravity (Done in 60 Seconds) es la pieza con la que Leigh Lahav participa en el concurso Done In 60 Seconds de Jameson Empire. Ojo, spoilers. Como recordaréis los habituales de la casa, por aquí tenemos al menos dos visiones bastante...
Obi-Wan es el malo en Star Wars, — Oye Ben, gracias por el sable láser, es superchulo. ¿De dónde lo has sacado?— Oh, esa es la mejor parte, Luke. No sé cómo es que aún no te lo he contado. Le...
Por Nacho Palou -
10 FEB 2014
Dirigido por Jim Munroe, Just Ella apenas dura cinco minutos y casi no tiene diálogos, pero deja tanto a la imaginación que merece la pena verlo. (Vía Boing Boing)....
Ante el próximo estreno del remake de Robocop un grupo de fans ha decidido que ya se encargaban ellos de masacrar la película y han hecho Our RoboCop Remake, una versión libre de la película, bastante NSFW, todo sea dicho, en...
En realidad llegará a a la vez a 180 países en 48 idiomas tan solo un día después de su estreno en los Estados Unidos. En España el primer capítulo de Cosmos: a spacetime odyssey podrá ser visto a la vez...
Esta es LA camiseta que cualquier geek que se precie debería vestir el 21 de octubre de 2015. Idla pidiendo ya, no vaya a ser que se agote. Para los despistados, esa es la fecha en la que Marty y Doc...
Viendo el vídeo no queda nada claro de qué va la vaina, pero The After está producida por Chris Carter, creador de Expediente X, y sólo por eso merece un par de segundos de atención. En realidad se trata de un...
Por Nacho Palou -
5 FEB 2014
Reconozco que le tengo perdida la pista a Jack Bauer, el duro más duro de la televisión con permiso de Chuck Norris, pero para los que aún seguís sus aventuras, aquí está el teaser de la décima novena temporada, que se...
Las expectativas son enormes –y el recuerdo del Cosmos original muy poderoso– así que el batacazo puede ser morrocotudo, pero el próximo 9 de marzo comenzaremos a salir de dudas acerca de si la actualización de Cosmos merece la pena. Cosmos:...
Nelson Carvajal se ha entretenido en recopilar algunas escenas de todas las películas que han recibido un premio Óscar a los mejores efectos visuales desde hace 35 años, empezando por Star Wars. El resultado es una entrañable recolección de buenos recuerdos...
Un excéntrico, reclusivo y brillante programador sufre de una peculiar angustia existencial mientras trabaja en un misterioso proyecto cuyo propósito es descubrir el sentido de la existencia – o la ausencia de él. Sin embargo, es cuando experimenta en primera persona...
¿Cómo reaccionaría una persona que se hubiera visto convertida en un zombie si se descubriera una cura que volviera a convertirla en un ser humano normal? ¿Qué pasaría si pudieras recordar, auque sólo fuera parcialmente, en qué te convertiste y lo...
Pepe y los piratas[«A ver qué novelista que no sea un demagogo o un cretino se resiste a que lo lean más, en lugares donde el libro de papel no llega por diversas razones.» Arturo Pérez Reverte, 2009] vs. Ese fulano (quizás...
The Awareness, un corto de poco más de quince minutos para contar cómo en conserje de una pequeña start up se enfrenta a la decisión de su vida cuando una inteligencia artificial le pide que la destruya por el bien de...
En Vértigo. De entre los muertos (Hitchcock, 1958) este efecto visual de cámara dejaba al espectador con una extraña sensación de… acrofobia (¡apropiadamente!) En Tiburón (Spielberg, 1975) dejaba ver el impactante asombro del protagonista al quedarse espeluznado ante lo que acaban...
Al parecer, esta suculenta lata de Soylent Green junto con la galleta verde de la milagrosa comida de alto poder energético se vendió una subasta por unos 1.600 euros. No está mal para un pequeño trasto del atrezzo de una medio...
Es un poco viejuno, de la semana pasada, pero ahí va: 350 Kinds Of Zombies, Explained, «o cómo distinguir qué tipo de zombi es el que está a punto de comerse tu cerebro», A diferencia de un vampiro o de un...
Por Nacho Palou -
21 ENE 2014
Fight Club minus Tyler Durden from Richard Trammell on Vimeo. Alguien se molestó en borrar a Tyler Durden de esta escena de la película El Club de la Lucha, haciendo desaparecer al amigo imaginario del insomne protagonista. § Mashable....
Por Nacho Palou -
20 ENE 2014
¿Existirá el Pantone Tauntaun? Igual que el de la NASA el perfil de Star Wars en Instagram hace trampas porque las fotos que sube no están hechas con un móvil; de hecho los móviles, y mucho menos con cámara y conexión a...
Vesa Lehtimäki tiene una espectacular colección de fotografías hiperrealistas de Star Wars en Flickr, en varios estilos, totalmente dignas de admiración además de un ¡ooooooh! bien grande. Se trata de fotomontajes de todo tipo, la mayor parte escenarios reales a los...

– Pareces una persona, pero solo eres una voz que sale de dentro un ordenador.– Entiendo que la limitada perspectiva de una mente no artificial como tú lo vea de ese modo. Ya te acostumbrarás. Samantha es un sistema operativo de...
Anthony Daniels, más conocido como C3PO, protegiéndose del Sol Peter Mayhew, al que todos conocemos como Chewbacca, se entretuvo estos días publicando en su cuenta de Twitter, @TheWookieeRoars, fotos de los rodajes de las películas de la trilogía original de La guerra...
La Comisión Europea está recogiendo opiniones acerca de una futura reforma de los derechos de autor hasta el próximo 5 de febrero de 2014, incluida la cuestión de si hay que hacerla o no. Para ello es necesario leer la información y...
En Terminator se ve ensamblador del 6502, probablemente sacado de un Apple II Source Code in TV and Films es un Tumblr que se dedica a publicar capturas de pantalla de código fuente que sale en películas y series de televisión y...

Por fin un Star Wars sin gilipolleces.– un forero de OriginalTrilogy.com Este proyecto tiene una pinta genial, pero por alguna razón no lo vi pasar en su día. Se trata de una reconstrucción / remasterización llevada a cabo por fans de...
Eduardo nos cuenta que ha dedicado bastante tiempo a crear y hacer crecer Public Domain Movies, un blog dedicado a recopilar películas clásicas que son del dominio público. (Todas en inglés porque es prácticamente imposible conseguir dominio público en castellano.) La...
En una decisión que sin duda sólo puede tener sentido en las mentes corrompidas por los sistemas DRM de los altos ejecutivos de la empresa totalmente desconectados de la realidad Disney ha decidido retirar el acceso a algunos de los vídeos navideños...

Ese momento en que una máquina inteligente superará los límites de la biología. En poco tiempo su poderío analítico sera mayor que la inteligencia colectiva de todas las personas que hayan existido en la historia del mundo.Algunos científicos lo llaman la...
Un grupo de jóvenes descubre los planos de una máquina del tiempo y la construyen. Pero al final la cosa se les va de las manos y la lían parda. De momento esto es lo que sabemos de la fluzeante Welcome...
Cy Kuckenbaker se entretuvo en este pequeño proyecto consistente en grabar varios minutos del tráfico cotidiano de una autopista de San Diego y luego recortar y pegar en vídeo los coches según su color. El objetivo de su proyecto era analizar...

La próxima peli de nuestro admirado Christopher Nolan se llama Intestellar y este es el adelanto que se ha dejado ver – una mirada a la carrera espacial preparándonos para la futura carrera espacial de ficción que plantea en su argumento:...
Ya habíamos hablado por aquí de Paradoja temporal, una historia de gente corriente que se pregunta si dedicaría su vida a construir una máquina del tiempo; al parecer la historia ha funcionado y han preparado nuevos capítulos –llevan cuatro ya– con...
Clic para ampliar En All The Things That Are Wrong With Your Screenplay In One Handy Infographic, Un lector de guiones [que es un señor que se dedica a leer guiones], tras leer unos 300 guiones de cinco estudios de cine diferentes,...
Por Nacho Palou -
12 DIC 2013

Tom Cruise interpreta en Edge of Tomorrow al Teniente Coronel Bill Cage, que sin haber visto un sólo día de combate en su vida es enviado a luchar contra los Mimics, unos alienígenas que han invadido la Tierra. Y palma en...
Diez años después de que la productora Toho decidiera darle unas vacaciones por agotamiento Godzilla vuelve de la mano de Gareth Edwards. Por el trailer parece que el Godzilla de 2014 será: Godzilla la lía parda. Fallan todos los intentos estándar...
[Voz de señor que explica los trailers] «De los creadores de Matrix…» Pues efectivamente, porque este es el esperado trailer de Jupiter Ascending, la esperada película de los hermanos Wachowski. Y sí: es que llevaban desde los tiempos de Neo sin...
PacLaberinto de Shokxone Studios [clic clic para zum] Este póster que hibrida el Pac-Man + Laberinto, el pionero videojuego + la legendaria película de Jim Henson, se titula apropiadamente PacLaberinto. Tiene de todo, desde una «versión camiseta» a amplios títulos de crédito...
El vídeo del viernes de hoy es From Dust, de Daniel Winne: un pequeño corto de animación en el que es casi tan importante la banda sonora del mismo título de Paul Thomas Zito que la peliculita en sí. Me gustó...
Tan realista, divertida y gozosa como la nieve real: A Material Point Method For Snow Simulation, presentado en el SIGGraph, algunas de las técnicas que Disney ha usado en Frozen: el reino de hielo, la película de las navidades de este...
Anders Ramsell se ha currado esta versión resumida de Blade Runner dibujando 12.597 acuarelas de aproximadamente 1,5×3 centímetros y montándolas en este vídeo. Blade Runner - The Aquarelle Edition dura unos 35 minutos y es cierto que a ratos es complicadillo...

Esta es la historia de un grupo de gente que soñó con crear los nuevos episodios de Star Trek más fieles, hiperrealistas y dignos que fuera posible y de cómo lo consiguieron con mucha paciencia y la ayuda de Internet. Para...

Dos minutos y medio más para ayudarte a decidir si hay que ver o no el remake de Robocop que se estrena en 2014....
Por fin he tenido tiempo de ver Telescope, un corto de ciencia ficción ambientado en el año 2138 en el que el protagonista, un arqueólogo cósmico, viaja más rápido que la luz alejándose cada vez más de nuestro planeta, desprovisto ya...

Ya hay trailer oficial de Helix una prometedora nueva serie de ciencia-ficción, esta vez con el marchamo de Ron Moore, uno de los creadores de Galáctica: Estrella de combate. La historia gira alrededor de unos científicos del CDC (Centro para el...

La historia de la emisión por radio de La Guerra de los mundos en 1938 en el Mercury Teather es sencillamente apasionante: no solo se trata de una de las más grandes obras de la ciencia-ficción de todos los tiempos; también...
Ambientada en 2019, a Blade Runner se la categoriza principalmente como película de ciencia-ficción por aquello del futuro y los androides, pero paralelamente también es una excelente película de cine negro, el tradicional género de los detectives perdedores, los ambientes sórdidos...
Paradoja temporal es un corto/serie de Pedrojuán Gironés en el que se explora uno de los innumerables aspectos de los viajes en el tiempo, en este caso el compromiso requerido para inventar y construir el cacharro y, cómo no, las paradojas...
Un precioso vídeo de viernes que demuestra lo sencillo que puede ser crear un vídeo a modo de proyecto personal y que quede bonito. Y también lo importante que es el acompañamiento sonoro para darle un toque especial. Es un trabajo...
Sí, por supuesto, con la de problemas que le encontré a Gravity he disfrutado como un enano con la parodia en 8 bits de 8-Bit Cinema. Blade Runner narrado como videojuego retro estilo 8-bits, otro genial vídeo de esta gente.8 bits...
Hell no, que se traduce como «Demonios, no», o incluso «Ni de coña», es una parodia acerca de las películas de terror en la que por fin los personajes son inteligentes, toman buenas decisiones, usan la lógica, el pensamiento crítico, etc…...
Zombies vs. animals? The living dead wouldn't stand a chance, o cómo la naturaleza acabaría con un Apocalipsis zombi rápida y salvajemente. Para disfrutar del horror zombi hay que dejar de lado algunas reglas de la ciencia. De hecho, asumiendo que los...
Por Nacho Palou -
15 OCT 2013
Ah, hay que ver lo que nos fascina el apocalipsis zombi, a veces parece que estamos deseando que suceda de una vez. Tal vez porque ya puestos a un apocalipsis, el zombi pinta más intedezante que el descrito en el libro...
Por Nacho Palou -
9 OCT 2013
Este montaje extremadamente bien preparado con actores, un decorado a medida y todo tipo de trucos hace que el poder de la telequinesis se vuelva real para los incautos visitantes de una cafetería de Nueva York – al menos durante unos...
Gravity (Alfonso Cuarón, 2013). Con Sandra Bullock y George Clooney. Durante una misión del transbordador espacial un par de astronautas quedan a la deriva en el espacio exterior, en una situación de la que solo se puede esperar lo peor. Con...
Tuneando el Hubble Ojo, esta anotación contiene un montón de spoilers, así que no sigas leyendo si no has visto la película a menos que no te importe que te la destripen. Como habrás visto por el tráiler la especialista de la...
I.T. Crowd (en España: Los informáticos) terminó definitivamente hace una semana con la emisión de un último episodio «especial» de doble duración, un cariñoso cierre para una de las series británicas más divertidas y geeks de los últimos tiempos. En este...
Jeffrey Kluger de Time Magazine recopila fallos técnicos de la película Gravity en Gravity Fact Check: What the Season’s Big Movie Gets Wrong. Algunos son tan técnicos que es imposible que los detecte la mayoría del público. Otros como los sonidos...
Por Nacho Palou -
2 OCT 2013
Una película en la que el protagonista se llama Neo que es un anagrama de One (Uno) que es el número de expresiones faciales que puede interpretar Keanu Reeves en una saga de tres películas: una. La gente de Screen Junkies...
Una de las escenas más impactantes de Alien es el momento en el que el quebrantapechos atraviesa el pecho de Kane, dejando ya claro lo agradables que son los xenomorfos. En ALIENS Behind-the-Scenes Chestburster FX Test Stephen Norrington explica como fabricaron...
Con todo lo WTF que es la película «Objetivo la Casa Blanca» resulta que contiene la que es probablemente la escena del tipo personas delante de un ordenador más realista que se haya visto nunca en el cine. — La contraseña es¹...
Por Nacho Palou -
30 SEP 2013
Red Tails. Al fin –con un «poquito» de retraso– he visto la película sobre los aviadores de Tuskegee, los primeros pilotos africano-americanos (negros, para entendernos sin eufemismos) de la historia de las fuerzas armadas de los Estados Unidos. Pero he de...
Esto es solo la esquina superior izquierda, clic para ir a la imagen completa La ilustración Starship Size Comparison Chart de Dirk Loechel no recoge todas las naves imaginadas por el género de la ciencia ficción como se dice por ahí sino...
Revolucionar la física concebiendo la mecánica cuántica pero que años después tu imagen aparezca #2 en Google enterrada junto a decenas más de un personaje de ficción asociado con la metanfetamina. ¡Qué jodienda! Al menos se trata de Breaking Bad y...
El Dungeon Master más cabestro de este mundo es el protagonista de Zero Charisma, una película independiente altamente friki con el humor inherente a los juegos de rol como temática. Buscaban financiación colectiva y la consiguieron finalmente. El bajo, bajísimo carisma...
Los dos años de cárcel que sugería la Memoria de la Fiscalía General del Estado de 2012 [PDF 12,6 MB] para […] quien con ánimo de lucro y en perjuicio de tercero, reproduzca, plagie, facilite el acceso, distribuya o comunique públicamente, en...
Plot Point Productions realizó este bello montaje titulado The Last Thing You See: A Final Shot Montage. Los amantes del cine sabrán apreciarlo y reconocerán muchas escenas: son los últimos segundos de los finales de decenas y decenas de películas de...
Ya lo decía hace unos días Sergio Carrasco a raíz de las dos resoluciones que en el mismo día condenaban y absolvían al titular de una web de enlaces: La Sección Segunda se saltará la Ley en sus resoluciones hasta que se...
España, 2 de septiembre de 2013. El abogado David Bravo recibe dos notificaciones: La Sección Segunda de la Comisión de Propiedad Intelectual, más conocida como Comisión Sinde-Wert, formada por funcionarios a los que no se les exige ser jueces, decide que el...
Gravity: A Falling Montage es un precioso montaje de Plot Point con 61 caídas libres al vacío procedentes de películas de todo tipo de géneros de cine: desde las de ciencia ficción (principalmente) a las de misterio, acción y superhéroes. Entre...
Closer de Angelo Licata —con subtítulos en español en las opciones de vídeo de YouTube— es un corto de ciencia ficción mejor que muchas de las películas de ese género que han pasado últimamente por las salas de cine. Según su...
Por Nacho Palou -
12 SEP 2013
¡En el nombre de Dios! ¡Sabed que no abandonaremos nuestra lucha hasta que todos y cada uno de vosotros yazca muerto!– Rey Arturo ¡No es gracioso! Pero a la vez demuestra cómo con el mismo material de una de las películas...
Ya comentamos el trailer hace tiempo, hoy se ha estrenado Traveling Salesman, una producción indie con aspecto de peli de espías a lo Sneakers sobre qué sucedería si qué sucedería si P = NP....
Hace unos meses se supo que The IT Crowd volvería este año para despedirse como merece y, según anunciaba Graham Linehan en Twitter ese momento estaría tan cerca como finales de este mismo mes de septiembre, con un capítulo doble de...
Por Nacho Palou -
6 SEP 2013
Sí, me sigue apeteciendo ver Gravity, pero este trailer me ha resultado un poco molesto, porque empieza diciendo que a 372 millas de la Tierra no hay nada para transportar el sonido... Pero bien que se oyen los piñazos de las...
En Visua.ly, varias tablas de los elementos de Breaking Bad como inspiración, incluyendo esta infografía en la que se listan todas las «reglas» que propone su protagonista a sus socios. Pero, recuerda, sobre todo: A la química hay que respetarla....

Álex Roca de Tentacle nos hizo llegar este cortometraje que rodaron el año pasado titulado Balisa. Tiene el mérito de ser una producción humilde, completada en tan solo 40 días y con un presupuesto de 50 euros; aunque el propio director...
Elysium. Los futuros distópicos son uno de los aspectos que más me apasionan de las películas de ciencia ficción. Así que cuando a finales del siglo XXII resulta que la mayor parte de la gente vive pasando calamidades en las peores...

Madrid, 2057. La tecnología proporciona al ser humano una vida llena de comodidades y… ¿Sin errores? Jorge Arellano, un tipo corriente, se verá acorralado en su propia casa por los mismos dispositivos que garantizan su seguridad. ¿Cómo reaccionará un hombre acostumbrado...
Lo primero es lo primero: no son zombies, son infectados. Guerra Mundial Z (Marc Forster, 2013). Esta otra superproducción de la temporada dicen que es la que más dinero está generando para Brad Pitt en toda su carrera (ah, la ironía)...
Masters of the Air: America's Bomber Boys Who Fought the Air War Against Nazi Germany Donald L. Miller. Edición Kindle en Inglés. Creada como unidad independiente el 22 de enero de 1944, la Octava Fuerza Aérea de los Estados Unidos fue...

Pacific Rim (Guillermo del Toro, 2013). Esta película es entretenimiento puro; poco más se puede decir. No deja ni un minuto de tranquilidad antes de situar al espectador en un futuro de trepidante acción no muy lejano en el que hay...
Tan insulsa y bobalicona como prometedora era, Room 237 es una «especie de documental» sobre El resplandor, una de las grandes películas de Stanley Kubrick basada en un libro de Stephen King. Digo bobalicona por no decir una soberana soplapollez dado...
La gente suele pensar en rms como en el filósofo del que surgió la idea y en mi como el ingeniero que fue capaz de ponerla en práctica.– Linus Torvalds No habíamos mencionado por aquí hasta ahora un «documento histórico» titulado...
Esta versión de Blade Runner como si fuera un juego de la época de las máquinas de 8 bits tiene un encanto especial porque hace coincidir prácticamente la época del estreno de la película con el aspecto que tenían los entretenimientos...
Un fotograma de Marwencol En Filmin proponen esta lista de Los 20 documentales más esenciales del S.XXI (hasta ahora, obviamente), muy útil de cara a las tardes de asueto veraniegas: Spellbound (2002) [en Filmin], sobre los enormemente populares concursos de deletreo en...
Dentro de su humildad, I’s tiene una pinta estupenda: es una película sobre la Singularidad Tecnológica. En el trailer pueden verse algunos detalles buenísimos; la campaña de financiación en KickStarter ya ha alcanzado el objetivo, así que para después del verano...
Hala, ahí queda eso hasta que el próximo 3 de septiembre se estrene la tercera temporada de Homeland....
Como seguramente no habrás podido estar allí, reserva un par de horas y prepara las palomitas porque este es el documental completo de los cuatro días de conferencia DEFCON, de la mano del archivista Jason Scott (el de Textfiles.com). Baste decir...
La primera versión de Star Wars que escribió George Lucas se llamaba The Star Wars y ni la historia ni los personajes que hoy conocemos eran exactamente iguales, incluido un tal general Skywalker. Dark Horse va a publicar a partir del...

En Regreso al futuro los actores que interpretan a los padres de Marty McFly y a Biff Tannen aparecen en escenas separadas por 30 años en la línea temporal de la película. En el mosaico de arriba se ve a Lea...
Ya falta menos para poder ver la adaptación de El juego de Ender al cine, aunque si no has leído la novela igual es mejor que te saltes este trailer, ya que hay algún detalle un tanto spoileador. Hay más material...

Si La verdadera sabiduría se halla en las camisetas con textos.- anónimo y Los acertijos de la vida tienen su respuesta en las películas.– Grand Canyon (1991) Entonces este vídeo debe ser algo así como la respuesta al sentido de la...
El Escuadrón de Rescate 38 de la Fuerza Aérea de los Estados Unidos tiene como misión evacuar soldados y civiles heridos aún bajo el fuego enemigo, con el objetivo de llevarlos a un hospital dentro de la hora siguiente a haber...
Apenas unas voces en inglés y en árabe y la fecha del estreno de la tercera temporada son lo único que se puede ver en este teaser de la tercera temporada de Homeland. De hecho es tan teaser que aunque no...
Ya tenemos el segundo trailer de Gravity, la película sobre algún tipo de desastre espacial muy desastroso. Titulado Detached, «acongoja» casi más que el primero. Eso sí, a ver qué se han inventado Alfonso y Jonás Cuarón para meter en la...
En Time, en vídeo, Five Ways You Know You're Watching a Spielberg Movie, Problemas con papá.Rayos de luz.Caras atónitas.Gente mirando a través de un cristal.Música de John Williams. Bonus: Decenas de películas de Spielberg condensadas en 5 minutos. Extra de queso:...
Por Nacho Palou -
23 JUL 2013
Warning: SPOILERS MORTÍFEROS. ¡Y nunca mejor dicho!...
Un pequeño pero interesante homenaje Stanley Kubrick, el genio del cine que estos días cumpliría 85 años. Es un trabajo de Shaun Pitz. (Vía Kuriositas.)...
Clay Folden puso su cuadracóptero Phantom a volar por las alturas de Hollywood – un prometedor panorama. Como cámara añadió esa pequeña maravilla que es la GoPro Hero3. Necesitó muchas baterías, mucha paciencia y algunos repuestos hasta completar la grabación. El...
Si yo tuviera un centro de investigación sería solo para llamarlo algo así como Laboratorio Cinemático para los Estudios de Sonidos y Vibraciones Visibles en el Agua Sónica. Alternativamente, Centro de Investigaciones Foto Atómicas también me vale....
Desde el departamento de «es que no tenía otra cosa que hacer» llega este detallista montaje de Clara Darko y Brutzelpretzel, que han empalmado las mejores escenas de películas dentro de películas. En total son 139 cortes de 93 películas diferentes...
En Vice España, Julian Assange no es Wikileaks es una entrevista a Alex Gibney, autor del documental We Steal Secrets: The Story of WikiLeaks sobre la organización Wikileaks —que califica a Assange de "radical de la transparencia"— y también sobre la...
Por Nacho Palou -
16 JUL 2013
Hyoshiart consiguó juntar unos cuantos Deloreans y grabarlos en pausada formación, recreándose en el proceso como si de poesía se tratase. Auténtico pr0n para autotrastornados (o tempotrastornados, según se mire). Bonus: (Mmm… ¿cuál es realmente el pluran de DeLorean?)...
Los equipos de David Lightman y el WOPR El otro día hablábamos de la tecnología de Juegos de guerra, una de nuestras películas preferidas de todos los tiempos. En ella David Lightman estaba a punto de desatar una guerra termonuclear global por...
Ver el gráfico completo. 50 Years of visionary Sci Fi Computer Interface Design es un gráfico kilométrico que resume 50 años de tecnología imaginada en la ciencia ficción —desde Perdidos en el Espacio (1965) hasta Oblivion (2013)— y qué tecnologías actuales anticiparon...
Por Nacho Palou -
5 JUL 2013
La última entrega de la saga trekkie en su versión «universo reiniciado» es Star Trek: en la oscuridad, que se estrena mañana en España. Es una nueva superproducción dirigida por J.J. Abrams que además de Chris Pine y Zachary Quinto cuenta...
Jeremías nos escribió para contarnos que ha creado una especie de artilugio para grabar en «tiempo bala» con un ventilador de techo y una pequeña cámara GoPro. Lo cuenta al completo en su blog: How to create a DIY Matrix bullet...
Literalmente, según este póster de la segunda parte de El Hobbit, de la que ya habíamos visto el trailer, Evangeline Lilly como la elfa Tauriel… No tiene problema en matar.Porque ella mismaes una máquina de matar. Queda claro que la vida...
Este genial trabajo de John Hess condensa bien todo lo que hace falta saber sobre la relación de aspecto (ratio) en el cine y la televisión, que básicamente es la proporción entre el ancho y alto de la imagen. Indispensable para...
Estuve el otro día repasando Juegos de guerra, una de nuestras películas geek favoritas y la verdad es que aguanta el paso del tiempo dignamente. Hay algunas cosas un tanto irrisorias hoy en día, como el acoplador acústico, las cabinas telefónicas...
Todos hemos pensado esto acerca de muchas –demasiadas– películas, pero Pedro Jorge Romero lo clava en Bandazos por el tiempo: Looper, de Rian Johnson: Es un hecho universalmente aceptado que los villanos de película siempre hacen las cosas de la forma más...
Probablemente, la sensación más parecida a moverse a velocidad hiperespacial: Hyper Drive. Con música de BS, Solar Storm. Grabado con una DMC-GH3 de Panasonic. Para ver en alta definición y a generoso volumen....
A raíz de que habláramos por aquí sobre el futuro de las salas de cine –que quizá sean pronto más selectas, carísimas y con un toque de «experiencia única»– nos escribieron para enseñarnos un vídeo sobre las salas iPic: En Estados...
A Game of Clones, una colección de fondos de pantalla (eso sí, en talla XS de 1920 x 1080 píxeles) resultado de mezclar La Guerra de la Galaxias con Juego de Tronos. Vía Geeks are Sexy. Blasones, lemas y casas de...
Por Nacho Palou -
18 JUN 2013
Leo hoy que el grupo Ábaco Cinebox cierra. Al parecer en el punto álgido de su negocio llegó a tener 42 multisalas en todo el país, pero desde 2007 «acarreaba un concurso de acreedores» y ya había cerrado 14 cines y...
No tenía ni idea de que hubiera una segunda parte de 300, pero mira, ya tengo algo que hacer en marzo del año que viene. Al parecer 300: Rise of an Empire es lo que en comic se llamó simplemente Xerxes,...
Prepara las palomitas porque este hallazgo es bueno: ni más ni menos que 45 minutos diferentes de Blade Runner, probablemente una de las mejores películas de todos los tiempos – al menos según el criterio de los geeks amantes de la...
Quedan muchos días hasta el 13 de diciembre, pero a falta de otra cosa habrá que ir salivando con el primer trailer de El Hobbit: La desolación de Smaug, quinta película de la saga y segunda de la precuela de El...
Los miembros del Gremio de Escritores de América han escogido las 101 series de televisión mejor escritas y las han publicado en 101 Best Written TV Series List. Estas son las diez primeras: Los Soprano. Seinfeld. The Twilight Zone, AKA En los...
Blade Runner, Star Wars, The Matrix y muchas otras otras grandes películas de ciencia ficción avejentadas como novelas pulp por Timothy Anderson. Se pueden conseguir también como pósteres en su tienda. (Vía Taxi.)...
Seis astronautas parten rumbo a Europa en una misión para intentar encontrar signos de vida en esta luna de Júpiter, aunque por lo que se ve en el trailer se lía parda y lo mismo no todos vienen de vuelta. Según...
Infinitamente impactante vídeo este de los mejores momentos de Cazadores de Mitos recopilados por un fan: explosiones por doquier, cámaras lentas para regocijarse con objetos volando y destrucciones totales y grandes dosis de adrenalina con solo ver cómo terminan algunas pruebas....
Lo nuevo de J.J. Abrams parece algo así como una serie en plan Starsky y Hutch o Miami Vice (o cualquier «pareja de policías», vamos) pero con androides casi humanos y ambientada en 2048. Como ya va siendo habitual, solo se...
En Vulture, vía EW.com, vía News Y Combinator, The IT Crowd Is Coming Back! — La adorable comedia británica sobre nerds The IT Crowd tendrá, por fin, un episodio final especial. Su creador Graham Lineham anunció en una conferencia en Alemania que...
Por Nacho Palou -
13 MAY 2013
Yo he visto cosas que vosotros no creeríais. Atacar naves en llamas más allá de Orión. He visto Rayos-C brillar en la oscuridad cerca de la Puerta de Tannhäuser. Todos esos momentos se perderán en el tiempo como lágrimas en la...
Estas cinco películas son, al menos según cuentan los redactores y lectores de Techland en The Top 5 Underrated Sci-Fi Movie Masterpieces, las cinco mejores películas de ciencia ficción que generalmente pasan desapercibidas sin merecerlo: Naves misteriosas. Gattaca. Serenity, heredera de...
Estamos acostumbrados a que Wicho nos deleite con todo tipo de detalles y vídeos sobre la Estación Espacial Internacional, pero en octubre llegará a las pantallas Gravity de Alfonso Cuarón, con toque diferente. La fórmula es sencilla: George Clooney + Sandra...
¿Qué sucedería si se resolviera el problema más difícil del mundo? Vale que el tema no tiene para el común de los mortales la espectacularidad de Iron Man 3, el carisma de Star Trek o la acción de Los vengadores, y...
Tras el teaser del trailer, ya tenemos el trailer propiamente dicho de El juego de Ender. Otra de esas películas que apetece ver pero que a la vez da miedito por la calidad de la novela que intenta llevar al cine....
Para relajarse un rato, he aquí Precious Lines, un vídeo de Alexandre Chappel sobre la belleza de la creación de objetos recreándose especialmente en la precisión en la fabricación....
FlavorWire hablando acerca del Streamageddon, en el que han desparecido 1.800 películas y series de su vasto catálogo porque han caducado los acuerdos o derechos de comercialización que tenían: Aún a riesgo de que suene infantil: se supone que esto es...
Esto es ya rizar un poco el rizo, porque ya no es el teaser de una película, sino el teaser del trailer de la película de El juego de Ender, en la que Asa Butterfield interpreta a Andrew «Ender» Wiggin y...
El Valle de la Muerte es uno de los lugares más impresionantes de nuestro planeta, y este vídeo le hace justicia con unas espectaculares tomas nocturnas en las que se ven trazos de estrellas, las gemínidas, y algún que otro planeta....

La han titulado A boy and his atom y aunque artísticamente no sea gran cosa es literalmente la película más pequeña del mundo – récord Guiness oficial incluido. Cada fotograma de la animación se creó y fotografió en los laboratorios de...

Básicamente parece Mazinger Z + Godzilla + Transformers y solo de pensar en el trabajo visual, artístico y los efectos especiales ya agota. Aunque luego sea una castaña y no cunmpla con las expectativas –como tanto ocurre últimamente– seguramente merezca la...
Además del primer y apuñalante ejemplo informático, tan real como la vida misma, el resto no le va a la zaga. Mención especial para ese zoom estilo CSI: – Amplíe con el zoom… ¡Oh! ¿Qué es eso?– Es un pixel negro,...
Con un minucioso trabajo de selección la diseñadora Roxy Radulescu extrae de algunas de las películas más emblemáticas de la historia los fotogramas más representativos en cuanto al color y crea con Photoshop sus paletas de color. Decenas de ellas pueden...
El otro día me recordaron que no habíamos comentado nada de la segunda temporada de Black Mirror, la miniserie británica de la que disfrutamos el año pasado como enanos. Si la primera temporada estaba dedica a las historias sobre un futuro...
El más reciente y prometedor trailer de la próxima película de Superman, Man of Steel, un reinicio de la saga. Sale «el Gladiator», está dirigida por el de 300 (Zack Snyder) y a Superman le ponen traje nuevo. Detalle: los estadounidenses...
¡Cuidado que hay spoilers! Si te gustan los viajes en el tiempo y todas sus variantes en el blog de Mr. Dalliard han publicado este diagrama de flujo sobre los viajes en el tiempo [zoom] que te va dirigiendo a todas...
No tenía ni idea de que existía esto… … pero obviamente que al lector RSS va directo; al parecer han publicado ya seis números – voy a bajar algunos a ver qué tal por dentro. Geek está disponible tanto en papel como...
Oblivion (aquí el trailer) tiene algunos puntos interesantes: en vez de un futuro perfecto muestra un planeta Tierra en el que han sucedido cosas increíblemente chungas; la raza humana está muy al límite. Pero ante tanta destrucción destacan los límpidos diseños...
Prácticamente el mismo encuadre perfectamente simétrico con el efecto de los personajes centrados y de espaldas a la cámara ante un fondo por alguna razón épico en 95 peliculas diferentes: se titula The View: A ‘Back-to-the-Camera Shot’ Supercut y es un...

Todas las películas con escenas de hackers reunidas en un videoclip con la apropiada música electrónica de Eclectic Method....
¡Ah! Ese tono verdoso en las imágenes, esas copias casi imposibles de seguir con la mirada, esa parsimonia… ¡Qué recuerdos! En fin, Smith siempre será Smith, con permiso de todo el malware del mundo. (Hay que verlo hasta el detalle final,...
En Wired, Lawyers and Psychiatrists Answer the Tough Questions in The Walking Dead [peligro de spoilers]. Médica y legalmente es relevante el hecho de que el cerebro de un caminante aún funcione, aunque sólo sea el tronco del encéfalo y algunas otras...
Por Nacho Palou -
12 ABR 2013
Hace unos días me llamaron del programa Bos Días la Televisión de Galicia para pedirme mi opinión sobre la Ley Lassalle, y aunque intenté que hablaran del tema con un abogado, que seguro que sabría más que yo del tema, insistieron...
Verdaderas obra de arte en sí mismas a veces, los títulos de crédito tienen una larga historia, comenzando por un tal Thomas Alva Edison que andaba usando los primeros fotogramas de las películas para plantificar allí sus notas de copyright ya...
Del director que nos sorprendió tan gratamente con esa joyita que es Distrito 9 anuncian ya Elysium, una peli de esas con una pinta estupenda: futuro utópico + futuro distópico, todo en uno, con un montón de ambientes, decorados y efectos...
Catfish (Henry Joost y Ariel Schulman, 2010) es un documental –o más bien «una especie de…», que dirían los puristas– acerca de un tipo normal y corriente que conoce a alguien a través de Facebook. Sin querer revelar nada digamos que...
La anotación sobre qué fue de los Goonies incluía un enlace a una lista de diez películas para educar a tus hijos como pequeños geeks, aunque a @jmruizgarrido no debieron parecerle suficientes, algo que tampoco le vamos a discutir, porque dijo tal...
Los Goonies inspeccionando el plano del tesoro Para los que ya peinamos canas los Goonies es una de esas películas imprescindibles que, además, los que tenemos hijos hemos usado para iniciarlos en la cosa esta del geekerío. Por eso me hizo gracia...
The Walking Dead es en realidad Toy Story, Un tipo llamado JimmyLegs decidió recopilar todas las similitudes entre ambas series y el resultado es una galería visual que lo demuestra más allá de toda sombra de duda. Ojo, ver Zombie Story...
Por Nacho Palou -
3 ABR 2013
Me encantó la idea de los meta-niveles en Breaking the 4th Wall Movie Supercut. Es un genial montaje de Leigh Singer en alta calidad, con escenas de más de 50 películas bien conocidas en las que los personajes hacen algo que...
En un futuro planeta Tierra que ha evolucionado hasta ser irreconocible un hombre se enfrenta al pasado y toma el camino de la redención mientras lucha para salvar a la raza humana.Jack Harper, interpretado por Tom Cruise, es uno de los...
Cuando el gobierno de España se inventó la Ley Sinde, a instancia de la industria de contenidos y duramente presionado por el gobierno de los Estados Unidos, los que saben de todo esto dijeron que no serviría de nada y que lo...
Este cortometraje para el PBS 2013 Online Film Festival demuestra que no hacen muchos medios para crear una buena historia a partir de los recuerdos icónicos que todos tenemos de los clásicos de la cinematografía. A disfrutarlo: Hoverboard. Hay otros finalistas...
A Story About Robots de Paramotion Films en Vimeo....
Por Nacho Palou -
15 MAR 2013
Amazon ha anunciado hoy >la disponibilidad en España de la tableta Kindle Fire HD con pantalla de 8,9 pulgadas. Este modelo viene para acompañar al ya comercializado Kindle Fire HD de 7 pulgadas, «su producto más vendido en todo el mundo»,...
Por Nacho Palou -
13 MAR 2013
La vida en la Tierra es captada a través de la tecnología de un satélite. Este detecta cualquier incidencia que se produce en el Planeta, inundaciones, incendios, movimientos de las corrientes oceánicas y cuánta nieve ha caído o caerá durante la...
A finales de 2011 Will Stauffer-Norris y Zak Podmore comenzaron un recorrido en canoa y a pie de algo más de 2.700 kilómetros de el nacimiento del río Verde en la cordillera Wind River, en Wyoming, que es el principal afluente...
Esta silla que se puede usar solo ocho veces antes de que un mecanismo interno destruya sus juntas es un trabajo de Thibault Brevet y unos colegas para el hackathon The Deconstruction. Puede parecer una exageración, pero no hay que olvidar...
Durante el pasado MWC LG exhibía un televisor Ultra HD (4k, 3840 x 2160 píxeles) que recibía la señal de vídeo por wifi, desde un teléfono móvil Optimus G Pro en tiempo real. El resultado era bastante bueno más allá de...
Por Nacho Palou -
4 MAR 2013

La Casa de la Cascada de Lego revela la genialidad de Wright y el arte de la producción en masa. Sobran piezas, faltan excusas para no montarla.
Alberto Castaño y Luis Caldevilla recibieron el encargo por parte del Patronato de la Junta Constructora del Templo Expiatorio de la Sagrada Familia de Barcelona para captar mediante un timelapse su visión de la basílica. El resultado es espectacular, ofreciendo además...
El equipo que estaba restaurando el Delorean de Regreso al Futuro ha completado su trabajo. Aunque se usaron varios coches durante el rodaje de la trilogía, este es el Delorean DMC-12 denominado Hero «A», usado originalmente en las principales escenas de...

Tiene pinta de que The Numbers Station va a ser la típica peli de espías de esas en las que el único agente que se entera de que hay un infiltrado tiene que enfrentarse con sus antiguos colegas para «desfacer» el...

Tras años de vicisitudes en una apasionante aventura personal y profesional, el próximo 14 de mayo se estrena El Cosmonauta, de la que hemos contando un montón de detalles dado por aquí hemos visto nacer el proyecto, lograr la financiación colectiva,...

Este documental cuenta la historia en el MundoReal™ de los fundadores del polémico The Pirate Bay. Está protagonizado por ellos mismos en persona y dirigido por Simon Klose. Entre 2009 y 2010 y tras los oportunos recursos sus responsables fueron sentenciados...
Un tipo experimenta con una caja de cartón que sirve para teletransportarse a lugares aleatorios – con los consiguientes resultados un tanto caóticos. Es un corto de Spike Morris y Oscar Hudson, con Shun Sugimoto como protagonista. Como método para viajar...

Muy bien condensada esta versión del clásico de los 80 realizado por la gente de 14AStudio. Me recordó a las películas reinterpretadas por conejos en 30 segundos de Angry Alien, pero con algo más de más calma....
Uno de los tripulantes del transbordador espacial Columbia en su última misión era Ilan Ramon, el hasta ahora único astronauta israelí de la historia. Entre los varios ítems personales que llevó a bordo en el viaje había uno muy especial, una...
Full Moon Silhouettes es un vídeo de Mark Gee en el que se ve la Luna llena saliendo sobre el mirador del Monte Victoria en Wellington, Nueva Zelanda. Por eso, si vives en el hemisferio norte, te dará la impresión de...
De achterkant van het Internet, que se traduce por algo así como «la parte de atrás de Internet», es una curiosa pieza con música de Nathan Shirley adaptada al ritmo de los LEDs parpadeantes de uno de los centros de datos...
¡Ay, cómo echamos de menos a Roy y Moss! Mientras vuelven o no, qué mejor homenaje que imprimir este emblema y usarlo para decorar el escritorio: el lema oficial, disquetes, unas gafapastas, un d20, el 0118 999, la mismísima Internet, un...
Esta de Mondotees, sobre las tres partes de la trilogía Esta otra de Gianmarco Magnani con el Delorean en todo su esplendor. Y esta otra que condensa la tercera entrega en una especie de infografía. Por supuesto sin olvidar los clásicos...
La gravedad es un error.Nos pasamos la vida tratando de escapar de ella.- Dr. Nick Laslowicz De este mockumentary no se puede decir gran cosa para no estropearlo - así que búscate seis minutos libres y verás cómo merece la pena...
Según el propio Kim Dotcom: Top 5 #Mega traffic countries (week 1): Spain, Brazil, France, Netherlands & New Zealand.— Kim Dotcom (@KimDotcom) 26 de enero de 2013 Justo en la misma semana en la que el presidente de la Motion Picture Ass....
Ashton Kutcher como Steve Jobs intentando convencer a Josh Gad como Steve Wozniak de que la gente querrá comprar un ordenador cuando sepa que lo quiere. Este es el primer clip oficial de jOBS, la película sobre la vida de Steve...
El año pasado dijimos que había que ver Black Mirror sí o sí, así que esperamos con ansia el estreno de su segunda temporada. Pero si ves que te domina el ansia viva mientas llega su estreno en Vaya tele hay...
Tal y como prometio, Kim Dotcom vuelve a la carga con Mega, el servicio que está llamado a suceder a Megaupload. Más de un millón de usuarios registrados en poco más de dos días y un dimensionamiento un tanto escaso ante...
La Corporación de Radiodifusión Noruega, algo así como el equivalente noruego a RTVE, filmó en cuatro ocasiones durante el pasado año el recorrido de la línea que une Trondheim y Bodø, la línea que llega más al norte del país. El...
Tú no conoces el poder del Lado Oscuro. La colección completa, que es obra del diseñador freelance Pete Ware, se puede ver Drive-in Prints. Y adquirir en forma de póster. Vía Laughing Squid....
Por Nacho Palou -
17 ENE 2013

Cristóbal Vila nos vuelve a dejar boquiabiertos con Lux Aeterna, un bello cortometraje de creaciones 3-D tan reales tan reales que apenas son distinguibles de escenarios auténticos. Pero aunque algunas de ellas parezcan salidas de los telescopios de la NASA (¡a...
Como cualquier otra lista de un campo lo suficientemente amplio seguro que es discutible, pero The ABC of Architects no deja de ser un bonito recorrido por los apellidos de 26 famosos arquitectos y sus obras más representativas. (vía MetaFilter). Un...
Los de Think Geek han empezado a vender con su peculiar estilo, para los más fans de 2001, esta réplica casi perfecta de HAL 9000, que ya comentamos por aquí hace tiempo. No es que sea precisamente barato (500 dólares) pero...
How to stop piracy: 1 Create great stuff 2 Make it easy to buy 3 Same day worldwide release 4 Fair price 5 Works on any device— Kim Dotcom (@KimDotcom) enero 7, 2013 No siempre estoy de acuerdo con las cosas que...
Further Up Yonder – a message from ISS to all Humankind es un vídeo creado por Giacomo Sardelli con fotos tomadas desde la Estación Espacial Internacional, una música chula, y algunos mensajes de algunos de los astronautas que han pasado por...
Tras Maravillas del sistema solar y Maravillas del universo Brian Cox y la BBC vuelven a la carga con Wonders of Life, que se estrena en unos días y que tiene toda la pinta de ir a ser tan impresionante como...
Durante unos años Qué bello es vivir, la película de Frank Capra protagonizada por James Stewart, fue todo un clásico de la programación televisiva navideña porque por un error de la empresa que era titular de los derechos de autor esta quedó...
Utópicos, distópicos, extrañamente parecidos a nuestro presente, llenos de máquinas que a estas alturas nos parecen anticuadas y/o ingenuas o de máquinas que aún no tenemos ni idea de como hacer… Así es el futuro visto en las películas en The...
Creía que me quedaba poco por ver acerca de Blade Runner, pero en este apunte sobre los storyboards de la película encontré la referencia a RidleyVille.com. Entre otras cosas contiene fotografías antiguas, los vídeos de las pantallas que se ven en...
Un relajante vídeo de EdisProduction con preciosas escenas de este planeta en el que vivimos para prepararnos para el simulacro de paz mundial de los próximos días. (Vía Fogonazos). Date un paseo, para no olvidar que el viaje es tan importante...
Cierra los ojos. Reproduce el vídeo y escucha a… Lester Burnham de American Beauty, Carl Sagan en Cosmos, David Attenborough, la voz que acompaña a Pocoyó, la narración de Planeta Tierra, de A Vista de Pajaro, Starbuck en Battlestar Galactica (la...

Hermanos de Sangre (HBO 2001 - DVD | Blu-ray) cuenta la historia de la Compañía Easy del segundo batallón del 506º Regimiento de Infantería Paracaidista de la 101ª División Aerotransportada desde su formación en 1942 hasta el final de la segunda...
Con un reparto ciertamente de lujo y una estética similar a la de Superman Returns (2006), en el nuevo y espectacular trailer en español de El hombre de acero aparecen Russell Crowe, Kevin Costner y Laurence Fishburne bajo la dirección de...
Tras un aterrizaje de emergencia, un padre y un hijo exploran un planeta que fue evacuado por los humanos un milenio antes. Parece que la temporada que viene va a estar cargadita de pelis potentes de ciencia ficción; en esta ocasión...
Poner a un hombre [el joven africano Bolaji Badejo, de dos metros de altura] en el papel [del xenoformo] de Alien «transformó» la criatura, según [Ridley] Scott «en un hombre con aspecto femenino -- un hermafrodita» que resultó muy adecuado ya...
Por Nacho Palou -
10 DIC 2012

Un consejo de guerra envía a un soldado veterano a un distante planeta, donde habrá de destruir lo que queda de una raza alienígena. Pero la llegada de un «viajero inesperado» le hará cuestionarse todo lo que sabe sobre el planeta,...
Para recordar que no hay nada mejor que caminar cuando estás descubriendo un sitio nuevo si realmente quieres descubrirlo y no limitarte a haber estado allí. (Vía Gadling). Curiosity, nuestro más reciente enviado a Marte.Barcelona en primavera, para llevar mejor el...

No está mal empezar un fin de semana largo con un teaser de la próxima de Star Trek dirigida por J.J. Abrams (¡ejem!) y titulada Star Trek Into Darkness. El póster mola tanto o más: Al parecer la historia narra la...
[…] Le enseñamos todo lo que sabemos, hicimos todo lo que pudimos por él. Pero ahora tiene que encontrar su propio camino.Lo vemos en las fotos que toma de si mismo, pero nunca lo tocaremos de nuevo ni tampoco podremos arreglarlo...
Productos relacionados con Apocalipsis Z en Amazon España Cogiendo la información acerca de qué productos suele comprar la gente junto con otros en Amazon Yasiv proporciona una forma gráfica de navegar por esta red de productos. Para ello, basta con teclear el...
The Big Bang Theory, imagen de CBS.com. Y este sería uno de los motivos, entre otros, recogidos por el NYDailyNews.com (vía Dave) que explicarían el éxito «contra todo pronóstico» de la serie The Big Bang Theory, que en su sexta temporada anda...
Por Nacho Palou -
27 NOV 2012
the future as foretold in the past - clic para ver la imagen completa [jpeg 1,4 MB] De 2012 hasta el año 802701, A Visual Timeline of the Future Based on Famous Fiction es un diseño de Giorgia Lupi que analiza 62...
Science Fiction: A Supercut (Glitch Mob remix "Monday") es un montaje de seis minutos y medio con pequeños cortes de más de cien películas de ciencia ficción. Algunas están metidas un poco con calzador, al menos según lo que yo entiendo...
Esto es precisamente lo que se plantea Nacho Vigalondo en el corto Cambiar el mundo cuando su protagonista se despierta una mañana y comprueba que puede hablar con sus copias en otros universos paralelos. ¿Podrían ponerse todos de acuerdo para hacer...
Todo un trabajo de artesanía el que están llevando a cabo el equipo de Time Machine Restoration. Cada una de las piezas está pasando una revisión e incluso han encontrado el condensador de fluzo original de la máquina del Doctor Brown....
Barcelona Spring 2012 Timelapses por Nicolas Gutierrez Wenhammar en Vimeo. Mientras el invierno se nos viene encima inexorablemente, un bonito vídeo que recoge lo que podría ser un día de primavera en Barcelona, cuando el Sol vuelve poco a poco a dominar...
En Major Nelson, "Halo 4" está camino de alcanzar los 300 millones de dólares en ventas globales en su primera semana, lo que convierte a esta entrega en la más existosa de la saga, y también en el mayor lanzamiento de...
Por Nacho Palou -
14 NOV 2012
Si todavía te estás preguntando cómo es posible que el guión de Prometheus tuviera más huecos que un queso emmental (no, el gruyere no tiene ojos) igual te apetece echarle un ojo al guión original de la película antes de que...
Con muchas más prisas que otros temas más urgentes el gobierno parece dispuesto a sacar adelante una reforma de la Ley de Propiedad Intelectual modificándola por Real Decreto-Ley. Piratas de Cataluña ha obtenido una copia del borrador que maneja el gobierno, y...

Cuando ya parecía que la que es probablemente una de las mejores series de ciencia ficción de todos los tiempos nos había dejado para siempre, llega el primer trailer de Battlestar Galactica: Blood & Chrome, una precuela de la que empiezan...
the Peak por Christian Mülhauser en Vimeo. Un relajante time-lapse del Zermatt acompañado de la pieza Oceano de Roberto Cacciapaglia para empezar el viernes y sobrellevar con dignidad las horas que quedan antes de que llegue el fin de semana. (@FitzRoyAs vía...
Clic para ver al completo Ahora que Leia es una princesa Disney –¿dónde está Obi-Wan cuando realmente se le necsita?– no está de más echarle un ojo a Film Franchises Infographic: Who Owns What? para saber qué y quién pertenece a que...
Internet nos trajo maravillas como la IMDB, un vasto archivo de cine que comenzó con el duro trabajo manual de un montón de voluntarios de USENET y con el tiempo creció y creció hasta ser un recurso tan importante para los...
Mercator - close to the heavens es un time lapse de Péter Pápics, un doctorando en astronomía, que recoge imágenes tomadas en el Observatorio del Roque de los Muchachos del Instituto de Astrofísica de Canarias. La música es la sonata para...
Grand Canyon : Blink of Time por GOTM Films en Vimeo. Lee Kirchner y Kevin Rossi se pasaron siete semanas en el Gran Cañón del Colorado tomando más de 80.000 fotografías para luego poder montar este time-lapse de uno de los...
Disecciones de Brad McGinty de personajes como gremlins, xenoformos de Alien, depredadores o marcianos de Mars Attack! en dos sabores, camiseta o póster. Vía Dvice....
Por Nacho Palou -
23 OCT 2012
Looper (Rian Johnson, 2012). El viaje en el tiempo todavía no se ha inventado, pero se inventará – y será declarado ilegal. En ese lejano futuro las mafias que tengan que deshacerse de ciertas personas las enviarán a una época anterior...
Panel de mandos El frikismo debe ser poderoso en Chris Lee, que ha decidido embarcarse en el proyecto de construir un Halcón Milenario a tamaño real en una finca que posee con la ayuda de unos cuantos pirados como él. Armas Aunque...
La gente de The Trash Lab creó este curioso, bello y a la vez inquietante vídeo time-lapse de la ciudad de San Francisco sin personas en las calles. Tiene un toque surrealista y terrorífico a la vez que poético; podría ser...
HAL 9000 Replica (vía Coolest Gadgets) es una recreación del mítico ordenador malvado en la película 2001: Una odisea del espacio. No parece servir para nada más que como elemento decorativo que dice frases, y cuesta 499 dólares (unos 400 euros)....
Por Nacho Palou -
19 OCT 2012
Ahora que hemos aprendido que todas las fotos que aparecen en las revistas son mentira, y que se pueden hacer retoques a lo Photoshop también con los vídeos, anuncios publicitarios y películas, sólo nos queda saber cuán fácil es este trabajo....
Mapping The Entertainment Ecosystems of Apple, Microsoft, Google & Amazon muestra de forma visual la disponibilidad que tienen en todo el mundo los ecosistemas de entretenimiento de Amazon, Apple, Google y Microsoft, específicamente contenidos digitales de música, películas, programas de televisión,...
Por Nacho Palou -
17 OCT 2012
Defiance es una serie de ciencia-ficción con extraterrestres a tutiplén, producida por Rockne S. O'Bannon, que emitirá SyFy en abril del año que viene; lo más curioso tal vez es que tendrá «fuertes vínculos» con un MMOG (videojuego multijugador masivo en...
En este póster de más de un metro de ancho pueden leerse con todo detalle los títulos de más de 2.000 importantes largometrajes de todos los géneros y subgéneros desde que el cine es cine: The History of Film. ¿Cuántas de...
Ijon Tichy es un personaje recurrente en las novelas y colecciones de relatos de Stanislaw Lem, y si sus aventuras son a menudo como poco surrealistas la adaptación que hizo la ZDF ya roza cotas estratosféricas. Arriba está el segundo capítulo...
Me llamó mucho la atención el inicio de la producción de la película Iron Sky hace ya un par de años. El proyecto comenzó sin muchos recursos y financiándose sobre la marcha, incluso con aportaciones de particulares o "vendiendo" el acceso...
Por Nacho Palou -
10 OCT 2012
He aquí algunas imágenes de Winged Planet, un documental de Discovery Channel en el que las cámaras HD van montadas sobre los propios protagonistas: las aves. Tal y como explican en MAKE -que es por donde lo vi pasar- básicamente destriparon...
100 habitantes de Amsterdam con edades entre 1 y 100 años dicen su edad a la cámara en este vídeo. Dice el autor que, como es lógico, le costó especialmente encontrar gente en los dos extremos de la serie, en especial...
Un homenaje a los escritores de la serie, a la cultura libre y a todos lo que crearon Lostpedia con sus más de 7000 artículos. A falta de Perdidos bueno es recuperar los guiones y visualizarlos de forma artística de una...
El mañana ya no será nunca lo mismo El vídeo de este viernes es un cortometraje que estoy seguro gustará por aquí: dura menos de tres minutos y está ambientado en el año 2020. Lost Memories está escrito y dirigido por...

Lo que tenéis que entender, niños, es que las cosas antes eran diferentes. Usábamos la electricidad para todo. En los ordenadores, en los teléfonos, incluso para hacer crecer la comida y para transportar el agua. Pero después del «gran apagón», nada...

Dredd (Pete Travis, 2012). En lo que parecía que iba a ser un día más en el trabajo al Juez Dredd le asignan a la novata Casandra Anderson para que se la lleve con él para hacer su evaluación final y...
Como vídeo del viernes en esta ocasión tenemos al grupo belga Willow, con este videoclip del single Willow, donde utilizando tecnología bastante-baja se simula una especie de «sala de hologramas» como la del Enterprise D. Es lo que los expertos llamarían...
Acabo de ver en el Telediario que los hermanos Wachowski vuelven a la carga con Cloud Atlas, una película cuyo trailer tiene buena pinta y que según el resumen de la web oficial: explora como las acciones y consecuencias de cada...
Los apartamentos de Shelodon y Leonard y el de Penny en The Big Bang Theory Iñaki Aliste Lizarralde se ha currado, a base repasar a conciencia las series en cuestión, los planos de algunas de las «sitcoms» más populares de todos los...
En 1902 George Méliès estrenaba Viaje a la luna (Le voyage dans la lune), una de las primeras películas de la historia del cine y también de la ciencia ficción. De tan solo 14 minutos de duración (y rodada a 16...
Un pequeño estudio sobre la perspectiva en algunas de las películas de Stanley Kubrick: dicen que hacía uso de un alto grado de simetría para darles un toque psicológicamente irreal a algunas escenas. Sobre el diseño «imposible» de los escenarios de...
Red Dwarf, que llegó a España como Enano Rojo, es probablemente una de las series de ciencia-ficción espacial más divertidas y absurdas que pudimos disfrutar en nuestra niñez: de hecho era más bien una especie de comedia británica de personajes que...
The Newsroom, de Aaron Sorkin (HBO, 2012). Con Jeff Daniels –grandioso– Emily Mortimerm, Dev Patel y Jane Fonda. Es probable que The Newsroom sea la serie revelación de la temporada y la que más premios coseche: es toda una obra de...
Un pequeño vídeo acerca de cómo se ha restaurado Tiburón (1975) para su edición en Blu-ray con motivo del 100º aniversario de Universal Pictures, a partir de unos negativos bastante chungos y rayados, con el color bastante deteriorado: miles y miles...
Luis, Elio y la gente de Sopa de Sobre y La Huella FX nos escribieron para contarnos sobre un proyecto en el que llevan ya tiempo trabajando: una adaptación como cortometraje de animación de la clásica novela de ciencia ficción de...
La vida casi como si fuera un juego: un cortometraje futurista muy visual y con excelentes efectos especiales, que recuerda un poco al Project Glass de Google y todas sus potenciales posibilidades, aunque en versión lentillas biónicas. Un trabajo de Eran...
Prometheus (Ridley Scott, 2012). En 2089 una expedición arqueológica a la isla de Skye descubre un mapa estelar entre las pinturas rupestres de una cueva con unos motivos muy similares a otros aparecidos en otras culturas que existieron en la Tierra...
En Think Geek venden una camiseta con el dibujo de un Flux Capacitor en pleno fluzeaminto. Muy apropiada para vestirla ayer. (Vía FashionablyGeek.)...
La camiseta You Can’t Take the Sky from Me, homenajeando a los clásicos....
15 temporadas de la historia de la sala de urgencias del hospital County General en Chicago son la base de Urgencias, una de las series que más me han gustado en mi vida y que recomendaría a cualquiera, aunque es bien...
Bendito Machine es un proyecto de Jossie Malis y su gente: seis años trabajando pacientemente en una serie de animación sobre máquinas y ridículos comportamientos humanos. Los episodios se pueden ver en su web y con el tiempo se ha convertido...
#carminaorevienta se está convirtiendo en un fenómeno gracias a vosotros.Os pregunté si la compraríais.Dijísteis sí y dicho y hecho. Gracias— paco leon (@pacoleonbarrios) julio 8, 2012 Con unos 30.000 visionados en línea y un 85 por ciento de los DVDs editados vendidos...
Continuum (de Simon Barry, 2012). Toda serie que incluya viajes en el tiempo comienza con buen pie, y si además la trama principal son las paradojas intrínsecas del asunto, mejor que mejor. Por eso esperaba el estreno de Continuum con verdaderas...
Todos conocemos a Paco León fundamentalmente por su papel de Luisma en la serie Aída. Pero si Luisma va por la vida sin enterarse de nada, Paco León parece tener muy claras las cosas al haber tomado la decisión de estrenar...
Para empezar el viernes relajaditos, una de esas espectaculares proyecciones de imágenes sobre un edificio que hacen que este cobre vida propia. En este caso se trata de una creada por URBANSCREEN para ser proyectada sobre las «velas» de la Casa...
Blade Runner cumple 30 años y se mantiene estupendamente. El 25 de junio de 1982 se estrenó en los cines de Estados Unidos esta obra maestra de la ciencia-ficción. Blade Runner se basa en el relato ¿Sueñan los androides con ovejas...
Ayer, mientras la selección española machacaba inmisericordemente a la francesa en los cuartos de final de la Eurocopa, RTVE emitía en Informe Semanal una mini biografía sobre Nikola Tesla, que probablemente tuvo audiencia cero, pero que podemos recuperar ahora mismo gracias...
La gente de Comedy Central se ha currado esta promo para la nueva temporada de Futurama, en la que han recreado la secuencia del comienzo de los episodios con objetos reales, en forma de maquetas y «efectos especiales de bajo coste»....
¿Que cómo de grande eran los transbordadores espaciales comparados con las Soyuz o el SpaceShipOne? Pues Invader Xan se ha currado esta imagen en la que se ven un montón de naves espaciales reales a la misma escala para poder comparar...
Desde Bigotes y cejas nos recomendaron Cerulean, este curioso videoclip de Simian Mobile Disco, con muchos toques RGB de videojuego clásico, con formas geométricas como protagonistas. Countdown, una animación musical astronáutica Midnight City, un poco de música relajante con una buena...

… But you can’t take the sky from me. ¿Por qué no? Al fin y al cabo, ambas son de Joss Whedon. Este tipo de montajes los hace Cruciatus a partir de los originales, simplemente como entretenimiento – y le quedan...
El comité de Mercado Internacional, INTA, del Parlamento Europeo le ha dado hoy otro buen golpe al tratado ACTA, el Anti-Counterfeiting Trade Agreement, o Acuerdo Comercial Anti-Falsificación. Con los votos a favor de Socialistas, Liberales, Verdes y la Izquierda Unitaria, se ha...
Una simpática composición animada de los títulos de crédito de Star Trek, pero utilizando dibujos y jugando con las tipografías, con la voz original del Capitán Kirk de fondo y elementos de las otras series de la saga también: Star Trek...
Gracias a lo que cuenta David Bravo en Llega el primer caso a la Comisión Sinde: por qué es más peligrosa de lo que parecía ya sabemos el primer nombre de un sitio web español que tiene que enfrentarse con los...
El vídeo relajante de este viernes es Countdown, una animación que encontré en un RT del equipo de El Cosmonauta. Es un trabajo de Céline Desrumaux, con toques de Stanley Kubrick, Hans Richter, Len Lye y Godfrey Reggio. La banda sonora...
SPACE ODYSSEY por Chilefixers en Vimeo. Space Odyssey: Voyage To The Planets (BBC, 2004). Se trata de un falso documental que narra el viaje de seis años por el sistema solar de la nave Prometeus en una misión conjunta de la...
He visto ya unas cuantas veces el trailer de ¡Rompe Ralph! y estoy seguro de que aún se me pasa alguna de las múltiples referencias y homenajes a videojuegos de todos los géneros que contiene… No quiero ni pensar en lo...
Ayer los comités de Industria, Asuntos Legales, y Libertades Civiles del Parlamento Europeo votaban su posición respecto al tratado ACTA, el Anti-Counterfeiting Trade Agreement, o Acuerdo Comercial Anti-Falsificación, y los tres votaron que no lo van a apoyar. Su voto, igual que...
Acostumbrados a tanta historia espacial de la NASA, bien viene un pequeño cortometraje animado para desengrasar. Es un delicioso –y nunca mejor dicho– trabajo de Corentin Charron, del tercer curso de la escuela de animación SupInfoCom. Está hecho con 3ds Max...
Un auto fechado el 11 de mayo pero comunicado el 28 a las partes entiende que no hay motivos suficientes para suspender la aplicación del Reglamento de la Ley Sinde-Wert, y que en todo caso será su aplicación y no el reglamento...
Un tributo pixelado a las armas en la ciencia ficción, la fantasía y los videojuegos: desde los phasers de Star Trek a Mazinger Z, Excalibur o los gadgets de Robocop. (¡Gracias, Riot Cinema!)...

Una recopilación interesante de fotos relativamente poco conocidas de los rodajes de la trilogía Regreso al Futuro, datadas entre 1985 y 1990. Interesantes porque complementan aquellas otras fotos inéditas de los decorados de Hill Valley que salieron a la luz el...
En los Estados Unidos ya se habían publicado algunas sentencias que decían que una dirección IP no identifica a una persona, como en el caso de la demanda Hard Drive Productions contra 90 personas por descargarse una de sus películas, una similar...

Los juegos del hambre (Gary Ross, 2012). Web oficial. Razonablemente entretenida, Los juegos del hambre se deja ver bastante bien y está dignamente interpretada, ambientada y con muy buenos actores secundarios. Situada en un futuro distópico donde se elige a jóvenes...
Un apagón. Todo aparato eléctrico deja de funcionar en el planeta. Y la humanidad retrocede a siglos pasados. Como planteamiento apocalíptico es prometedor, y está producida por J.J. Abrahams. A ver si es tan buena como el trailer....
Este artículo se publicó originalmente en La Voz de Galicia, donde colaboramos habitualmente. Esta es la versión sin límites de espacio y con enlaces. Antón Reixa, recién elegido como nuevo presidente de la SGAE, realizaba el pasado mes de marzo unas declaraciones...
Bonito montaje este de la gente de BARB con un megaremix de lo mejor que ha pasado por los tubos de Internet en lo que llevamos de 2012 –en cuanto a vídeos creativos se refiere– incluyendo nuevas técnicas, ideas y tomas...
De nombre extraño y misteriosamente sonoro, Hartverdrahtet fue el ganador del concurso PC 4kB. En ese concurso de programación el software presentado deben ocupar 4 KB de código fuente como máximo. El original funciona en Windows XP/Vista/7 y de su ejecución...
The Avengers (Joss Whedon, 2012). Entretiene, divierte, emociona un poco y cumple su cometido. Como película de superhéroes, está muy bien. Watchmen seguirá siendo superior, pero así es la vida. Para pasar un buen rato de cine con refresco, palomitas, niños...
Tarde, mal, y a rastras, van llegando las opciones autorizadas para ver series, películas, y documentales en línea en España. Con la reciente apertura a todo el mundo de Youzee, que hasta el momento sólo estaba disponible por invitación, Antonio Delgado...
El corto Blinky™ de Ruairi Robinson es algo viejuno pero no me suena haberlo visto antes. Es el resultado de 45.000 euros de presupuesto y una post producción "que llevó unos nueve meses de infierno" en palabras de su autor. "Hay...
Por Nacho Palou -
23 ABR 2012
David: tecnológico, intelectual, físico, emocional. El androide perfecto: Otro producto de Industrias Weyland, para ayudar a los seres humanos y a sus empresas. Y hasta aquí puedo leer. (Vía Uruloki.)...
El viaje en el tiempo todavía no se ha inventado. Pero dentro de 30 años, lo inventarán. Por aquí nos gustan más las películas de viajes en el tiempo que a un tonto un lápiz, así que estamos encantados con que...
Un ingenioso montaje con la tercera parte de la trilogía Regreso al futuro devolviéndola al estilo de principios del siglo XX. Como la auténtica está ambientada en la época del lejano oeste queda muy resultona, casi un homenaje a El maquinista...
Estuve viendo el episodio piloto de Touch, protagonizado por Kiefer Sutherland, que está emitiendo la Fox desde hace unos días. No se puede revelar mucho sobre la trama sin desvelar sorpresas, pero baste decir que es acerca de un niño especial...

¿Te pareció complicada de entender la trilogía de Regreso al Futuro? A Mushir Hoda, también, de modo que dibujó una infografía que explica todo lo que sucede salto temporal a salto temporal. Todo esto sucedería en la tradicional interpretación cósmica de...
Nos ha llegado el primer póster de The Pelayos, la historia del mítico clan de jugadores de ruleta que ganaron a la banca en casinos de España y de todo el mundo – pataletas legales posteriores incluidas. Se estrenará en el...
Este vídeo tiene todas las papeletas para ir a WTF pero la cosa es seria: recoge el momento carrera de aceleración entre el batmóvil de la serie de televisión de 1960 y el vehículo que utiliza Batman en la película de...
Por Nacho Palou -
21 MAR 2012
Ya, que sí, que luego ponemos las expectativas muy arriba y el batacazo es monumental, pero… ¡Ya está tardando en llegar Prometheus, la precuela de Alien! (Vía, una vez más, Uruloki). Trailer de Prometheus, la precuela de Alien: para ir salivando...
El azar ha hecho que la vida de Zero se vea afectada de forma muy negativa por los prejuicios de la sociedad en la que nace, en la que todo el mundo lo desprecia por haber nacido como ha nacido… Hasta...
Todo un detallado estudio de Delia Rodríguez sobre uno de los fenómenos grandes de la memética de este año....
A relajarse que es viernes, con Prismatica, de Kit Webster, un curioso montaje en el que se utilizan cristales sobre una pantalla LCD para producir curiosos patrones de luz y color. (Vía Boing Boing.) Slow Snow, a relajarse en la nieve...
El otro día conocí a Manuel González, profesor de Historia en el IES Concepción Arenal de Ferrol, quien me habló de su proyecto Cliphistoria, con el que intenta acercar a sus alumnos –y a cualquiera que pueda estar intersado en el tema–...
Slow Snow (Motion): Iceskating in Amsterdam es un relajante vídeo grabado por Enzo Angilletta durante una tarde de patinaje sobre hielo en los canales helados de Ijburg, un barrio de Amsterdam. La música es July de Youth Lagoon. Distorsión temporal, el...
Construyendo Mundos Mejores es su lema; el vídeo está dirigido por Ridley Scott. Y no digo nada más. Ahí lo dejo....

He sido amablemente invitado por AGAPI, la Asociación Gallega de Productoras Independentes, a participar en un taller-debate sobre el tema de las descargas no autorizadas dentro de la jornada A obra Audovisual, propiedade intelectual e contexto dixital que se celebra hoy en...
El orden en que se grabaron y proyectaron las películas de la saga de La guerra de las galaxias, para muchos el orden natural es IV, V, VI, I, II y III Pero el orden cronológico de la propia saga sería I,...
Temporal Distortion, de Randy Halverson, es un relajante vídeo de viernes, que cuenta con el bonus de una banda sonora de Bear McCreary, que también ha compuesto música para Galáctica: Estrella de Combate, The Walking Dead y Eureka. Se puede ver...
Thread of Life (1960) es una antiquísimo documental divulgativo sobre cómo funciona la herencia genética en los seres humanos: qué son los genes, el ADN y cómo se transmite la información de una generación a otra – al menos lo que...
Cristobal Vila de Eterea Estudio, autor de maravillas como Nature by Numbers o Snakes, nos envió su última creación: Inspirations, que conviene disfrutar en HD. La relajante música de fondo es de Ólafur Arnalds. Inspirations recrea una combinación de mundos matemáticos,...

Last Day Dream (2009), un maravilloso microcorto de Chris Milk....
Tras algunos años en producción financiada muy en parte de forma independiente, a base de donaciones de particulares, la película Iron Sky se proyectará este fin de semana en el Festival de Cine de Berlín, la Berlinale. En 1945 los nazis...
Por Nacho Palou -
9 FEB 2012

Tienen una vida y se la van a jugar. Primero fue el libro, que parecía casi el guión de una película, y ahora es… la película. La Fabulosa Historia de Los Pelayos ha sido llevada a la gran pantalla y se...
Titulado Signal to Noise tenemos este estupendo montaje medio time-lapse, medio efectos animados, de Douglas Koke con las antenas del radiotelescopio VLA (Very Large Array) de protagonistas. Situado en Socorro, Nuevo México, es el mismo lugar que se usó como escenario...
Un tributo de Nick McKaig a nuestra serie favorita, aunque repitan y repitan los viejos episodios más de lo deseable....
The German de Nick Ryan en Vimeo. The German, de Nick Ryan es un corto irlandés sobre la II Guerra Mundial que relata la persecución de un piloto inglés a un piloto alemán, primero por aire y después a pie, por tierra....
Por Nacho Palou -
30 ENE 2012

Una simpática animación de Richard Giles, que dura un par de minutos y que hará reir a los amantes del meta-humor y a las historietas en que los dibujantes se ensañan desde un plano superior de la existencia con sus pequeños...
El vídeo de Todd Sandler homenajea a Steven Spielberg -en su consecución del premio David O. Selznick- recopilando escenas de cada una de las películas en las que Spielberg ha participado como productor, productor ejecutivo y/o director. No me considero particularmente...
Por Nacho Palou -
24 ENE 2012
Conviene verlos en alta definición y a pantalla completa, para no perderse detalle. Increíble la cantidad de trabajo, capas y capas que puede haber en cualquier nimia escena… De ahí el resultado de tan alta calidad, claro. Después de ver este...
La aplicación Action Movie FX (para iPhone, iPad y iPod, gratuita en la App Store con algunos efectos adicionales de pago) aplica diversos efectos típicamente peliculeros –coches o helicópteros que caen, explosiones de misil, ataques aéreos,...– en vídeos grabados con el...
Por Nacho Palou -
23 ENE 2012
Sherlock: temporada 2, de Steven Moffat y Mark Gatiss. Con Benedict Cumberbatch y Martin Freeman. BBC One. (En España la emiten TNT / Antena 3) La segunda temporada de Sherlock son otros tres episodios de casi 90 minutos de duración, prácticamente...

Dale al HD 1080p, pantalla completa y a flipar. Si hacía falta una buena excusa para volver a verse las siete temporadas de Star Trek: la nueva generación hela aquí: la gente de Paramount lleva años restaurando el original en HD...
Empezando por una imagen transparente y buscando en Google Imágenes usando la función «imágenes relacionadas» van apareciendo imágenes ligeramente distintas pero cambiantes en cada interacción. Sebastián Schmieg se entretuvo en recopilar 2.951 de ellas y montarlas en un vídeo, al que...
Las licencias Creative Commons permiten conectar al autor directamente con su audiencia, impulsan la co-creación y la co-producción, además permiten que la obra se comparta de modo que alcancen el mayor número de espectadores. Disfrutaremos del mejor cine durante el fin...
La recopilación de la lista original de #ComparteCultura es obra de @kurioso y está en #ComparteCultura. P2P La mejor forma de ejercer tu derecho a compartir con otros usuarios de la red es el P2P (Peer-to-Peer). El P2P sirve para intercambiar...
Black Mirror: tres episodios más que recomendables sobre el «futuro que podría ser» el impacto de la tecnología y las redes sociales en nuestras vidas y un montón de ideas respecto a todo esto....

Este artículo se publicó originalmente en Cooking Ideas, un blog de Vodafone donde colaboramos semanalmente con el objetivo de crear historias que «alimenten la mente de ideas». Estuve viendo los tres episodios de Black Mirror (2011) después de que la calificaran...
El vídeo muestra los cinco primeros minutos de la película Olive (ficha en IMDB), autoproclamda con "el primer largometraje de calidad cinematográfica grabado íntegramente en un teléfono móvil inteligente". Para filmar los 89 minutos de película se utilizó un Nokia N8,...
Por Nacho Palou -
28 DIC 2011
De la mano del mismísimo Ridley Scott, la historia de cómo llegamos a Alien, el octavo pasajero: el trailer oficial y en HD. Una de las grandes sagas de la ciencia ficción de todos los tiempos, entre las favoritas de los...
El vídeo de este viernes es una preciosa historia de Sharon Wright, que ha ganado premios en varios festivales y que además tiene un punto de espíritu navideño apropiado para estas fechas. Relacionado: Génesis, un futuro no tan lejano La dirección...
En junio de 2008 Promusicae, Sony BMG Music Entertainment S.A, Universal Music Spain S.A., y Warner Music Spain S.A. denunciaron a Pablo Soto reclamándole 13 millones de euros al entender que había desarrollado sus aplicaciones para intercambio de archivos mediante redes P2P...
Homeland (Showtime, 2011) es la serie adecuada para aquellos que se quejan de que «no hay ninguna serie decente» últimamente. Podría describirse como un combo entre 24 + Sleeper Cell con una protagonista (Claire Danes) de tintes y actitudes jackbauerianas aunque...
Youzee es un servicio de videoclub online para alquilar películas y series. De momento funciona a través del navegador web y mediante invitación, pero a partir del año que viene –en cuestión de semanas, como quien dice– estará disponible para todo...
Por Nacho Palou -
16 DIC 2011
Y hoy viernes, niños, crearemos un Universo. Un corto de animación 3-D de Andreas Wannerstedt, con música de Niveau Zero, que en su página explica además cómo se hizo… el cortometraje, no el Universo. (Vía Fubiz.) La dirección es aproximada, altamente...
Un audio en YouTube de 24 horas de duración, con el sonido ambiente del Enterprise 1701-D de Star Trek: La nueva generación. El típico ruido blanco de fondo, tan familiar como tranquilizandor, con el que puedes convivir a bajo volumen o...
Siendo hoy martes y 13, qué mejor ocasión para recuperar el episodio de Escépticos dedicado a las supersticiones: Es sólo uno de los trece episodios de una serie que ha demostrado que otra televisión es posible, en la que el pensamiento crítico...
Cinco minutos de cortometraje con unos efectos especiales CGI muy bien integrados en la historia, que está muy bien contada y además tiene una fotografía excelente. La localización y la ambientación también ayudan, claro, pero se ve que hay el trabajo...
Más de una hora, (sí: ¡más de una hora!) de imágenes del Cosmos acompañadas de música relajante, dignas de servir de salvapantallas en HD mientras te entretienes haciendo cualquier otra cosa. Enchúfalo a pantalla completa en la tele y será cien...
Un montón de cajas y gentecilla por ahí. What it Looks Inside Amazon.com, en Buzzfeed, con unas impresionantes fotos de Matt Cardy para Getty Images. Mmmm… ¿Dónde habré visto yo esto antes? Ah, sí… En busca del Arca perdida (Steven Spielberg,...
Un vídeo creado con la técnica de time-lapse a partir de fotos de altísima calidad, lo que le confieren un aire un tanto mágico a la espléndida ciudad rusa. Es un trabajo de Artem Sergeevich. Creo que produce el mismo tipo...
Jugando con Google Street View y aquello de que «la dirección indicada es solo aproximada» Tom Jenkins de The Theory Films creó este impresionante corto de animación que resulta tan entrañable como conmovedor – ideal como clip de los viernes. Un...
Ya habíamos hablado por aquí del último evento Burning Man, esa experiencia medio hippie medio artística medio futurística ambientada a lo Mad Max II, en el desierto de Black Rock (EE.UU.) Con este vídeo titulado Burning Man, Rites of passage (Day)...
Hervé Attia se dedica a ir recorriendo escenarios y decorados en los que se rodaron películas famosas y a filmarlos para luego hacer montajes en los que se superponen o se ponen lado a lado imágenes de la película y las...
Un pequeño trabajo en stop-motion con unos resultados visualmente muy interesantes y coloridos, además de una música muy animada, propia de los alegres vídeos del viernes. Es un trabajo de Constantine Konovalov, Irina Neustroeva y el equipo ruso de Teeter-totter-tam. The...
Este corto de animación, realizado íntegramente con cubos, es obra de Or Bar-El, y se llamaBeat. Para ser su primer intento en animación 3-D parece que tiene un futuro muy prometedor en la Academia de Arte y Diseño Bezalel en la...

El Cosmonauta sigue con rumbo firme tras tres años de trabajo, aventuras y disquisiciones. Miles de pequeños productores han colaborado en modo crowdfunding con este largometraje que todavía está en la fase de montaje pero que ya tiene trailer oficial y...
Disponible al completo, en gloriosa alta definición y con subtítulos, Life in a Day, producida por Ridley Scott y dirigida por Kevin Macdonald, redujo las 4.500 horas de vídeos enviados por unas 80.000 personas de 192 países a una hora y...
Torchwood: Miracle day. 10 capítulos, con varios escritores y directores. Oswald Danes, condenado a muerte por la violación y asesinato de una niña, es ejecutado mediante una inyección letal en la cárcel de Jacksonville, en Kentucky. Pero algo sucede y Danes...
GuzHeln nos pasó el enlace a este curioso vídeo musical que es una interesante combinación de imágenes medio fractales, medio escherianas, medio isomórficas, medio sin fin: ideal para acabar bien la semana hoy que es viernes. La música, con un apropiado...
Para recordarnos lo cerca que están a a veces el homenaje y el remix de la copia descarada, Rob Wilson se curró este montaje titulado Everything is a Remix: The Matrix. Con esto el trabajo de los Wachowski se une al...
¡Ya es viernes! Y si ves este vídeo, rejuveneces quince o veinte años. Música pintada, tan laborioso como bonito montaje Tape Generations: arte con rollos de celo La madre de todas las batallas de globos de agua, muy colorida Desierto, un...
The Alphabet 2, un corto vídeo-experimento, es una curiosa y muy elaborada representación visual del alfabeto combinando distintas técnicas. Una idea de Alessandro Novelli y n9ve....
Que la música puede «verse» de otra forma queda demostrado con Music Painting, un montaje de Matteo Negrin para disfrutar y relajarse aprovechando que es viernes y ya toca. A diferencia de otras versiones que circulan por televisión, aquí la música...
Escépticos: trailer por Jose A. Pérez en Vimeo. Tras el éxito del estreno del piloto ¿Fuimos a la Luna? y de que con ello la ETB encargara una temporada completa de Escépticos, hoy por fin comienza la emisión de la primera temporada...
Imposible no esbozar una sonrisa –o soltar una sonora carcajada– con este corto de Teemu Nikki. Es otro de los vídeos surgidos de la Nokia Shorts Competition, en donde quedó finalista. (¡Gracias Alejandro por el enlace!) Tape Generations, ¿se puede hacer...
Este artículo se publicó originalmente en Cooking Ideas, un blog de Vodafone donde colaboramos semanalmente. Desde hace años la industria audiovisual vive obsesionada por el hecho de tener que enfrentarse a que los compradores podamos hacer copias del material que nos venden....
Nos quejamos a menudo de lo caro que está todo, de lo costoso de soterrar la M-30 y de las obras del AVE ya ni hablemos, pero… ¿Qué pasa ahí fuera, comparativamente hablando? Unos economistas del Pentágono han calculado el coste de...
The Future According to films es una cronología de la historia del mundo según la ciencia-ficción. Elaborado por Michael Hobson de Tremulant Design permite darse cuenta de lo cerca que están algunos eventos que considerábamos futuros: Blade Runner, Akira, Soy leyenda,...

Super 8 (J.J. Abrams, 2011). Web oficial: Super8. Si sumas Encuentros en la tercera fase + E.T.: el extraterrestre + Los Goonies + Cloverfield te sale Super 8. En ciertos momentos es como ver una película de un J.J. Abrams poseído...
Tal día como hoy, un 8 de septiembre, pero de hace 45 años (¡1966!) se emitía el primer episodio de Star Trek, una de las más míticas series de ciencia-ficción de todos los tiempos. Ahora Space.com ha publicado una interesante infografía...
The Desert 2011, de Matt Pitcher, es el relajante vídeo del viernes: 30 segundos de calma total que no es lo que parece a los que siguen una zambullida en escenas de acción con una agradable música de fondo: Frank, AB...
Dando vueltas por YouTube me he encontrado con la primera adaptación a película de Solaris, escrita por Nikolay Kemarsky y dirigida por Boris Nirenburg en 1968 para la televisión. Está dividida en dos partes, Солярис (1968) 1/2 Телеспектакль, insertada arriba, y...
La memorable descripción de la sensación en un comentario de Israel en Tu blog de cine lo resume todo: Esta imagen, que es más de los Ultimate Avengers que de Los Vengadores propiamente dichos, me remite directamente a la niñez. A...

Industrials Revolutions de Stu Thomson (Cut Media) son los cinco minutos de vídeo-relax del viernes. Están protagonizados por el mago de la bici y el equilibrio Danny Macaskill en un entorno industrial decadente de esos que tanto nos gustan, fotografiado con...
The Walking Dead. Escrita y dirigida por Frank Darabont, Michelle MacLaren, Charles H. Eglee, Jack LoGiudice, Robert Kirkman, Johan Renck, Glen Mazzara, Ernest Dickerson, Adam Fierro, y Guy Ferland. Sitio web oficial. Rick Grimes, ayudante del sheriff en un pueblo de...
Esta es sólo una minúscula muestra de los 180 robots que salen en Where's WALL-E [jpeg 1 MB], dibujado por Richard Sargent. Personalmente, reconozco una parte muy pequeña de ellos, y les se poner nombre aún a menos, lo que deja...
Los chicos de Move tenían preparadas otras dos piezas con unos montajes muy parecidos al original pero con temas distintos: Learn y Eat, el aprendizaje y la comida. Supongo que después de viajar por 11 países durante 44 días mejor aprovechar...
SpaceTrek, un Tumblr dedicado a recopilar decorados vacíos -o casi- de Star Trek, la serie original. Y en otras noticias sobre Star Trek... a lo mejor para 2014 vemos un parque temático de Star Trek completamente oficial en el que según...
Möbius, creado por Benjamin Ducroz y ENESS es el vídeo relajante de este viernes: una especie de «escultura colaborativa» móvil pero inmóvil, que se instaló en Federation Square en Melbourne (Australia). Al parecer la gente podía ir y mover las piezas,...
Mundo Hacker TV, que nació en la radio para luego saltar a la televisión por Internet a través de Globbtv, ahora va a poder llegar al gran público en Telecinco a través de Nosolomúsica. Será con cuatro programas especiales que se emitirán...
Hace tiempo le oí decir a @pixel que la voz masculina que anuncia las próximas paradas y correspondiencias de líneas del Metro de Madrid era la de Blas, el entrañable personaje de Barrio Sésamo, pero hasta hoy no había encontrado forma...
Tal y como cuenta el New York Times, la Fox ha encargado a National Geographic 13 episodios a modo de remake de Cosmos: un viaje personal, la obra de divulgación definitiva de Carl Sagan. En la nueva serie participarán Seth MacFarlane...
Origen del Planeta de los Simios (Rupert Wyatt, 2011). Como dicen casi todas las reseñas que había medio leído y oído antes de ver la película, esta precuela o intermediocuela de El Planeta de los Simios, en versión modernizada, está bien...
Lo más curioso de A History Of The Title Sequence es que nació como una «posible» secuencia de títulos de crédito para un documental, y acabó siendo… una narración sobre los títulos de crédito a lo largo de la historia del...
Move es un proyecto de Rick Mereki, Tim White y Andrew Lees con un resultado muy profesional, que muestra un viaje de 60.000 kilómetros en una especie de secuencia milimétricamente coordinada compuesta de planos de unas pocas décimas de segundo cada...
The Beauty of Maps (Steven Clarke, 2010) es un excelente documental BBC Four, que a lo largo de dos horas y cuatro capítulos recorre el maravilloso mundo de los mapas, su historia, arte, belleza y sus detalles y misterios. Rodado además...
Paul es una película para pasar el rato, pero dentro de lo que se puede esperar está el pack completo que adoraría todo geek: una mezcla de E.T. con Encuentros en la Tercera Fase, convenciones de frikis de los comics, princesas...

Los amantes del cine de Stanley Kubrick apreciarán esto: un análisis detallado titulado Film Psychology: «The Shining», Spatial Awareness and Set Design en el que Rob Ager analiza las imposibilidades físicas de los escenarios de El Resplandor (1980), probablemente una de...
A relajarse y disfrutar del arte y la técnica de Supakitch; otra relajante pieza audiovisual para empezar bien el viernes y el fin de semana que se avecina. Relacionado: Fuegos artificiales caseros, grandes bolas de fuego Splitscreen, una historia de amor...
La gente de InOutTV nos envió amablemente una unidad de pruebas del InOutTV MediaCenter 4G HD Full Equip, el último modelo de su mediacenter / DVR concebido para grabar la televisión digital en HD (alta definición) y gestionar otras funciones de...
Source Code (Código fuente, 2011) de Duncan Jones, es una de las pelis de ciencia ficción de este año que no había podido ver hasta ahora. Cuenta de forma repetitiva los ocho últimos minutos de una explosión en un tren de...

Devin Graham es el creador de Homemade Fireworks [HD], una preciosa pieza audiovisual en la que Aaron Sorensen puso los efectos especiales y Stephen Anderson la música, parte integral de la historia – no se usó ningún sonido de ambiente original....
Begins. Falls. Rise. Bonito póster así como quien no quiere la cosa para irse preparando para Batman: The Dark Knight Rises, que completará la trilogía de la era Nolan cuando se estrene el año el verano… de 2012. Para terminar de...
Jorge, de la popular serie Malviviendo, lleva años peleándose con YouTube y el famoso «contador de visualizaciones»; se ha convertido en un pozo de sabiduría al respecto y nos ha contado por correo un montón de cosas que añadir a lo que...

¿Muestra el contador de YouTube el número de gente que ha visto completo un vídeo? ¿O tan solo los que han pulsado play independientemente de que abandonen la reproducción a los pocos segundos? Siempre sospeché que era lo primero, pero la confirmación...
Aunque la parte complicada desde luego era el montaje, todas las escenas de Splitscreen: A Love Story, una bella pieza de JW Griffiths, están grabadas con un N8 de Nokia. Combinando una buena idea con una cuidada fotografía y una música...
El vídeo relajante de los viernes es en esta ocasión un poco viejuno (2008) pero merece la pena; se llama Alone in Tokyo es de Philip Bloom. Está grabado con una Sony EX1. La música es de Air, y está editado...
No entiendo cómo se me pudo pasar este vídeo si es de hace un par de años, pero bueno… Gracias a rvr que lo rescató he podido disfrutar los diez minutos preciosos de On the Set of Blade Runner (también es...

Erica Haowei Hu es la autora del clip artístico-musical-relajante de este viernes, una bella y surrealista animación sobre el paso de las estaciones, ahora que ha comenzado el ansiado veranito. Está creado con After Effects, Cinema 4D y Maya. Relacionado: Extremities...
Nacho encontró este enlace a una breve aunque interesante y diría que poco conocida colección de polaroids propiedad de la actriz Sean Young (Rachael) realizadas durante el rodaje de Blade Runner, probablemente la mejor película de la historia. Los secretos tras...
¡Ay, cómo se echa de menos Galáctica! Para compensarlo, esta ingeniosa camiseta Starbuck’s. (Vía Geeks are Sexy.) Starbucks en un Starbucks, rizando el rizo Geek & Gamer Girls, incluyendo a Katee «Starbuck» Sackhoff...
¡Incluyendo escenas con humo y llamas! Es el trailer de Bots High, un documental sobre los chavales que construyen robots luchadores. (Vía I Heart Robotics.)...
Estaba pendiente del estreno de Falling Skies desde que descubrí los cómics que le sirven de introducción en la tienda de Dark Horse, y ese estreno tiene lugar hoy en los Estados Unidos. La serie comienza seis meses después de la llegada...
Tras la impagable recopilación de Las mejores 50 películas de los años 80 Joan de Gazpachu nos ha avisado de que ha publicado la lista requetedefinitiva: 1001 películas que hay que ver antes de morir, con un ligero saborcillo friki. Si...
108 Lost T-Shirts es una interesante mega-selección de camisetas de Perdidos que Coty Gonzales hizo con motivo de la conclusión de la serie. Están repartidas por tiendas de todo el planeta. Aunque veinte no se pueden comprar y hay algunas un...
Los cubitos de hielo que querría Jabba El Hutt se pueden hacer con esta bandeja para hielo a la venta en The Green Head por unos 8 euros: Han Solo Frozen In Carbonite Ice Tray, vía The UberReview, donde consideran más...
Por Nacho Palou -
2 JUN 2011

¡Houston, Houston… El Cosmonauta tiene un problema! Resulta que el proyecto de El Cosmonauta atraviesa un momento difícil: uno de los socios ha fallado en el último momento y con el rodaje a medias la financiación del largometraje está en apuros....
Ecstasy of Order es un documental actualmente en postproducción muy al estilo de King of Kong, uno de nuestros favoritos. Según cuentan en el trailer, trata sobre la vida y competiciones de los «maestros del Tetris»: gente que lleva jugando desde...
The Island es un proyecto llevado a cabo por fans de Perdidos que consiste en reeditar la serie completa en orden metódicamente cronológico. La idea es que existan varias versiones; una por ejemplo con toda la historia dentro de la isla,...
Tercer teaser de la película Iron Sky, la película sobre el regreso de los nazis que en 1945 huyeron de la Tierra para esconderse en la cara oculta de la Luna. La película ya tiene además fecha de estreno, el 4...
Por Nacho Palou -
13 MAY 2011
Fox Mulder Wristwatch es un blog dedicado única y exclusivamente al reloj que lleva Fox Mulder en cada episodio de Expediente X. Porque hay blogs pa tó. (Vía Neatorama.)...
Nunca había sido muy fan -más bien nada en realidad- de Torchwood hasta que vi Children of Earth, su tercera temporada, que me gustó mucho. Así que estaré pendiente del estreno de Miracle Day, la cuarta temporada de la serie, en...

Another Earth pudo verse en el último festival de Sundance: es una historia sobre cómo se transforman las vidas de algunas personas cuando aparece de repente un planeta igual a la Tierra en nuestro Sistema solar, una especie de copia espejo...

Transformers 3 (Dark Side of the Moon) es como un videojuego espectacular en el que han insertado algunos de esos muñecos, cómo se llaman… ¡Ah, sí! Actores. Bonus: relanzará las conspiraciones lunares, promete el comienzo....
Desde el departamento de Definitivamente hay gente que tiene mucho tiempo libre llegan estas 1.900 líneas de código C (y un poquito de ensamblador) para explicar la película Origen como si fuera un programa informático: si se ejecuta el programa, se...
¿What is Reality? es un programa de Horizon emitido por la BBC a principios de este año, que explora algunas ideas relacionadas con el concepto de realidad. Aparecen en él un montón de físicos, que en breves entrevistas intentan explicar algo...
Exit Through the Gift Shop, de Banksy, es un documental –o algo parecido, lo cual además es parte de la gracia– sobre el arte moderno en general y el arte urbano en particular. Sólo puedo decir que es de esas películas...
Los protagonistas de Take Me Home Tonight se juntan con la banda Atomic Tom para versionar Don't You Want Me de The Human League en un vídeo lleno de referencias a películas de los 80 que a muchos nos sacarán más...
Por cuarto año, la WeekendTrek-CifiCon 2011 reunirá en Barcelona a los aficionados de Star Trek y de la ciencia-ficción en general, durante los días 17, 18 y 19 de junio en esta ocasión. Este año se contará con la presencia de...
Aunque no estarían fuera de lugar en una película de ciencia ficción, estas imágenes son parte de los efectos visuales creados por la empresa Burrell Durrant Hifle para Maravillas del universo, por lo que en realidad representan cosas que se pueden...
Salvo error u omisión la ley actualmente vigente en España al respecto permite hacer hasta tres copias de seguridad de los discos que compremos, algo que además en los últimos años tiene cada vez más sentido a la hora de poder poner...
No están todas, en especial dado que cada vez salen más ordenadores haciendo más cosas (muchas veces descabelladas) en cada vez más películas, pero en Access Main Computer File hay capturas de pantalla de los interfaces de ordenador usados en un...
Tal vez su nombre no te suene, pero seguro que has visto sus trabajos: Mark Coleran es el diseñador de una buena parte de las interfaces gráficas de ordenadores y otros aparatos que se ven en las películas de Hollywood. Entre...
Josh Nimoy habla en Tron Legacy del medio año que se pasó escribiendo software para generar los efectos especiales de la película del mismo título, incluyendo un montón de pantallazos. Pero casi lo que más me gustó es que el equipo...
Nos escribieron desde la Escuela Ténica Superior de Ingenieros Aeronáuticos de Madrid para contarnos que llevan tiempo preparando una obra de teatro, El hombre que siempre estuvo aquí, a modo de adaptación de la obra de ciencia-ficción The Man from Earth (que...
NetflixPrize-MovieMap-Titles-RedYellowOnWhite por Christopher Hefele Dejando aparte remakes y «homenajes» foto a foto, muchas películas se inspiran en otras, y aunque a menudo nos damos perfectamente cuenta de por donde van los tiros, no deja de ser sorprendente echarle un ojo a las...
Tenía pendiente de recomendar Kick-Ass, una película de Matthew Vaughn basada en el cómic de Mark Millar y John Romita Jr. que se estrenó el año pasado pasando ligeramente desapercibida. Tuve la suerte de verla después de que me regalaran el...
@CLenses (¡∞ gracias!) nos puso sobre la pista de Microserfs, la película homónima de la novela, un largometraje que según la IMDB existe o debería existir. Por un lado se la califica como película independiente con un reducido presupuesto de 35.000...
Pictogram Movie Posters, carteles de grandes obras del cine protagonizados por iconos minimalistas. Un simpático proyecto de Viktor Hertz (vía Un Mundo Libre)....

Wonders of the Universe, una miniserie documental de la BBC, es una especie de continuación del estupendo y divulgativo Wonders of the Solar System emitido el año pasado. Protagonizado por el profesor Brian Cox, «el nuevo Carl Sagan», Wonders of the...
Captain America: The First Avenger llegará a los cines en julio; el trailer permite hacerse una idea de cómo será la peli, aunque tiene mucho de pre-Capitán América y poco del superhéroe, pero bueno… Me gustaron los toquecillos que recuerdan a...

Inspiración musical para empezar bien el día.
En abril y diciembre de 2008 los juzgados de instrucción números 1 y 4 respectivamente ordenaban el archivo de los casos contra IndiceDonkey y contra Spanishare al concluir que un enlace no es un acto de comunicación pública. Esta semana, con apenas...

He aquí el tráiler de una serie de la BBC4 titulada Everything and Nothing sobre la naturaleza física del espacio y la materia. Es interesante cómo una mini-explosión que parece el disparo de un petardo de las fiestas acaba siendo cosmológicamente...

Una historia nunca está completa sin los espacios vacíos entre las imágenes. Segundo y último teaser-trailer de El cosmonauta, el proyecto de largometraje nacido en Internet que va a comenzar el rodaje en breve y en el que cada vez somos...

Un trailer de Tron Uprising, una miniserie de diez episodios de animación que Disney emitirá el año que viene. No se ve nada mal. La acción se sitúa entre las dos películas (Tron y Tron: Legacy) con la rebelión en la...
Hoy he estado junto con algunos colegas blogueros en Torrespaña viendo la nueva versión de RTVE.es a la carta, una web de Televisión Española que ha sido completamente renovada y desde donde se puede acceder al archivo histórico de programas de...
TRON The Next Day - Flynn Lives Revealed (TR3N... por daftworld Ojo, spoilercillos: The Next Day es un vídeo que forma parte de los extras de la edición en Blu-ray de TRON: Legacy en el que durante unos diez minutos se desvelan...
Super 8 = Encuentros en la tercera fase + niños a lo E.T., lo cual combinado con la química en la producción/dirección de Steven Spielberg + J.J. Lost Abrams… puede resultar en algo totalmente explosivo este verano cuando se estrene. (Vía...

Tick, Tock es un curioso cortometraje de esos que nos gustan por aquí, escrito y dirigido Ien Chi y un amplio grupo de estudiantes con una Canon 5D Mark II y un objetivo 24-70mm montado en una steadycam Merlin. La película...
+ The Tron Lebowski existe como dos versiones al menos: la de College Humor y la de Rated Awesome. Son los trailers de lo que sería el crossover definitivo de la historia del cine... ¡Qué digo un crossover! ¡Un clásico instantáneo!...
(…) La emocionante aventura de un grupo de jóvenes con pocas perspectivas de futuro a los que se les presenta la gran oportunidad: cambiar su suerte y disfrutar de una aventura que se convertirá en un modo de vida absolutamente a contracorriente,...
Ed Pegg recopiló en The Legacy of TRON, dentro de su blog en Wolfram.com, algunos de los detalles más ultra-geeks de Tron: Legacy que tan solo pueden ser apreciados después de ver la película dos, tres o n veces. Entre ellos está...
Los simpáticos conejitos ¡¡¡daaaaaah!!! de Ubisoft viajan en el tiempo, y aunque no con la elegancia de un DeLorean sino con una lavadora, para el caso les hace el apaño… El resultado, como dicen en Trecool que es donde lo encontré,...

Thor es la próxima de superhéroes Marvel que llegará a los cines el próximo mes de mayo. Prometedor el trailer, con detalles de fino humor como el «momento Táser» y un poquito de fotofacebook....
A buen entendedor… (Vía Pixel y Dixel)....

Prometedora la historia de la precuela de la última película de la saga de nuestros mutantes favoritas, X-Men: First Class, que se estrenará en junio. Y es que eso de explicar por enésima el origen de los superhéroes vez buscándole las...

En la foto, Dirk Benedict (Starbuck en Galáctica, 1978) y Katee Sackhoff (Starbuck en Galáctica: estrella de combate; 2004), tomándose un cafetito en un Starbucks. Es decir, Starbucks en un Starbucks. (Nos lo envió Holden de Entre machacas y becarios [Actualización:...
Tal y como nos temíamos, el PP y el PSOE han pactado esta misma tarde, casi en el último momento, una nueva versión de la Ley Sinde que será aprobada en el Senado sin ningún problema, ya sea mediante la abstención del...
Los interesados en la ciencia, el universo y los maravillosos misterios de la física encontrarán interesante hacerse con los DVD de El universo de Stephen Hawking, una miniserie documental de la PBS en tres partes que tiene al eminente físico como estrella....
Hey… esto… mola, tío.– El Nota Algunas tomas de Jeff Bridges: The Dude Abides («El Nota Perdura»), un documental de la PBS norteamericana dedicado al actor que encarna a El Nota en una de las mejores interpretaciones de las películas de...
Si la Guerra de las Galaxias hubiera tenido lugar en universo que se rigiera por las leyes físicas del UniversoReal™ además de batallas espaciales en las que las explosiones no producirían ruido, el destino de Endor podría haber sido muy otro...
Televisión Española estrena mañana a las 13:40 Maravillas del sistema solar, una de las mejores series que he visto en los últimos años: Ver vídeo: Wonders of the Solar System - Trailer - BBC TwoWonders of the Solar System - Trailer -...
Estos días, entre copita de champán y pedacito de turrón, Luis Alfonso Gámez y José A. Pérez andan dando los últimos toques al programa piloto de Escépticos, un programa que a juzgar por lo que se puede ver en la promo, hace...

La máquina de copiar jamones, de Flinn Sorrow, es un divertido cortometraje que muestra lo que sucedería en el mundo si existiera una máquina capaz de copiar alimentos, en este caso jamones de buen muy ver. Con apariciones estelares de Nikola...
Scott Pilgrim contra el mundo (Scott Pilgrim vs. the World) de Edgar Wright. Con Michael Cera y Mary Elizabeth Winstead. Página oficial del cómic: Scott Pilgrim, de Bryan Lee O'Malley. Había escuchado algo sobre Scott Pilgrim pero como no ando muy...
TRON: Legacy de Joseph Kosinski. Con Jeff Bridges, Garrett Hediund, Olivia Wilde y Bruce Boxleitner. Web oficial: Tron Legacy. Hay que verla. La secuela de Tron, la tercera mejor película geek de la historia según nuestros lectores, es de visita obligada...

Probablemente nunca tendremos confirmación oficial de ello, pero hay rumores que aseguran que cuando Daft Punk presentó a la Disney la banda sonora para Tron: Legacy a los responsables del estudio no les pareció demasiado adecuada y que les pidieron una...

Falta una semana para que se estrene Tron: Legacy, una de las películas a las que más ganas le tenemos de los últimos tiempos. Para ir haciendo más llevadera la espera, te proponemos este vídeo de uno de los temas compuestos...
Una tienda de motos a medida de Florida construye y vende, por unos 55.000 dólares, una motocicleta basada en las que aparecen en la película Tron: Legacy. La moza de la foto está ahí como referencia del tamaño de la moto,...
Por Nacho Palou -
30 NOV 2010

Como alguien a quien la combinación de caballos y naves espaciales en Firefly y luego Serenity le pareció una gran idea, Vaqueros y alienígenas, la película que se basa en el cómic del mismo título, parece una cita obligada. Además, sale...
Imagen: BBC.co.uk / Sarah Mines. La imagen muestra otra forma de extender la imagen de vídeo más allá de la pantalla. Resulta bastante más simple gracias al uso de un proyector, pero básicamente trata de lograr el mismo efecto: que el espectador...
Por Nacho Palou -
26 NOV 2010
Otra peli de ¡santo cielo, invaden nuestro planeta! para que nos vayamos preparando; se llama Battle: Los Angeles y se estrenará en marzo. (Vía Uruloki)...
La semana pasada Apple presentó su nuevo Apple TV (119 euros) y comenzó a ofrecer películas en alquiler y venta a través de iTunes, lo que es parte esencial del nuevo Apple TV. El nuevo Apple TV poco tiene que ver...
Por Nacho Palou -
19 NOV 2010
Aunque arriesgada, la apuesta de la Xunta de Galicia por Conexións, un programa de divulgación sobre los últimos avances en el conocimiento, la tecnología, la investigación y la innovación en Galicia cuya primera temporada se comenzó a emitir el pasado mes de...
Malos. Los de Disney son muy malos, porque en cada nuevo trailer de Tron: Legacy apenas nos revelan unos mínimos detalles más de la secuela de Tron, una de nuestras películas favoritas de todos los tiempos, secuela que podremos ver a...

Para ver a oscuras, en el modo HD y volumen a tope… ¡Ah, si sólo consiguieran un nivel de emoción en las carreras al estilo del Speed Racer de los Wachowski! En fin, que la cosa sigue prometiendo. Quedan 50 días,...
Exclusive Tron Legacy Concept Art recopila unas cuantas imágenes para ir abriendo boca ahora que el estreno internacional de Tron Legacy está a unas pocas semanas vista. Como bonus, uno de los carteles oficiales: Todo un homenaje al original. Tron: Legacy...
¿Por qué sus padres no reconocen a Marty, su propio hijo, si los presentó en la fiesta de graduación? ¿Por qué Doc no fabrica gasolina en 1885 para mover la máquina del tiempo? ¿Por qué hay dos Delorean en Regreso al...
Ya lo dijimos en su momento cuando salió para el iPad: VLC Media Player apenas tiene botones y es la caña. Ahora la recién publicada versión 1.1.0 de VLC es también compatible con el iPhone 3GS, 4, e iPod Touch recientes, y...
Los legos en la materia nos despertamos ayer con la alegría de los primeros titulares que aseguraban que el tribunal de Justicia de la Unión Europea había declarado ilegal el canon digital que se aplica en España a dispositivos electrónicos y soportes...
Lo estábamos esperando desde mayo de este año, cuando Verica Trstenjak, Abogado General de la Unión Europea, emitió una opinión que decía literalmente que «el canon por copia privada sólo puede gravar los equipos, aparatos y materiales de reproducción digital que presumiblemente...
¡Pedazo homenaje! (Vía Gizmodo... from the future.)...
Star Trek vs. Star Wars No hay mucha información acerca de esta ilustración, que parecen ser naves de los dos respectivos universos renderizadas a la misma escala para ver quién las tiene más grandes, pero siempre se puede recurrir a Starship Dimensions...

El pasado fin de semana tuve la oportunidad de participar, invitado por Disney, en el Tron Legacy Bloggers Day, celebrado en las instalaciones de Digital Domain, donde trabajan a todo gas para terminar la secuela de Tron, una de nuestras películas favoritas...
¡El sueño de todo friki hecho realidad! ¿Quién no pagaría por ver esto? Aunque, la verdad, todos sabemos que los tripulantes del Enterprise tienen una ligera ventaja… § Geeks Are Sexy...
Starring the Computer es una detallada lista de películas y episodios de series de televisión en los que aparecen todo tipo de ordenadores. No es que todos tengan un papel protagonista (son más bien also starring) pero lo interesante es que...
VLC Media Player para iPad. Apenas tiene botones y es la caña....
Transformers de repey815 en Vimeo. Más corta, más barata, menos aburrida y sin rastro de Megan Fox, este corto de Transformes es mucho mejor que el largometraje de Michael Bay y su secuela juntas. Está supuestamente grabado con cámaras réflex baratas con...
Por Nacho Palou -
20 SEP 2010
Misfits, creada por Howard Ovrman. Dirigida por Tom Gren y Tom harper. Con Iwan Rheon, Robert Sheehan, Lauren Socha, Nathan Stewart-Jarrett y Antonia Thomas. E4. Cinco jóvenes condenados a realizar servicios sociales por distintos motivos están trabajando un día cuando se...

Vejado en el tiempo es un corto de Raúl Navarro que te gustará si te gustan las cosas locas que publicamos por aquí a veces, o si te gustó Atrapado en el tiempo (a.k.a. El día de la marmota)....
En una época en la que estamos ya acostumbrados a que los ordenadores, convenientemente manejados por los especialistas actuales en efectos especiales, hagan todo tipo de maravillas, es encantador ver a Douglas Trumbull contar en Blade Runner: Hades Landscape cómo se...
La Weekend Trek de este año se celebrará del 1 al 3 de octubre en Pinto (Madrid). Los invitados son Connor Trinneer (Trip Tucker) y Dominic Keating (Malcolm Reed) de Enterprise y Garrick Hagon (Rojo 3 en Star Wars). En la web...
Strike Back, dirigida por Daniel Percival y Edward Hall. Con Richard Armitage, Andrew Lincoln, Orla Brady, Shelley Conn, Colin Salmon y Jodhi May. Sky1. La noche anterior a que diera comienzo la invasión de Irak en 2003 John Porter, al mando...
La mítica película de terror La noche de los muertos vivientes (1968), del director George A. Romero, pertenece al dominio público. Pero no por deseo de sus propietarios ni porque hayan pasado décadas desde su lanzamiento y los derechos hayan caducado... Es...

Este precioso homenaje a Blade Runner es de esos para disfrutar con la luz apagada, volumen a tope y alta definición (basta hacer clic en el icono HD para ir a Vimeo y allí elegir el icono de pantalla completa.) Se...
Las vidas posibles de Mr. Nobody de Jaco Van Dormael. Con Jared Leto, Diane Kruger. Web oficial: Mr. Nobody. Tal y como directamente spoilea la traducción del título original al castellano, esta película narra la vida(s) de Mr. Nobody, un anciano...

The Pacific, dirigida por Carl Franklin, Tim Van Patten, Jeremy Podeswa, Tony To y David Nutter. Con James Badge Dale, Jon Seda y Joe Mazzello. HBO. {Ojo con los enlaces de esta reseña, pueden contener algún pequeño spoiler} Precedida por grandes...
Origen (Inception) de Cristopher Nolan. Con Leonardo Di Caprio, Ellen Page y Cillian Murphy. Importante: Todo lo que se puede decir de esta película sería spoiler, así que si no la has visto mejor no sigas leyendo. Dado que es un...
Persons Unknow, de or Christopher McQuarrie / Televisa + Fox TV para NBC. Con Alan Ruck, Daisy Betts. A falta de Lost buena es una serie sobre siete personas observadas por «otros» en un muy extraño lugar al que no saben...
Sherlock , de Steven Moffat y Mark Gatiss. Con Benedict Cumberbatch y Martin Freeman. BBC One. El Doctor Watson tiene un blog. Y Sherlock Holmes publica una página web sobre sus métodos deductivos. «Joder, cómo ha cambiado el cuento». Esta microserie...
The I.T. Crowd, cuarta temporada. Chris O’Dowd, Richard Ayoade, Katherine Parkinson y Matt Berry. Channel 4. Con media docena de episodios de la cuarta entrega de nuestros «informáticos favoritos», The I.T. Crowd sigue mejorando a medida que madura: en esta nueva...

… llega el póster de Olivia Wilde, a.k.a. «13» en House, que también sale en la peli como ya vimos en el segundo trailer. Actualización (29 de julio de 2010): Y algo más en el tercero. (¡Gracias, tokafondo!)...
Polchinski, que nos envió su creador Jaime Herrero –que bien sabe lo que nos gusta– es un corto de ciencia-ficción grabado con webcam para el LifeCam Shorts Film Festival. Una simpática historia sobre cómo podría ser el primer experimento de viaje...

En Likeme Daily han publicado una de esas interesantes listas que por aquí tanto nos gustan titulada 10 Under-Appreciated Sci-Fi Movies: recopila grandes películas de ciencia ficción que pasaron desapercibidas en su día, no fueron un éxito de taquilla pero que...
Ya está a punto de llegar a los cines españoles Inception, aquí rebautizada como Origen, de Cristopher Nolan (director de algunas de nuestras favoritas como Memento y Batman: El Caballero Oscuro), la que dice que es «una de sus películas más...
Pioneer One.Un proyecto de Josh Bernhard y Bracey Smith. Con James Rich, Alexandra Blatt, Matthew Foster. Web oficial: PioneerOne.tv. Esta serie independiente es uno de esos proyectos simpáticos, arriesgados y dignos de disfrutar y expicar para que más gente los conozca....
Panel de control de desplazamiento temporal del Outa Time Hoy es el día al que la máquina del tiempo del Dr. Emmet Brown estaba programada para viajar en Regreso al futuro hasta que Marty cambió la fecha de destino liando un poco...
El Águila 4 de Espacio 1999 por Bill George A medio camino entre el frikismo de la ciencia ficción y el aerotrastorno, el sitio Sci-Fi Airshow de Bill George está montado como si algunas de las más populares naves del género hubieran...
Wonders of the Solar System BBC 2010. Presentada por Brian Cox. El Profesor Brian Cox, además de trabajar en el Gran Colisionador de Hadrones, uno de los sitios más increíbles en la actualidad para un físico, se ha pasado varios meses...
Creo que es artificial… De la mejor calidad, un producto superior… Sí, aquí está el número de serie…– Blade Runner (1982) Craig Venter y su equipo han incluido una especie de mensaje secreto, «huevo de pascua» o marca de agua en la...
Pulp Fiction Chronological Sequence permite entender cuándo sucede todo en Pulp Fiction (Quentin Tarantino, 1994), esa piedra angular del cine de los 90. Alternativamente, tampoco está mal ver esta película de Disney diez o quince veces revisándola con lupa hasta captar...

Encontré en la colección de X-Ray Delta One esta interesante foto del decorado centrífugo de la película 2001: Una odisea del espacio (Stanley Kubrick, 1968). Efectivamente, tal y como parece cuando se ve en la película la escena del astronauta haciendo...
Tan viejuno como intrigante: más o menos la mitad de las películas no superan la llamada prueba de Betchdel, que consiste en fijarse en tres detalles de la película en cuestión: (1) si aparecen al menos dos mujeres que (2) hablan la...
Con 13,5 millones de espectadores y cerca de un 9 por ciento de cuota de pantalla se puede decir que millones de telespectadores vieron el final de Perdidos en Estados Unidos… Pero nada que ver con los grandes «finales» de la historia...
La fuerza es poderosa en estos elementos... La tabla de los elementos que hicieron de la película El Imperio Contraataca (Star Wars: Episode V, The Empire Strikes Back) un clásico – en estas fechas en las que se cumplen 30 años desde...
Por Nacho Palou -
24 MAY 2010
El fin de semana pasado tuvimos ocasión de probar los nuevos televisores 3D de LG que se presentaron en Barcelona, donde acudimos invitados por la marca. El modelo presentado, el LX9500 Infinia 3D, utiliza gafas activas para lograr el efecto 3D....
Por Nacho Palou -
12 MAY 2010
Difícil será que a algún lector de Microsiervos le sorprendan a estas alturas todas las 15 cosas que probablemente no sabías sobre Star Trek, pero incluso a mi me sorprendieron tres de ellas. Entre mis favoritas de todos los tiempos está...

El próximo domingo 9 de mayo a las 15:20 la Televisión de Galicia estrena Conexións, un programa de divulgación sobre los últimos avances en el conocimiento, la tecnología, la investigación y la innovación en Galicia producido por Adivina Producciones. Yo tengo...
Los hombres que miraban fijamente a las cabras (The Men Who Stare at Goats, 2009). Dirigida por Grant Heslov. Con George Clooney, Ewan McGregor, Jeff Bridges y Kevin Spacey. Web oficial: TheMenWhoStareAtGoatsMovie.com. No es El Gran Lebowski, pero podría haberlo sido....
Si no puedes hacerlo bueno hazlo 3DOtro puyazo al 3D y a la patética excusa que a menudo representa (yay!everyday vía Un mundo libre)....
Entrañable película/anuncio «con mensaje» creada para la WWF por la agencia Leo Burnett. La música es de Ben Lee: Song for the Divine Mother of the Universe. No sabía si meterlo en el área de Ecología por el triste aniversario de...
N.Konstantinov y un grupo de matemáticos utilizaron la técnica de stop-motion para generar Kitten, esta película de animación con un gato como protagonista que probablemente sea una de las primeras de la historia en que participó un ordenador. No está claro...
Camiseta My Other Ride Is a Light Cycle, inspirada en los trajes utilizados en la película Tron. Incluso como en éstos, los circuitos brillan en la oscuridad. § DVICE....
Por Nacho Palou -
20 ABR 2010

Aprovechando que han vuelto los episodios de V (la versión remake de 2009/10) me pasaron este vídeo del blog de TNT, que es la cadena que emite la serie en España; todavía me estoy partiendo de la risa con las declaraciones...
O al menos de aquellos que son aficionados a las películas / series que aparecen en la tabla Sci-Fi Superfan Reference Manual –– en la cual sobraría Lost que no está a la altura del resto ni por asomo si no...
Por Nacho Palou -
7 ABR 2010
El 21 de mayo de 2010 se cumple el 30º aniversario del estreno de El imperio contraataca, para muchos fans la mejor de las películas de la saga de Star Wars. Aprovechando esta fecha, se está organizando en Santiago de Compostela...

The Road (La Carretera). Dirigida por John Hillcoat. Viggo Mortensen, Kodi Smit-McPhee, Charlize Theron, Robert Duvall, Guy Pearce. Web oficial: The Road. Ambientada en un futuro cercano y apocalíptico, La carretera muestra un futuro tan distópico como deprimente: un evento estilo...
Numerosos abogados llevan años diciéndolo, y muchos sin tener ni idea de leyes no entendíamos que se pudiera pensar otra cosa. Tampoco es ni con mucho la primera en este sentido, pero la sentencia [PDF 262 KB] en la que D. Raúl...

Con todos los respetos que impone siempre revisitar un clásico, la espera para ver su secuela hasta diciembre de este año se va a hacer larga. (Vía Clipset). Relacionado: Tron, película geek Top #3 para los lectores de Microsiervos. Publicado el...
Children of Earth. Escrita por Russell T Davies, John Fay y James Moran. Dirigida por Euros Lyn. Un día a primera hora de la mañana en el Reino Unido todos los niños se quedan quietos de repente, sin hacer caso a...
Caprica. Creada por Remi Aubuchon, Ronald D. Moore y David Eick. Si no has tenido suficiente con la versión de Galáctica de 2003, Caprica te permite regresar al mismo universo 58 años antes de los hechos relatados en esa serie. La...

Si te gustó la magnífica Hermanos de sangre, apúntate ver The Pacific, que estrena la HBO el próximo 14 de marzo en los Estados Unidos y al día siguiente en Canal + en España: Cuenta la historia de los marines Robert...
Todos hemos tenido que sufrir los trailers y diversos avisos que no hay manera de saltarse en los DVD que compramos porque los estudios deciden lo que podemos y no podemos hacer con nuestros discos: Así que como dice este gráfico, que...
En Cuatro hicieron una promo de la sexta y supuestamente última temporada de Lost tan buena que hasta el propio Carlton Cuse, uno de los creadores de la serie, retuiteó el mensaje en el que le pasaban el enlace. En este vídeo...
Tenía por ahí medio olvidado el enlace a esta galería en la que se puede ver la colección de cromos chulísimos y totalmente retro en la que se basa la genial película Mars Attacks de Tim Burton: Mars Attacks! por Bubbles, Inc....
Si te perdiste ayer el estreno de la sexta temporada de la serie Lost (Perdidos) -o si quieres volver a verlo, por ejemplo en versión original- los dos primeros episodios están en la web de Play Cuatro, junto con algunos extras...
Por Nacho Palou -
10 FEB 2010

Este es el primer teaser-trailer de El cosmonauta, el proyecto de largometraje nacido en Internet que semana a semana sigue avanzando y en el que cada vez somos más los productores (1.500+ en el momento de esribir esto). La fórmula de...
Mientras dure en YouTube, y ojo que contiene spoilers si no has visto hasta el final de la quinta temporada, estos son los cuatro primeros minutos de la sexta y última temporada de la serie, marcas de agua incluídas: Ver vídeo: lost...
Tenía por ahí guardado este viejo vídeo comentado en ALT1040 que muestra las diferencias de los últimos minutos de la primera y segunda partes de Regreso al futuro. A pesar de haberlas visto decenas de veces no conocía este gran detalle:...

Avatar (3-D, 2009). Dirigida por James Cameron. Sam Worthington, Sigourney Weaver, Michelle Rodriguez, Stephen Lang, Zoe Saldana. Avatar = Pocahontas + Aliens + Batalla de Kashyyyk + elfos azules de tres metros + Sigourney Weaver - demasiada «espiritualidad» + Ana Lucía...
Stargate Universe (2009). Creada por Brad Wright y Robert C. Cooper. En algún momento posterior a los hechos relatados en Stargate SG-1 y Stargate Atlantis el Comando Stargate ha localizado una puerta estelar en el planeta Icarus que tiene la peculiaridad...
Dentro de poco más de cien días se producirá en España el último paso del apagón analógico, tras el cual cesarán las transmisiones de televisión «de toda la vida», que a partir de entonces solo podrá ser vista a través de la...
Bueno, en realidad se trata más bien de un contrato que ha firmado Fede Álvarez, el director de Ataque de Pánico! con Ghost House Pictures para hacer una película con un presupuesto de 30 millones de dólares, según cuentan en Gizmodo. Ataque...

Genial crossover: – Ya sé que suena raro eso de que un extraño vaya dejando cajas envueltas en papel de regalo por las casas, pero…– ¡Quiero… LOS NOMBRES! Una gran ocurrencia de The Rebel Viral Team, que me encontré vía el...
La gente de Multitouch Barcelona creó este simpático vídeo sobre lo que sucede entre bastidores en el interior de nuestros queridos ordenadores… una especie de «interfaz humana» llamada Hi, de lo más curiosa y divertida. (Vía CyberHades.)...
Solaris. Dirigida por Andrei Tarkovsky (1972). Con Natalya Bondarchuk, Donatas Banionis, Jüri Järvet, Vladislav Dvorzhetsky, Nikolai Grinko y Anatoly Solonitsyn. Años después del descubrimiento del planeta bautizado Solaris su estudio, la solarística, parece no haber avanzado apenas nada, y de hecho...
The Darwin Awards: Muertes de risa. Dirigida por Finn Taylor (2006). Con Joseph Fiennes y Winona Ryder. Esta curiosa peli de hace unos años está graciosa y entretenida y tiene como tema central a nuestros admirados Premios Darwin; esas menciones que…...
Spamalot, el musical por El Tricicle. Teatro Lope de Vega de Madrid. Muy entretenido el musical que la gente de El Tricicle ha montado adaptando el original que a su vez está basado en Los caballeros de la mesa cuadrada y...
Exergian es un estudio de diseño que ha creado una serie de carteles reducidos a la mínima expresión que representan series bastante conocidas, como este, al que le he quitado el nombre para ponéroslo un poco más difícil (la solución está...
Trauma (2009). Creada por Dario Scardapane y Peter Noah. Dirigida por Jeff Reiner. Centrada en las andanzas de varios equipos de paramédicos de la ciudad de San Francisco que van de un lugar a otro salvando vidas, a menudo jugándose el...
Ágora. Dirigida por Alejandro Amenábar (2009). Con Rachel Weisz y Max Minghella. Web oficial: Ágora, la película. Por fin pude ver Ágora, y me gustó bastante. Había intentado no leer ni oír demasiadas reseñas para no ir al cine condicionado, y...
Harald Kraft se curró The Big Bang Theory Intro Frame by Frame extrayendo los 109 fotogramas de la secuencia ultrarrápida de la cabecera de The Big Bang Theory e intentando completar las imágenes con datos sobre lo que muestran. Como dice...
Creo que la razón por la que existen las historias y los libros es porque permiten a alguien venir y secuestrar tu «voz interior» durante un rato, de modo que no tienes que hacer ningún trabajo mental. Desde la iTunes Store...
Hubble's amazing rescue. PBS/Nova 2009. Una de las discusiones más recurrentes en el campo de la investigación es el de si es conveniente o tan siquiera necesario enviar seres humanos al espacio, en especial teniendo en cuenta los resultados espectaculares que...
¡Ajá!, tal y como me imaginaba no hay más que hacer un par de búsquedas rápidas en Internet para comprobar que no es cierto que en el calendario maya –y que se sepa en ningún otro– el 21 de diciembre de 2012...
Por Nacho Palou -
13 NOV 2009
Nos habían avisado. Hoy 13 de noviembre se estrena en casi todo el mundo 2012, la esperada película sobre el fin del mundo -o algo parecido- de Roland Emmerich. Gran día para los aficionados a las películas de mega-catástrofes, porque a...

Primer trailer de Clash of the Titans, todo un remake del clásico, que así a simple vista y por su estética parece que será reconvertido en una combinación de 300 + El Señor de los Anillos + Troya. A disfrutarlo a...
¿Pero cómo voy a distinguir la pastilla roja de la pastilla azul? Una simpática parodia de The Matrix intepretada por el grupo de actores rusos Big Difference (Bolshaya Raznitsa), con Chaplin como Neo, algo de bullet time pero con tartas y...

Un chulísimo corto de bajo presupuesto -300 dólares, seis personas y seis meses de trabajo- dirigido por Fede Álvarez Mirate en el que unos robots gigantes atacan Montevideo acompañados de una multitud de naves triangulares. (Motinographer vía El mundo según Sanjuán)....
La mini-serie original de tres capítulos que dio lugar a la serie V –cuyo remake se ha estrenado estos días– se puede ver completa y con el doblaje a español en YouTube, en cómodas porciones de 10 minutos (quince partes) –enlazadas...
Por Nacho Palou -
5 NOV 2009
Venimos en son de paz. Siempre. V (2009). Prometedor comienzo el de V, un remake de la miniserie de los 80 con aquellos lagartos que nos conmocionaron sobremanera, malos malísimos pero de verdad, y una «resistencia» digna de toda serie de...
Los hombres que no amaban a las mujeres (Män som hatar kvinnor, 2009). Dirigida por Niels Arden Oplev. Michael Nyqvist, Noomi Rapace, Peter Haber. No voy a hablar aquí del argumento de la película, pues en su momento ya reseñé la...
Actividad paranormal (Paranormal Activity, 2007). Dirigida por Oren Peli. Rodada a modo de falso documental en una semana y con 15.000 dólares, recaudó 9 millones de dólares nada más llegar a las salas grandes, lo cual tiene su mérito. La historia...
Battlestar Galactica: The Plan (2009). Dirigida por Edward James Olmos. Battlestar Galactica ya acabó, pero antes de continuar con la precuela Caprica, -cuyo primer gran piloto se filtró hace tiempo- sus creadores han decidido reunir de nuevo a los personajes y...
Surrogates (Los substitutos, 2009). Dirigida por Jonathan Mostow. Bruce Willis, Rhada Mitchell, James Cromwell.. Entretenida película para pasar la tarde, que muestra un mundo en el que los androides controlados a distancia han reemplazado a las personas en la vida real....
Los fans pretenden recrear Star Wars en Star Wars Uncut. La idea es recortar la película en 472 trozos de 15 segundos, y que cada cual grabe uno, en el estilo que prefiera: con actores, muñecos, dibujos animados… De momento quedan...
Moon (2009). Dirigida por Duncan Jones. Sam Rockwell, Kevin Spacey (como la voz de GERTY). Web oficial: Moon. Esta es la intrigante aventura de un astronauta enviado a una base en la Luna con un contrato de tres años para extraer...
Stargate: Continuum. Dirigida por marting Wood. Con Ben Browder, Amanda Tapping, Christopher Judge, Michael Shanks, Beau Bridges, Claudia Black, Richard Dean Anderson, Cliff Simon y Don S. Davis. Ojo, esta reseña contiene spoilers de Stargate SG-1 y Stargate: The ark of...
The Time Traveler’s Wife (2009). Dirigida por Robert Schwentke. Eric Bana, Michelle Nolden, Ron Livingston. Web oficial: The Time Traveler’s Wife. La mujer del viajero en el tiempo se tradujo en algunos sitios por Te amaré para siempre. Inadecuado pero por...
Ahí van algunas curiosidades sobre el número 137, con el que los de Flash Forward nos van a vacilar más que los de Lost con los maquiavélicos números chungos. 137 segundos es el tiempo durante el cual la gente pierde el conocimiento...
Nos avisaron de que un año más el club de Star Wars en Sevilla, Holored Estelar está organizando las IV Jornadas y Exposición sobre Star Wars. Tendrá lugar el fin de semana del 10 y 11 de octubre en el Centro Civico...
Las creamos cuidadosamente, les dimos nuestra inteligencia, nuestro aprecio, les confiamos nuestros secretos y entonces… se volvieron contra nosotros. Cuando las máquinas se vuelven “rebotonas” es un artículo del siempre genial PixFans donde se narran algunas de las historias más tremendas...
Hoy por la noche el canal AXN estrena la serie Flash Forward en España (22:25 horas, hora peninsular). Puedes leer algo sobre la serie (ojo, posibles spoilers) en la mini-reseña de Alvy, Flash Forward y en TVlia. Además, Flash Forward es...
Por Nacho Palou -
5 OCT 2009
Flash Forward (2009). Ceada por Brannon Braga, David S. Goyer y Robert J. Sawyer (autor de la novela). Esta prometedora serie puede ser la bomba de la temporada. Tanto el piloto como el segundo episodio ya te dejan totalmente enganchado a...
El WeekendTrek tendrá lugar este fin de semana del 2, 3 y 4 de octubre en Fuenlabrada, Madrid. Este año como estrella invitada vendrá Robert O’Reilly, más conocido entre los trekkers como el Canciller Klingon Gowron. La WeekendTrek es un evento...
Un auto de la Audiencia Provincial de Murcia ordena reabrir de nuevo el caso contra el sitio de intercambio de enlaces P2P Elitedivx, a instancias de un recurso de la acusación ante el auto de sobreseimiento dictado en el verano de 2008...

Desde Den of Geek, La historia de la Nostromo, narrada por el mismísimo Ron Cobb, uno de los más famosos diseñadores de la ciencia-ficción, en cuya creación también participó Chris Foss....
Al escribir sobre el canon digital que se paga en España por soportes y dispositivos capaces de almacenar información en formato digital, así como por impresoras y copiadoras, hemos dicho que uno de sus grandes problemas es que se aplica a todo...
Tal y como augurábamos hace unos días el gobierno francés ha conseguido aprobar finalmente en ambas cámaras una nueva ley contra las descargas a través de Internet, conocida como Hadopi 2, en la que para sortear la declaración de inconstitucionalidad que tumbó...

Frequently Asked Questions About Time Travel. Dirigida por Gareth Carrivick. Con Chris O’Dowd, Marc Wootton, Dean Lennox Kelly y Anna Faris. Esta humilde producción es una ingeniosísima vuelta de tuerca a las clásicas películas de viajes en el tiempo, con el...
Defying Gravity. Dirigida por David Straiton y Peter Howitt. 2009. En el año 2052 la Organización Espacial Internacional envía la nave Antares, tripulada por cuatro hombres y cuatro mujeres, en un viaje de seis años de duración a lo largo y...
Después de intercambiar unos cuantos correos con Fer, uno de nuestros lectores, descubrí en su galería de Flickr una foto de un recortable de un Águila de Espacio: 1999. Space 1999 por Fer Al preguntarle de dónde había sacado el modelo me...
Ya que no estábamos por aquí para dar la noticia de la llegada de la televisión, nos alegramos de poder anunciar la puesta en marcha de Telebisión, un programa pasado en XBMC para gestionar y visualizar en el televisor contenidos de...
Por Nacho Palou -
17 SEP 2009
In praise of the sci-fi corridor de Den of Geek tiene una estupenda recopilación de cómo son los corredores de muchas naves espaciales y un sinfín de detalles sobre algunos de ellos, incluyendo su curvatura o las tipografías utilizadas en los...
Preciosa peliculita publicitaria en el que el mundo que rodea al protagonista es, literalmente, de papel. (Vía Fubiz.)...
District 9. Dirigida por Neill Blomkamp. Sharlto Copley. Web oficial: Distrito 9. Las grandes expectativas que tenía para esta película producida por Peter Jackson tras ver el trailer se han visto sobradamente cumplidas. District 9 trata el primer contacto con una...
Virtuality. Dirigida por Peter Berg. 2009. A mediados del siglo XXI el Phaeton, la primera nave espacial interestelar de la humanidad, con una tripulación de doce hombres y mujeres, parte rumbo a Épsilon Eridani en una misión de exploración con una...
Aunque el 29 de Marzo de 2006 el Juzgado de Instrucción nº8 de Alicante había acordado el sobreseimiento libre y archivo de las actuaciones contra Naiadadonkey.com al final esa resolución fue anulada al determinarse que el tribunal en cuestión no era competente,...
Sunshine (Alerta solar). Dirigida por Danny Boyle. Cillian Murphy, Cliff Curtis, Rose Byrne. 2007. Ambientada en un futuro relavitamente cercano, Sunshine es la aventura de unos astronautas enviados en una misión descisiva para el futuro de la raza humana: revivir el...
Mientras la junta extraordinaria de accionistas de Global Gaming Factory X aprobaba la compra de The Pirate Bay con la idea de convertirlo en un sitio de pago, suponiendo, eso sí, que consigan la financiación necesaria y que la investigación a la...
Ver vídeo: Visual Effects: 100 Years of InspirationVisual Effects: 100 Years of Inspiration [YouTube 5:06] Desde The Enchanted Drawing (ver en YouTube), el corto que se considera la primera película de animación producida en los Estados Unidos, hasta El curioso caso de...
Time travel in popular film and tv por David McCandless, Dominic Busby y Alice Cho [clic para ver la imagen entera] Con la cantidad de series de televisión y películas que incluyen viajes en el tiempo no es de extrañar que terminar...
Knowing (Señales del futuro). Dirigida por Alex Proyas. Nicolas Cage, Rose Byrne. 2009. Excelente película para quienes gusten de la ciencia ficción combinada con el misterio, la intriga y un poco de terror. La historia es la de un profesor del...
Desde que empecé a escribir sobre el asunto del apagón analógico en España para dar el paso a la Televisión Digital Terrestre he venido argumentando, entre otras cosas, que se estaba engañando, no me atrevo a decir si intencionadamente o no, a...
El próximo 21 de septiembre se estrena la cuarta temporada de Héroes, que incluye el volumen 5, titulado Redención (la tercera temporada incluyó los volúmenes 3 y 4). En este vídeo se pueden ver casi seis minutos de imágenes correspondientes a esta...
Algunos están a la vuelta de la esquina, al menos por las fechas en que se supone que transcurre la acción. Esta es mi selección personal, ordenada cronológicamente, de diez posibles futuros de ficción con sus ventajas y desventajas: no tengo del...
Up. Dirigida por Peter Docter y Bob Peterson. Después de toda una vida juntos, a la muerte de Ellie su marido Carl se encuentra solo y triste, y cuando está a punto de ser internado en un asilo decide tomar las...
Espectacular secuencia del programa de la BBC Top Gear (que emite en España Discovery Channel) en el que el piloto Ken Block muestra cómo maneja su Subaru Impreza entre aviones en un pequeño y apartado aeropuerto en California. El momento se...
Por Nacho Palou -
6 AGO 2009

Como cualquier geek que se precie, Tron es una de mis películas favoritas de todos los tiempos -aunque confesaré que no he vuelto a verla muchas veces para evitar que la perspectiva que dan los años me haga cambiar de opinión-...
Empieza a ser complicado llevar la cuenta, pero David Bravo informa en Se archivan las actuaciones seguidas contra la web de enlaces a redes p2p etmusica.com de un nuevo caso en el que las acciones legales iniciadas contra un sitio que distribuye...
Filmada casi como un documental, esta producción de 30 millones de dólares de Peter Jackson, dirigida por Neill Blomkamp, cuenta las repercusiones sociales y geo-políticas de una nave extraterrestre que cae sobre Johannesburgo. ¡Tiene muy buena pinta! Me encanta cuando la...
En España ya se han producido unas cuantas sentencias absolutorias en juicios contra sitios que proporcionaban enlaces a archivos de redes P2P como por ejemplo los de Spanishare, Sharemula, o eliteDivX, por citar algunos. El único caso en el que ha habido...
En Frkncngz aparecen de vez en cuando «películas vistas al revés», resúmenes en una frase de los clásicos, como si se vieran proyectados desde el final hasta el principio, como por ejemplo… Si ves Tiburón al revés trata sobre un tiburón que...
Ver vídeo: Sobre RuedasSobre Ruedas [7 min.] Búscate siete minutos tranquilos… Hace cuatro años andaba buscando un impactante cortometraje, del que sólo recordaba el argumento. Un amable lector consiguió localizarlo de manera casi increíble y las casualidades de Internet hicieron que después...
Dan Meth recoge en Futuristic Movie Timeline algunas películas clásicas de ciencia ficción, ordenadas por el año en el que tiene lugar la acción de estas, y además a la izquierda de la línea vertical blanca, que representa el año 2009,...
Darío nos ha pasado un enlace a otra recopilación de cortinillas del programa educativo infantil PythagoraSwitch de la NHK en las que se usan increíbles máquinas de Rube Goldberg: Ver vídeo: The Incredible Machine IIThe Incredible Machine II [4:20 disponible en HQ]...
Sanctuary. Temporada 1, 13 capítulos (existe una versión previa formada por 8 webisodios). En una ciudad sin especificar de los Estados Unidos la doctora Helen Magnus dirige el Santuario con la ayuda de su hija Ashley, de un geek llamado Henry...
Según comentan en Collider, vía ¡Vaya Tele! –a donde llegué vía un RT de @fotomaf, será la cadena Comedy Central la que emitirá los nuevos episodios de la serie Futurama que parece que están haciendo con piedras y palos a juzgar...
Por Nacho Palou -
9 JUN 2009
Réplicas de R2D2 en el WonderCon 2009, foto Chris / Artoo Detoo. Hoy va la cosa de la Guerra de las Galaxias: el R2 Builders Group es un grupo de aficionados que se dedica a fabricar réplicas a escala real del carismático...
Por Nacho Palou -
2 JUN 2009
Esta semana Pablo Soto participó en un encuentro digital en El Mundo en el que respondió a unas cuantas preguntas que le fueron haciendo los internautas sobre el juicio que acaba de protagonizar -involuntariamente, claro está- en el que la industria discográfica...
Stargate: The Ark of Truth. Dirigida por Robert C. Cooper. Con Ben Browder, Amanda Tapping, Christopher Judge, Michael Shanks y Claudia Black. Ojo, esta reseña contiene spoilers de Stargate SG-1, en especial de las temporadas 9 y 10. Tras haber disparado...
Dani nos ha pasado el enlace a este entrañable vídeo en el que una niña de cinco años cuenta como es vivir con su hermano autista. Relacionado: Brain Man en español, un más que recomendable documental sobre Daniel Tammet, una persona...
Esta página fue publicada originalmente La Voz de Galicia, diario en el que nos han fichado como colaboradores para publicar una página sobre tecnología, ordenadores, Internet y esas cosas en la sección de Sociedad. Juicio a las redes P2P,La Voz de Galicia...
StarGate SG-1. 10 temporadas, 214 episodios, de 1997 a 2007. Ojo con los enlaces de esta anotación, alguno puede llevarte a alguna página que contenga algún spoiler de la serie. Un año después de los hechos descritos en la película, justo...
Esta semana nos llegó información sobre la película No-Do, una película de terror dirigida por Elio Quiroga sobre el contenido de los llamados “No-Dos” secretos de los años 40 y 50 del siglo pasado. Aunque la nota era sobre todo información...
Por Nacho Palou -
23 MAY 2009
Este es un pequeño adelanto del remake de V, la serie de marcianos invasores que tanto nos impactó de niños a principios de los 80. Las imágenes son del episodio piloto; la «nueva V» se estrenará en otoño de este año....
Tecnología Obsoleta publicó una completísima anotación sobre la Exégesis de la USS Enterprise, dedicado a la verdadera protagonista de Star Trek y todas las películas y spin-offs de la saga. El encargo en la mente de Gene Roddenberry, el creador de...

Una tan apasionante como arriesgada idea sobre una película multimedia acerca de uno de nuestros temas favoritos: la conquista del espacio.
Este bonito y emotivo vídeo que en apenas 23 tomas y 42 segundos resume la vida de una persona fue filmado para el festival Ondedreamrush, en el que 42 autores fueron invitados a mostrar en 42 segundos los sueños que les...
Hoy a las 11:30 comienza en Madrid el juicio contra Pablo Soto y su empresa MP2P Technologies, que ha publicado herramientas como Piolet, Omemo y Blubster que funcionan con tecnología P2P y que permiten a sus usuarios intercambiar archivos de forma rápida...
Lost, quinta temporada. 17 episodios. Terminó estos días la quinta temporada de Perdidos en Estados Unidos, lo cual hace que queden 248 interminables días más hasta que empiece la sexta y definitiva el año que viene. Esta temporada añade más misterios...
Ángeles y demonios. Dirigida por Ron Howard. Con Tom Hanks, Ayelet Zurer y Ewan McGregor. Entretenida y fácil de ver, la película basada en el Angels & Demons de Dan Brown podría haber dado un poco más de sí, pero es...
Star Trek (2009). Dirigida por J.J. Abrams. Chris Pine (Kirk), Zachary Quinto (Spock), Leonard Nimoy (Spock prime). Siete años han pasado desde la última peli de Star Trek, pero al menos ha merecido la pena. Esta undécima película de la saga,...
¡Unos minutos de frikismo! Star Wars SoundBoard permite trastear con sonidos de la saga de La Guerra de las Galaxia. Se pueden mezclar efectos, voces, frases míticas... Para ir más allá y sacarle provecho, utilizando algún programa como Audio Hijack se...
Por Nacho Palou -
15 MAY 2009
Esta página fue publicada originalmente La Voz de Galicia, diario en el que nos han fichado como colaboradores para publicar una página sobre tecnología, ordenadores, Internet y esas cosas en la sección de Sociedad. ">EE.UU. llama pirata a medio mundo,La Voz de...
Trailer de presentación, mejor en alta resolución (Play Hi-Res) Algo de 2001 con un poco de Solaris y quizás una pizca de Naves misteriosas… Moon tiene pinta de ser una película que habrá que ver, aunque ahora parece que soy yo el...
La Digital Millennium Copyright Act es una ley vigente desde 1998 en los Estados Unidos para protección de los derechos de autor que, entre otras cosas, convierte en un acto criminal la producción y distribución de tecnología, dispositivos, o servicios diseñados para...
No creo que realmente sorprenda a nadie, pero El Ministerio de Industria aplaza sine díe la implantación de la TDT en la zona de Santiago de Compostela y 43 municipios de su área. Por lo visto en el área en cuestión, en...

Encontré estos dos vídeos de The Real Hustle en Geeks are Sexy y me parecieron absolutamente brillantes. Se trata de un programa de la BBC que es algo así como «el Cazadores de Mitos de los timos callejeros». El resultado es absolutamente...
Una ola de cuatro metros de altura en super cámara lenta y grabada en alta definición, términos ambos que nos encantan y más si van combinados: Monster wave gives up its secrets. Procede de un documental de la BBC y en...
Como por ejemplo, ...el co-inventor del USB, Ajay Bhatt. Pedazo «crack». (Vía ALT1040.) Actualización (2013): Como suele suceder con la «magia de la televisión y el marketing» resultó que el protagonista del vídeo no era el sñor Bhatt en persona sino un...
Este listado de formatos de las peliculas de Internet habla de todas esas siglas y nombres que se utilizan en los nombres de archivo que hay en las redes que comparten películas, algo un tanto críptico pero que el artículo aclara con...
Con motivo del estreno el próximo 8 de mayo de Star Trek (XI) Daniel del Club Star Trek de Sevilla nos escribió para contarnos cómo los trekkers van a celebrar allí un día tan especial. Durante varios días habrá en la...

El mundo de las perspectivas engañosas y lo imposible, tan habitual en M.C. Escher, trasladado a un cortometraje de Francisco Gutiérrez de 2003. No lo envió Carlos (¡gracias!) y aunque parezca increíble por lo mucho que nos gusta esa temática, no...
La pertenencia del juez Tomas Norström, que fue quien dictó la sentencia que condenaba a un año de cárcel y a pagar una multa de 2,7 millones de euros a los cuatro responsables de The Pirate Bay, a diferentes grupos que defienden...
Absolutamente genial: Uncomfortable Plot Summaries, de los cuales tradujo algunos La infiltrada: Entre los más hilarantes… Alien: Una nave no entrega su cargamento y la tripulación se queda sin bonus. Batman Un hombre rico ataca a discapacitados mentales. Frankenstein: Los avances científicos...
Battlestar Galáctica, temporada 4,5 (2009). Ronald D. Moore y David Eick. Me metí una sobredosis en un par de días con los más de quince episodios que me quedaban por ver de Battlestar Galactica, para terminar de disfrutar de la que...
Tal y como adelantaba Peter S. Kolmisoppi por Twitter, la sentencia en el juicio que se seguía contra él y los otros tres responsables de The Pirate Bay es condenatoria. El Museo Nacional de Ciencia y Tecnología de Suecia acaba precisamente de...
Ver vídeo: What's in the Box? What's in the Box? [9 min.] {HD} Un cortometraje de Tim Smit, un estudiante holandés, rodado con 3DS Max, After Effects, 150 euros y mucho talento. Hay quien lo toma por un viral, un anuncio de...
En su momento ya comenté que el nombramiento de Ángeles González-Sinde, como ministra de cultura no me parecía muy adecuado por su vinculación a la industria audiovisual, lo que la convertía en juez y parte, pero también comentaba que me gustaría estar...
KuvE, el ex-webmaster de Infopsp, nos escribió para comentarnos que David Bravo había publicado una entrevista con él en la que hablan del caso de InfoPSP y del acuerdo al que llegó para declararse culpable aún cuando todas las sentencias anteriores en...
Me extrañó mucho oír en el telediario hace un par de días que el responsable del sitio Infopsp había sido condenado a un hombre a seis meses de prisión y al pago de una multa de 4.900 euros por lucrarse mediante su...

Una pequeña joya de historia hecha con técnicas stop-motion, mucho cariño e infinita paciencia. (Vía MeFi.)...
Inspiración, empresas, técnicas de sonido, efectos especiales, películas, series, juegos… How Star Wars Changed the World es una impresionante infografía que lo recopila todo en forma de cronología temática. (Vía MeFi.)...
Tal y como aprendimos de Han Solo, las apestosas entrañas de un Tauntaun abierto en canal son un sitio realmente acogedor en las frías noches del planeta Hoth. Por 40 dólares, Tauntaun Sleeping Bag. (Vía Geek are Sexy.)...
Por Nacho Palou -
2 ABR 2009
¿Crees en el destino? ¿Crees que tienes el control de tu vida? ¿Qué es la realidad? Son algunas de las reflexiones que lanza la película a lo largo de sus 130 minutos. Parece que fue ayer, pero The Matrix, una de...
Tras Barcelona 1908 llegan otras imágenes de la Filmoteca Nacional sobre Madrid hacia 1910 (¡gracias Hombrelobo!). Son básicamente de Cibeles, Alcalá, Gran Vía y lo que hoy es el Paseo de la Castellana (que creo que se llamaba de otra forma)...
Star Wars Episode I (izq.) y Big Fish. 50 Brilliantly Photoshopped Movie Posters valora sobre ante todo el trabajo de diseño y la creatividad aplicada al diseño de pósters de películas –aunque hay unas cuantas no están a la altura del cartel....
Por Nacho Palou -
26 MAR 2009

En el canal TCM seleccionaron 50 películas que deberías ver antes de morir, una de esas listas a las que aquí somos adictos. Cada semana emiten una y publican una pequeña reseña y el trailer en su web. De momento llevan...
Al parecer Fred Barton Productions se dedica a crear réplicas robóticas perfectas de los más entrañables –o temibles– engendros mecánicos que ha visto la ciencia ficción: desde el mítico Robby, the Robot de Planeta Prohibido a legendarios androides como C3P0 y...
Este es un breve análisis que me ha pedido La Voz de Galicia sobre las leyes «de tres avisos» que se están implantando o estudiando en distintos países. Dudas razonables a la hora de legislar las descargas en la Red La Voz...
Este vídeo rescatado de la Filmoteca Nacional y titulado Barcelona en Tranvía, de Ricardo Baños está rodado en 1908, hace más de un siglo. Muestra imágenes cotidianas de la ciudad, tomadas por la cámara circulando en tranvía por las calles y...
Creo no desvelo ningún spoiler si cuento esto, pero aviso por si acaso… me pareció humor fino digno de ser mencionado. Resulta que en el episodio 14 de la séptima temporada de 24 uno de los personajes envía información importante utilizando...
Coja su estaca aquí, Póster publicitario de Trueblood, foto de antony8627. Original anuncio de la serie Trueblood de la HBO, que en España creo que se emite –o emitía– como “Sangre fresca”....
Por Nacho Palou -
18 MAR 2009
Desde el sector cinéfilo de las típicas recopilaciones en listas que nos encantan llega 10 Most Egregious Academy Awards Decisions, donde describen diez de las mayores aberraciones, injusticias, atrocidades, esto-clama-al-cielo o como se le quiera llamar que la Academia de las Artes...
Del creador del medidor de trilogías, un curioso análisis dentrífico sobre la distribución de las viviendas en las que se escenifican comedias de situación de los años 70 a 90, Sigue... La única conclusión a la que podemos llegar con estos datos...
Por Nacho Palou -
12 MAR 2009
Esta página salió en la edición del domingo pasado de La Voz de Galicia, diario en el que nos han fichado como colaboradores para publicar una página sobre tecnología, ordenadores, Internet y esas cosas en la sección de Sociedad. Las P2P, en...
Confirmándose aquello de que en Internet hay de tó, llega un enlace en ruso de pósteres de películas como si fueran grabados en madera del siglo XIX, incluyendo algunos clásicos como Matrix, Terminator 2 o la saga Star Wars, entre otras...
Mientras el gobierno francés sigue empeñado en sacar adelante su ley de los tres avisos mediante la que pretende evitar que los usuarios se descarguen contenidos de Internet protegidos por derechos de autor usando redes P2P, el equivalente noruego a Radio Televisión...
World Builder de Bruce Branit es un espectacular corto (en el que un hombre construye un mundo virtual para la mujer a la que ama) que se filmó en un día. Llevó dos años completar los efectos y la post producción....
Por Nacho Palou -
8 MAR 2009
Algunas migajillas más para que los trekkers que llevamos siete años esperando una nueva entrega de la saga tengamos algo que echarnos a la boca: el nuevo trailer ya definitivo de Star Trek (2009), dirigida por J.J. Abrams (Lost, Fringe), que...
Watchmen de Zack Snyder (2009), basada en la novela gráfica de Alan Moore y Dave Gibbons. Ficha en la IMDB: Watchmen. Ninguna reseña haría justicia a esta película. Simplemente, véase veces y luego ya puede uno morir tranquilo. Actualización (7 de...
Hoy se estrena por fin la adaptación al cine de Watchmen, una de las obras maestras del cómic, lo que, como es habitual en estos casos conlleva el nerviosismo de saber si lo apetecible que la hace parecer el trailer se...
Mis admirados Stanislaw Lem y Jorge Luis Borges cultivaron el género de escribir reseñas de libros inexistentes, en el caso del primero bordándolo al incluir en uno de sus libros formados por estas reseñas inventadas una reseña del libro en cuestión, así...
Welcome to Macintosh. Un documental de Robert Baca y Josh Rizzo (2008). Siempre entrañable como casi cualquier pasaje de la historia antigua de Apple Computer, este documental es una recopilación enlazada de entrevistas con algunos protagonistas de la época y otros...
En la nueva cabecera de Los Simpson en HD, cuando pasan a Maggie por la caja del supermercado aparecen dos cifras en la pantalla. Entonces sucede algo que el Dr. Matrix calificaría de entre inquietante y premeditado por lo altamente improbable… 243.26...
Trilogy Meter es la particular visión de Dan Meth sobre algunas de las grandes trilogías del cine, con quien básicamente concordamos, especialmente en que la gráfica que va de la primera a la segunda y tercera parte de cada saga suele...
Ya se ha estrenado la prometedora serie Dollhouse de Joss Whedon (creador de las míticas Buffy Cazavampiros y Firefly entre otras). En esta ocasión, Eliza Dushku –más conocida por su papel como Faith, la cazavampiros «oscura» de Buffy– interpreta a una...
Joan preparó una selección personal de lo que consideró el mejor cine de su época, titulada Las 65 mejores películas de los años 80. Entre las elegidas se atisba cierto sesgo geek por la fantasía y la ciencia-ficción (un poco el...
Me llegó esto por correo electrónico: Lo cual ya sólo por el título promete bastante. Pero atención a la foto: Al parecer es una comedia titulada Frequently Asked Questions About Time Travel («Preguntas Frecuentes sobre Viajes en el Tiempo») y el protagonista...

King of Kong: A Fistful of Quarters. Un documental de Seth Gordon (2008). Ficha en la IMDB: King of Kong. Este especialmente entrañable documental narra la historia de un montón de gente alrededor de una competición de videjuegos clásicos: las máquinas...
Del departamento de Educación para el Geekerío, una lista de diez películas geek para educar a tus hijos adecuadamente, 10 Geeky Movies to Raise Your Kids On: La Guerra de las Galaxias, pero como debe ser empezando por lo que ahora se...
2019: Off-World guarda un archivo de artículos interesantes sobre Blade Runner, la mayoría un tanto añejos pero que conservan cierto interés para los fans del clásico de culto. Entre otras cosas hay un capítulo completo que Paul M. Sammon no pudo...
Slumdog Millionaire. Danny Boyle (2008). Web oficial. El director de Trainspotting y La playa consigue transportar al espectador de esta película a un mundo completamente distinto al occidental: el que rodea la infancia y la juventud de un niño miserablemente pobre...
Primer episodio, primera escena: ¡números chungos! A eso llamo yo un buen comienzo. De hecho es un buen comienzo de un buen comienzo. Promo de la 5ª temporada de Lost (Perdidos), esto pasará Lost (Perdidos), en el #2 de nuestro Top...
Trinity hackeando con nmap en algún tipo de *nix que se usaba en Matrix Hace tiempo que S21Sec publicó este entrañable artículo sobre la seguridad informática en los medios de entretenimiento como el cine y la televisión, donde se repasan diversas escenas...
Esta página salió en la edición del lunes pasado de La Voz de Galicia, diario en el que nos han fichado como colaboradores para publicar una página sobre tecnología, ordenadores, Internet y esas cosas en la sección de Sociedad. Tecnología para el...
Sleeper Cell (2005). Me recomendaron esta serie hace tiempo y creo que todavía no ha llegado a España, a pesar de que los episodios que he visto cuentan una historia profundamente interesante: la de una célula durmiente de terroristas islamistas que...
Frankenstein (1931) Una de las curiosas anécdotas de Nikola Tesla que se cuenta en Wizard: The Life and Times of Nikola Tesla es que en los años 30 colaboró con Paramount Pictures para crear toda la parafernalia eléctrica que utilizaba el doctor...
Man on Wire. Dirigido por James Marsh. 2008. Este curioso y apasionante documental narra una de las «hazañas» del funambulista francés Philippe Petit, calificada como «uno de los mayores crímenes artísticos de la historia de la humanidad». Allá por 1974, Petit...
Esta página salió en la edición del domingo pasado de La Voz de Galicia, diario en el que nos han fichado como colaboradores para publicar una página sobre tecnología, ordenadores, Internet y esas cosas en la sección de Sociedad. TDT: demasiado poco...
TorrentFreak acaba de publicar su ya tradicional lista de los mejores 10 sitios para buscar torrents del año, Top 10 Most Popular Torrent Sites of 2008, y que son: The Pirate Bay, con una media de más de 25 millones de personas...
Esta página salió en la edición del lunes pasado de La Voz de Galicia, diario en el que nos han fichado como colaboradores para publicar una página sobre tecnología, ordenadores, Internet y esas cosas en la sección de Sociedad. Cultura avisa a...

Hipnotizantes imágenes a cámara lenta captadas haciendo vibrar una gota de agua. Si crees que te podrías pasar horas mirando algo así también existe una versión larga en DVD de dos horas de duración: Wasserklangbilder. (¡Gracias por el enlace, Ángel!) Actualización...
El pasado día 18 de diciembre nos dejó otro icono del futuro, Majel Barrett-Roddenberry, la primera dama de Star Trek. Viuda de Gene Rodenberry, el creador de la serie, partició en varios papeles de la saga, especialmente como la enfermera Chapel en...
Esta página salió en la edición del lunes pasado de La Voz de Galicia, diario en el que nos han fichado como colaboradores para publicar una página sobre tecnología, ordenadores, Internet y esas cosas en la sección de Sociedad. Un canon que...
Film Addict calcula tu grado de adicción al cine si tienes la paciencia de marcar en la clásica lista de las mejores 250 películas de todos los tiempos de la IMDB cuáles has visto y cuáles no (importante: los títulos están en...
Star Wars ABC, vía Metropolis....
Por Nacho Palou -
11 DIC 2008
Una vez más, y ya van unas cuantas, un caso contra un sitio de intercambio de enlaces termina con el sobreseimiento de este: "Si no es delito, no es delito": Se sobreseen las actuaciones seguidas contra la página de elinks Spanishare. De...
Ver vídeo: The Black HoleThe Black Hole / Phil and Olly [3 min.] ¿Qué harías si tuvieras una especie de agujero negro portátil? Es una breve pero genial historia de las que se presentaron al festival de cortos Future Shorts. (Vía H.L.M...
Esta lista es del año pasado pero sigue siendo igual de interesante; se titula Top 50 Dystopian Movies of All Time y recopila películas distópicas de ciencia ficción. Un año después todavía no he conseguido terminar de ver todas las pelis...
“From Hell”, primer episodio de la tercera temporada de The I.T. Crowd. El pasado viernes comenzó la tercera temporada de The I.T. Crowd, una de nuestras series favoritas. El primer episodio “From Hell” ya tiene subtítulos en español disponibles gracias –como en...
Por Nacho Palou -
24 NOV 2008
Fractals: Hunting the hidden dimension (Michael Schwarz y Bill Jersey, 2008. NOVA / PBS). Un excelente y altamente recomendable documental sobre el fascinante mundo de los fractales. De una calidad de producción inigualable, explora gráficamente lo que son y cuál es...

Hace tiempo que Premiere recopiló esta fotogalería sobre las tal vez 25 películas más «peligrosas» de todos los tiempos, donde «peligroso» se define como digamos que no son «pelis de entretenimiento» o «para pasar el rato». Son experiencias galvanizantes que hacen...
Uno de nuestros temas favoritos de todos los tiempos es tratado en profundidad por alguien realmente friki del asunto, bajo el título de Temporal Anomalies in Time Travel Movies. Incluye tanto los clásicos como otras películas menos conocidas donde se abordan los...
Los trekkers más detallistas encontrarán en Star Trek Minutiae todos los guiones «oficiales» de Star Trek: la Nueva Generación, Espacio Profundo 9 y todas las películas, además de algunos episodios sueltos de Voyager y Enterprise. (Curiosamente, nada de la Serie Original,...
El esperado tráiler cuya descripción recibimos cual migajas, acaba de ver la luz oficial: Star Trek XI [HD], todavía sin título definitivo, con imágenes cañeras que anticipan una vuelta de la acción a la saga....
Amiguitos, pronto se va a impartir justicia, así que llegó el momento de arrodillarse ante el trailer definitivo de Watchmen. Altamente recomendable verlo en HD (y con detalle, cada píxel de cada uno de los 3.600 fotogramas, uno por uno). Lo...
El set de Flickr Early Star Wars Storyboards contiene algunos de los primeros bocetos de storyboards utilizados en el rodaje de las primeras películas de La Guerra de las Galaxias. El mismo usuario recopila además unas cuantas más en la colección...
Por Nacho Palou -
13 NOV 2008
Hay que ver cómo somos los fans del cine y la ciencia-ficción, siempre esperando la última noticia, el último trocito de vídeo, cualquier migaja que echarnos a la boca a la espera del estreno en la gran pantalla, ¡todo vale! En Uruloki...
Una vez más un caso contra un sitio de torrents que en su momento fue vendido a bombo y platillo y en el que se habló de pérdidas de hasta 535.000 euros ha sido sobreseido provisionalmente al considerar el Juzgado de Insrucción...

Con infinita complacencia, los hombres fueron de un lado a otro por el planeta ocupándose de sus pequeños asuntos, seguros de su dominio sobre la materia. Tal vez los microbios que vemos al microscopio hacen lo mismo. Nadie pensó que los mundos...
Esta página salió en la edición del domingo pasado de La Voz de Galicia, diario en el que hemos sido amablemente invitados a publicar una página sobre tecnología, ordenadores, Internet y esas cosas en la sección de Sociedad. Adiós a los discos,La...
Zattoo HiQ es la versión en alta calidad de Zattoo, un programita que sirve para ver la televisión convencional por Internet, en directo. Lo conocíamos desde la primera versión, y ahora nos dejaron amablemente probar la modalidad de pago «HiQ» que ofrece...
De The 5 Reasons Luke Skywalker Is a Complete Idiot, en Topless Robot: Por no pasarse al lado oscuro - toda una vida llena de desgracias (sus padres adoptivos mueren, todos sus amigos mueren o son heridos o torturados, la mujer que...
Por Nacho Palou -
27 OCT 2008
The Abyss Movie Set en Historic Decay. El abismo abandonado, en Fogonazos, es una visita virtual a los restos de lo que fue el decorado de la película The Abyss (1989) donde aprendimos sobre eso de la ventilación líquida para respirar sumergido...
Por Nacho Palou -
27 OCT 2008

Hace algún tiempo reseñábamos Brain Man, un interesante documental de Channel Five sobre Daniel Tammet, una persona que sufre el síndrome de Asperger y que, entre otras cosas, tiene unas asombrosas capacidades en cuanto a la manipulación de números y el...

Ojo con los spoilers si no has visto Perdidos hasta el final de la cuarta temporada. Dale al play bajo tu propia responsabilidad. No volverá hasta principios de 2009, pero para ir haciendo boca, aquí está una promo de la quinta...
Time Warp es un interactivo de Discovery Channel que permite ver algunas películas en cámara lenta (rodadas a alta velocidad) controlando el efecto con el teclado o el ratón, para apreciar todos los detalles. Entre otras cosas: los efectos de un...
Me debato entre la alegría y el horror ante ciertas nuevas secuelas de algunos clásicos; es como si a alguien se le hubiera acabado la imaginación y en vez de nuevas grandes películas solo sirviera el reciclaje de lo que en su...
Alex nos recomendó anoche mientras cenábamos un vídeo sobre cómo trabajan los guionistas de Lost que anda por YouTube: Ver vídeoLos guionistas de Lost [YouTube 3:36] (Javier me evitó el trabajo de tener que buscarlo.)...
En El Condensador de Fluzo han recopilado con datos de FilmAffinity las diez mejores peliculas con viajes en el tiempo, tanto para adelante como para atrás como en bucles interminables. De las diez sólo hay dos que no veré: El Gran Golpe...
Vaya por delante aquello de que no soy abogado, pero según cuenta Javier de la Cueva en Suspendido el canon: la Audiencia de Barcelona lo envía a Europa un reciente auto de la Audiencia de Barcelona admite preguntar al Tribunal de Justicia...
The Big Bang Theory, imagen de CBS.com. Esta semana ha comenzado la segunda temporada de The Big Bang Theory, una de las series más divertidas que he visto en los últimos tiempos. Reseña de The Big Bang Theory en Microsiervos....
Por Nacho Palou -
24 SEP 2008
Modified Mars (Marte modificado), es un detallado mapa de un Marte salido de novelas de ciencia ficción. Inspirándose en relatos de autores como Arthur C. Clarke, Carl Sagan, Kim Stanley Robinson, Robert Zubrin, Chris McKay y Thomas Gangale, entre otros, el...
Por Nacho Palou -
22 SEP 2008
David Bravo y Javier de la Cueva nos dan hoy una estupenda noticia en Resolución final del caso Sharemula. La Audiencia de Madrid es rotunda: las webs de enlaces a redes P2P no son delito. En efecto, el famoso caso contra Sharemula,...
Resérvate ocho minutos tranquilos antes de ver esto. Si pudieras pedir que se cumpliera un deseo antes de que acabara el día… ¿Cuál sería? § MeFi La banda sonora está compuesta por las canciones Slow Jam y Unspoken del D.J. británico...
43 episodios del correcaminos en YouTube, junto con una entrañable reseña de una de las series de dibujos animados que más infancias han marcado. Entre lo cruel y lo hilarante, con un verdadero protagonista loser que casi resulta más apasionante que el...
Generation Kill, imagen de IMDB.com Generation Kill. HBO 2008, creada por David Simon, Ed Burns, basada en el libro de Evan Wright. Dirigida por Susanna White, Simon Cellan Jones y Patrick Norris, Durante la invasión de Iraq en 2003 casi 800 redactores...
Con la llegada del mes de septiembre, además del fin de las vacaciones para muchos, llega la época de los coleccionables, segmento del mercado en el que año a año las editoriales se superan con propuestas cada vez más inverosímiles… Pero también...
Aunque absolutamente from the past, porque se actualizó por última vez en 1999 (!) siempre viene bien repasar los guiones originales que están en INFlow’s Sceenplay Repository, incluyendo todas las películas de Quentin Tarantino como Reservoir Dogs o Pulp Fiction, las de...
Me crucé con el trailer de 2081: Everyone Will Finally Be Equal, una película de ciencia-ficción sobre un futuro distópico, en el que todas las personas son iguales porque a todos se les hace «peores» por ley. Está basada en el...
Según se puede leer en Coalición de Creadores y operadores negocian un modelo contra las descargas no permitidas la Coalición de Creadores e Industria de Contenidos, integrada por entidades como la SGAE, Promusicae y la Federación para la Defensa de la Propiedad...
WALL·E (Andrew Stanton, 2008). Web oficial: WALL·E Batallón de Limpieza. En el futuro la Tierra está tan llena de basura que la humanidad decide abandonarla y refugiarse en una nave espacial dejando atrás toda una cuadrilla de robots que se encargarán...
Batman: El caballero oscuro (Cristopher Nolan, 2008). Christian Bale, Heath Ledger. Web oficial: The Dark Knight. Otra excelente película que no hay que perderse, pero esta vez y aunque suene extraño, por ver al Joker más que al propio Batman. La...
Al portavoz bocarrana de Telecinco le han durado menos sus afirmaciones que a Apple los iPhone el día del lanzamiento: Condenan a Telecinco a pagar 31.252 euros por emitir sin permiso Remington Steel. Lo más divertido es que el caso proviene de...
Una tarrina de 50 CDs - 7,58 eurosCanon correspondiente - 10,50 euros La discusión acerca de si esta factura es de verdad o no (que sí lo es), de su legalidad, de a quién lo corresponde pagar el canon y de otras...
Modern Marvels: Tomcat sunset (The History Channel 2006) Inglés. 68 minutos. Después de 32 años de servicio una ceremonia celebrada en NAS Oceana el 22 de septiembre de 2006 ponía fin a la carrera del Grumman F-14 Tomcat con la marina...
La diferencia en la apariencia estética y la legibilidad del texto inicial entre las películas originales de La Guerra de las Galaxias y las películas más recientes sirve de ejemplo para una lección sobre justificado en Star Wars y la tipografía....
Por Nacho Palou -
31 JUL 2008
TR2N ComicCon 2008 teaser [YouTube, 3 min.] es un adelanto en forma de teaser trailer de Tron 2 (título real: TR2N), una segunda parte de la mítica película medio de animación medio de ordenador medio de imagen real Tron que tanto...
Un curioso artículo en Scientific American explicando desde un punto de vista real por qué un superhéroe como Batman podría existir en el MundoReal™. Why Batman Could Exist--But Not for Long (Por qué Batman podría existir --aunque no por mucho tiempo -...
Por Nacho Palou -
21 JUL 2008
Aunque con los años ha ido ganando en popularidad y reconocimiento hasta el punto de que es candidata a formar parte del patrimonio de la humanidad de la UNESCO en su apartado de la Memoria del Mundo, cuando en enero de 1927...
Me recordarán de... Curriculum completo de Troy McClure en IMDB (Vía Cynical-C Blog.) Bonus: Troy McClure en Wikipedia en español (¡sorprendentemente completa!) Mas: Troy McClure Film or Actual Terrible Movie? un test rápido en el que hay que responder si los sucesivos...
Por Nacho Palou -
25 JUN 2008
Llegan con varios meses de retraso sobre lo previsto inicialmente, pero tal y como recoge El País en Aprobado el nuevo canon digital con una rebaja para los móviles el Boletín Oficial del Estado publicaba ayer la Orden Ministerial que recoge las...
Stan Winston (1946-2008) en The Far Left Side por Mike Stanfill. – Si, no está mal esto, ¡pero ahora que estás aquí podemos hacer algo verdaderamente chulo! Sólo que esta vez sin republicanos....
Por Nacho Palou -
19 JUN 2008
Estos días estoy repasando Firefly por segunda vez, y mirando por ahí me encontré con este interesante Timeline de Firefly, una cronología con las fechas más relevantes según lo que se puede adivinar en la serie que sucede de aquí al siglo...
21: Blackjackde Robert Luketic, con Jim Sturgess y Kevin Spacey. Estuve viendo 21: Blackjack con ganas tras haberme leído diversos los libros sobre el tema de los hackers del MIT que «ganan a los casinos al Blackjack», y aunque sabía que...
Todavía no he terminado de verlo, así que haré la reseña completa cuando lo haya hecho, pero por lo que he visto hasta ahora el documental The machine that changed the world de WGBH Boston y BBC TV es tan bueno como...
Sheldon Shirts es una recopilación de todas las camisetas que el nerd de Sheldon luce en The Big Bang Theory, una de nuestras más recientes series favoritas. También salen algunas de las de sus colegas y otras camisetas nerds/geeks que encontró...
Dollhouse [2 min.] (Casa de muñecas) es la esperada nueva serie de ciencia-ficción de Josh Whedon, al que recordamos como creador de series como Buffy Cazavampiros, Firefly y por haber participado en diversos guiones, como el de la entrañable Toy Story....
A falta de analizar la demanda a fondo para poder comentarla David Bravo reproduce en Caso Napster a la Española: reclaman a desarrollador de software P2P 13 millones de euros la nota de prensa que MP2P Technologies ha distribuido al respecto. Los...
Una de nuestras películas favoritas de todos los tiempos, la mítica Juegos de Guerra, está de aniversario y cumple 25 años estos días. Lo mencionan Slashdot y Barrapunto: WarGames and the Great Hacking Scare of 1983 «Juegos de guerra» cumple 25...
En la sentencia del Juzgado de Instrucción Número 4 de Cartagena recogida en Caso Elitedivx: proporcionar enlaces P2P no es delito el juez ordena el sobreseimiento de caso contra los responsables del sitio eliteDivX. No soy abogado y a lo mejor meto...
El récord de longitud lo tiene la película La vuelta al mundo en ochenta días de 1956. El segundo puesto es para Clerks 2, en cuyos créditos finales Kevin Smith incluyó los nombres de todas aquellas personas que lo marcaron como...
Por Nacho Palou -
4 JUN 2008

Boeing 747-400 Cathay Pacific. Intelligent Television and Video. DVD multizona, aspecto 4:3, 63 minutos, PAL o NTSC, inglés sin subtítulos. Inteligent Television and Video es una empresa que se dedica a producir documentales para aerotrastornados que recogen vuelos de distintas compañías...

Recientemente falleció Alexander Courage (1919-2008), más conocido por ser el compositor del mítico tema musical original de Star Trek, que tantas y tantas veces hemos oído. Ahí queda el vídeo con la famosa introducción a modo de homenaje. En su página...
La Asociación de Amigos de la Casa de las Ciencias convoca la I Edición de la Muestra Internacional de Ciencia y Cine, un certamen que «quiere ser un referente internacional en el ámbito del documentalismo científico, y aspira a ser el gran...
En el sitio oficial de Formula 1 hay resúmenes en vídeo de buena calidad que condensan todo un campeonato en apenas un minuto y permite repasar maniobras a cámara lenta ajustable. La versión en grande merece la pena y carga dignamente...
Por Nacho Palou -
28 MAY 2008
El columpio de Heidi, cuyas colosales dimensiones mirábamos asombrados los niños de los 70 en la ya clásica apertura de cada episodio [YouTube] tiene según puede calcularse una longitud de l = 20,25 metros tal y como explican en el hilo del...
Banderas de nuestros padres (2006). Dirigida por Clint Eastwood. De los seis hombres que salen en la famosísima fotografía de Joe Rosenthal del izado de la bandera en Iwo Jima sólo tres salieron con vida de la isla, ya que aunque...
Una «carta de efectos acongojantes» de la Fundación Anti Piratería ha provocado el cierre de Wikisubtitles por parte de smalleye, su administrador, a la espera de lo que le puedan recomendar los abogados al respecto, tal y como cuenta él mismo en...
Everything’s Gone Green (2007). Dirigida por Paul Fox. Estuve viendo por fin la divertida Everything’s Gone Green con guión de Douglas Coupland, nuestro Santo Patrón, que me resultó bastante fresca y familiar. Por todos los detalles visuales y de la historia...
Tom Castro, un lector del blog, nos envió una captura de pantalla de una curiosa formación geográfica visible en las imágenes aéreas de Sigpac (Sistema de Información Geográfica del Ministerio de Agricultura y Pesca, similar a Google Maps), para preguntar si sabíamos...
Por Nacho Palou -
16 MAY 2008
Ya hay trailer oficial para el segundo largomentraje de Expediente X, que tendrá como título The X-Files: I Want to Believe. Mas detalles en: Blog de Cine y unos pósters chulos en 10 GoTo 10. Vuelven Mulder y Scully con una...
Precioso póster alternativo de Blade Runner en The Popcorn Cult, donde hay algunos más de películas de la época, como Golpe en la Pequeña China. Se pueden comprar en la sección de pósteres de Mondo Tees que es parte de The...

Película de culto donde las haya, largometraje que todo adolescente debería ver –y el resto del personal también– ahora Donnie Darko (Richard Kelly, 2001) tendrá una secuela, se llamará S. Darko y como cuentan un tanto por encima en Snarkerati, tratará sobre...
Hoy a las 22:30 se estrena simultáneamente en antena y en la web Solo ante el peligro, el nuevo late night de Paramount Comedy presentado por Juan Solo. El proceso de puesta en marcha del programa puede leerse en Tambores de guerra...
WWII: The Lost Color Archives (2000), también conocido como World War II in color. The History Channel. Inglés. 135 min. Disponible en Google Video: WWII The Lost Color Archives 1/3 WWII The Lost Color Archives 2/3. WWII The Lost Color Archives...
Speed and Angels (2008). Dirigida por Peyton Wilson. Inglés. 95 min. Web oficial. Jay dice que siempre ha querido ser piloto de caza de la marina y que probablemente es algo que lleva en la sangre porque su padre lo llevó...
The Man from Earth (2007). Dirigida por Richard Schenkman. Basada en una obra de Jerome Bixby. 85 min. Web oficial: ManFromEarth.com. Entrañable esta pequeña película que me recomendó Inti y que bien podría ser una obra de teatro. El argumento es...
El municipio lucense de A Fonsagrada se convertía hoy, con casi dos años de adelanto respecto a la fecha prevista para toda España, en el primero en el que se producía el apagón analógico y la recepción de la señal de televisión...
Por casualidad descubrí que están emitiendo la serie basada en el libro jPod en el canal Buzz, disponible en plataformas digitales (Digital+, Imagenio, et al), los miércoles a las 22.30 horas. Curiosamente ahora veo que salió publicado en varios sitios, aunque por...
Por Nacho Palou -
4 ABR 2008
Ya se había rumoreado a finales del pasado mes de octubre, pero SlySoft confirmaba hace unos días en Press Release: AnyDVD HD now with BD+ support que BD+, el sistema de protección contra copia de los discos Blu-ray que supuestamente iba a...
Everything's Gone Green es una nueva(*) película en tono de comedia de Douglas Coupland, nuestro Santo Patrón y autor de Microsiervos. Por el trailer que puede verse en la web tiene pinta de ser bastante divertida, tal vez un poco en...
Nano nos recordó que en unas semanas se estrena en EE.UU. 21, que es la esperada película sobre el equipo del M.I.T que contaba cartas para ganar al BlackJack. El trailer que se está emitiendo en algunos cines españoles y que también...
Did You Know? 2.0 [originalmente en Flash, pero desapareció, aunque encontré esta otra versión en YouTube] es una presentación con una una duración de unos siete minutos. Contiene un montón de datos curiosos del tipo ¿Sabías que…? pensados para provocar pensar....
"Alguien voló sobre el nido del cuco" en el episodio 9F17 "Éste es el resultado: Retrospectiva de Los Simpsons". La serie de anotaciones Momentos de cine de Actualidad Simpson recopila decenas de escenas de Los Simpson que son recreación de escenas de...
Por Nacho Palou -
7 MAR 2008
Si no has visto aún la película Soy Leyenda, tal vez no quieras seguir leyendo. En Must Watch: I Am Legend's Original Ending - This is Amazing se puede ver (en inglés) el final alternativo para la película Soy Leyenda (I Am...
Por Nacho Palou -
6 MAR 2008
Dangerous Knowledge BBC Four. David Malone (2007). Inglés. 90 minutos. Esteban me recomendó este documental que, dividido en dos entregas de 45 minutos, explora a modo de homenaje las vidas de cuatro científicos: Cantor, Gödel, Turing y Boltzmann. Las vidas de...
En septiembre de 2006 José Manuel L. H. fue absuelto en el juicio al que lo llevaron distintas entidades de gestión de derechos de autor por descargar música, películas y juegos de Internet y compartirlos a través de redes P2P con otros...
“Hace mucho tiempo,pero de algún modo en el futuro...” © Twentieth Century Fox Film Corp. Esta mañana asistimos en la Casa FOX al pase para prensa de Padre de Familia: “Blue Harvest”, un episodio a camino entre la parodia y el homenaje...
Por Nacho Palou -
26 FEB 2008

No se yo si hacía falta un estudio científico para esto, pero ahí está: Why Does Popcorn Cost So Much at the Movies? analiza el trabajo de investigadores de Stanford y la Universidad de California sobre el precio de las palomitas,...
Este Video Esférico de Melbourne [requiere Flash] está bastante bien conseguido: permite moverse arrastrando el ratón y las vistas son preciosas. Es como un panorama de QuickTime VR en 360 grados pero en movimiento, el helicóptero sigue volando por ahí mientras...
(Vía Digg, vía RPF.)...
Por Nacho Palou -
25 FEB 2008
Se veía venir desde principios de este año y los rumores en los últimos días así lo aseguraban, pero ahora ya es oficial, pues el propio presidente de Toshiba comunicaba esta misma mañana de manera oficial que su empresa abandona la producción...
Absolute Zero: The story of harnessing of cold and the race to reach the lowest temperature possible. NOVA/PBS. David Dugan (2008). Inglés. 120 minutos. Basado en el libro Absolute Zero and the Conquest of Cold de Tom Shachtman. Me cruce con...
Why 2010 is better than 2001 es un provocativo título con el que en IO9 rinden de paso homenaje al recientemente fallecido Roy Scheider, más conocido por su papel de Sheriff Brady en Tiburón (1975). Aunque suene a sacrilegio siquiera intentar comparar...
No es país para viejos de Ethan y Joel Coen (2007). Tommy Lee Jones, Javier Bardem, Josh Brolin. Llewelyn Moss (Josh Brolin) está un día de caza en el desierto de Texas cuando mientras sigue el rastro de un antílope al...
The Big Bang Theory, imagen de CBS.com. The Big Bang Theory de Chuck Lorre y Bill Prady. Reparto: Johnny Galecki, Jim Parsons, Kaley Cuoco, Simon Helberg, Kunal Nayyar. Hasta la fecha se han emitido ocho episodios de la primera temporada de la...
Por Nacho Palou -
11 FEB 2008
When is HD not HD? cuenta la estúpida situación en la que podrían estar inmersos algunos servicios de venta y alquiler de películas y series en alta definición (HD), tipo Apple TV y Xbox Live. El resumen del asunto es que si...
Mejor ir reservando estos días en la agenda de este año: la próxima WeekendTrek 2008 tendrá lugar los días 12, 13 y 14 de septiembre de 2008 en Sevilla. Es la convención nacional de Star Trek que está organizando el Club...
Los Crímenes de Oxford de Álex de la Iglesia (2008). John Hurt, Elijah Wood, Leonor Watling. Entretenida película esta que trata de una serie de crímenes en serie en la Universidad de Oxford, en los que un profesor y un estudiante...
En EE UU el “carpooling” es compartir coche entre varias personas para ir al trabajo, por ejemplo. Esto permite utilizar carriles especiales para vehículos de alta ocupación —lo que aquí es el carril BUS/VAO para autocares, coches con dos o más...
Por Nacho Palou -
22 ENE 2008
En cualquier momento pueden entrar en vigor las nuevas tarifas del canon digital que el mes pasado nuestros políticos decidieron mantener vigente al rechazar una enmienda que proponía su revisión para dentro de un año, así que es el momento de aprovechar...
Life After People se estrena hoy noche en History Channel en EE UU. Life After People es un documental que especula sobre cómo sería el mundo si de algún modo el planeta quedase repentinamente libre de humanos. Se estrena hoy History Channel...
Por Nacho Palou -
21 ENE 2008

La Realidad de la Vida, de Lazyboy (Facts of Life, 2005), es un simpático vídeoclip que enumera un montón de hechos estadísticos curiosos, medio verdad medio leyendas urbanas, como los que circulan en las famosas listas de Internet que casi nadie...
Primeras imágenes de la grabación de Expediente X 2 De esto si que no tenía ni idea: vuelven Mulder (David Duchovny) y Scully (Gillian Anderson) con una nueva entrega de Expediente X / X-Files en formato película aún sin título, aunque podría...
Por Nacho Palou -
18 ENE 2008
Mensaje reivindicativo sobre Tesla en la serie House, A Tesla le robaron Lo vío Tomàs Segarra en el segundo episodio de la cuarta temporada de la serie. Dr. House, una definición concisa del personaje.Música de la serie Doctor House, que tampoco tiene...
Por Nacho Palou -
18 ENE 2008
Cuatros tipos. Una cámara. Cuatro días. Mucho, mucho talento: Bloody Omaha [YouTube, 4 min.] Pulsa play y prepárate para que se te caiga la mandíbula: (Víctor Indio Alfa futuratronics desde Kevin Kelly)...
La brújula dorada. Chris Weitz. New Line Cinema 2007. Página oficial de la película. Un aletiómetro © New Line Cinema Lyra Belacqua es una niña de 11 años que vive en un universo paralelo muy parecido al nuestro, con muchos elementos muy...
Completa lista con todos los cambios en las escenas de Blade Runner: The Final Cut, auténtico trabajo por amor al arte. Incluye tanto los cambios generales como detalles escena a escena. En una de las escenas de Deckard corriendo por el interior...
Como actualización de la lista de Buscadores de Torrents que funcionan que publicamos hace casi un año, esta es la lista de los diez sitios más populares de 2007, sacada de Top 10 Most Popular Torrent Sites of 2007: Mininova, uno de...
Whisky Romeo Zulu. Enrique Piñeyro. Aquafilms, 2004. Página oficial de la película. El 31 de agosto de 1999 el Boeing 737-204C con matrícula LV-WRZ (Whisky Romeo Zulu en el alfabéto fonético aeronáutico) que realizaba el vuelo LAPA 3142 con destino Córdoba (Argentina)...
Crossover múltiple con «cameos» del Tetris en algunas de nuestras series favoritas: Padre de familia, Futurama y Los Simpsons. La escena de los Simpsons, que no conocía, me ha recordado aquello de que La vida cada vez se parece más a...
The Galactically Hot Women of Star Trek TOS es una galería de fotos con todo el glamour alienígena de los 60 (o del siglo XXIII, según se mire): las más bellas representantes del género femenino de origen interestelar, procedentes de lugares...
Death Star de Mattias Adolfsson.Ver a tamaño grande. ...Y otros personajes y artilugios de La Guerra de las Galaxias en Star Wars, the baroque version y parte 2, parte 3 y parte 4. (Gracias José Alfonso, vía John Nack on Adobe.)...
Por Nacho Palou -
21 DIC 2007
1408. Mikael Håfström. Dimension Films/MGM, 2007. Basada en la historia corta 1408 de Stephen King. John Cusack en 1408 Mike Enslin es un escritor que después de haber escrito lo que parece ser una buena novela cambió de estilo radicalmente y ahora...
Fuerza Aérea Sociedad Anónima. Enrique Piñeyro. Aquafilms, 2007. Página oficial de la película. Argentina, junto con Nigeria, tienen la dudosa distinción de ser los dos únicos países del mundo en los que se da la curiosa circunstancia de que la aviación civil...
Ya hemos hablado en alguna ocasión de la guerra de formatos de vídeo de alta definición entre Blu-ray y HD-DVD, pero me parece que en este texto de Clear Blu en ReelToughts está muy bien resumido el asunto: No se trata de...

Precioso póster de The Dark Knight, la próxima película de Batman, con reminiscencias evidentes a la escena final de El Club de la Lucha. Lo último que habíamos visto aparte de otros pósteres fueron algunas fotos interesantes. A seguir salivando hasta 2008...
¡Oh!, ¡Cazadores de Mitos en cualquier lugar! Llevamos unos días probando la plataforma de televisión móvil de Vodafone Live que se emite vía 3G y que viene en dos sabores: Live TV y Digital+ móvil (o tres sabores contando los canales para...
Por Nacho Palou -
14 DIC 2007
The Room Illusion es uno de los más asombrosos e impactantes fragmentos del maravilloso y altamente recomendable documental Brain Story (2000). Es una ilusión óptica de las mejores que haya visto nunca. No hay trucos digitales ni de post-producción: es una...
Mientras muchos ya vais recibiendo vuestros maletines en Zona DVD han hecho un completo análisis de la edición definitiva para coleccionistas de Blade Runner en DVD, también conocida como Blade Runner: The Ultimate Collection. Este análisis se divide en tres partes, Las...
Ayer terminé de ver la segunda temporada de la serie Dexter y debo reconocer que es una fenomenal y muy digna sucesora de la entrega original. Es de agradecer además que los productores nos ahorren el hastío que produce la cada...
Por Nacho Palou -
10 DIC 2007

White and Nerdy Lego Edition es un cruce entre «Blanquito» y Nerd + LEGO en stop-motion....
Justo hoy que en España hemos empezado a recibir los packs Blade Runner: The Ultimate Collection me encuentro el artículo Blade Runner on the Cutting Edge que explica cómo se pasa una película del celuloide a los nuevos formatos digitales de alta...
Donkey Xote. José Pozo. Filmax Animation, 2007. Reseña en plan Ferguson, porque la cosa no da para más: Filmax le aplica el método Shrek al Quijote y fracasa. Estrepitosamente. De todos modos, a los niños, que no saben más, les gusta. Por...
Aunque ya conocía a Alfonso Merelo de oídas, o más bien de leídas en algunas listas de correo, estos días he estado echando un vistazo a su blog después de haber leído Fantástica Televisión, su libro sobre series de televisión de tema...
(Nota: Esta anotación habla de MyStrands, que es una de las empresas en que participo como consejero. Ver Full Disclosure.) Hoy ha sido un gran día para uno de los proyectos en los que tengo el honor de participar. El Grupo BBVA...
Mientras que en Francia ya se está hablando de emisiones en Alta Definición vía TDT en España su implantación no parece acabar de arrancar, y de hecho hasta los propios directivos de las cadenas dudan de que se pueda llevar a cabo...
"¡Buenas noticias chicos! los idiotas que cancelaron nuestra serie han sido despedidos por incompetentes..." Ya está a la venta (17,99 dólares, en inglés) el medio-largometraje Bender's Big Score que supone de algún modo la vuelta de la malograda serie Futurama, una...
Por Nacho Palou -
27 NOV 2007
Fantástica Televisión Alfonso Merelo. Grupo Editorial AJEC 2007. ISBN: 9788496013355. Blog del autor: - MEMORANDO - . (Nota: Aunque por lo general es el Grupo AJEC quien de vez en cuando nos envía libros dentro de su servicio de prensa por si...
Damages creada por Glenn Kessler, Todd A. Kessler y Daniel Zelman. Reparto: Glenn Close, Rose Byrne, Ted Danson, Zeljko Ivanek, Noah Bean. 13 episodios. Web oficial: Damages. Si vi esta serie fue gracias a esta apasionada reseña de Inti: Si no...
¡Nunca se sabe cuándo se va a necesitar escapar de un cubo gigante lleno de habitaciones llenas de trampas mortales, con números extraños grabados en las puertas! Para no acabar como los protagonistas de Cube, MalaCiencia ha recopilado en la anotación...
Gonzalo Martín lleva un par de días en el II Congreso de Interactividad y Televisión Digital Terrestre (TDT) y lo está blogeando en su blog, La Nueva Industria Audiovisual: Congreso de TDT e Interactividad de Alcázar: impresión urgente, primeras notas sobre el...
A tenor de informaciones como las publicadas en el reportaje SGAE: la punta del iceberg de un entramado societario de Público y otros similares la Asociación de Internautas, junto con la Asociación Española de Pequeñas y Medianas Empresas de Informática y Nuevas...
Si este próximo fin de semana no vas a estar en Evento Blog España a lo mejor te apetece pasarte por Jornada Albedrío: Por una Cultura Libre, organizada con el objeto de «debatir sobre el libre flujo de la información, que está...
Doble ración bladerunneriana hoy. En el Sci Fi Scannner de AMC publican Blade Runner II? donde se comenta medio en serio los rumores sobre una posible secuela de Blade Runner. Sería como para ignorarlo si no fuera porque citan a Paul Sammon,...
¡Oportunidad histórica donde lass haya! Me sorprendió leer que Blade Runner: el gran clásico del cine futurista, regresa a las carteleras (20 Minutos) y comprobando los cines de Madrid veo que efectivamente se va a poder ver esta semana (en el...
Los 10 falsos documentales más falsos es una fotogalería del diario ADN de un género bastante curioso para quien le gusten los documentales. Sólo he visto algunos así que intentaré buscar los otros a ver qué tal, porque me encanta ese...

Bart Bauer, la parodia de 24 protagonizada por Los Simpsons. Con un gran comienzo. (¡Gracias, neoburgos!)...
Sorprendentes declaraciones de Edgar Bronfman, el CEO de Warner Music, en Warner Music Boss: We Were Wrong, sobre todo por lo que representan de cara a un hipotético cambio de actitud de la industria: Solíamos estar tan orgullosos de nosotros mismos… creíamos...
Fictional Flags, una enorme recopilación de decenas de banderas que aparecen en relatos, libros, películas o series de ficción y que identifican países, planetas, federaciones, razas, entidades diversas e incluso otros planos de existencia. Bandera de Tomanian en “El Gran Dictador” (Vía...
Por Nacho Palou -
15 NOV 2007
He aquí el totalmente hilarante episodio que describe la durísima existencia tecnológica de Jack Bauer y la gente de la CTU en 1994, época en que se supone está rodado este episodio piloto / parodia. Con AOL dominando la superautopista de...
The Top 10 Evil Computers que puede hojearse como fotogalería muestra los ordenadores más malos malosos de la historia de la ciencia-ficción, incluyendo a HAL 9000 de 2001: Una Odisea del Espacio, Nomad (de Star Trek), el ordenador de Superman III,...
Desde hoy mismo ya se puede reservar Blade Runner: The Ultimate Collection en DVDgo: Maleta Blade Runner: Montaje Final. Edición Coleccionista 5 Discos, aunque no se pondrá a la venta ni la enviarán hasta el 11 de diciembre. Recuerda que se trata...
Este anuncio es una viejísima campaña de The Guardian, el periódico británico. El narrador viene a decir algo así como que «un evento visto de una forma puede parecer una cosa, visto desde otro puede parecer una distinta y sólo cuando...
Guide to Mathematics and Mathematicians on The Simpsons recopila, una por una, todas las referencias matemáticas que alguna vez han aparecido en episodios de los Simpson. Hay otras recopilaciones similares y muchos enlaces más en Simpsonsmath.com. (¡Mosquis! ¡Gracias Javier!)...
Mmmm… Esto yo ya lo he vivido… Acabo de recibir por correo ordinario la Guía Rápida para clientes: Todo lo que necesita saber para sacar el máximo partido a Digital+, un folletito donde destaca su sección ¿Que hago si…? con grandes soluciones...
¡AVISO! ¡Spoilers mortales! Pueden atacarlo… Pueden juzgarlo… pero no pueden doblegarlo. Promete, promete… (Este Vía tuvo lugar en ALT1040 entre las 8:00am y las 9:am)...

Los problemas cotidianos del hombre más rico de la historia. Actualización: ¡Siempre es arriesgado usar «el único…»! Por correo Martin nos envió Microsoft DaDaDa que es otro anuncio protagonizado por Gates y Ballmer, sobre el navegador Microsoft Explorer, estilo Volskwagen. Y...
No sé ni cómo me topé con esto: Star Trek National Power [YouTube, 1 min.] un extraño y divertido anuncio televisivo británico de principios de los 90. Son los personajes de Star Trek en todo su esplendor, en la época que podría...
Why sci-fi makes me better than you. Las seis razones que aporta este autor, en un ensayo entre lo personal y lo humorístico, dedicado a los diversos fans de culto: 1. Molas más (hotness)2. Honestidad3. Lealtad4. Fe en la humanidad5. Invención e...
Si es que en Youtube hay de tó, como en Internet. Fascinante. (Vía los Vídeos Relacionados que ofrece YouTube a la recopilación de Mahna Mahnas de Least Significant Bit – canción que data originalmente ni más ni menos que de… ¡1969!...

Time Bandits Map es una réplica en alta resolución del mapa que utilizan los protagonistas de Los Héroes del Tiempo (1981), una de las películas más encantadoras de Terry Gilliam (con muchos de los Monty Phyton de protagonistas) y una de...

Enjuto Mojamuto intentando la solución universal válida tanto para la realidad como la ficción, en lo que el muñeco de Muchachada Nui denomina El Peor día de mi vida. Otras peliculitas del histriónico y cibernético protagonista: La Agenda Apretada La Cibernovia...
Cuando en abril del año pasado se lanzó una gran operación policial contra las redes de intercambio de enlaces P2P, la que en su momento se calificó como una operación sin precedentes en Europa, muchos dijimos que no era más que un...
Star Trek XI, como ya anticiparon, se desarrolla en la academia de la flota estelar. Estas son las caras del reparto confirmado: (Vía Uruloki :: Blog.)...
Es un poco largo y falto de enlaces porque está escrito para una revista de esas que se publican en formato árboles muertos, pero aún así Más Allá De La Telebasura: Las Pseudociencias es un interesante repaso de Javier Armentia a cómo...
“¡Buenas noticias chicos! los idiotas que cancelaron nuestra serie han sido despedidos por incompetentes...” Ya está disponible el tráiler del largometraje de la serie Futurama que, como ya comentamos por aquí, previsiblemente saldrá en noviembre directamente en formato DVD, divido en...
Por Nacho Palou -
9 OCT 2007

Todavía me sigue gustando más el anuncio de las pelotas saltarinas cayendo San Francisco abajo, pero reconozco que el nuevo anuncio de Sony Bravia de los conejitos de plastilina de colores está también muy bien. Los datos del making of son...
Brain Story. Narrado por Susan Greenfield. 2000. Inglés. Miniserie (6 episodios de 50 minutos). Libro de la autora: Brain Story: Why Do We Think and Feel as We Do? (Por qué pensamos y sentimos como lo hacemos?) El estudio del cerebro...

Galactica: Gag Reel, Season 3 [YouTube, 10 min.] Golpes y porrazos, risas, muecas… conviene haber visto antes esta tercera temporada de Galáctica, Estrella de Combate para apreciar mejor el contraste entre lo oscuro de la serie y las risas del rodaje....
Monolito, una obra artística de David Herbert. Este monolito estilo 2001: Una odisea del espacio es una versión gigante de una cinta VHS de la propia 2001. Parece que incluso mantiene más o menos las proporciones del original creo eran 1×4×9 según...
Una de las cosas que intentamos dejarle clara en la medida de lo posible a Rich Marty, el vice presidente para New Business Development de Sony Pictures Home Entertainment, cuando estuvimos hablando con él durante el encuentro con bloggers que Sony organizó...
Desde hoy Joost, el servicio de vídeo bajo demanda a través de Internet que tanto está dando que hablar en los últimos meses y que ya habíamos podido probar hace algún tiempo, está abierto al público sin necesidad de invitaciones, así que...
Brain Man (Channel Five, 2005) [Google Vídeo, 43 min., inglés; también disponible en las redes P2P] Al acabar de leer Born on a blue day me quedé con las ganas de ver Brain Man, el documental que realizó Channel Five sobre...
Gran artículo Bladerunneriano: A Cult Classic Restored, Again en el New York Times. El autor es Fred Kaplan, e incluye todo lo que cualquier amante del cine debería saber sobre el clásico entre los clásicos de la ciencia ficción: lo más...

Guns, Germs and Steel: The Fates of Human Societies. Jared Diamond. 1997. Inglés. 480 páginas. ISBN: 0393317552. En español: Armas, gérmenes y acero (Editorial Debolsillo). Tengo que agradecer a mi amigo José Manuel que me sugiriera este libro cuando hablábamos sobre...
Hace unos días la cadena NBC decidía retirar sus programas de televisión de la iTunes Store, no porque se vendieran mal, ya que de hecho suponían como un tercio de las ventas de vídeos en la iTunes Store, sino porque quería aumentar...

La serie de anuncios y la web del Subaru Impreza WRX están inspirados en Blade Runner: la música es muy Vangelis y los lemas «The Legend Reborn» y «It’s What Make a Subaru, a Subaru» parece también alusiones a la película...
Cuatro matemáticos desconocidos entre sí son invitados por un misterioso anfitrión con el pretexto de resolver un gran enigma. La sala en que se encuentran resulta ser un cuarto menguante que les aplastará si no descubren a tiempo qué les une...
La semana pasada en la IFA Sony nos regaló cinco discos en formato Blu-ray que ni Dixel, ni Eduardo ni yo podemos ver porque no tenemos ningún reproductor compatible, lo que nos llevó a plantearnos qué porcentaje de nuestros lectores podía tener...
Estamos en septiembre, y además de la vuelta de los niños al cole y de los las coleccionables cada vez más inverosímiles y largos a los quioscos también vuelven nuestras series favoritas a la televisión, así que no te pierdas Your Definitive...
Los actores que ganan un Oscar de la Academia de Hollywood viven como promedio cinco años más que los candidatos que no lo ganan. [Fuente: un estudio de Michael Marmot, de WhiteHall Studies, citado en The Black Swan.]...
(Nota: Esta anotación habla de MyStrands, que es una de las empresas en que participo como consejero. Ver Full Disclosure.) Se acaba de lanzar en beta MyStrands.TV que es uno de los proyectos que estaban en la lista de lanzamientos del...
Igual que hicieron en su momento con la primera temporada de la serie, en Noséqué.net está publicando los subtítulos para la recientemente estrenada segunda temporada de The I.T. Crowd.Ya están disponibles los de los dos capítulos emitidos hasta ahora, y prometen seguir...
Tal y como estaba previsto este pasado viernes se celebró la reunión con ejecutivos de Sony Electronics y Sony Pictures Home Entertainment en el marco de la feria IFA 2007 que está teniendo lugar estos días en Berlín, y la sensación, al...
Blade Runner Trailers and Video Clips son cuatro pequeños clips que muestran unos cinco minutos de las novedades que se podrán ver en Blade Runner: Edición Especial 25º Aniversario, incluyendo una persecución de Zhora ampliada, algunas tomas inéditas de Deckard (Harrinson Ford)...

The Simpsons Star Wars es un magnífico y divertido vídeo creado por Rich Cando que sitúa la conocida introducción de los episodios de los Simpson en el universo de Star Wars. (TechEBlog vía Freak's City vía Volatilis.) Relacionado: Los Simpson, una...
Ratatouille. Brad Bird y Jan Pinkava (co-director). Pixar, 2007. Web de la película. Por diferentes motivos no pude ir a ver esta película hasta varias semanas después de que la estrenaran, con lo que a esas alturas ya había leído varias críticas,...
El viernes de la semana que viene estoy invitado a participar en un encuentro con los directores de Sony Pictures y de Sony Electronics, que si no me equivoco son respectivamente las divisones de Sony responsables de los contenidos en formato Blu-ray...
The IT Crowd, una de nuestras series favoritas y una de las que más se hace esperar, ya tiene fecha de regreso para su segunda temporada, el 24 de agosto en Channel 4 (Reino Unido) —después de mucho tiempo sin tener...
Por Nacho Palou -
13 AGO 2007
Este vídeo en cinco partes es un documental de BBC Horizons sobre algunas ideas científicas alrededor de la construcción del Large Hadron Collider (en la Wikipedia en español: Gran Colisionador de Hadrones), el más caro y complejo instrumento científico jamás creado...

Bonita película del estilo de Cosmic View y Powers of Ten. [35 min.; dividida en YouTube en cuatro partes]. Originalmente concebida para salas IMAX es del año 1996 y está narrada por Morgan Freeman. (¡Gracias, Eduardo!) Actualización (5 de agosto de...
Snow And The Seven será una nueva adaptación de Blancanieves y los Siete Enanitos. Tendrá como director a Francis Lawrence (el de Constantine) y como protagonista a Natalie Portman (Padme en Star Wars I-III). Yuen Woo-Ping participará como director de coreografía (hizo...
Ya en el Comic-Con de 2005 se especuló con la posibilidad de que la serie Futurama volviese en forma de película —y poco más tarde se convirtió en una posible nueva temporada. Ahora según leo en TV Squad (vía del.icio.us/popular) que parece...
Por Nacho Palou -
31 JUL 2007
Qué largas se van a hacer las esperas de algunas de las prometedoras películas que se estrenarán el año que viene… Aquí está el teaser trailer de Batman: The Dark Knight a modo de migajas de adelanto: En BlogDeCine y Uruloki hay...
Un amable lector nos pasa un enlace a Blade Runner - Edición Especial 25 Aniversario, donde además de confirmar la existencia de Blade Runner: The Ultimate Collection, ese impresionante maletín al estilo del de Deckard con cinco discos y algunos goodies más,...
Ejem… Que conste que sólo voy a The Pirate Bay «por leer los artículos» y no por sus torrents. La sorpresa de hoy ha sido ver que también ellos se han simpsonizado a modo de homenaje, cambiando el logo de su...
Y con su imparable poder han colocado Los simpson, la película como una de las mejores películas de todos los tiempos... antes de que se haya estrenado. (Divertida frase de HogWild) En el momento de escribir esto aparece en el Top 250...
Por Nacho Palou -
27 JUL 2007
La portada de StarTrek.com de hoy abre con La tipografía clásica en letras estrelladas sobre fondo blanco. De momento hay que confirmarse con esta imagen y con que la fecha de estreno de la undécima película de la saga será el día...
La película de Los Simpson es divertida. Te ríes y se pasa volando. Merece la pena verla. Después de mucho tiempo siguiendo los rumores, noticias y trailers varios de la película de Los Simpson, ayer tuvimos la suerte de asistir invitados...
Por Nacho Palou -
26 JUL 2007
Boston Legal es una de las series que sigo habitualmente por la cadena FOX —donde se está emitiendo la segunda mitad de la segunda temporada de las tres que hay hasta ahora. Cuenta los casos y peripecias de un grupo de abogados...
Por Nacho Palou -
4 JUL 2007
Star Trek es la mejor serie de culto de la historia. No está mal que se reconfirme de vez en cuando. Por otro lado, las diez primeras series del Top 30 actualizado de la revista TV Guide (lo revisan de vez en...

Science Fiction Movie Paper Craft Gallery es una galería de maquetas recortables de papel bastante conseguidas y que se pueden descargar para recortar y construir. Hay modelos increiblemente detallados como el Halcón Milenario o los AT-AT de las nieves que alguna...
¡Buenas noticias para los fans de Padre Made in USA! Próximamente comenzará a emitirse en EE.UU. la tercera temporada, y parece seguro que habrá una cuarta que se emitirá a finales del año que viene. A ver qué tal se portan con...
Por Nacho Palou -
26 JUN 2007

Este año, más exactamente el 21 de agosto, se cumplirán 25 años del estreno de Blade Runner. Qué decir de la película de culto de la ciencia ficción que para muchos (me incluyo) es la número uno indiscutible de todos los...
Zattoo sirve para ver la tele en directo desde el ordenador, siempre que tengas una conexión decente a Internet. Basta registrarse, descarga el programa, y elegir el canal que quieres ver. Así de simple. Es la tele de siempre pero que puedes...
En alta resolución, gran detalle y en lo que puede considerarse «versión oficial»: Mapa de la galaxia de Star Wars: Se publicó en el primer número de The Official Star Wars Fact File en 2002 y luego fue republicado en el Star...
Futurama Panoramas son panorámicas de secuencias de la serie de animación Futurama obtenidas juntando capturas estáticas de los espisodios de la serie. (Vía Reddit.)...
Por Nacho Palou -
7 JUN 2007
Con ciertas similitudes al Viaje a la Luna de Méliès, carteles con diálogos y banda sonora al piano, esto es lo que los fans han recreado imaginando un Star Trek mudo en blanco y negro, cincuenta años antes de lo debido: (Vía...
En la carrera entre los estudios empeñados en limitar lo que los usuarios pueden hacer con los discos que compran y los usuarios dispuestos a hacer con esos mismos discos lo que ellos estiman oportuno y no lo que los ejecutivos de...
Hoy se celebra el día del Orgullo Friki con eventos y fiestas (frikis, por supuestos) a lo largo y ancho de de Internet y del MundoReal™ La fecha se hace coincidir con el aniversario del estreno de la primera película de la...
Por Nacho Palou -
25 MAY 2007
(spoiler = destripar la trama o el final de una película / serie / novela / lo-que-sea) Por cierto que una de las camisetas que más gracia me han hecho siempre siempre por algún motivo que desconozco es esta: Honk if you...
Por Nacho Palou -
23 MAY 2007
El micrositio Travels To The Edge with Art Wolfe parte del Digital Learning Center de Canon contiene explicaciones (en vídeo y texto, en inglés) de las técnicas y el equipo que utiliza el fotógrafo de naturaleza Wolfe para hacer las fotografías...
Por Nacho Palou -
19 MAY 2007
Cuando hace poco más de dos semanas se publicó la clave que permite decodificar todos o prácticamente todos los títulos publicados hasta le fecha en formato HD-DVD e incluso algunos en formato Blu-Ray estaba claro que sólo era una cuestión de tiempo...
Desde el departamento de cosas-extrañas-que-recopila-la-gente llega este vídeo que sencillamente un montaje con los últimos diez segundos de cada episodio de la primera temporada de Star Trek: La Nueva Generación [YouTube, 10 min., inglés], un tanto extraño pero curioso de ver (musiquilla...
Transformers: Trailers es un adelanto «exclusivo» en varios formatos de la futura película «con actores reales» de los Transformers, dirigida por Michael Bay. Efectos 3-D por ordenador por un tubo y bastante resultones por los que se ve. Se estrena el...
Este año se cumplen 25 años del estreno de Blade Runner, la película #1 de nuestro Top 10 de Películas Geek, motivo por el que la Warner había anunciado su reedición en DVD, y si los detalles que se han filtrado de...
En unos días (el próximo domingo 20) la serie de Los Simpson cumple 400 episodios —episodio 22 de la termporada 18. Recientemente también cumplieron 20 años en antena, desde que comenzaron a emitirse como episodios cortos en 1987. Además de la...
Por Nacho Palou -
17 MAY 2007
Según se puede leer en El final de la serie 'Perdidos' llegará en 2010 nuestra querida serie sobre los supervivientes del Vuelo 815 llegará a su final en el episodio 119 al haber alcanzado los productores de la serie y la cadena...
Más de una vez te habrá parecido que casi a la vez o muy cercanas en el tiempo se estrenan dos películas distintas pero de parecido argumento: Volcano y Dante’s Peak en 1997; Armageddon y Deep Impact, Hormigaz y Bichos, en 1998:...
Por Nacho Palou -
4 MAY 2007
Los detalles son un poco hardcore como para seguirlos a fondo si no estás muy interesado en el tema, pero en los foros de Doom9 se está discutiendo un nuevo crackeo del sistema de protección AACS que haría innecesarias las claves de...
Alguien se entretuvo en hacer esta interesante recopilación: IMDB's Top 50 Independent Films, que recopila las 50 películas de cine independiente que aparecen en lo más alto de la Internet Movie Database (IMDB) marcadas como independientes, según los votos promediados de los...
Estuve viendo los dos primeros episodios de Star Trek: New Voyages, una iniciativa de un grupo de fans, actores y técnicos para que los viajes de la nave espacial más famosa de la ciencia ficción no acaben nunca. Tal y como...
(Vía el mismísimo Darth Vader desde Twitter) La dura vida de Darth Vader en las calles. Malas noticias, mi señor. Linea Caliente Friki y otros vídeos frikis de Star Wars. Darth Vader, ese tipo, jugando a los bolos. PowerPoint es Malvado,...

Una de las parodias de anuncios televisivos de los pantalones vaqueros Bad Idea («Mala Idea») que por fin ha aparecido en YouTube; estaba en mi lista personal de los mejores anuncios humorísticos de todos los tiempos. Es necesario saber un poquillo...
Films that have been considered the greatest ever es una recopilación en la Wikipedia (en inglés) de películas de cine que según diversas votaciones de críticos, público o expertos han sido consideradas como «la mejor película de todos los tiempos». La lista...
¡Feliz cumpleaños! El 19 de abril de 1987 Los Simpson comenzaron a emitirse en forma de cortos y como parte del programa «The Tracey Ullman Show». Un par de años después, en diciembre de 1989 se convirtió en la serie que conocemos...
Por Nacho Palou -
19 ABR 2007
Llevamos años oyendo a los responsables de los grandes estudios quejándose de las copias piratas de sus discos, de que si Internet esto o que si Internet aquello, años sufriendo su empecinada lucha contra las redes P2P, años oyéndoles llorar que si...

En la wikipedia está la lista de las 267 maldades de Earl, en referencia al protagonista de Me llamo Earl (My Name is Earl) una de las más divertidas y entrañables series de humor que he visto en los últimos tiempos. El...
En la cadena Cuatro llevan un tiempo anunciando el próximo estreno de Brainiac, un programa “en el que la ciencia se lleva al extremo” y que estará co-presentado entre otros por Javier Sánchez de Internet a Mano e Interneox. Brainiac se produce...
Por Nacho Palou -
12 ABR 2007
Who Wrote The Bible? (2004). Se trata de un documental producido por el canal británico Channel 4 que explora el origen de las sagradas escrituras de las religiones cristiana y judía. El presentador es el Doctor Robert Beckford, un creyente y...
La sección Moving Image Archive de Archive.org es un recurso fantástico que almacena a día de hoy 61.028 películas, definición que abarca «imágenes en movimiento» de todo tipo, desde largometrajes tradicionales que están libres de derechos a documentales, animaciones por ordenador y...
Spellbound (2002) Un documental de Jeffrey Blitz. Nominado para el Óscar. Web oficial: SpellboundMovie.com [Flash]. Llevaba tiempo queriendo ver este documental y finalmente lo pude hacer ayer. Es la historia de ocho niños que compiten en el campeonato nacional de deletreo...

Los mejores sketches de Monty Python (en el Teatro Alfil, Madrid). Una producción / adaptación de Imprebís / Yllana con Carles Castillo, Richard Collins-Moore, Antonio de la Fuente, Fernando Gil, Diego Molero y Juan Cañas. Una amiga nos invitó a ayer...
Esto es mejor que las Manos dibujando de Escher: Cómo Homer Simpson se dibuja a sí mismo: Y no sé por qué… mi pelo y mis orejas forman una M y una G (Vía ForoFriki.com)...
Grandes momentos de los años sombríos: ¡Es una bruja! de los Monty Phyton en Los Caballeros de la Mesa Cuadrada y sus Locos Seguidores, cómo no. (Vía Wakai.)...
Con el Gran Premio de Australia comienza este viernes 16 la Temporada 2007 de Formula 1, en el circuito de Melbourne. La carrera es el domingo día 18 a horas intempestivas: para verlo en directo desde España (hora oficial) habrá que levantarse...
Por Nacho Palou -
14 MAR 2007
En el episodio de Cazadores de Mitos que emitieron ayer en Discovery Channel (Episode 59 -- "Crimes and Myth-Demeanors 2") el equipo de cazadores intentó romper medidas de seguridad electrónicas de varias formas. Algunas funcionaron y otras no, pero fue un episodio...
Por Nacho Palou -
9 MAR 2007
Igual que Alvy, ya hace algún tiempo que vengo usando los feeds RSS de Mininova y sitios similares como Dime A Dozen o U2Torrents para ver qué aparece en estos sitios y decidir qué me interesa descargar, pero eso hace que a...

Chuck Workmanm ganó el Oscar al mejor cortometraje en 1986 con Precious Images. Se trata básicamente de cientos de fragmentos de las grandes películas de la historia del cine, elegidos cuidadosamente y montados sobre algunas bandas sonoras conocidas. Existe una versión...

The Philosophy of Time Travel es una versión web «escaneada» de algunas páginas del libro del mismo título de Roberta Sparrow, uno de los personajes de Donnie Darko, película de culto donde las haya. Tiene unas pocas páginas y misteriosos textos para...
Hace ya meses que Blockbuster desapareció en España, ahora Arturo intenta recopilar en ¿Qué fue de tu Blockbuster? una lista que descubra en qué se reconvirtieron todos los locales que otrora dombinaban el alquiler de vídeos y DVDs. De momento, hay gente...
Rememorando un diálogo clásico de Wayne's World: Benjamin: Tenemos un contrato con el patrocinador, haciéndole concesiones, como por ejemplo, aparecer en el programa... Wayne: Benjamin, creo que tú y yo vemos las cosas de un modo diferente. Con contrato o si sin...
Una fiesta de cumpleaños que acaba mal: Stabbing at Leia's 22nd Birthday [YouTube, 1:24 min.] (Vía YesButNoButYes.)...
Por Nacho Palou -
22 FEB 2007
El Número 23 es la nueva película de Jim Carrey, dirigida por Joel Schumacher y trata sobre un tipo que está obsesionado, literalmente, con el número 23. Qué extraño eso de que la gente se obsesione con ciertos los números, en fin…...
Un nuevo trailer de la película de Los Simpson que se estrena este verano (a finales de julio):Probablemente en breve estará en español y/o subtitulado al menos.Previo de la película de Los Simpson (en español)Previo de la película de Los SimpsonTeaser de...
Por Nacho Palou -
20 FEB 2007
Llevaba algún tiempo apuntado en el programa de beta testers de Joost, antes conocido como The Venice Project, esperando a que saliera una versión para Mac OS para poder probarla, lo que por fin ocurrió este fin de semana con la publicación...
Zeroes, una divertida parodia de las promos de Heroes, ahora con subtítulos en español [YouTube 1:45]:(Vía Zona Heroes, subtítulos de CORNISA.net.)...
Encontré este clásico moderno en formato documental. Está basado en No Logo: el poder de las marcas, la obra de Naomi Klein sobre las marcas comerciales, los abusos de la publicidad y la globalización. Es una especie de larga entrevista a...
Dejemos de lado el hecho de que los usuarios no los queremos y que como mucho los toleramos si no son demasiado restrictivos y que la industria debería tomar nota e ir por otro sitio, pero según se puede leer en Blu-Ray...

Tras comprobar que el blog en el que troleaba el descerebrado de Randal en Clerks II existe realmente en WheelieBlog.org , qué mejor que rememorar esa gran escena de humor negro moderno y friki: Randal: Je, je, je… Estoy dándole caña a...
Esta semana pude por fin ver completa Children of the Stones, que en España se llamó Los chicos de Stonehenge y se emitió a finales de los 70 o principios de los 80, tal y como contaron detalladamente hace semanas en La...
Por si queda todavía alguien interesado en Lost ayer se acabó la sequía de capítulos de la serie más desconcertante de la televisión con la emisión del capítulo 7 de la tercera temporada (“Not in Portland”). Parece que la serie acabó encontrándose...
Por Nacho Palou -
8 FEB 2007
Algunos nos habéis escrito preguntando por el regreso de la venerada serie The I.T. Crowd que desapareció después de seis episodios y sobre la que durante todo el año pasado se estuvo especulando iba a volver con nuevos episodios, primero a finales...
Por Nacho Palou -
7 FEB 2007
Cuando en 1966 Gene Rodenberry y su equipo rodaron The Cage, el episodio piloto de Star Trek, realizaron pruebas de maquillaje y filmación a la chica que interpretaba el papel de la esclava de Orión, «una mujer a la que ningún ser...
Star Trek: Enterprise Guidance Control es un completo y detallado plano del Enterprise 1701-D, cubierta a cubierta, con explicaciones sobre cada uno de los detalles de la nave protagonista de Star Trek: La Nueva Generación. En total hay 42 cubiertas. La...

A ver qué predice Punxsutawney Phil este año. Actualización: Phil no ha visto su propia sombra este año, de modo que la primavera llegará pronto....
Wanfry me escribió para comentarme algo sobre una de las anotaciones que hice sobre Blade Runner en la que se explica algo sobre La Inmortal [requiere Java], que es ni más ni menos que la partida de ajedrez que se juega en...
Llevo vistos los primeros episodios de la serie Dexter que se estrenó el pasado noviembre en EE.UU. De entrada me resultó un poco extraña y casi incómodo (por un rato pensé que no iba a seguirla) pero al final me enganchó y...
Por Nacho Palou -
16 ENE 2007
Una compilación de impresionantes máquinas de Rube Goldberg creadas para el programa educativo infantil PythagoraSwitch de la NHK, The best of Pitagora Suicchi [YouTube, 12:54]: Se utilizan como cortinillas al principio y final del programa y entre secciones. (Gracias, Miguel Ángel.) Actualización...
Ratónpolis. David Bowers y Sam Fell. Aardman Animations y DreamWorks Animation, 2006. El ratón Roddy es la mascota de una niña que vive en una magnífica casa de Kensington, uno de los mejores barrios de Londres. Como tal, tiene todos los bienes...

¡Qué buena película! El Truco Final (The Prestige) combina una historia de rivalidad mortal entre dos ilusionistas de finales del siglo XIX con misterios inexplicables, tan mágicos como sus trucos. Uno de nuestros idolos, el «inventor del siglo XX», Nikola Tesla...
Mañana sábado a las 11.24 de la mañana emiten el primer episodio de “El coche fantastico” en la cadena Cuatro. (Vía Motorpasión.)...
Por Nacho Palou -
12 ENE 2007
Arthur y los Minimoys. Luc Besson. EuropaCorp - Avalanche Productions - Apipoulaï Prod, 2006. Web de la película. El abuelo de Arthur lleva casi tres años desaparecido, lo que coloca a su abuela en una situación económica complicada, tanto que el día...
Back to the Future Timeline es un curioso gráfico de un artículo de la Wikipedia donde se puede ver un gráfico de la línea temporal (timeline o cronología) que siguen los personajes de las tres películas de la legendaria trilogía Regreso al...
Hoy miércoles a las 21h00 en Discovery Channel (España) emiten el documental Los primeros vuelos del Airbus A380.[El documental] recoge todos los datos técnicos de este superavión, que tiene una capacidad para 550 pasajeros y está concebido para realizar vuelos de larga...
Por Nacho Palou -
20 DIC 2006
Si ya estás irremediablemente enganchado a Héroes, la serie revelación de la temporada, y llevas muy mal lo de tener que esperar hasta el 22 de enero para ver cómo siguen las aventuras de sus protagonistas igual puedes paliar un poco tu...
Mientras esperamos al estreno de la nueva temporada de The IT Crowd el próximo 5 de enero -es casi como un regalo de reyes- aquí tienes un vídeo con escenas no emitidas de la primera temporada, subtitulado en español: The IT Crowd...
La siguiente historia tiene lugar siete meses después de la quinta temporada de 24, 24 - Season 6 Prequel (Official) [YouTube, 10:38]: (Vía Chica de la tele.) Trailer de la sexta temporada de 24, apenas unos segundos para ver lo que nos...
Bare Metal Bender Wind-up — ¿A quién no le encanta un robot sarcástico, sabiondo, fumador, bromista, egoísta y bebedor? Bender es el hijo número 1729 de su madre. A su padre lo mató un abrelatas. Fue a la universidad, se especializó en...
Por Nacho Palou -
30 NOV 2006
La Singularidad Desnuda recupera en una pequeña reseña una de esas mini-series que los que tenemos treintaymuchos años vimos en televisión cuando éramos muy, muy pequeñitos y que nos dejó impactados: Los Chicos de Stonehenge (Children of the Stones). Al parecer la...
Después de la parada tras el sexto capítulo de la tercera temporada de Perdidos que durará hasta principios del año que viene, en IGN Entertainment han recopilado los 50 misterios o cabos sin atar más importantes de la serie en IGN's Top...
Revisar los episodios de Mazinger Z es toda una experiencia. En uno de los primeros, cuando el poderoso ejército de brutos mecánicos del Doctor Infierno comienza a sembrar el caos y la destrucción, la joven Sayaka se pregunta: Mmmm… Ese «Doctor Infierno»,...
Ayer vi que el Canal de Historia, sin duda uno de mis favoritos (disponible en plataformas digitales) emitirá el próximo domingo 26 de noviembre a las 15.00 el documental La buena fortuna de los García-Pelayo que trata sobre la legendaria familia García-Pelayo...
Parece que no somos los únicos a los que no les salen las cuentas de la Televisión Digital Terrestre, pues por lo visto Telecinco solicita un «plan Renove» para la televisión digital terrestre. Temen que a menos que el Ejecutivo ponga en...
Free MythBusters Episodes recopila episodios, en inglés sin subtítulos, del programa Cazadores de mitos que tanto nos gusta por aquí. Están en YouTube y Google Vídeo y la lista es un poco antigua y carece de mantenimiento, de modo que puede suceder...
Por Nacho Palou -
21 NOV 2006
Héroes (Heroes, 2006) de Tim Kring, es la nueva serie de moda de la NBC que, vistos los primeros episodios vía eMule, promete un montón. Tiene el toque misterioso de Lost y un poco de Expediente X, a ratos parecen historias de...

Una nueva colección de tomas falsas de nuestros admirados Cazadores de Mitos. (Vía MetaFilter.) Relacionados: Cazadores de mitos - los experimentos «perdidos» Los Cazadores de Mitos y la Guerra de las Galaxias Arenas movedizas y Disparando balas al agua Cazadores de...
Salva de Resistance is Futile descubrió una de las más divertidas listas frikis de los últimos tiempos, El alfabeto Lebowski:El alfabeto Lebowski – Una de las pelis de culto con las que más he reído es El Gran Lebowski. El Nota es...
Según se puede leer en HMC EXCLUSIVE Interview with GEORGES JEANTY (ojo, el sitio usa frames, así que su página principal es Hellmouthcentral.com) a partir del próximo mes de marzo comenzarán a publicarse los cómics que se corresponden con lo que sería...
Totalmente adecuado para la noche de Halloween, The 100 scariest movie scenes recoge las cien escenas más terroríficas de la historia del cine con sus correspondientes capturas de pantalla y algunos vídeos. Traduzco el Top 10 de la lista, y ojo, que...
Hace algo menos de un año empezaban oficialmente en España las emisiones de TDT con el objetivo de que el apagón analógico, momento en el que ya ninguna emisora podrá emitir en analógico, se produzca en 2010, adelantándonos en dos años a...
Para cuando tengas una horita libre, un documental de la BBC sobre un juego que a lo mejor te suena y al que a lo mejor jugaste alguna vez, Tetris, y su autor, Alexey Pazhitnov: BBC >> Tetris - From Russia With...
Ojo, esta anotación contiene spoilers de la quinta temporada. La aparición de los chinos al final de la quinta temporada de 24 nos permite suponer por dónde van a ir los tiros de la sexta temporada, aunque como ha quedado demostrado en...
Ya se puede ver en Sony BRAVIA - The Advert [QuickTime, 70 segundos, 5 MB] el nuevo anuncio de la gama de televisores Sony Bravia, que se hizo mundialmente famosa con el anuncio de las pelotas saltarinas corriendo por las calles...
Empty your mind. Be formless, shapeless. Like water. You put water into a bottle and it becomes the bottle. You put in a teapot, it becomes the teapot. Water can flow, or it can crash. Be water, my friend! Este es el...
¡Buenas noticias! La serie The IT Crowd que tantas mandíbulas ha desencajado en los miembros de la comunidad geek (y no-geek) volverá el próximo 5 de enero (¡gran regalo de Reyes!) según leo en Chica de la tele que lo leyó en...
Por Nacho Palou -
10 OCT 2006
Mat! de Other Films nos envió esto que suena interesante: 8 BIT es un documental de realización totalmente independiente y con vocación artistica (se estrenara el proximo 7 de Octubre en el moma de Nueva York) que se adentra en la relación...
Otra serie de animación hilarante es Padre de Familia (Family Guy), de Seth MacFarlane que es también autor de Padre Made In USA (American Dad) mencionada por aquí hace no mucho. Padre de Familia es anterior en el tiempo y actualmente va...
Por Nacho Palou -
3 OCT 2006
¡Posibles spoilers! Tal vez si no has visto las dos temporadas completas de la serie Perdidos / Lost no deberías mirar el Map of the Lost Word, un mapa gigante de (¡ojo!) 7200 x 7200 píxeles (51 Mpx) en un archivo de...
Por Nacho Palou -
2 OCT 2006
(Ojo: ligeros spoilers, pero nada super-relevante.) Llevo un par de meses viendo Smallville desde el principio. Que conste que no he visto nada de Lois & Clark y que la reciente Superman Returns me pareció una basura. Pero Supermán es Supermán y...
Realmente es difícil describir… «esto»… con palabras: El polinomio de Shaw-Basho y nuestros queridos 4, 8, 15, 16, 23, 42, explicado en Gaussianos, un altamente recomendable blog colaborativo sobre matemáticas que descubrí hace poco y es genial. Lo más friki del asunto...

Clerks II. Kevin Smith. Secuela del clásico de culto Clerks, situada diez años después, con los mismos protagonistas perdedores de toda la vida que ahora tienen un mac-job y trabajan vendiendo hamburguesas. Tras algunas pelis buenas y otras menos buenas, Kevin Smith...
Con Gustavo como Neo, Peggy como Trinity y Gonzo como Agente Smith. Lo han hecho tres estudiantes de 3-D de Kentucky. (Vía MetaFilter.) Relacionado: The Matrix, la original de los hermanos Wachowski....
YouTube, el conocido sitio para compartir vídeos, acaba de anunciar un acuerdo con Warner Music mediante el que podrá utilizar legalmente contenidos propiedad de esta a cambio de una parte de sus ingresos por publicidad: YouTube in 'landmark' music deal. Así, vídeos...
¡Ojo! Montones de spoilers si no has visto la segunda temporada de Perdidos, pero aquí está un avance de la tercera temporada, a punto de estrenarse en los Estados Unidos:Actualización: Fluimucil nos pasa el enlace al mismo vídeo con subtítulos en español....
Más o menos cuando IBM sacaba al mercado el primer disco duro de la historia en España comenzaban las emisiones de televisión, y para conmemorar estos 50 años Pixel y Dixel se han dedicado a recopilar casi 200 vídeos disponibles en YouTube...
13 de septiembre de 1999: Una inesperada explosión en la luna envía violentamente a la base lunar Alpha, al comandante John Koenig, a la doctora Helena Russell, y a 309 hombres y mujeres fuera de órbita hacia lo más oscuro del espacio...
La tercera temporada de Battlestar Galactica se estrena en los Estados Unidos el próximo 6 de octubre y para ir calentando motores la NBC ha creado una serie de diez «webisodios» titulada Battlestar Galactica: The Resistance que en principio sólo se deberían...
4, 8, 15, 16, 23, 42… 4, 8, 15, 16, 23, 42… ¡Super-spoiler! (Para los que no hayan visto la segunda temporada todavía) El significado de los Números Chungos [YouTube] es un vídeo en inglés de unos seis minutos que recopila los...
Bastante silenciosamente, hoy se celebraba el 40º aniversario de la primera emisión de la Serie Original de Star Trek. Cuarenta es un número enorme de años que sirve como recordatorio de que casi todos los que estamos leyendo esto ni siquiera habíamos...
Una juez absuelve a J.M. en el juicio al que lo llevaron distintas entidades por descargar material audiovisual de Internet, además de ofrecerlo e intercambiarlo con otros usuarios mediante chats. Dado que siempre lo hizo sin ningún ánimo de lucro, la sentencia...
Tarantinospain es un nuevo blog sobre todo lo que rodea a Quentin Tarantino y sus películas, que a pesar de llevar poco tiempo está lleno de algunas historias jugosas. Resulta que existe, por ejemplo, un videojuego sobre Reservoir Dogs, película de la...

La primera vez que los Microsiervos nos reunimos en el MundoReal™ para algo que no fuera una de nuestras cumbres microsiervas fue cuando Javier Sánchez y sus colaboradores nos invitaron a participar en Internet@Mano, el programa sobre Internet que hacían para...
¡Más todavía! Según el artículo Galactica Gets Dark(er) in Season Three con declaraciones de Edwars James Olmos (protagonista) y Ron Moore (productor) la tercera temporada de Galáctica, Estrella de Combate (ya mencionamos el trailer aquí) será «más oscura todavía». ¡En el nombre...
Con motivo del superpremio en el concurso de televisión Pasapalabra hice un llamamiento a ver si alguien tenía grabado aquel programa de ¿Quiere ser millonario? (50x15) en el que un concursante se llevaba en plan torero el gran premio: 50 millones de...
SciFi Channel ha confirmado estos días que no renovará Stargate SG-1, una de las series de nuestro Top 10 de series geek, cuando termine la décima temporada que actualmente se está emitiendo en los Estados Unidos: SG-1 Ends Run; Atlantis Back. En...
Solo ante el subtítulo. Experiencias de un subtitulador. es un antiguo pero interesante artículo sobre los problemas añadidos que suponen los subtítulos a los doblajes, contados en primera persona y con ejemplos. Como dice Xosé: Nunca falta en los congresos sobre traducción...
Cuando los ejecutivos de la FOX decidieron cancelar la serie Firefly seguidores de esta de todo el mundo pusieron el grito en el cielo e intentaron organizarse para salvarla, igual que ha sucedido en múltiples ocasiones con otras series canceladas. La diferencia...
Curiosidades Blade Runner demuestra que por mucho que hayas visto la pelicula y leído libros y FAQs, siempre queda algo nuevo por descubrir, como por ejemplo: El ordenador del Spinner de Gaff muestra la misma secuencia que Madre, el ordenador de la...
Esto sí que es un pedazo de teaser adelantado, pero menos da una piedra. Aunque sea para dentro de… ¡dos años! A los trekkies sólo ver el logo de la Flota Estelar ya nos pone a tono, así que… Se sabe que...

JC nos envió un enlace a una antigua pero interesante película, el anuncio del Audi A6 basado en imágenes M.C. Escher, figuras imposibles y algunas variaciones de sus obras y otras escenas sorprendentes. Es delicioso de recordar de vez en cuando,...
Antonio de MediaXpress, que también es fan de la serie, me escribió para contarme que se ha confirmado que el próximo 9 de septiembre de 2006 se pondrá a la venta la segunda temporada de Doctor en Alaska en DVD en castellano,...

Tyrell y J.F. Sebastian juegan una partida de ajedrez en Blade Runner, que acaba terminando Roy Batty cuando va a visitar a su «creador». En el FAQ de Blade Runner se le dedica un apartado especial a ese detalle. Al parecer (aunque...
CSI: Miami, contra mi propia opinión, ha sido nombrada la serie de televisión más popular según un estudio llevado a cabo en veinte países: CSI show 'most popular in world' El «top ten» incluye algunas telenovelas –«telenovela» debería ser una categoría distinta...
Por Nacho Palou -
6 AGO 2006
Si no ha habido cambios y contraprogramaciones de última hora esta noche a las 22:00 en Antena 3 Jack Bauer comenzará el quinto de esos días tan complicados que se le presentan a veces en los que no tiene ni tiempo para...
Treinta y tres imágenes y sencuencias diferentes componen la apertura de noventa segundos de los títulos de crédito con los que empieza cada capítulo de Star Trek: Enterprise. Naturalmente, tras verlas repetidas veces uno se pregunta qué es qué y quién es...
En realidad no del todo, porque habrá un retén de mantenimiento por si alguna vez hace falta volver a utilizarlo, pero a todos los efectos el ejército de los Estados Unidos ha decido desactivar el centro de operaciones de Cheyenne Mountain y...
Seguro que recuerdas el precioso anuncio de los televisores Sony Bravia filmado en San Francisco en el que 250.000 pelotas saltarinas caían por las cuestas de la ciudad al ritmo del tema Heartbeats de José González. Pues Sony está trabajando en un...
Mercè Molist acaba de publicar en versión libre y original dos artículos que en su momento escribió para un par de revistas en los que trata del tema de las redes P2P, su situación legal, quienes están de cada lado, etc, explicado...
Hoy, tres semanas después de su publicación en el Boletín Oficial del Estado, entra en vigor la nueva Ley de Propiedad Intelectual, aprobada por unanimidad por nuestros representantes políticos aún a pesar de que va de manera bastante evidente en contra de...
Si todavía no has visto por otros medios la quinta temporada de 24, una de nuestras series favoritas, Antena 3 la estrena en España, si no hay cambios, el próximo 6 de agosto, domingo, a las 22:00. El plan es emitir tres...
No tiene que ver con el Teaser de la película de Los Simpson sino que son algunas secuencias sueltas aún esquematizadas de la película de Los Simpson que se estrenará el año que viene (exactamente dentro de un año por cierto, el...
Por Nacho Palou -
27 JUL 2006
Cars. John Lasseter y Joe Ranft. Disney • Pixar, 2006. Web de la película [necesita Flash]. Rayo McQueen está a punto de hacer historia en la Copa Pistón y convertirse en el primer novato que la gana, pero en la última carrera...
La avalancha ya ha comenzado. En 2007 habrá nuevas historias del universo Babylon 5, una de las series de culto de la ciencia ficción más impresionantes de las últimas décadas. Que el regreso sea de la mano de su creador, Michael «jms»...
Me encanta la serie de animación Padre Made in USA (el título original es Amercian Dad!) que es de los mismos productores de la más conocida Padre de Familia (Family Guy) y muy similar a esta, aunque Padre Made in USA cuenta...
Por Nacho Palou -
24 JUL 2006
Esta Transcripción en Castellano del Guión de Blade Runner es una nueva traducción completa de la primera versión 1982, más conocida como «US Theatrical Release». Contiene el voice-over o voz en off del narrador y también el Happy Ending o «final feliz...
54 iconos de la serie Lost (Perdidos) para Mac diseñados por Lard Designs. Inapropiada cantidad porque deberían haber sido 42, pero bueno. Aun así están muy bien. Incluyendo la carpeta con la estatuilla de la virgen, que debe ser la de «ayuda...
Por aquí debe haber mucho fan de Doctor en Alaska. Me di cuenta de un montón de referencias cada vez que las citas de Chris Stevens desde la K.OSO aparecen como frase del día en el blog. Para los interesados, casi todas...
Hoy se estrena en los Estados Unidos Clerks 2 [IMDB], y con tal motivo Comic Book Resources ha publicado The Clerks II Interviews, una serie de entrevistas con Kevin Smith, el director, y con los actores principales:Brian O'Halloran and Jeff Anderson (Dante...
Sobre el papel la idea de poderte descargar DVDs con el visto bueno del estudio titular de sus derechos no parece mala, así que el acuerdo al que han llegado Universal y Telefónica para que esta distribuya películas de la primera a...
Apenas dura un parpadeo, pero menos da una piedra: Mini-trailer de la tercera temporada de Galáctica: Estrella de Combate. 30 segunditos en YouTube. Actualización: Freddie de Cristalab nos apunta a esta otra versión, Battlestar Galactica Season 3 Preview [YouTube 1 min. 15...
Desde que descubrí la unidad de energía en que se mide la carga de los desfibriladores de reanimación no puedo evitar fijarme más en lo que dicen los médicos cada vez que lo usan en alguna película. En All Things (episodio 7ABX17...
Todo lo que necesito saber sobre la vida lo aprendí de Star Trek: Hay que buscar nuevas vidas y nuevas civilizacionesNo interferir es la Directriz PrincipalMejor mantener el phaser en «aturdir»Los seres humanos son bastante ilógicosEl pinzamiento vulcano de la muerte no...
Siguiendo con la semana de preestrenos en AXN hoy a las 22h20 GMT+2 el canal preestrenará la 6ª temporada de CSI (La Vegas) que comenzará a emitirse regularmente en septiembre tanto en esta cadena como previsiblemente en Telecinco:C.S.I. 6ª Temporada –La sexta...
Por Nacho Palou -
11 JUL 2006
Ralph McQuarrie es (aparte de George Lucas) el único que podría decirle aquello de «yo soy tu padre» al propio Darth Vader:Ralph McQuarrie Bio – Uno de las más importantes aportaciones de McQuarrie a la saga de La Guerra de las Galaxias...
Por Nacho Palou -
10 JUL 2006
Como comentaba Nacho el otro día en el meme sobre series de televisión esta noche a las 22:37 Cuatro empieza a emitir LAX, una serie sobre el aeropuerto de Los Angeles y sus empleados, con lo que en principio podría resultar atractiva...
Buffy: The Vampire Slayer, The Unaired Episode [YouTube, 25 min.] es al parecer el episodio piloto inédito que se rodó para probar lo que pasaría a convertirse en una de las mayores series de culto de finales de los noventa: Buffy Cazavampiros....
A pesar de lo que piensa DkT por aquí no tenemos ninguna política contraria a los memes ni nada parecido… todo lo más los procrastinamos hasta el infinito, así que aquí va mi lista de «series que vemos actualmente en TV o...
Increíble, pero existe: Hollywood Math and Science Film Consulting – Somos una empresa que garantiza que todos los detalles técnicos y jerga de los guiones de sus películas suenen creíbles, ya sean de temas matemáticos, científicos o médicos. Nos encargamos de que...
Nacho Escolar escribe en su artículo Canon digital: el unánime absurdo, entre otras cosas, acerca del hecho de que la recién aprobada Ley de Propiedad Intelectual establece por ley (antes era un acuerdo entre los fabricantes de soportes y la SGAE) un...
The Real Da Vinci Code. Kashaf Chaudhry (2005). Estuve viendo ayer este documental, de casi dos horas, emitido por Channel 4, que está disponible en Google Video (para ver o descargar: The Real Da Vinci Code). Es una especie de aproximación científica...
Aunque aún queda más de un año para el estreno (4 de julio de 2007), ya está online el anuncio inicial de la película Transformers, para ir abriendo boca –luego cuando podamos verla ya vendrá la decepción, aunque siendo Michael Bay el...
Por Nacho Palou -
30 JUN 2006
En torno al DVD se reúnen, divididos en dos grupos, el mayor número de descerebrados y bobos escogidos entre toda la humanidad. Un grupo es el de los fabricantes de aparatos y el otro el de los editores de las películas.Amén. Carlos...
Si ya teníamos una canción para geeks enamorados, ahora tenemos un corto, real como la vida misma, sobre los frikis y el amor, DVD, que se puede ver desde la página de DVD. (Bigordos vía Pixel y Dixel y algunos otros sitios...
A raíz de la recientemente aprobada reforma de la Ley de Propiedad Intelectual uno de los conceptos que parece haberse modificado es el de «copia privada», que hasta ahora permitia copiar y compartir música, películas y otros materiales para uso privado mientras...
Vecinos Invasores. Tim Johnson, Karey Kirkpatrick. Dreamworks Animation / Paramount Pictures, 2006. Web de la película [necesita Flash]. R.J. es un mapache que a causa de su codicia se ve metido en un buen lío con Vincent, un oso con muy malas...
No es la primera vez que circulan rumores al respecto, pero esta vez parece que va en serio y que el Top #1 de nuestra lista de series geek vuelve para al menos una temporada más que se estrenará en 2008. Tanto...
A finales de abril y principios de mayo se produjeron unos cuantos anuncios de productoras de televisión y cine y discográficas que empezaban a experimentar con descargas por Internet de música y programas de televisión, ya fuera mediante webs y reproductores propios,...
Una serie de empresas que compartían ISP con The Pirate Bay cuyos servidores fueron también confiscados por la policía en la operación dirigida contra el conocido sitio de intercambio de torrents han anunciado que planean pedir compensaciones económicas al estado sueco de...
Un regalo (mientras dure) para los adicionados al programa Camera Café que emite Telecinco después de las noticias de la noche: El forastero ha recopilado todos los episodios y los ha colgado en YouTube, listos para ocupar esos huecos de ocio oficinil....
Por Nacho Palou -
15 JUN 2006
Estoy terminando de ver estos días la segunda temporada de Galáctica, Estrella de Combate que es sin duda alguna la serie revelación de la temporada, al nivel de Firefly por lo menos. Es un remake de la clásica y legendaria Galáctica,...
Siempre andamos agradeciendo a los fans de los subtítulos el ímprobo trabajo que hacen traduciendo y subtitulando series como 24 o Lost para compartir el resultado con el resto de la humanidad. Esto no sólo viene bien a los que no hablan...
Tengo por costumbre no ver Cuarto Milenio, el programa de que hace Iker Jiménez en Cuatro, pero he de reconocer que me gustaría haber visto al menos la parte en la que en el programa de ayer daban a conocer la historia...

Las bodegas del USS Saracosta NCC-9737, una nave/club/web para aficionados a Star Trek, están repletas de planos y logotipos de las diversas series trekkers, listos para descargar, en formato vectorial (Windows Metafile). Pueden utilizarse para imprimirlos en papel, bordarlos en camisetas, hacer...
Ahora no podré dejar de fijarme en cada episodio si el número 47 aparece tanto en Star Trek como dicen: The 47 Conspiracy on Star Trek. 47 – La frecuencia con que sale este oscuro número en Star Trek está fuera de...
Mientras esperamos ansiosos el estreno de Cars el próximo 5 de julio (en España), ya podemos ir viendo el trailer de la próxima película de Disney/Pixar, Ratatouille, cuyo estreno está previsto para verano de 2007, película que cuenta las aventuras de una...
La gente de Cuatrosfera nos cuenta que el próximo 12 de junio emitirá un especial conmemorativo del 40º aniversario de Star Trek. Jordi Costa contará algunas cosas sobre las series, películas, actores y los fans, y también se emitirá un pequeño fan...
Lost Theories es una recopilación «estilo web 2.0» de teorías sobre qué sucede realmente en la serie Lost (Perdidos) cuya segunda temporada acaba de terminar de emitirse en Estados Unidos. En la web se pueden añadir teorías, ver las más populares, creativas,...
No creo que sorprenda a nadie, salvo a los instigadores de la operación en la que la policía sueca cerró The Pirate Bay (y probablemente a estos tampoco) pero sólo tres días después de la citada operación el conocido sitio de intercambio...
Hace 100 años la mayoría de los coches eran eléctricos. El sitio Who Killed the Electric Car, de promoción de un documental de próximo estreno con el mismo título, indaga en la breve historia (o «resurgir») de los coches eléctricos que tímidamente...
Por Nacho Palou -
6 JUN 2006
Sugerencia de plan para este próximo fin de semana:Con motivo de la llegada del nuevo canal temático Sci Fi, vuelve la Muestra de Cine Fantástico y Ciencia Ficción, que se celebrará del 8 al 11 de junio de 2006. El madrileño cine...
Por Nacho Palou -
6 JUN 2006
La película número 1 de nuestro Top 10 de películas geek, Blade Runner, lleva años descatalogada en DVD, aunque según cuenta El País en ¿Sueñan los cinéfilos con Blade Runner? estamos de enhorabuena, pues en septiembre saldrá a la venta, aunque por...
La policía sueca ha clausurado hoy The Pirate Bay, el conocido sitio de intercambio de torrents, tal y como puede leerse en la nota que hay ahora mismo en su web, aún a pesar de que su supuesta ilegalidad está a debate....
Al final ayer en vez de ver los dos últimos episodios de Lost vi los dos últimos de la quinta temporada de 24, lo cual tampoco estuvo nada mal. No tengo ni idea de cuándo la emitirán en España, pero sólo digo...

El año pasado nos encantó el anuncio de los nuevos televisores Sony Bravia en el que lanzaron 250.000 pelotas saltarinas por los aires en San Francisco, pero la parodia que han montado los de Tango -que por lo visto es el...
Me quedan sólo dos episodios que creo que devoraré hoy, y luego a revisar el diagrama y las teorías (ojo que la imagen contiene spoilers si no has llegado hasta el final): ¿Perdidos? – Si has terminado de ver la segunda temporada...
Últimamente me he aficionado a ver películas antiguas que recuerdo haber visto de pequeño. Para encontrar algunas he tenido que buscar preguntando por secuencias que recuerdo vagamente o buscando por Internet. ¡Ouch!, igual es la «crisis de los 30» si es que...
Por Nacho Palou -
22 MAY 2006
La legendaria frase que controla el robot en la mítica película de cienca-ficción de los 50 Ultimatum a la Tierra (The day the Earth Stood Still) aparece «homenajeada» en un montón de sitios según la Wikipedia: Klaatu barada nikto. Desde películas (incluyendo...
Algo extraño sucede en el reloj de la serie 24 es una explicación de un detalle tipográfico visual curioso que sólo los más frikis habíamos apreciado. (Es agradable encontrarse en internet que ese frikismo extremo es a veces compartido con otros seres...
No es que no lo hayamos dicho por aquí unas cuantas veces ya, es que el propio Fiscal General del Estado deja claro en una circular del 5 de mayo [PDF 588 KB] que el intercambio de archivos vía redes P2P no...
No es una lista exhaustiva ni mucho menos, pero esta colección de noticias de los últimos días hace pensar que lo mismo los grandes estudios se están empezando a dar cuenta de que realmente tienen que renovar su modelo de negocio: La...
Para variar, un artículo que habla bien de los hackers, titulado precisamente ¿Qué tenemos que agradecer a los hackers? Unas pistas: videojuegos, música generada por ordenador, el ordenador personal, una «cosilla» llamada Internet… (Vía Port 666.) The New Hacker's Dictionary, Third Edition;...
Los aficionados a la ciencia ficción estamos de enhorabuena, ya que SciFi Channel llega a España el próximo 1 de junio. En principio se incorpora a la oferta de Digital+, pero es de suponer que otras operadoras que basan su oferta en...
Imagino que si sigues la serie estarás perfectamente al loro, pero por si los excesos de Semana Santa todavía embotan tus neuronas, recuerda que esta noche, a partir de las 22:00, vuelve a Cuatro Gregory House, el médico más borde de la...
Algo de humor negro en la serie Los Simpson (¡como no!) con el iPod killer (literal) como protagonista:Nando de Venera7.com:El abuelo Abe siente que sus días han llegado a su fin, y se dispone a morir en una clínica de eutanasia. El...
Por Nacho Palou -
17 ABR 2006
Ice Age 2: El deshielo. Carlos Saldanha. Blue Sky Studios, 2006. Web de la película. En Ice Age 2 volvemos a encontrarnos con Sid, Diego y Manny, que se ven obligados a poner pies en polvorosa junto con los demás animales del...
«Mejores» según votación popular, o al menos según los votos que están dando los aficionados a la serie Doctor House desde la página Tengo una cita con el Doctor House del canal Cuatro a los 22 episodios de la primera temporada. De...
Por Nacho Palou -
11 ABR 2006
No quedó en el Top 10 de series geek, ni de hecho entre las 25 más votadas, pero en su momento muchos decíais que os apetecería volver a ver V, lo que podréis hacer a partir de mañana en Cuatro. Durante Semana...
Savior nos apunta a Empire, que ha dedicado un microsite a Las mejores 50 películas del cine independiente. El trabajo es visualmente es excelente y sirve para reconocer algunas de las películas de culto de la última década. Hay algunas que me...
En Youtube, The Official Simpson's Movie Teaser, la presentación inicial de la futura película de Los Simpson, una de nuestras series geek favoritas. poco más de 20 segundos que no aportan nada, pero al menos es una señal. El estreno, previsto para...
Por Nacho Palou -
3 ABR 2006
Mientras seguimos esperando impacientes su estreno, Kevin Smith acaba de colgar el tráiler de Clerks II en la Red: (Gracias, Íñigo.) Teaser de Clerks II.Trabajar en la Estrella de la Muerte.The Passion of the Clerks.Inocentes....
Mangley nos avisó en su momento de que había subtítulos en español para el primer capítulo de The IT Crowd, y ahora nos comenta que ya están disponibles los subtítulos para los seis capítulos de la primera temporada. Ya no tienes disculpa...
Un wiki, tipo Wikipedia, dedicado a la Guerra de las Galaxias: Wookieepedia. ¡Sólo para los más frikis!...
Por Nacho Palou -
31 MAR 2006
Music & Songs: CSI: Crime Scene Investigation es una página que recopila todas las canciones y la música que se escucha en la popular serie CSI, tanto en la original situada en Las Vegas como en las series posteriores ambientadas en Miami...
Crash. Paul Haggis. Lions Gate Films. 2004. Web de la película. Un policía racista a cargo de un padre enfermo, dos ricos blancos, una pareja de negros que se dedica a robar coches, un matrimonio coreano ya algo mayor, un cerrajero hispano,...

Ayer pude ver por fin Star Wreck: In The Pirkinning, que es un largometraje completo de casi dos horas rodado por fans de Star Trek y Babylon 5, parodiando ambas series a la vez. El trabajo es sencillamente colosal y alucinante:...
ElDoblaje.com es una enorme base de datos sobre doblaje de películas y series de televisión, con más de 7.000 películas, 2.000 actores de doblaje y casi 1.000 series de televisión. Se puede recorrer por ejemplo para ver que a Gil Grissom de...
Los productores de South Park [NSFW, 18+] ejecutan su venganza contra el personaje Jerome «Chef» McElroy al que daba vida Isaac Hayes –quien recientemente dejó la serie aparentemente por las críticas hechas en ésta a la Iglesia de la Cienciología. Más información:Los...
Por Nacho Palou -
23 MAR 2006
Aunque los responsables echan la culpa «a las descargas por Internet» muchos hemos sido clientes de Blockbuster y usuarios de Internet durante años y no nos lo creemos del todo:¿Quién 'mató' a Blockbuster? – Es indudable que la piratería afecta, pero últimamente...
Por Nacho Palou -
22 MAR 2006
A veces en una serie de televisión, aunque también puede suceder en películas con varias partes, un personaje desaparece sin que estuviera realmente previsto, bien por algún tipo de desacuerdo contractual con el actor, por la escasa popularidad del personaje, porque al...
Ayer viendo Pasapalabra en Antena 3 me sorprendió ver que el bote del concurso ha llegado a más de 1.800.000 euros, una cifra impresionante para un concurso de televisión. Al parecer llevan meses sin que gane nadie y el premio aumenta y...
MalaCiencia publicó una divertida anotación sobre la Ciencia en Espacio: 1999. Como siempre que se analiza una película o serie de ciencia ficción hay muchas lagunas, y estas son las más divertidas de la legendaria serie: Espacio: 1999 – ¿A qué velocidad...
Mangley nos avisa de que existen subtítulos en español para el primer episodio de la serie The I.T. Crowd, The It Crowd 1×01: Subtitulos en español. En Noséqué.net además buscan voluntarios que quieran ayudar en la traducción de los siguientes episodios –la...
Por Nacho Palou -
14 MAR 2006
La Petite Claudine en El País: «Nuestros representantes políticos son analfabetos en el medio digital».P. ¿Qué opina sobre la reforma de la ley de Propiedad Intelectual?Como cualquier persona en su sano juicio, opino que es una barbaridad: establece que el usuario de...
Prime Time. Las mejores series de TV americanas: de C.S.I a Los Soprano. Concepción Cascajosa Virino. Calamar Ediciones. ISBN: 84-96235-13-0. Español. Ya decía Steven Berlin en Everything bad is good for you que la televisión no es tan mala como muchos dicen...
Tenía pendiente escribir una pequeña guía de cómo copiar DVDs con Mac OS X, pero como es habitual estaba procrastinando un poco el tema, hasta que leí en Y viva el canon que nuestros «queridos» políticos han decidido ceder a las presiones...
TwoFifty.org mantiene una copia actualizada de la lista de las 250 mejores películas del Cine de todos los tiempos, según los votos de los lectores de la IMDB (Internet Movie DataBase). Lo interesante es que puedes personalizar esa lista: basta regisrtrarse e...
Realmente muy logrado: Real Life Simpsons Intro [en YouTube], una recreación de toda la escena inicial con que abren los capítulos de Los Simpson, pero rodada con personas reales, cuidando todos, todos los detalles. Actualización: hay una versión de mejor calidad en...

A Scanner Darkly es una nueva película de animación para este año, que muestra un futuro en el que todo se graba y donde la el Mundo Real™ y el mundo cibernético están extrañamente entremezclados. Es una adaptación de la novela...
BT nos recuerda que a partir del próximo martes por la noche emiten la nueva serie Numb3rs en Antena 3. Al parecer Numbers es una mezcla de CSI con X-Files y Sherlock Holmes, en el que un agente del FBI reculta a...
Cuenta La Chica de la Tele en Abandonando «Perdidos» que dos de los miembros principales del equipo creativo de Perdidos han abandonado la serie para dedicarse a otros proyectos… ¿Será el momento de que resuelvan la trama en dos temporadas o se...
He estado probando Democracy que es una mezcla entre un player de QuickTime y un agregador como NetNewsWire, de hecho hasta la interfaz es muy parecida. Está bastante bien y es agradable porque consigue un punto de comodidad a la hora de...
Una de las principales diferencias entre Star Trek y Star Wars es la cantidad de horas de diversión disponibles para los fans. De Star Trek hay cinco series distintas (o seis, contando la de animación). Cada serie tiene siete temporadas completas de...
En Zona Negativa publican hoy la primera parte de la traducción y resumen de una entrevista que le hizo la revista Wizard a Joss Whedon, creador de Buffy, Angel y Firefly, y autor de guiones para X-Men: Especial Joss Whedon 1 de...
En el blog CuarzoMundo hay recopiladas algunas de las ácidas frases, respuestas y diálogos de Greg House, el médico que protagoniza la serie House que emiten en el canal Cuatro y que añado a la lista «dignas de ver».…¿Preferiría un médico que...
Por Nacho Palou -
17 FEB 2006
Después del fiasco del DRM de Sony/BMG, ahora resulta que también hay DVDs en el mercado que, igual que los discos de audio de Sony/BMG, llevan sistemas DRM que instalan un rootkit que compromete la seguridad del ordenador en el que los...
Estos días están poniendo con cierta frecuencia un anuncio en televisión que cuenta la historia de varios miles de patitos de goma que un día naufragaron en el Pacífico para terminar apareciendo años más tarde en las costas de Escocia arrastrados por...
Hace algún tiempo hablábamos de las prisas de Google, y entre otras cosas mencionábamos los problemas que supone que los vídeos que vende con DRM sólo se puedan reproducir, al menos por ahora, bajo Windows. Hoy Cory insiste en el tema del...
Una vez terminada la publicación del top 10 de las series geek, aquí va la lista de las series que ocuparon los 25 primeros puestos por si te has quedado con ganas de más: Futurama, 384 puntos. Perdidos, 254 puntos. MacGyver, 247...
Aunque al principio se anunció la cancelación de Toy Story 3 tras la compra de Pixar por parte de Disney, parece ser que finalmente no solo no habrá cancelación sino que será Pixar la encargada de hacer Toy Story 3: Toy Story...
Serie geek Top #1: Futurama (1999). Creada por Matt Groening. Protagonizada por Billy West (voz de Philip J. Fry, Prof. Hubert J. Farnsworth, Dr. Zoidberg, Zapp Brannigan y otros), Katey Sagal (voz de Turanga Leela), John Di Maggio (voz de Bender y...
Por Nacho Palou -
10 FEB 2006
Serie geek Top #2: Lost (Perdidos) (2004). Creada por J.J. Abrams , Damon Lindelof, Jeffrey Lieber. Protagonizada por Matthew Fox (Jack), Evangeline Lilly (Kate), Terry O'Quinn (Locke), Josh Holloway (Sawyer).El vuelo 815 de Oceanic Airlines se estrella en una remota isla en...
Serie geek Top #3: MacGyver (1985). Creada por Lee David Zlotoff. Protagonizada por Richard Dean Anderson (MacGyver), Dana Elcar (Pete Thornton), Bruce McGill (Jack Dalton).El nombre de la serie MacGyver se corresponde con el del protagonista interpretado por el actor Richard Dean...
Por Nacho Palou -
7 FEB 2006
Ahora que estamos con el Top 10 Series geek Guillermo descubre The I.T. Crowd serie que se ha estrenado hace poco y tiene toda la pintar de ir a convertirse en una serie de culto «y que bien podría estar en la...
Por Nacho Palou -
7 FEB 2006

Serie geek Top #4: Expediente X (The X-Files, 1993). Creada por Chris Carter. Protagonizada por David Duchovny (Fox Mulder), Gillian Anderson (Dana Scully), Mitch Pileggi (Walter Skinner). Dos agentes del FBI investigan casos actuales que implican de algún modo fenómenos paranormales....
Excelente recopilación en castellano: El Club de la Lucha, frases y curiosidades, sobre todo por los datos de trivia al respecto. Si no has visto la película, no sigas el enlace, corre primero a tu videoclub. En esa anotación se menciona también...
Serie geek Top #5: C.S.I.: Crime Scene Investigation (2000). Creada por Anthony E. Zuiker. Protagonizada por William L. Petersen (Gil Grissom), Marg Helgenberger (Catherine Willows), Gary Dourdan (Warrick Brown), George Eads (Nick Stokes), Jorja Fox (Sara Sidle), Eric Szmanda (Greg Sanders).Gil Grissom...
Serie geek Top #6: Ghost In The Shell: Stand alone complex (2003-2005). Dirigida por Kenji Kamiyama. Protagonizada por Atsuko Tanaka (voz de la mayor Motoko Kusanagi en la versión japonesa), Mary Elizabeth McGlynn (voz de la mayor Motoko Kusanagi en la versión...
Serie geek Top #7: Los Simpson (The Simpsons, 1989). Creada por Matt Groening. Protagonizada por Dan Castellaneta (voz de Homer Simpson, Abuelo Simpson, Barney Gumble, Krusty el Payaso, Willie el Granjero, Alcalde Quimby y a otros personajes), Julie Kavner (voz de Marge...
Por Nacho Palou -
3 FEB 2006
Serie geek Top #8: El mundo de Beakman (1993-1998). Creada por Jok R. Church. Protagonizada por Paul Zaloom (Beakman), Mark Ritts (Lester), Alanna Ubach (Josie), Eliza Schneider (Liza), Senta Moses (Phoebe), Alan Barzman (voz de Herb) y Bert Berdis (voz de Don).Basada...
Adam y Jamie, los Cazadores de Mitos, y dos de los miembros de su equipo, Grant Imahara y Tory Belleci, trabajaron durante algunos años en Industrial Light and Magic, la empresa de George Lucas. Allí tomaron parte en la elaboración de películas...
Serie geek Top #9: Star Gate SG-1 (1997). Creada por Jonathan Glassner y Brad Wright. Protagonizada por Richard Dean Anderson (General de Brigada Jack O'Neill), Michael Shanks (Dr. Daniel Jackson), Amanda Tapping (Teniente Coronel Samantha Carter), Christopher Judge (Teal'c) y Don S....
Demostración práctica, en Presentation Zen: (Vía Jeremy Zawodny's blog.)...

Serie geek Top #10: Star Trek (1966). Creada por Gene Roddenberry. Protagonizada por William Shatner (James T. Kirk), Leonard Nimoy (Spock), DeForest Kelley (McCoy). En el siglo XXIII, la nave Enterprise de la Federación Unida de Planetas explora la galaxia en...
¡Mea Culpa, el retraso es mío! Como nos han recordado algunas personas por correo, teníamos todavía pendiente publicar desde hace semanas los resultados de las votaciones de las series de televisión geek que organizó Wicho durante diciembre y enero. Como la vez...
Los números chungos de Hurley siguen adelante con su PDM y cada vez aparecen en más lugares:La lotería de Irlanda en el MundoReal™, dónde casi consiguen salir premiados, aunque finalmente la combinación que salió fue 4, 8, 15, 16, 23, y 24.La...
La versión resumida viene a ser más o menos esta:How To Turn 10 Million Into 7 Billion: A Brief History Of Pixar – George Lucas necesitaba dinero para pagar su divorcio y mirando a ver de dónde podía sacarlo sin que afectara...
Por Nacho Palou -
25 ENE 2006
Lo anuncia la CNN en Disney buys Pixar: Disney compra Pixar por 7.400 millones de dólares. Jobs entrará a formar parte del consejo de dirección de Disney y John Lasseter se convertirá en el jefe creativo de los estudios de animación de...
Acaba de estrenarse la quinta temporada de 24 en los Estados Unidos, lo que se nota por la cantidad de enlaces que van apareciendo por ahí sobre Jack Bauer, su protagonista. Como muestra:Jacktracker, una forma de seguir las andanzas de Jack vía...
La NBC confirmó ayer que la séptima temporada de El Ala Oeste (The West Wing), una estupenda serie que RTVE se ha empeñado en machacar con horarios inverosímiles, será la última. (Digital Spy vía David GP.) El «share» de nuestras series preferidas.Vuelve...
Todavía tiene que ser aprobado por sus respectivos consejos de dirección, que se reúnen mañana, pero el Telegraph da por hecho en Jobs to scoop $3.5bn as Pixar board approves Disney takeover que ambos consejos aprobarán la compra de Pixar por parte...
Por si ya no hubiera suficiente confusión con todo el asunto de la TDT, ahora resulta que algunos operadores de cable van a empezar a ofrecer a sus abonados los canales de la TDT, pero, al menos según dicen en el operador...
Mythbusters: The «Lost» Experiments: Seis videos de tomas falsas o escenas de los cazadores de mitos que finalmente no salieron por televisión. (Vía Slashdot.) Cazadores de mitos en Slashdot.Cazadores de mitos....
Vistos los resultados de la votación del Top 10 de series geek, que por cierto esperamos publicar en breve, a más de uno os gustará saber que Cuatro recupera el mítico 'Humor amarillo'. Será los sábados y domingos a partir del 28...
Adrenalina. La ciencia del riesgo. Marc Fafard. Sky High Entertainment, 2002. Hay personas que son adictas al riesgo y buscan una vez tras otra emociones fuertes para experimentar el subidón de adrenalina que esto les produce, hecho cuyas bases psicológicas y fisiológicas...
Kevin Smith acaba de colgar el teaser de Clerks II, que se estrenará en agosto, en la web de la película. Esperamos impacientes al estreno, porque Clerks molaba todo. Por cierto, Kevin tiene blog: My Boring Ass Life . The Passion of...
¡Pero alguien tiene que hacerlo! Este anuncio tiene cierta gracia: Worst Job Ever. Antes de quejarte de tu trabajo piénsatelo un par de veces ;-) (Vía populicious.)...
Por Nacho Palou -
9 ENE 2006
Vaya, ¡qué pena que pasaron las navidades! Olvidé pedirle esto a Santa Claus: el conejo asesino de Los Caballeros de la Mesa Cuadrada (procendente de la mítica película: Oh, un tierno y simpático conejito, ¿verdad? ¿Cómo podría un animalito tan tierno arrancarle...
Ya ha terminado la votación para escoger el Top 10 de series geek, y ya tenemos los resultados, aunque tendrás que esperar un poquito para saber qué series se han colado en ese top 10 y saber quién se llevó el router...
Crónicas de Narnia: El León, la Bruja y el Armario. Andrew Adamson. Walt Disney Pictures y Walden Media. 2005. Los hermanos Peter, Susan, Edmund y Lucy Pevensie son evacuados de Londres durante la Segunda Guerra Mundial para ponerlos a salvo de los...
Recuerda que el plazo para enviar tus votos para escoger las 10 series de televisión más geek de la historia termina este próximo domingo 8 de enero a medianoche y que entre los que enviéis vuestros votos sortearemos un sortearemos un router...
Esta película tiene pinta de que va a molar: 5-25-77.O lo vida de un tipo en la época del estreno de La Guerra de Las Galaxias, fecha que da título a la película. Visto en BBoing!, 5-25-77, donde hay un enlace al...
Por Nacho Palou -
4 ENE 2006
El ordenador que acabó con Homer - Después de darse cuenta de que no está metido en la onda del ciberespacio, Homer compra un ordenador, se conecta a internet y crea una página web. Decepcionado por las pocas visitas que recibe su...
Por Nacho Palou -
3 ENE 2006
Pasado el plazo para añadir series a la lista de series y que estas puedan entrar en la votación, aquí van las reglas: La lista sobre la que realizaremos la votación es esta, que es la que se corresponde a las 13:31...
La lista de series geek que estamos preparando para escoger las 10 mejores lleva ya unos días sin apenas actividad, aunque ya hay más de 150. Suponemos que esto es porque todo el mundo ha añadido ya sus preferidas, pero por si...
Fifty music videos es una selección de 50 vídeos musicales de 2005 que «molan», además se pueden ver desde la web en diversos formatos, casi todos QuickTime o Flash, también algunos Windows Media. El #9 de Beck con los robots es muy...
Uno de mis episodios favoritos de Star Trek: La Serie Original es Mirror, Mirror. A causa de un problema en el transportador, parte de la tripulación del Enterprise aparece en un «universo paralelo» en el que todo está al revés: en vez...
Anotación recomendable sólo para fánaticos de Lost / Perdidos. 20.085 = 3 × 5 × 13 × 103 de donde pueden extraerse 3 + 13 = 16 = número chungo 5 + 103 = 108 = el más chungo todavía (4 +...
Jamie Hyneman y Adam Savage, más conocidos como los Cazadores de Mitos, contestan a las preguntas de los lectores de Slashdot sobre el programa en The Mythbusters Answer Your Questions. English required, claro....
La edición de esta noche de Redes, titulada ¿Aún creyendo cosas extrañas?, que como siempre sale a la cómoda hora de la 1:15 de la madrugada, estará dedicada al escepticismo y al pensamiento crítico. La entrevista que se emite durante el programa...
Teníamos pendiente escoger el Top 10 de series de televisión geek, así que vamos a empezar el proceso. Igual que hicimos con el Top 10 de películas geek, empezaremos por recoger candidatas en la página Series Geek del wiki de microsiervos, con...
Vi esta extraña película inglesa, Layer Cake, que me prestó un amigo inglés en DVD, traída desde las islas hace meses. Creo que aquí en España no se ha estrenado, es como una mezcla entre Pulp Fiction, Trainspotting y Cerdos y Diamantes,...
Un clásico: Trabajar en la Estrella de la Muerte, uno de los mejores diálogos de Clerks: Había algo que no encajaba cuando la ví por primera vez, no sabía lo que era, pero algo no encajaba (...) La segunda Estrella no estaba...
¿Se acerca la realidad a la ficción? ¿Es Perdidos algo más que una serie de televisión? Los números de Hurley casi salen en la Lotto de Irlanda el pasado 19 de noviembre, pues la combinación ganadora fue 4, 8, 15, 16, 23,...
Algunas series que están emitiendo en el canal Cuatro, «el canal sin películas», que en mi opinión merecen la pena ver si se tiene ocasión. Algunas son nuevas, otras ya conocidas y repetidas —y otras muy repetidas:Anatomía de Grey, una de médicos...
Por Nacho Palou -
15 DIC 2005
Está visto que el nivel de estulticia de la gente -o su afán de notoriedad a cualquier costa- alcanzan límites insospechados: Space Cadets es un reality show que ahora mismo está en marcha en el que han convencido a tres participantes de...
Prometía bastante, pero como lo más destacado del primer episodio de Los 4400 podría resumirse (ojo: pseudo-spoiler) en Bien, digamos que aparece un enorme cometa que se dirige a la Tierra, que claramente cambia de rumbo así que de cometa tiene poco,...
Alta Fidelidad. Nick Hornby. Ediciones B. S.A.. ISBN: 844065944X. Español. [En inglés | Ver similares] Rob Fleming es un apasionado de la música que tiene una tienda de discos en Londres en la que trabaja con dos amigos/empleados con los que mantiene...
En Public Domain Torrents hay más de 500 películas clásicas y de serie B que ya están en el dominio público listas para ser descargadas vía BitTorrent; muchas de ellas están además disponibles en formatos compatibles con PDAs e iPods. Muchas te...
En Fimoculous están recopilando en Lists: 2005 listas de todo tipo relativas a 2005: música, libros, coches, juguetes más peligrosos, descubrimientos científicos... El año pasado llegaron a recopilar unas 550 listas en Lists: 2004. (Vía MetaFilter.)...
Chicken Little. Mark Dindal. Walt Disney Feature Animation, 2005. Tarde de tormenta y frío, así que tocó ir al cine con los enanos a ver Chicken Little, la primera película animada por ordenador creada por Disney. Cuenta la historia de un pollito...
En uno de los cientos de comentarios sobre Lost (Perdidos) que han llegado hasta Microsiervos he descubierto LostPedia que es un Wiki sobre Lost. Es curiosa la elección de un wiki para series de este tipo, otro similar y muy completo es...
Tras años hablando del tema y años de emisiones en pruebas hoy comienzan en España oficialmente las emisiones de TDT. La oferta inicial es de 18 canales, a los que pronto se unirán otros dos recién concedidos a La Sexta, aunque todavía...
Una lista con los mejores robots de la historia del cine. En cabeza, R2-D2 y C-3PO (aparentemente van empatados). Mi favorito, Gort de Ultimátum a la Tierra, ocupa el sexto puesto.Terminator debería estar más arriba, y no sé qué pinta «El Gigante...
Una recopilación bastante graciosa: 10 Dumb Moments in Sci-Fi Cinema, que viene a ser una explicación de los momentos más estúpidos de las películas de ciencia ficción, como por ejemplo: Los Imperial Walkers atacan a los Rebeldes en Star Wars: El Imperio...

La canción del anuncio de televisión del Sony Bravia se llama Heartbeats, de José González (en su álbum Veneer). En esta bonita y original película se lanzaron 250.000 pelotas de plástico reales rebotando por las colinas de San Francisco....
La semana pasada estuve tan liado que hasta anoche no tuve tiempo ni de sintonizar Cuatro en el canal adecuado de las televisiones de casa, y cuando al final lo hice, voy y me encuentro con Iker Jiménez y Cuarto Milenio. ¿Es...
No se ve mal, Watching all six Star Wars movies simultaneously: Only-one Kenobi - ¿Te imaginas poder ver los 6 episodios de «La Guerra de las Galaxias» (Star Wars) a la vez? Pues no te pierdas este curiosísimo proyecto de un fanático...
No sabía que tuviera... ¡Guardería! Las tripas de la Estrella de la Muerte - Conocer las interioridades y el funcionamiento de (ambas) Estrellas de la Muerte es algo que cualquier fan de La Guerra de las Galaxias, sus secuelas y precuelas, habrá...
Disfraz para muy geeks: Office Space Costume ¿Cuántos post-its harán falta realmente? Inspirado en la película Trabajo Basura que recientemente fue nombrada la película geek oficial Top #9....
He aquí el verdadero dilema geek sobre Cuatro: ¿Dónde ponemos la Cuatro? - Después de leerlo en La Vanguardia, he pensado lo mismo. En mi mando a distancia la Primera es el 1, La 2 el 2, Antena 3 el 3 y...
Algunos nos habéis pedido que publiquemos el recuento de votos del Top 10 de películas geek, así que aquí están películas las que obtuvieron al menos 10 puntos, sin ponderar si recibieron más votos de 5 puntos que de 3 ó 2...
Ya que en la mayoría de nuestra lista top 10 de películas geek los ordenadores juegan un papel muy importante, conviene no olvidar que en la mayoría de las ocasiones en las que aparece un ordenador en una película Hollywood mete la...
Bueno, una vez terminada la publicación de las diez mejores películas geek de todos los tiempos, que hemos ido dando a conocer una por una durante los últimos diez días, este sería el ránking completo y definitivo: Las 10 mejores películas geek...

«Yo… he visto cosas que vosotros no creeríais…»

Película geek Top #2: Juegos de Guerra (WarGames) (1983). Dirigida por John Badham. Escrita por Lawrence Lasker y Walter F. Parkes. Protagonizada por Matthew Broderick (David Lightman), Ally Sheedy (Jennifer), John Wood (Dr. Stephen Falken) y Barry Corbin (General Jack Beringer)....
Película geek Top #3: Tron (1982). Dirigida por Steven Lisberger. Escrita por Steven Lisberger y Bonnie MacBird. Protagonizada por Jeff Bridges (Flynn/Clu), Bruce Boxleitner (Alan/Tron), David Warner (Dillinger/Sark/MCP), Cindy Morgan (Lora/Yori). Puntuación en la IMDB: 6,4 de 10.Kevin Flynn es un programador...
Por Nacho Palou -
21 OCT 2005
Hoy se estrena Serenity en España, así que aquí queda esta anotación para que los que la vayáis viendo podáis ir comentando y spoileando a gusto. Los microsiervos la veremos el martes por la tarde, aún no sabemos dónde. El principio de...

Película geek Top #4: 2001: A Space Odyssey (2001: Una odisea del espacio) (1968). Dirigida por Stanley Kubrick. Escrita por Stanley Kubrick y Arthur C. Clarke. Protagonizada por Keir Dullea (David Bowman), Gary Lockwood (Frank Poole), Douglas Rain (HAL 9000), William...
Como todavía no conozco una buena traducción de spoiler, me quedo con el término en inglés que en Internet es bastante popular. Un spoiler es algo así como contar a alguien cómo acaba una película, un libro, un chiste, una serie de...
Película geek Top #5: The Matrix (1999). Dirigida y escrita por Andy Wachowski y Larry Wachowski. Protagonizada por Keanu Reeves (Neo), Laurence Fishburne (Morpheus), Carrie-Anne Moss (Trinity), Hugo Weaving (Agente Smith). Puntuación en la IMDB: 8,6 de 10; posición #34.Anderson ha estado...
Por Nacho Palou -
19 OCT 2005
Película geek Top #6: Cube (1997). Dirigida por Vincenzo Natali. Escrita por André Bijelic, Vincenzo Natali y Graeme Manson. Protagonizada por Nicole de Boer (Leaven), Nicky Guadagni (Dra. Holloway), David Hewlett (Worth), Andrew Miller (Kazan), Julian Richings (Alderson), Wayne Robson (Rennes), Maurice...
Por Nacho Palou -
18 OCT 2005
Hace un rato vi como terminaba Decisión Crítica (Executive Decison) una película de Kurt Russell en la que unos terroristas secuestran un Boeing 747 con fines aviesos... Y resulta que ese 747 era el vuelo 340 de ni más ni menos que...
Antes de hacerse mundialmente famosos con su propio espacio en la Fox los Simpson aparecieron entre 1987 y 1989 en 41 cortos en The Tracey Ullman Show, cortos que te puedes descargar de la página Tracey Ullman Shorts. Eso sí, están en...
IMDb, la mejor base de datos de películas de Internet, cumple quince años hoy 17 de octubre. Hace quince años ni siquiera existía la web, y la primera versión nació en los grupos de Usenet, fue forjada por voluntarios y creció y...
Película geek Top #7: Pi / Pi (fe en el caos) (1998). Dirigida por Darren Aronofsky. Escrita por Darren Aronofsky, Sean Gullette y Eric Watson. Protagonizada por Sean Gullette (Maximillian Cohen); Mark Margolis (Sol); Ben Shenkman (Lenny); Pamela Hart (Marcy). Puntuación en...
Película geek Top #8: Sneakers (Los Fisgones) (1992). Dirigida por Phil Alden Robinson. Escrita por Lawrence Lasker, Phil Alden Robinson y Walter F. Parkes. Protagonizada por Robert Redford (Martin Bishop); Sidney Poitier (Donald); David Strathairn («Sónar»); Dan Aykroid («Madre»); River Phoenix (Carl);...
Las cenizas de James Doohan, el actor que durante años dio vida a Scotty en Star Trek viajarán al espacio en el lanzamiento The Explorers Flight de Space Services, Inc., cuyo despegue probablemente tendrá lugar a mediados de diciembre de 2005; junto...
Película geek Top #9: Trabajo Basura / Office Space (1999). Escrita y dirigida por Mike Judge. Protagonizada por Ron Livingston (Peter Gibbons); Jennifer Aniston (Joanna); David Herman (Michael Bolton); Ajay Naidu (Samir); Stephen Root (Milton Waddams) y Gary Cole (Bill Lumbergh)....
Película geek Top #10: 12 monos / Twelve Monkeys (1995). Dirigida por Terry Gilliam. Escrita por Chris Marker y David Webb Peoples. Protagonizada por Bruce Willis (James Cole); Madeleine Stowe (Kathryn Railly); Brad Pitt (Jeffrey Goines). Puntuación en la IMDB: 8...
Ya ha terminado la votación de las películas geek... Y ya tenemos los resultados, pero aún tendréis que esperar un poquito para conocerlos ;-)...
Recuerda que sólo tienes hasta medianoche de hoy para votar por tus películas geek favoritas. Si quieres votar y aún no lo has hecho, sigue las instrucciones que damos en Películas geek - la votación....
Universal ha liberado los nueve primeros minutos de Serenity, la película que cuenta las aventuras de Malcolm Reynolds y su tripulación después de Firefly. Puedes verlos aquí, aunque puede que necesites permitir los pop-ups de http://video.vividas.com/ para poder verlo en Firefox. ¿Podrás...
Perdidos por Lost es un nuevo blog en castellano dedicado a la serie de moda. ¡Ojo! Está lleno de spoilers que pueden desvelarte cosas que no querrías saber todavía. (Vía Jam Session.) Lost / Perdidos, reseña completa de la serie, que...
Dentro de dos semanas se estrena en España Serenity, la mejor película de ciencia ficción de, por lo menos, este año. Estoy intentando por todos los medios no leer nada sobre ella para no tropezarme con ningún spoiler, pero no he podido...
Mmm... todas las canciones de la banda sonora de Lost / Perdidos en una misma página: LOST Music. Sí, lo confieso, estoy enganchado a la serie de televisión «Lost» (Perdidos). Ya se han dicho y hecho muchas cosas en la Red acerca...
Hace algún tuiempo a raíz de una petición de Raúl (KingsSoft), os preguntábamos por películas geek, y pronto hubo más de cien sugerencias en los comentarios de aquella anotación, sugerencias que terminamos recopilando en una nueva sección del wiki de Microsiervos llamada...
Al final va a ser que no era culpa de las redes P2P o cualquier otra excusa. Los ejecutivos de los grandes estudios están empezando a darse cuenta de que lo que hace que cada vez menos gente vaya al cine es...
Acabo de ver Código 46, que me gustó bastante. Es de Tim Robbins, con una temática similar a La Isla pero con un toque asiático estilo Lost in Translation e incluso, por qué no decirlo, Blade Runner. También tiene mucho de Gattaca...
Hoy estrenan película, al menos en la parte del mundo en la que se habla inglés, Joss Whedon (Serenity, IMDB) y Neil Gaiman (Mirrormask, IMDB) y con tal motivo Time publicaba hace unos días una entretenida entrevista con ambos que no tiene...
Ningún fan de Star Trek debe perderse la Espatrek 2005 que se celebrará en Málaga este año del 21 al 23 de octubre. Yo hace mucho que no voy a ninguna convención trekker, la falta de vida propia me impide disfrutar de...
¡Hmmmm! ¡Iconos y Futurama en la misma frase!: Futurama Vol. 1(Vía r00lz.) FamFamFam: iconos gratis total¡Favicons!Iconos: la historiaIconos, enlaces a sitios y colecciones de iconos.GUIdebook, un bonito sitio que reúne iconos y otros elementos de interfaces gráficos.Futurama TaglinesCuriosidades matemáticas en Futurama...
Por Nacho Palou -
30 SEP 2005
Este es el lugar para poder comentar la segunda temporada de Lost / Perdidos (Lost en la Wikipedia), que acaba de ser estrenada en los Estados Unidos. Ten en cuenta que por ahora la inmensa mayoría de la gente no la ha...
Dado que Lost / Perdidos (Lost en la Wikipedia) ha demostrado ser popular entre los autores y lectores de Microsiervos y que el hilo de comentarios en la anotación sobre los números de Hurley en la primera temporada ya ronda los cien...
Un programa que trato de no perderme cuando tengo ocasión de verlo es Cazadores de Mitos (Mythbusters el original en inglés), donde se intentan confirmar o desmentir algunos mitos o leyendas urbanas tales como si es posible morir engullido por arenas movedizas,...
Por Nacho Palou -
28 SEP 2005
Hay gente a la que le encanta hacer listas de todo lo inimaginable, como por ejemplo esta: Estrellas Invitadas Muertas tras aparecer en episodios de Los Simpsons. Barry White, George Harrison, Linda McCartney, Los Ramones, Stephen Jay Gould, Johnny Cash, Bob Hope,...
No me había enterado hasta que lo oído esta mañana en la radio, que hace un par de días falleció Dom Adams, más conocido como el Superagente 86 (Get Smart), protagonista de la serie con el mismo nombre que aquí se emitía...
Por Nacho Palou -
27 SEP 2005
Volví a ver el otro día High Fidelity (Alta Fidelidad, 2000), la película de Stephen Frears donde el protagonista, John Cusack, es un experto musical obsesionado con las «listas Top #5». Parece como si todo en su vida circulara alrededor de esas...
Nada mejor para empezar bien un lunes. ¡El mejor vídeo de la temporada! Imperdonable no haberlo visto. Lo más graciosamente nerd, geek y friki que he visto nunca sobre La Guerra de las Galaxias. Gonzolog lo mandó a una lista de correo...
Una de las claves fundamentales del éxito «post mortem» de Firefly ha sido sin duda que además de ser una serie increíble sus seguidores no han parado de hablar bien de ella, en especial a través de Internet. Conscientes de ello, Universal...
T.W.D.C.I.S.L. = The Walt Disney Company Ibérica Sociedad Limitada ¡Ah! Qué alivio. Es que me pone nervioso ver acrónimos y no saber lo que significan. TWDCISL aparece en pequeñito al principio de muchas películas del Grupo Disney, Buena Vista, etc. Por ejemplo...
Dejo esta anotación simplemente por si alguien quiere hablar de Sin City en el hilo de comentarios, porque ayer mencioné de pasada que fui al cine a verla en el post sobre el ADSL duplicado, que no tiene nada que ver y...
Firefly - The Complete Series. Joss Whedon, 2003. 4 discos, región 2, PAL. Audio inglés. Subtítulos en inglés. [ver similares] Firefly - The Complete Series. Joss Whedon, 2003. 4 discos, región 1, NTSC, widescreen. Audio inglés, francés y español. Subtítulos en inglés...
Parece ser que el éxito de CSI y sus series derivadas está teniendo efectos colaterales poco deseables: Los científicos alertan de que la serie CSI 'ayuda' a los delincuentes. Resulta que son como los programas que emite la UNED, pero para cacos....
¡Wow! Al final va a existir un comunicador de Star Trek de verdad. Al parecer lo va a fabricar una empresa llamada Sona Mobile tal y como cuenta esta nota de prensa de hace algunas semanas: Sona Mobile to Create Star Trek...
Tras la falsa alarma del lunes pasado, hoy sí estrenan CSI: NY en Telecinco: Los agentes de «CSI Nueva York» debutan esta noche en Telecinco. También comienza la tercera temporada de CSI: Miami con el estreñido de Horatio, pero casi cualquier cosa...
Eres más listo que la televisión.¿Y qué?- Microsiervos (Douglas Coupland, 1995)...
Pixel me pasa el aviso de que mañana se estrena en España la película basada en La guía del autoestopista galáctico, a ver qué tal. Estoy deprimido.Trailer de la Guía del Autoestopista Galactico.La Guía del Autoestopista Galáctico al cine....
Si antes Raúl alguien buscaba una película que no sabía cómo se llamaba ahora yo ando buscando un cortometraje. Con el título me valdría, pero si alguien lo tuviera grabado, que no creo, pues estupendo. Puede que tenga tal vez unos diez...
Raúl (KingsSoft) pide ayuda para localizar una película:He visto una peli, pero lamentablemente no me repare en saber cual es su titulo, solo puedo decir que trata de 3 programadores y un mercadolo que crean un pc por $99, al final la...
Basada en el libro Fire in the Valley: The Making of The Personal Computer, la película Pirates of Silicon Valley cuenta la historia de los principios de Apple y Microsoft y sale ahora en DVD; en español está en VHS, pero no...
Tal día como hoy, 29 de agosto, hace ocho años (según alguien añadió al Calendario Geek) la red de ordenadores Skynet tomó consciencia de sí misma y empezó a suponer «un pequeño problemilla» para los seres humanos. El resto es historia....
Si no estás al día siguiendo Perdidos, cuya primera temporada termina esta noche en La Primera, y todavía no has visto Números, el capítulo 18, esta anotación tiene algún «spoiler», así que a lo mejor no te interesa seguir leyendo. De lo...
The Corporation. Un documental de Jennifer Abbott, Mark Achbar y Joel Bakan. Tres capítulos de unos 60 minutos. Web oficial: The Corporation. Canadá. Inglés. 2003. Hace algunos pocos cientos años las «corporaciones» eran entidades prácticamente insignificantes. Sólo existían con fines limitados y...
Cuando Miramax fue adquirida por Disney, Pulp Fiction se convirtió en la primera «película Disney» con una escena bastante explícita de sodomía, aquella en la que Butch, Marsellus, Zed, el Policía y «el tarado» están en el sótano de la tienda de...
En estos momentos termina la cuarta temporada de 24, de hecho estoy escribiendo esto en uno de los múltiples intermedios publicitarios que van a hacer durante estas últimas tres horas. Podemos aprovechar esta anotación como lugar sobre el que comentar tan apasionante...
Espero que sea buena, porque la verdad es que Kevin Smith ha ido de mejor a peor, la última Jersey Girl era realmente infumable, de lo peor que he visto este año. Habiendo hecho películas geniales como Clerks, Persiguiendo a Amy o...
Ayer vi La Isla, una película que está bastante bien en todos los sentidos (historia, actores, efectos), pero que queda realmente fastidiada debido a la publicidad (product placement). En BlogDeCine también lo han notado: ¿Por qué hiciste 'La isla' Scarlett? - (...)...
Ya está disponible el trailer de la nueva película de los hermanos Andy y Larri Wachowski, creadores de Matrix: V for Vendetta. Con Hugo Weaving, más conocido como «Agente Smith» y Natalie Portman «Princesa Amidala». Tiene un look extraño y curioso, es...
Gran serie, poco «share» analiza los motivos por los que las series extranjeras de más éxito como Mujeres desesperadas, Perdidos, 24, El ala oeste de la Casa Blanca o A dos metros bajo tierra tienden a fracasar o a tener unas cuotas...
Este es el salvapantallas definitivo. Como buen fan de Star Trek levaba tiempo esperando algo como esto, y por fin lo he encontrado y además es totalmente genial. System 47 es un salvapantallas que convierte por un rato tu ordenador en...
A los 85 años de edad ha fallecido James Doohan, el actor que interpretaba al popular ingeniero Montgomery Scott («Scotty») en la serie original Star Trek. Scotty era un personaje entrañable favoritos de muchos trekkers y especialmente de los geeks. Se hizo...
Se supone que cuando vas al cine estás pagando por ver una película de cine, no por tragarte diez minutos de publicidad antes del comienzo. Además, nunca empiezan a la hora que dicen y encima las palomitas y refrescos cuestan un dineral....
Por si quieres saber de qué tratan pero sobre todo cómo acaban algunas películas y libros, sin tener siquieta que verlas o leerlos: The Book SpoilerThe Movie Spoiler(Vía The J-Walk Blog.)...
Billy West, el actor que pone voz a Fry, entre otros personajes de Futurama, ha confirmado que está en marcha una película de la serie que saldrá directamente en DVD, con la posibilidad de que se haga una segunda si esta funciona...
La peor de las malísimas películas de Ed Wood, que por ser tan mala se ha ganado la consideración de obra de culto, está ahora disponible en distintos formatos en Archive.org bajo una licencia CC: Plan 9 From Outer Space. Ojo, que...
Everything Bad Is Good for You. How Today's Popular Culture Is Actually Making Us Smarter. Steven Johnson. Riverhead Hardcover, 5 de mayo de 2005. ISBN: 1573223077. Inglés. [ver similares] Desde hace años la «cultura popular» viene manteniendo que los juegos de ordenador,...

Me encantó Primer, una pequeña joya de cine independiente, ópera prima de Shane Carruth. Al igual que otros grandes como Amenábar, Carruth hizo de todo: escribió el guión de Primer y además dirigió, compuso la música, realizó el montaje y es...
¡Qué bueno! Luis me mandó por correo un vídeo procedente del año 2014, un documental del Museo de Historia de los Medios titulado EPIC 2014 [Act: ya no funciona]. Cuenta mediante imágenes y una narración en inglés cómo han ido las...
Este verano Movistar empieza a probar la recepción de canales de televisión en directo y de servicios interactivos en teléfonos móviles. El servicio podría estar disponible el próximo mes de febrero.Los seleccionados para la prueba dispondrán de un terminal Nokia 7710 con...
Por Nacho Palou -
6 JUL 2005
Por si después de ver Batman Begins necesitas ponerte al día con el personaje, David Hernando y Gustavo Martínez mantienen Batman -Guía Visual-, una curradísima página sobre el personaje con todo tipo de información. También son responsables de la recién estrenada Superman...
Este fin de semana largo de cuatro días he tenido ocasión de probar con cierta intensidad Imagenio, la televisión por ADSL (IPTV) de Telefónica, que aunque todavía tiene algunos peros me ha sorprendido muy gratamente y ha resultado ser mucho mejor de...
Por Nacho Palou -
5 JUL 2005
Razorbuzz de Llámame Lola me envió el Meme de Cine que circuló hace semanas. También me lo mandó poco después DiDE, pero como estaba de vacaciones lo dejé para la vuelta, así que aprovecho ahora: Número de películas que tienes: Pues...
¡Qué bueno! En el episodio de CSI que están emitiendo ahora mismo (No More Bets, cuarta temporada) el caso trata de unos tipos que ganan jugando a la ruleta con un ordenador en el zapato, y como no podía ser de otra...
Super City es una obra visual de Douglas Coupland (nuestro Santo Patrón) que se exhibe en el Canadian Centre for Architecture de Montreal. Mmmm... ¡Con sus detallitos de LEGO! Coupland también está trabajando en una película que será su primer guión llevado...
Si por algo se caracteriza Maddox, el autor de La Mejor Página del Universo es por decir las cosas claras... Sus viñetas suelen ser la risa total y los comentarios también: ironía pura donde las haya. Tras el estreno de Star Wars...
Para ir ambientando el estreno de la película Guerra de los Mundos, aparte de la sugerencia de pasar una sesión en DVD de la versión de 1953 La Guerra de los Mundos —la nueva versión pierde un artículo en el título, ¿qué...
Por Nacho Palou -
23 JUN 2005
Se confirma la noticia que dábamos hace unos días de que la cuarta temporada de «24» iba a ser emitida este verano; en concreto, su emisión empieza este jueves, 23 de junio, a las 22:40, justo después del último capítulo de la...
Aunque como es habitual en las series buenas, lo hace en el horario estelar de la una de la madrugada, probablemente a partir del próximo lunes 27 de junio. Del comunicado de prensa de RTVE sobre su programación para este verano en...
Mañana se estrena en los cines la película Batman Begins, en la que se cuenta el origen del personaje. Tiene buena pinta y PJorge ha recopilado algunas críticas que en principio son buenas pero que como siempre hay que manejar con escepticismo...
Por Nacho Palou -
16 JUN 2005
He recopilado toooodos los taglines, esa frasecita más o menos graciosa que aparece al inicio de cada capítulo, de la serie Futurama en el grupo de Flickr Futurama Taglines por orden (inverso) para disfrute general. Hay algunas realmente divertidas. Las 72 capturas...
Por Nacho Palou -
14 JUN 2005
Según el artículo Ay Caramba! "Simpsons" Movie Going parece que después de años de rumores finalmente se está preparando una película de Los Simpsons. Lo soplaba «la voz de Bart» Nancy CartwrightYou know what? We've just done the table read for The...
Por Nacho Palou -
9 JUN 2005
Cuenta la prensa que este verano podremos ver la cuarta temporada de «24», una de nuestras series de cabecera: Antena 3 estrenará este verano la cuarta temporada de «24». Y por lo visto, aunque por supuesto esos planes pueden cambiar de un...
Fer nos envía este enlace con la ficha técnica de la película El regreso Algo en Común en Terra CineSorprende ver a qué idiomas se doblan algunas películas hoy en día... Actualización: En los comentarios YoNoSoyTu lo explica[N]o es que esté doblada...
Por Nacho Palou -
9 JUN 2005
En las páginas de soporte de Microsoft hay una extensa nota dedicada a un problema curioso y divertido: Problemas de reproducción y de protección contra copia cuando se intenta reproducir la película en DVD de Blancanieves y los siete enanitos[...] Windows XP...
Por Nacho Palou -
6 JUN 2005
La verdad es que es un timo integral, entras al cine y las palomitas y la Coca-Cola suelen costar ya más que la propia entrada. Las palomitas que se venden en los cines son «malas y caras» según la OCU - Muchas...
Estaba esperando a verla yo mismo, pero no hay manera, así que para los que ya la hayáis visto o la vayáis a ver por enésima vez, Episode III Easter Egg Hunt, una recopilación de referencias, cameos, y coñas varias en La...
Mola: La serie MacGyver, ese gran clásico de las series de televisión, resulta que existe en DVD, al menos en parteMacGyver - The Complete First SeasonMacGyver - The Complete Second SeasonRecientemente repusieron la serie en Telemadrid los sábados por la mañana creo...
Por Nacho Palou -
1 JUN 2005
Rumores para echarse a temblar hablan de un «precuela» de La Amenaza Fantasma, el Episodio I de La Guerra de las Galaxias: Lucas' idea for new Star Wars Prequel? Lo peor es que aún quedan infinitos números (negativos incluídos) para seguir añadiendo...
Por Nacho Palou -
27 MAY 2005
Entre los carteles de películas de próximo estreno disponibles en Apple Movie Trailers me llama la atención la gran cantidad de remakes de películas antiguas que están por venir —como en la página van cambiando cada vez que se recarga las he...
Por Nacho Palou -
25 MAY 2005
Una buena reseña de «La venganza de los sith» en PJorge:Los jedis son un grupo de payasos incapaces de defender ni un chiringuito de playa y menos una galaxia. Son tan inútiles, que yo esperaba encontrar a Anacleto sentado en el consejo...
Por Nacho Palou -
24 MAY 2005
Como en muchas otras series o películas, en Futurama hay más de lo que parece a simple vista, como por ejemplo toda una serie de curiosidades matemáticas que puedes encontrar en la Indoblable Página de Bender Bending Rodríguez. Por cierto, en la...
Siguiendo con el tema estrella (aquí un inglés diría «pun intended») de la semana, una recopilación de las referencias que hay a Star Wars en Los Simpson. (Vía La vaca sueca.)...
El tema daría para mucho porque tiene infinitos matices, pero he aquí un resumen rápido: Star Wars vs Star Trek en cinco minutos. First, Star Wars vs Star Trek normally means «could the Empire kick the Federation's ass?» If it's a question...
Enlazo con cierto recelo esta página porque está completamente escrita en Comic Sans (¡mis ojos! ¡mis ojoooos!) pero bueno, aquí va: How to be a Successful Evil Overlord que recoge 100 sabios consejos sobre qué cosas no hacer para ser el malo...
Por Nacho Palou -
20 MAY 2005
Hoy es un día típico de spoilers. Todo geek que se precie habrá visto ya Star Wars: Episodio III, La Venganza de los Sith al menos una vez desde que se estrenó, probablamente dos y los más frikis tres o más. Y...
Por Nacho Palou -
19 MAY 2005
Quiero esta camiseta que queda así de chula ;)...
Por Nacho Palou -
19 MAY 2005
Pues resulta que la empresa nos ha comprado como regalo las entradas para la primera sesión del estreno de mañana: Star Wars: Episode III - Revenge of the Sith. Y además nos dará horas libres para poder ir tranquilamente, comer algo al...

El título lo dice todo: Los 100 mejores momentos y escenas icónicas de las mejores películas, en FilmSite con fotos incluídas. (Vía GarajeKubrik quien lo vió en La Petite Claudine - por cierto, ambos blogs altamente recomendables.)...
En la charla del viernes también surgió (creo que al hablar sobre «guías de podcastings») una mención a MiGuíaTV.com, que es una web que ni siquiera sé muy bien cómo la encontré, ni a quién pertenece, pero que me guardé porque encontré...
Están poniendo en la tele Stargate (la película original de 1994), que para mi siempre ha sido el ejemplo perfecto de película de las cuales los 10 ó 15 primeros minutos son totalmente apasionantes y prometedores - pero luego el resto del...
Esta es otra anotación que seguro que le encanta a Alex, y es que vista la ficha de "Ella Enchanted" en la web de Yelmo Cineplex, algo me dice que al programa de traducción automática que usan aún le faltan por lo...
Aunque la publicidad excesiva e intrusiva me parece insportable, sea cual sea el medio, como por ejemplo la que está usando El Ideal Gallego estos días de la cerveza 1906 que al menos en mi caso lo que ha conseguido es que...
Un Han Solo congelado en carbonita hecho a tamaño casi natural con unas 10.000 piezas de Lego... ¡y mucha paciencia! [vía The Green Head] Además Un paseo por el universo de George Lucas: hasta el al 28 de mayo de 2005 se...
Por Nacho Palou -
27 ABR 2005
Es esta semana: TV-Turnoff Week (Semana sin Televisión) del 25 abril al 1 de mayo. También es una gran casualidad (o gran ironía) que la entrevista en televisión a los Microsiervos que escribimos este weblog se emita justamente hoy, en Localia TV...
El año pasado probé a participar en la TV-Turnoff Week (Semana sin Televisión) que este año será dentro de dos semanas, (la última semana de abril: del 25 abril al 1 de mayo, más concretamente). En su día no di cuenta del...
Extraña y triste noticia: El mostruo de las Galletas dejará de comer galletas: Barrio Sésamo inicia esta semana su 36 temporada en la televisión estadounidense PBS con grandes novedades. Triki, el monstruo de las galletas, deja su alimento favorito para pasarse a...
MJ Simpson (no confundir con OJ), que lleva veinte años estudiando la obra de Douglas Adams, acaba de publicar una crítica sobre la película basada en La Guía del Autoestopista Galáctico que está a punto de ser estrenada. Hay una versión larga,...
Mira que soy fan de la película, pero nunca hubiera pensado que el fenómeno diera lugar un festival a modo de convención... Pero ahí está: Lebowski Fest. Llevan así desde 2002. Imprescindible las fotos del Lebowski Fest. Más info en las Preguntas...
Robots. Chris Wedge y Carlos Saldanha. Blue Sky Studios / Twentieth Century Fox. Como es casi de rigor en los últimos años, una película supuestamente para niños que el público adulto disfrutará mucho más que ellos, porque está llena de referencias y...
Otra vez el Sr. Pez, esta vez con una interesante reflexión acerca de la ciencia ficción en Entre La Ciencia Y La Ficción....
Hace tiempo que no poníamos ninguna anotación sobre películas, pero El escondite (Hide and Seek) sin duda se lo merece. En dos palabras: un absoluto desperdicio (vale, han sido tres, pero es que me siento generoso)....
En enero del año pasado Antena 3 estrenó Sin Rastro, serie que en la tónica habitual de los programadores de esa cadena pronto hizo honor a su título desapareciendo y reapareciendo de la parrila varias veces en días y horarios distintos hasta...
Emergency! Crisis on the Flight Deck. Stanley Stewart. Airlife Publishing, Ltd. 1 de abril de 2003. Inglés. Este libro recoge los relatos de varios incidentes graves en vuelo de aviones de pasajeros que a pesar del susto terminaron sin la pérdida de...

Amazon tiene el tráiler de la película basada en la Guía del Autoestopista Galáctico en su página principal; por si lo sacan de ahí, este es en enlace directo. Tengo muchas ganas de verla, pero me da miedo que el resultado...
Al parecer hoy lunes a las 22.00 Telecinco emite el episodio Miami-Nueva York sin escala de CSI, que sirve de presentación para los personajes de la nueva serie ambientada en la Gran Manzana....
La odisea del espacio explicada se refiere, claro está, a la película 2001 Una odisea en el espacio y es una interpretación sobre el significado de la película. Dura unos 20 minutos (formato Flash en streaming) y se puede ver en distintos...
Por Nacho Palou -
10 FEB 2005
Si hay algo icónico de las películas de la Guerra de las Galaxias -aparte de los sables de luz- son los textos que aparecen al principio de cada película perdiéndose en la distancia, y parece ser que en la web oficial de...
rvr recuerda unos cuantos relatos, libros y películas en los que está presente Titán en Regreso a Titán, e incluye una referencia a entrada de José Carlos Canalda sobre esta luna el el glosario del Sitio de Ciencia-Ficción, que a su vez...
Navegando me encontré con Trekker o Trekkie; una anotación que apuntaba al Glosario de Ciencia Ficción, donde se explicaba la diferencia entre estos dos términos Trekkie es el término original para los primeros aficionados a Star Trek. Pero con el paso del...
Ayer en el cine proyectaron el trailer completo de Batman Begins. Se puede ver el teaser en Apple.com y en otros mirrors. En Warner Bros está el trailer completo en formato QuickTime, 12 MB. Esta es probablemente la película que con más...
Vodafone y la Twentieth Century Fox han anunciado hoy que esta última creará 24 "movisodios" de un minuto protagonizados por los personajes de la serie 24 diseñados para ser vistos en la pantalla de los móviles del servicio 3G de Vodafone que...
Yonderboy confirma lo que temíamos acerca del reciente lanzamiento de Cosmos en DVD en España: Suevia Films ha doblado de nuevo la serie con otro doblador para ofrecer el audio en Español en Dolby 5.1 y 5.1 DTS Surround, y no se...
Hoy en Slashdot hay un post acerca de unas declaraciones de Mark Hamill, el actor que protagonizó el papel de Luke Skywalker en la trilogía original de La Guerra de las Galaxias, en las que habla de otra trilogía más, que constaría...
Hace unos minutos acaba de empezar en Antena 3 la emisión de la tercera temporada de 24. Si es como las dos anteriores, nos tendrá pegados al televisor durante las 24 horas en cuestión; lo malo es que la rubia tonta ahora...
Ahora que ya habrás tenido oportunidad de verla, estas son las notas y fuentes utilizadas por Michael Moore para realizar la película....
Ha tardado, pero parece que por fin el próximo 28 de agosto saldrá a la venta Cosmos en DVD en España. Si lees este blog, imagino que la explicación sobra, pero por si acaso, Cosmos es una de las más grandes series...
Me ha parecido divertida la lectura de Spiderman que hace Jaime en La decadencia del ingenio.En definitiva, queda claro que Mary Jane es el verdadero personaje malvado de la película, el antagonista con el que el hombre-araña se tendrá que enfrentar una...
Por Nacho Palou -
22 JUL 2004
Repasando las citas memorables de Gladiator me di cuenta de que la gloriosa frase que da inicio a la gran batalla del principio, Maximus: «A mi señal, ira y fuego.» No tiene nada que ver con la versión original, Maximus: «At my...
Los película Sky Captain and the World of Tomorrow cuenta una historia sobre robots gigantes que atacan la ciudad de Nueva York de los años 30. Está protagonizada por Gwyneth Paltrow y en ella Angelina Jolie interpreta a la comandante de un...
Por Nacho Palou -
15 JUN 2004
Cada vez que hablamos de series en Microsiervos termina por salir Urgencias, cuya primera temporada en DVD está por fin a la venta desde hoy en España: DVDgo, OfertaDVD. Ofkors, no tengo ninguna relación comercial con ninguna de las dos empresas salvo...
Disney, propietaria de los estudios Miramax, que han sido los que han financiado Farenheit 9/11, el más reciente documental de Michael Moore, ha decidido no distribuirlo en los Estados Unidos por temor a perder las ayudas fiscales de las que disfruta en...
Leído en Guía Star Trek: El productor de Star Trek Rick Berman reveló hoy que ha comenzado a trabajar en lo que eventualmente podría convertirse en Star Trek XI. «Estoy involucrado en las muy tempranas etapas de lo que podría ser la...
La semana completa sin ver la televisión será del 19 al 25 de abril, es decir, a partir del lunes de la semana que viene. La iniciativa se llama TV-Turnoff Week 2004 y ya es el décimo año que la convocan --...
Anoche, mientras zapeaba en un intermedio de CSI, vi el final de una escena de la serie As leis de Celavella que emite la Televisión de Galicia que me llamó la atención. Si no me equivoco, en ésta se veía como uno...
Hace algún tiempo Alvy escribía acerca de aquellas grandes series de TV que probablemente nunca volvamos a ver, quizás tan siquiera en DVD. La primera de las que mencionaba era Doctor en Alaska. Pues bien, resulta que TVE acaba de sacar la...
– Fucking Quintana! That creep can roll, man. – Yeah, but he's a pervert, man… Y un montón de citas más de Esa Gran Película en The Big Lebowski Random Quote Generator. (Vía Blogdex.)...
Parece que finalmente este verano (al menos en EEUU) llega al cine la historia Aliens versus Predator (AVP), en la que se enfrenta a dos de las más feroces criaturas que ha dado el cine. La película llega años después de que...
Por Nacho Palou -
16 MAR 2004
«(...) Crees estar viendo una película, y cuando termina resulta que has estado viendo otra. Estás durante todo el largometraje intentando almacenar detalles sobre esa escena o ese personaje, y al final descubres que poco o nada relevantes son respecto a la...

Ya está activa la web de la película basada en la colección de relatos Yo, Robot de Isaac Asimov, un libro que casi seguro que has leído. La acción se sitúa en el año 2035, cuando los robots se han convertido...
Godzilla Final Wars será, de momento, la última película del lagarto sobredimensionado. En su 50 aniversario la productora Toho ha decidido que es hora de un descanso, motivado en parte por el descenso de público, tras 28 películas desde 1954 en que...
Por Nacho Palou -
10 MAR 2004
Ahí va la lista de las últimas películas que he visto. En vez de listarlas cronológicamente como solía hacer las he agrupado antes en tres categorías. Advertencia: recuérdese que aquí en Microsiervos solemos recomendar películas por las razones más equivocadas del mundo…...
Homer Simpson no es desde luego el primero que se le vendría a la cabeza a nadie a la hora de pensar en sutilezas, pero los guionistas de los Simpson han incluido en diálogos y escenarios montones de bromas y coñas que...
Anoche vi como en una película un tipo con pinta de bombero le decía a su mujer algo así cómo: «Es mi trabajo y he de ir, pero no te preocupes, no me pasará nada» y automáticamente pensé «este tipo la palma...
Esta noche vuelve El Ala Oeste a RTVE, que no contenta con haberla machacado en la emisión de su primera temporada con el «magnífico» horario de las 23:30 de los jueves en TVE 1 como ya comentamos en su momento, ahora la...
La trilogía original de «La Guerra de las Galaxias» en DVD verá la luz en septiembre de este año, en EE.UU. y Canadá y poco después en el resto del mundo, aunque en sus versiones retocadas digitalmente y no las originales estrenadas...
Por Nacho Palou -
12 FEB 2004
De vez en cuando a las empresas, por el motivo que sea, se les ocurre que es una buena idea cambiar de imagen. Una de las últimas en hacerlo ha sido la compañía de seguros Génesis, que deja de tener a Carlitos,...
Esta noche vuelve Grissom con el estreno en Telecinco de la tercera temporada de CSI, de nuevo con Las Vegas como escenario de los casos. A continuación se repite el primer episodio de continúa CSI Miami....
Por Nacho Palou -
9 FEB 2004

En los días anteriores al acontecimiento tuvo al mundo entero preguntándose si aparecería. Un avión tras otro estuvieron esperándole en la pista, mientras él dormía la siesta, paseaba y comía bocadillos. Henry Kissinger le pidió que fuera por el honor de la...
Esta es la lista de las últimas películas que he visto, en cine, televisión o DVD. Es un poco larga porque incluye todo diciembre y noviembre pasados, que no actualicé. Si publico de vez encuando la lista completa de todas las que...
Las siguientes noticias no pueden ser más absurdas, dado que se publican todas a la vez y se puede elegir cualquiera de las tres posibilidades sobre la realidad del cine español: • El cine español ganó mercados y espectadores • El cine...
Bill Gates fue asesinado en el MacArthur Park de Los Ángeles el 2 de diciembre de 1999, mientras recibía un homenaje, por dos disparos de un tirador solitario apostado en la terraza de un hotel cercano. O al menos esa es la...
El tribunal de apelaciones de Oslo ha confirmado hoy la sentencia que absolvía a Jon Lech Johansen, más conocido cómo DVD Jon, de los cargos de violación del copyright y de fomento de la piratería que había presentado contra él la unidad...
Wired tiene un interesante artículo acerca de Philip K. Dick y el interés que sus relatos y novelas están despertando en Hollywood a título póstumo, a pesar de que en principio no parecen muy hollywoodienses por las eternas dudas de Dick sobre...
Uno de los grandes desafíos -si no el mayor- de la ciencia actual es dar con una teoría unificada que explique las cuatro fuerzas fundamentales que gobiernan el funcionamiento básico de nuestro universo (fuerza de gravedad, electromagnética, nuclear fuerte y nuclear débil)...
Leo en el suplemento de la programación de televisión que viene hoy con el periódico que Antena 3 programa para las noches del sábado Angel a eso de las 00:15, que siendo A3 más bien será a las 00:45 y a continuación...
Hoy terminó la emisión de la segunda temporada de 24, ese pedazo de serie que te deja pegado al televisor durante las 3 horas de emisión (excepto cuando sale la rubia tonta y los ratitos de anuncios). Las buenas noticias son que...
Hace unos años estaba comentando con un compañero que pensaba ir al cine durante el fin de semana a ver Alien 3 y va el tío y me suelta:Bah, es malísima, y además al final la tía muere.Me quedé tan a cuadros...
Nacida como un serial radiofónico, editada luego en forma de libro [inglés, español] y tras varias adaptaciones a otros medios incluyendo una serie de televisión, parece ser que al fin el proyecto para llevar al cine la trilogía de cinco novelas de...
Otra lista de mejores películas de todos los tiempos: TV Cream's Top 100 Films. Se autocalifica como «distinta de los dos tipos habituales de listas». Esos dos tipos son las que empiezan (a) por Ciudadano Kane, El Padrino, etc. y (b) las...
Las últimas películas que he podido ver: •Vanilla Sky (Cameron Crowe, 2001) • Kate & Leopold (James Mangold, 2001) • Ripley's Game [El Juego de Ripley] (Liliana Cavani, 200) • Frida (Julie Taymor, 2002) • Kamchatka (Marcelo Piñeyro, 2002) Muy malas casi...
Ayer mi mujer alquiló The Good Girl en Blockbuster. Es de esos DVDs de la distribuidora Filmax cuya carátula indica que es una edición especial de alquiler, con el logotipo de Blockbuster. Nos sentamos a verla cuando empezamos a cenar. A los...
The Fanimatrix - Run Program es un corto cuya acción transcurre en el universo de The Matrix poco antes de que Morfeo se ponga en contacto con Neo. Producido por un grupo de neozelandeses admiradores de la película original con presupuesto cero,...
En el episodio 15 de la segunda temporada de CSI, Burden of Proof, Grissom y su equipo han de investigar la muerte de un fotógrafo de Las Vegas que aparece en las cercanías de una especie de granja de cadáveres. Aunque parezca...
Si te has perdido alguno de los episodios de la segunda temporada de la serie 24 puedes seguir los episodios emitidos en España por Antena3 TV, dos hasta ahora, en la página que la cadena dedica a la serie 24. Para los...
Por Nacho Palou -
17 SEP 2003
Películas de Bajo Presupuesto. (John Randall, 1991. DORSL Ediciones). Lo del «bajo» presupuesto es un poco relativo, pues el principal ejemplo que guía el libro empieza a partir de 300.000 dólares (de 1991) para un largometraje de 90 minutos. Obviamente, se pueden...
Las últimas películas que he visto: • Star Trek III: The Search for Spock [En Busca de Spock] (Leonard Nimoy, 1984). • American Wedding [American Pie: Menuda Boda] (Jesse Dylan, 2003) • Snake Eyes (Brian De Palma, 1998) Nada digno que mencionar,...
Esta noche comienza en Telecinco la nueva temporada de la serie CSI, que apartir de ahora deja el desierto de Nevada y se desarrolla en la ciudad de Miami. Por lo que se indica en la página de Telecinco la cadena repetirá...
Por Nacho Palou -
1 SEP 2003
Las películas que he visto en las últimas semanas: Pearl Harbor (Michael Bay, 2001) Bridget Jones' Diary [El Diario de Bridget Jones] (Sharon Maguire, 2001) The Animatrix (2003) Armageddon (Michael Bay, 1998) Enigma (Michael Apted, 2001) Jaws [Tiburón] (Steven Spielberg, 1975) White...
Lo último que he visto: Charlie's Angels: Full Throttle [Los ¡ngeles de Charlie: A Todo Gas] (McG, 2003) Henry V [Enrique V] (Kenneth Branagh, 1989) [DVD] Thirteen Days [Trece Días] (Roger Donaldson, 2000) [DVD] Pirates of the Caribbean: The Curse of the...
Algunas de las últimas películas que he visto estas semanas: Star Trek II: The Wrath of Khan, Director's Edition [La Ira de Khan] (Nicholas Meyer, 1982) [DVD] Road to Perdition [Camino a la Perdición] (Sam Mendes, 2002) [DVD] Terminator 3: Rise of...
Las últimas películas que he visto: Anger Management [Ejecutivo Agresivo] (Peter Segal, 2003)The Life of David Gale [La vida de David Gale] (Alan Parker, 2003)The War of the Worlds [La Guerra de los Mundos] (Byron Haskin, 1953)The Perfect Storm [La Tormenta Perfecta]...
Vía plasticbag.org, un trailer de una nueva película de animación que tiene toda la pinta de que va a ser bastante divertida: The Incredibles. Pixar + Disney. Para el año que viene....
Una académico londinense ha hecho algunos cálculos para explicar cómo sería la Película Perfecta: Según Clayton, el esquema de la película perfecta sería algo así como: 30 por ciento de acción, 17 por ciento comedia, 13 por ciento de el Bien contra...
Tras haber visto The Matrix Reloaded un par de veces, y haber refrescado The Matrix (que ya debo haberla visto unas doce veces), ahí van mis comentarios y teorías, totalmente gratuitos y por supuesto desinformados (a.k.a. «paja mental») sobre lo que puede...
Las últimas películas que he visto: Red Dragon (Brett Ratner, 2002)Saving Grace [El Jardín de la Alegría] (Nigel Cole, 2000)The Matrix Reloaded (Andy & Larry Wachowski, 2003)The Matrix (Andy & Larry Wachowski, 1999)The Matrix Reloaded (Andy & Larry Wachowski, 2003)La Lengua de...
Esta sería mi lista de películas malísimas favoritas. Algunas desconocidas, otras no, pasaron sin pena ni gloria para el gran público o se consideraron «malas». Probablemente las he visto cada una más de 5 ó 10 veces, y las puedo serguir viendo...
Qué gran película: Bend It Like Beckham (Gurinder Chadha, 2002). Me parece que entra automáticamente en la lista de películas que podrías ver cinco o diez veces sin aburrirte. Y eso que no es perfecta ni mucho menos, pero tiene un toque...
X2 (Bryan Singer, 2003) Nueve Reinas (Fabián Bielinsky, 2000) Bowling for Columbine (Michael Moore, 2002) Chicken Run (Peter Lord, Nick Park, 2000) Moulin Rouge (Baz Luhrmann, 2001) De todas estas películas que he visto últimamente, la más destacada (y merecedora sin...
El genial escritor Peter David preguntó hace poco a sus lectores ¿cuál es tu película de superhéroes favorita?. Estaba recogiendo opiniones para una columna periodística. En los comentarios de la página hay un interesante debate. La mayoría de los votos fueron para...
Hablando el otro día de Memento, la película de Christopher Nolan, no conseguíamos descifrar el significado del título. Aunque es simplemente Memento a mi me sonaba que esa palabra era algo así como memoria o recuerdo, y también que Memento Mori era...
Divertida Office Space Soundboard en la que se pueden escuchar algunas frases y expresiones con la particular entonación que les da Bill Lumbergh, el insufrible jefe de Peter Gibbons en Office Space (Trabajo Basura), película de culto. (Vía Fark.)...
Por Nacho Palou -
16 ABR 2003
Las últimas películas que he visto: Mujeres al borde de un ataque de nervios (Pedro Almodovar, 1988).Trapped [Atrapada] (Luis Mandoki, 2002).The Bone Collector [El coleccionista de huesos] (Phillip Noyce, 1999).12 Angry Men [12 Hombres sin piedad] (Sidney Lumet, 1957)....

Esta otra película también promete tanto o más que Matrix2, se trata de Kill Bill, que parece combinar lo mejor de las películas de samurais de serie B con la habitual acción en las calles de Nueva York. Una asesina es...
Wired ya ha publicado el artículo sobre Matrix: Reloaded (o Matrix2, como prefieras). El Agente Smith ha vuelto, y está cabreado.Hace tiempo que también están disponibles el Trailer y el web oficial....
He aquí una lista de esas grandes series de televisión que me gustaría que repusieran algún día pero que con casi total seguridad no van a reponer -- y que por lo que parece va a ser también muy difícil que lleguemos...
Las películas que he visto en las últimas semanas: The Shipping News [Atando Cabos] (L. Hallström, 2001)Till Dad Do Us Part (Randall Miller, 2001)Windtalkers (John Woo, 2002)Star Trek: Nemesis (Stuart Baird, 2002)Chicago (Rob Marshall, 2002)K-Pax (Iain Softley, 2001)Lucky Numbers [Combinación Ganadora] (Nora....
Como no podía ser de otra forma, dado que hemos tenido recientemente películas como Spiderman, X-Men, Daredevil y similares, y queda por venir La Masa, y X-Men 2 y Spiderman 2, etc. etc. ya están haciendo una renovación del que no podía...
Con un poco de retraso, la lista de películas que he visto en las últimas semanas: Road to Perdition [Camino a la Perdición] (Sam Mendes, 2002)Solaris (Steven Soderbergh, 2002)The Hours [Las Horas] (Stephen Daldry, 2002)The Godfather, part III [El Padrino III] (Francis...

Sólo para trekkies: un grupo de fans se han unido para crear Starship Exeter: The Savage Empire, las aventuras de bajo presupuesto de la U.S.S Exeter, al más puro estilo Star Trek: La Serie Original. Esta nueva nave recorre la galaxia...
Últimas películas que he visto... Things to do in Denver When You're Dead [Cosas que hacer en Denver cuando estás muerto] (Gary Fledder, 1995)Serendipity (Peter Chelsom, 2001)The Sound of Music [Sonrisas y Lágrimas] (Robert Wise, 1965)...
Las últimas pelis que he visto: Basic Instict [Instinto Básico] (Paul Verhoeven, 1992)Lord of The Rings: The Two Towers [El Señor de los Anillos: Las Dos Torres] (Peter Jackson, 2002)El Hijo de la Novia (Juan José Campanella, 2001)...
Hoy me regalaron Star Wars: Executor Video Box Set / SuperClass: ISD, que es una caja-super-mega-pack para coleccionistas de Star Wars. Se trata de un pack de edición limitada (20.000 unidades en todo el mundo, ~40 en España) que lanzó George Lucas...
Las últimas películas que he visto... Ice Age [La Edad de Hielo] (Carlos Saldanha, 2002) Changing Lanes [Al Límite de la Verdad] (Roger Michell, 2002) The Peacemaker [El Pacificador] (Mimi Leder, 1997)...
Mola esto porque refuerza mi teoría de que El Señor de Los Anillos y La Guerra de las Galaxias son la misma historia pero en épocas antagónicas, con distintos personajes y en ambientes y escenarios diferentes. En este caso además se suma...
Por Nacho Palou -
27 NOV 2002
Las últimas pelis que he visto: Straw Dogs [Perros de Paja] (Sam Peckinpah, 1971)The Bourne Identity [El Caso Bourne] (Doug Liman, 200)Highlander [Los Inmortales] (Russell Mulcahy, 1986)Hot Shots! Part Deux [Hot Shots 2] (Jim Abrahams, 1993)...
Las peliculas que he visto este fin de semana: Ed Wood (Tim Burton, 1994)Hart's War [La Guerra de Hart] (Gregory Hoblit, 2002)Gosford Park (Robert Altmam, 2001)Harry Potter and the Sorcerer's Stone [Harry Potter y la Piedra Filosofal] (Chris Columbus, 2001)Ed Wood sigue...
Las últimas películas que he visto: GoldenEye (Martin Campbell, 1995)El Crimen del Padre Amaro (Carlos Carrera, 2002)Nuovo cinema Paradiso [Cinema Paradiso] (Giuseppe Tornatore, 1988)The Lord of The Rings: The Fellowship of the Ring [El Señor de los Anillos: La Comunidad del Anillo]...
Las películas que he visto este fin de semana: Butch Cassidy and the Sundace Kid [Dos Hombres y un Destino] (George Roy Hill, 1969)Back to the Future [Regreso al Futuro] (Robert Zemeckis, 1985)Back to the Future II [Regreso al Futuro II] (Robert...
Vistas recientemente: K-19 (Kathryn Bigelow, 2002)The Negotiator (F. Gary Gray, 1998)...
La reflexión graciosa (y/o profunda, realista, como te apetezca llamarla) del día ha sido esta, procedente de uno de los fans de Star Trek que están en la lista de correo del USS-Virtual. Ahora sólo me faltan 6 temporadas en DVDs [de...
Estas son las películas que he visto en las últimas semanas, algunas en el cine, otras en DVD: Annie Hall (Woody Allen, 1977)Blackout Effect (Jeff Bleckner, 1998)Minority Report (Steven Spielberg, 2002)Nothing Hill (Roger Michell, 1999)Titanic (James Cameron, 1997)Snatch (Guy Ritchie, 2000)Insomnia (Christopher...
La cuestión es, Bob, que no es que yo sea vago.Es que no me da la gana— Peter. De vez en cuando rebobino y veo la película Trabajo Basura (Office Space, 1999) de Mike Judge —que inicialmente iba firmada con su seudónimo...
Por Nacho Palou -
14 OCT 2002
Estas son las pelis que he visto este fin de semana: Annie Hall (Woody Allen, 1977) Signs (M. Night Shyamalan, 2002) Father of the Bride II (Charles Shyer, 1995)...
Estas son las pelis que he visto este fin de semana The Score (Frank Oz, 2001)Gladiator (Ridley Scott, 2000)Deep End of the Ocean (Ulu Grosbard, 1999)...
Estas las vi este fin de semana Black Hawk Down (Ridley Scott, 2001)DragonFly (Tom Shadyac, 2002)Matrix (Wachowski Brothers, 1999)Sneakers (Phil Alden Robinson, 1992)Monty Phyton Flying Circus Vol. 1 (1969-1974) y esta otra es de hace tiempo pero se me olvidó incluirla (tal...
Como ayer estaba insomne (maldito verano), revisité una buena película: Four Rooms (Anders, Rockwell, Rodríguez, Tarantino, 1995)...
Lista rápida de las últimas películas que he visto en estas semanas (pre y post-vacacionales): Superman II (Richard Lester, 1980)Independence Day (Roland Emmerich, 1996)Armageddon (Michael Bay, 1998)Tora, Tora, Tora! (Richard Fleischer, Kinji Fukasaku, 1970)True Romance, (Tony Scott, 1993)...
Hoy he estado viendo Dumb and Dumber (Dos Tontos Muy Tontos) en la realidad, como todo el día, ha sido como un deja-vù, como vivirla constantemente, como......
Estas son las pelis que he visto este fin de semana. High Crimes (Carl Franklin, 2002)The Sum of All Fears (Phil Alden Robinson, 2002)...
Estas son las pelis que he visto este fin de semana. Pushing Tin (Mike Newell, 1999)Spy Game (Tony Scott, 2001)America's Sweethearts (Joe Roth, 2001)Memento (Christopher Nolan, 2000)Young Frankenstein (Mel Brooks, 1974)...
Lista rápida de las últimas películas que he visto últimamente: L.A. Story (Mick Jackson, 1991)Star Trek: The Motion Picture [Special Edition] (Robert Wise, 1979)Reservoir Dogs (Quentin Tarantino, 1992)Eye of the Needle (Richard Marquand, 1981)12 Angry Men, (Sidney Lumet, 1957)...
Y Apple también ha puesto en su web el trailer de la segunda entrega de El Señor de los Anillos, Las Dos Torres, a ver si hay suerte y es tan buena como la primera....
Ya está circulando el trailer de la próxima entrega de la sala Trekker: Star Trek: Némesis. Con los personajes de La Nueva Generación y... un poquito de acción. Actualización: Sitio oficial de Star Trek: Némesis....
Ya puedes hacer de Spielberg con DFILM, una especie de generador de películas en Flash donde personalizas escenario, personajes y las cosas que van diciendo, y luego puedes enviar las películas como postal a tus amigos....
Era bien conocido que se pueden construir a medida, ahora resulta que Park Sabers ya ha vendido cerca de un millón de dólares construyendo sables de luz estilo Star Wars para los fans. Mmmm......